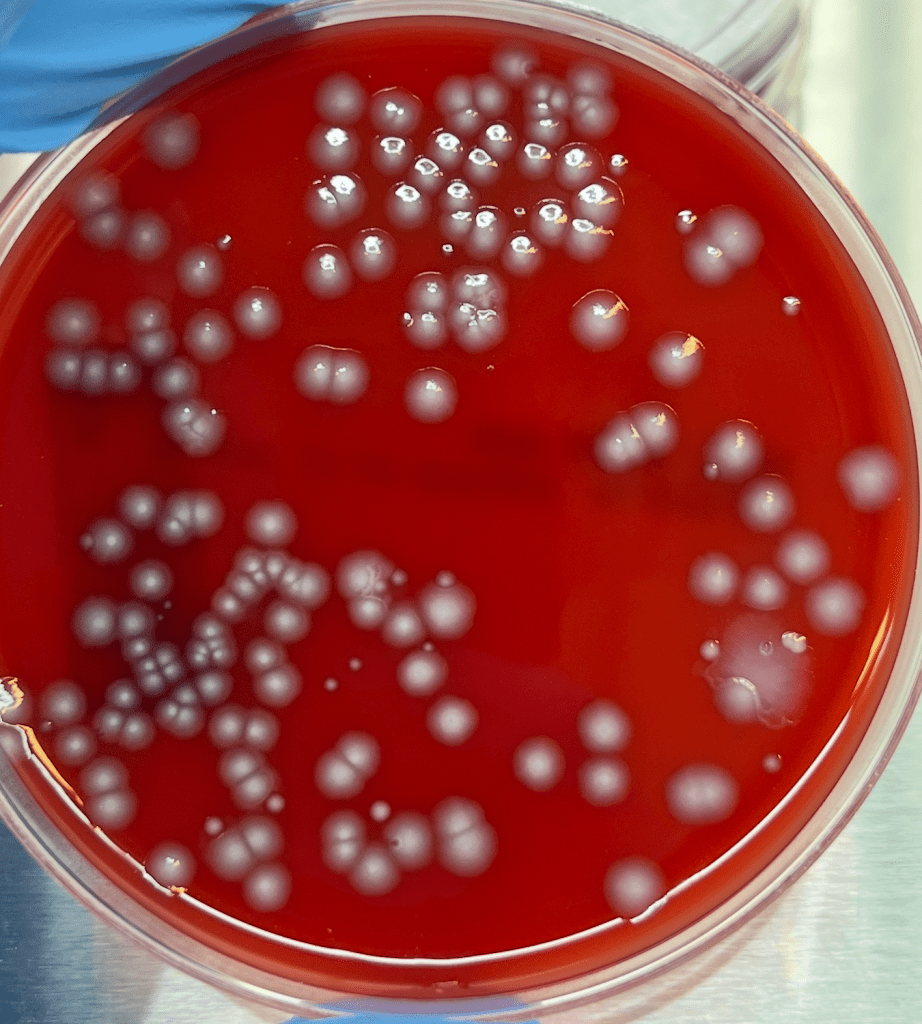

1/1/26 (Day Rating: 4.2/10)
- I am grateful for going to 할아보지 and 한모니’s house today to do se-be!
- I am grateful for lots of yummy and good food today and then grateful that we got to wake up at noon today
- I am grateful for finally being able to get some alone time today geez

12/31/25 (Day Rating: 4.2/10)
- I am grateful for going home and for Soogomo picking up our entire family from the airport that was nice of her
- I am grateful for safe travels back home on the airplane
- I am grateful for being able to go to the aquarium today

12/30/25 (Day Rating: 2.5/10)
- I am grateful for pool today
- I am grateful for Mexican food today
- I am grateful for relaxing today

12/29/25 (Day Rating: 0.9/10)
- I am grateful for basically getting all better
- I am grateful for making it to hotel
- I am grateful for sleep

12/28/25 (Day Rating: 1.7/10)
- I am grateful for monument valley
- I am grateful for getting lots better
- I am grateful for safe traveling

12/27/25 (Day Rating: 0.5/10)
- I’m grateful for the horshoe place looking pretty
- I am grateful for guided tour being fun
- I am grateful for food

12/26/25 (Day Rating: 1.4/10)
- I am grateful for feeling a little bit better today health wise
- I am grateful for in n out today
- I am grateful for safe travels td

12/25/25 (Day Rating: 1.9/10)
- I am grateful for Christmas
- I am grateful for pulling the immersive charizard
- I am grateful that the hotel was pretty nice.

12/24/25 (Day Rating: 2/10)
- I am grateful that we made it to Phoenix safely
- I am grateful for having in n out burgers today
- I am grateful that even though we are sick, we are not dead.

12/23/25 (Day Rating: 3.1/10)
- I am grateful that even though we felt like crap crap today, that it happened now rather than during finals or school or any other important day
- I am grateful for being able to go get Saranrom Thai food today!!
- I am grateful for being able to see Alice/Gerry/Michael today

12/22/25 (Day Rating: 6.8/10)
- I am grateful to make progress on youtube video
- I am grateful for starbucks coffee making me feel good
- I am grateful for so much sleep and being able to wake up/sleep whenever I want to LOL

12/21/25 (Day Rating: 5/10)
- I am grateful that OPM season 3 episode 11 came out today
- I am grateful for Halmony being born 82 years ago
- I am grateful for church today and being able to hang out with Josh/Jae afterwards (AND ALSO FOR FINDING MY AIRPODS)

12/20/25 (Day Rating: 6/10)
- I am grateful for safe travels home
- I am grateful we got to go to the Christmas light show today
- I am grateful that we got to spend the day w Joyce without having school work

12/19/25 (Day Rating: 3.5/10)
- I am grateful for finishing 317 paper
- I am grateful for alfalfa
- I am grateful for nap nap nap

12/18/25 (Day Rating: 6.5/10)
- I am grateful that we got to take a very nice nap today it was enjoyable much so
- I am grateful that we got to watch Avatar with the roomies today
- I am grateful for working on paper today for a little bit

12/17/25 (Day Rating: 7.5/10)
- I am grateful for Jua today!! Food was kinda fire HEHE
- I am grateful for getting to see Chloe/Jenny for the last time before they leavee. And then I’m grateful we got to finally grab a meal w Zehao too all at PJ’s today
- I am grateful for a very much fun and enjoyable day in the city

12/16/25 (Day Rating: 5.4/10)
- I am grateful for being able to sleep well today and then also making lots of progress on 317 paper
- i am grateful for alfalfa! Super yum
- I am grateful for being able to do work at Princeton it is a privilege to be here

12/15/25 (Day Rating: 6.7/10)
- I am grateful for acceptance day
- I am grateful that we got to drive Jourdain to the doctor’s office and see that he’s doing alright
- I am grateful for a very chill day at school cuz we get to hang w joyce

12/14/25 (Day Rating: 5/10)
- I am grateful the 308 paper deadline got pushed back until tomorrow gives me some rest/breathing space
- I am grateful that I got to see OPM season 3 episode 10 today
- I am grateful joyce brought us breakfast this morninggg

12/13/25 (Day Rating: 5.3/10)
- I am grateful for finishing my 309 final today and getting that done and over with
- I am grateful for getting small world with Brian today!
- I am grateful for nap and then making lots of progress on my paper for 308

12/12/25 (Day Rating: 5.9/10)
- I am grateful for getting all the 309 lectures done with today
- I am grateful for my temu package with Christmas presents arriving today!
- I am grateful for hoagie and Stone

12/11/25 (Day Rating: 4/10)
- I am grateful for making much progress on study study study
- I am grateful that we can eat KBBQ todayy
- I am grateful for the people here at princeton

12/10/25 (Day Rating: 4.1/10)
- I am grateful for waking up late today and getting solid sleep
- I am grateful for getting the 309 paper done and over with
- I am grateful for getting lots of studying for 309 done with today too

12/9/25 (Day Rating: 5.8/10)
- I am grateful for much sleep and then also being able to get the commencement fair over with!
- I am grateful for dinner with 김 선생님 todayyy
- I am grateful for making lots of progress on our papers

12/8/25 (Day Rating: 6.7/10)
- I am grateful for being able to buy groceries for da dinner tmrw and not having to worry about getting a parking ticket LOL
- I am grateful for my call with Mr. Chiu today and honestly getting some pretty fire advice. He’s a really insightful dude
- I am grateful for making progress on my EEB 309 paper today good job

12/7/25 (Day Rating: 5.5/10)
- I am grateful for BU visit day
- I am grateful that we got to meet super cool people like Kendall
- I am grateful for safe travels back to home/school

12/6/25 (Day Rating: 5/10)
- I am grateful for safe travels to Boston today
- I am grateful to be able to explore Quincy market with the family
- I am grateful for trying out boston foods like lobster mac n cheese and clam chowder

12/5/25 (Day Rating: 6.5/10)
- I am grateful for last day of classes today we are done for the Fall semester and done with all our immediate stressors 🙂
- I am grateful for getting 317 presentation done and over with
- I am grateful for being able to go home

12/4/25 (Day Rating: 5.8/10)
- I am grateful for FSG giving us lots and lots of BBQ chicken today
- I am grateful for getting the 317 slideshow presentation done
- I am grateful for having friends here at school

12/3/25 (Day Rating: 6.8/10)
- I am grateful for finishing senior thesis paper and locking in! And then am grateful for the final class of 308 today as well.
- I am grateful for going to concert with Amy and Joyce and Josh and Daniel and Doris and Aman today
- I am grateful for easy parking in the city today I feel like I am stressing myself out for no reasons. And then the food at moona today was fire

12/2/25 (Day Rating: 7.4/10)
- I am grateful for getting free dinner from PPDA today thank you princeton
- I am grateful for getting last of the interviews + 309 presentation done and over with today
- I am grateful for being able to get all of the courses that we wanted to get today!

12/1/25 (Day Rating: 7/10)
- Happy December!! I am grateful we made it to December muahhaha
- I am grateful for being able to wake up really really late this morning
- I am grateful for being able to be so much more productive at school than at home. I think I wanna stay at school for longer so I am grateful for school.

11/30/25 (Day Rating: 4.98/10)
- I am grateful for being able to see many people at church today!
- I am grateful for making it back to Princeton safely
- I am grateful for umma being elder today

11/29/25 (Day Rating: 5/10)
- I am grateful for day in the city w the family today
- I am grateful for my leg not dying on me today when walking everywhere
- I am grateful for being able to watch movie w umma and joey today

11/28/25 (Day Rating: 5.4/10)
- I am grateful for Black Friday shopping at Roosevelt Field today
- I am grateful for so much sleep today
- I am grateful for temu

11/27/25 (Day Rating: 4.6/10)
- I am grateful for thanksgiving today!
- I am grateful for putting up the Christmas tree today
- I am grateful for being able to see so many of my family today

11/26/25 (Day Rating: 6/10)
- I am grateful for being able to take naps today and then drive Joey to school
- I am grateful we got to see Michael today and grab chipotle and Mango Mango with him
- I am grateful that we got to do a lot of progress on the card today!

11/25/25 (Day Rating: 4.5/10)
- I am grateful Joshy was born 25 years ago
- I am grateful we got to hang out w Josh and Jae td
- I am grateful that we got to see the new renovations at the library today!

11/24/25 (Day Rating: 4/10)
- I am grateful for safe travels home
- I am grateful for mac and cheese and coke
- I am grateful for being able to help Vincent get to the bus company for his phone

11/23/25 (Day Rating: 7/10)
- I am grateful for roomie dinner today at Skully
- I am grateful for church today going well, talking with Michelle a little bit there and then being able to learn more about salt and light of the world message from Pastor Scott
- I am grateful that we finally are able to spend some time in Stone to lock in cause it has been quite a while

11/22/25 (Day Rating: 6.8/10)
- I am grateful for SSG today and being able to go to it for the first time!
- I am grateful for being able to see wicked 2 in theaters today
- I am grateful for so so much sleep today

11/21/25 (Day Rating: 5.7/10)
- I am grateful for sink being fixed today and same with leak!
- I am grateful for remembering Hoagie haven today
- I am grateful for leg being slowly healing

11/20/25 (Day Rating: 7/10)
- I am grateful for being done and over with interview td and then also being able to see Claire on the Zoom that was quite interesting!
- I am grateful for joyce buying us a coffee today and then being able to get a bunch of hot pockets for happy hour today
- I am grateful for FSG, for thanksgiving dinner, and being able to be productive today

11/19/25 (Day Rating: 6.8/10)
- I am grateful for being able to help out Brian with the junior-sophomore dinner today and then also showing up to all of our important meetings today like Graham safety meeting, 308 lecture and precept
- I am grateful for being able to go to Bible study with Payge every Wednesday this is something to be very grateful for!
- I am grateful for being able to take lil nappy naps

11/18/25 (Day Rating: 7.5/10)
- I am grateful Jenny was born 20 years ago
- I am grateful much progress was made on the 309 draft paper
- I am grateful for seeing a lot of the lab mates and then finishing all the meetings we needed to go to.

11/17/25 (Day Rating: 7/10)
- I am grateful that we got to help out Amysshi get to do the doctor’s office today and that the stupid EEB presentation is done and over with
- I am grateful for the little nap we got to take today!
- I am grateful for going to all of our important meetings today. Class, Precept, Amysshi, Dr. Graham.

11/16/25 (Day Rating: 6.8/10)
- I am grateful for the sermon today being pretty interesting and fire. We learned a lot about the persecution beatitude
- I am grateful for being able to serve by bringing people to church, and then serve through cooking for the junior class today
- I am grateful for being able to get important work prep done today

11/15/25 (Day Rating: 3/10)
- I am grateful for dhall
- I am grateful for firestone
- I am grateful for coffee

11/14/25 (Day Rating: 6.8/10
- I am grateful for terhune orchids today during field trip for EEB 317 that was fun! We learned a lot about apple tree farming lol
- I am grateful for going to the gym for the first time in months and chipotle w joyce td!
- I am grateful for dship w Daniel Guy going really well today he is a very fun person to talk to. Always enjoy conversations with him.

11/13/25 (Day Rating: 6.4/10)
- I am grateful that we got all of our essential meetings out of the way: precept, portrait, 2 BU meetings, class, FSG, happy hour. All done done done
- I am grateful for being able to eat lunch at the Dhall today and it was yummy
- I am grateful for being able to make the most of my time here at this school muahhaha

11/12/25 (Day Rating: 7.5/10)
- I am grateful that Sarah gave us her late mealll
- I am grateful for coffee club drinks w Joyce!
- I am grateful for getting Touro over with today

11/11/25 (Day Rating: 8/10)
- I am grateful for being able to go to all of the meetings that we needed to go to today and not be a completely lazy bum
- I am grateful for Eddy giving us his late meal
- I am grateful for Dr. Konkel giving us a comprehensive walk though of measuring bone loss today

11/10/25 (Day Rating: 7.7/10)
- I am grateful for being able to wake up at noon todayy. And then I am grateful for Yoon giving us her late meal
- I am grateful for costco run + this morning
- I am grateful for being able to make it to class today. Princeton is really nice when it’s chill

11/9/25 (Day Rating: 6.8/10)
- I am grateful for dinner with Kevin, Jocelyn and Michael today and then dessert at Mango Mango
- I am grateful for chicken sandwich lunch today at QB w Joyce!
- I am grateful for being able to meet a lot of new people driving to church today

11/8/25 (Day Rating: 8/10)
- I am grateful for so much yummy lunches and dinners today at KBAP and Schezwan House
- I am grateful for so much boba and sweets today
- I am grateful for safe travels

11/7/25 (Day Rating: 5/10)
- I am grateful for our friends trusting us enough to ask for help when they need it. So thankful that I was able to bring Amysshi to doctor’s office today
- I am grateful for the weather being really nice this past week with very pretty sunsets
- I am grateful that even though the paper isn’t done yet, that I am confident in our capabilities in getting this paper done on time.

11/6/25 (Day Rating: 6.5/10)
- I am grateful for making it on time for 308 precept and 309 preceptor letting us make up some work for the session we missed muahahha
- I am grateful for dino nuggies!! And then for my friends Chloe and Jenny sitting with us before 309 lecture
- I am grateful for Boston’s invite!!

11/5/25 (Day Rating: 7/10)
- I am grateful for safe travels to philly today and back! And then grateful for seeing Daniel Lee again
- I am grateful for trying out Molly tea today was pretty good
- I am grateful for Bible study and dinner with Payge

11/4/25 (Day Rating: 5.5/10)
- I am grateful for safe drives back to pton and for hey tea bogo
- I am grateful for making table w joyce td and returning old table
- I am grateful for being able to enjoy some time both at home and pton today

11/3/25 (Day Rating: 4/10)
- I am grateful about learning so much from appa by talking to him for 6 hours on the car ride. Lots of bank advice
- I am grateful for Buffalo interview done and over with
- I am grateful for very very yummy dinner today

11/2/25 (Day Rating: 5/10)
- I am grateful for safe trips to Buffalo
- I am grateful for appa coming with us and learning a lot from him
- I am grateful for church today and pastor sam’s sermon!

11/1/25 (Day Rating: 5.8/10)
- I am grateful for Kevin Wang and being his friend these past 3 years
- I am grateful for safe travels back home
- It’s crazy that we are graduating so soon and leaving like Kevin what the heck I am grateful for just being a student here 🙂

10/31/25 (Day Rating: 6/10)
- I am grateful for dship w Daniel and going to class today to the Watersheddd
- I am grateful for going to chic fila today!
- I am grateful for the interfellowship tn

10/30/25 (Day Rating: 4.3/10)
- I am grateful for making it in time for precept this morning although it was raining
- I am grateful that we got to spend some time with Jenny today before we went to 309 lecture that was fun
- I am grateful for treating myself to yummy dinner today

10/29/25 (Day Rating: 3/10)
- I am grateful to wake up at 1pm today and get full night of sleep
- I am grateful for lunch and dessert w joyce today and also being able to pick up happy hour stuff
- I am grateful that we finally decided to read the city of ember for pleasure brings us backk

10/28/25 (Day Rating: 4.5/10)
- I am grateful for being able to wake up whenever I want to
- I am grateful for doing some productive thingies today (precept assignment, 309 outline, thesis work) but honestly we were NOT locked in today
- I am grateful that ppl came to our small world open tab 🙂

10/27/25 (Day Rating: 7.5/10)
- I am grateful for a very much productive session at shopping today for michael, brian, chloe, joe, me, manna, joyce, amayel, MC, jason, many many things bought for many many people
- I am grateful for going to both classes today
- I am grateful for eating homemade lunch and dinner today

10/26/25 (Day Rating: 6.5/10)
- I am grateful for church today and lessons in mercy was an interesting analogy given by pastor today with his example of the cheating pizza sports teams
- I am grateful for safe travels to and from hmart today
- I am grateful for Xuanying being born 22 years ago

10/25/25 (Day Rating: 8.2/10)
- I am grateful for safe travels both to and from philly
- I am grateful for fun coffee fest and yummy brunch/dinner today
- I am grateful for the biggest, fattest, nap ever

10/24/25 (Day Rating: 6.5/10)
- I am grateful for Maho’s birthday today
- I am grateful for finishing my final Ooika shift
- I am grateful for the kpot dinner w the gang today!

10/23/25 (Day Rating: 7/10)
- I am grateful that Cafe 72 was fun today and it was a cute cafe
- I am grateful that jourdain is getting better
- I am grateful for winning twice in bingo LOL

10/22/25 (Day Rating: 5/10)
- I am grateful for being able to work with Sonia throughout the Ooika farmer’s market this semester
- I am grateful for Michael being born 21 years ago
- I am grateful that we took the bestest nap ever

10/21/25 (Day Rating: 5.25/10)
- I am grateful for getting another interview over w today
- I am grateful for nappy nap
- I am grateful for making it to the places that we needed to be today

10/20/25 (Day Rating: 5/10)
- I am grateful to get another ooika shift over with. At least we got to bring a free strawberry matcha latte tho
- I am grateful that we got to go to both of our classes today congrats!
- I am grateful for my nap nap nap

10/19/25 (Day Rating: 4.35/10)
- I am grateful for safe drives back to pton
- I am grateful for seeing umma today
- I am grateful for being able to chill for most of today

10/18/25 (Day Rating: 5/10)
- I am grateful for safe drives back home
- I am grateful for literally a full 15 hours of sleep
- I am grateful for seeing appa today

10/17/25 (Day Rating: 7.5/10)
- I am grateful for finishing a week of Ooika shifts
- I am grateful for Brian and Stella welcoming us into their home
- I am grateful for Hey Tea and hair cut and h mart

10/16/25 (Day Rating: 6/10)
- I am grateful for Halal guys w Luis for dinner today was fun
- I am grateful for meeting Kaya at Ooika today and learning about how bio grad programs are cooked atm
- I am grateful for nap today

10/15/25 (Day Rating: 6.5/10)
- I am grateful for getting 6 hour shift done today
- I am grateful for so many food places with grace, jocelyn sophia and joe today
- I am grateful for safe travels to and from flushing

10/14/25 (Day Rating: 5/10)
- I am grateful that kevin bought me tacoria today
- I am grateful for waking up at 1pm today so full day of sleep
- I am grateful for meeting with Yoon about thesis stuff

10/13/25 (Day Rating: 8/10)
- I am grateful to watch the horror netflix movie w Joyce today
- I am grateful that we got to go grocery shopping wth Michael and Jocelyn today
- I am grateful for a full shift at Ooika

10/12/25 (Day Rating: 7/10)
- I am grateful for coming home from retreat safely
- I am grateful for watching HTTYD w Joyce today
- I am grateful for good dinnerrr

10/11/25 (Day Rating: 8/10)
- I am grateful for a full day of retreat today and being able to spend a lot of time with all of the Manna people today
- I am grateful for breakfast/lunch/dinner with everyone being both yummy and good conversations
- I am grateful for meeting Isaac, Timothy, and talking with a lot of the frosh throughout retreat and then for the alumni coming

10/10/25 (Day Rating: 7.5/10)
- I am grateful that interview this morning is done and over with
- I am grateful for being able to look forward to Fall Retreat this weekend w everybodyy
- I am grateful that joyce came to visit us in stone as we finishing this stupid dichotomous key

10/9/25 (Day Rating: today was crazy/10)
- I am grateful for going to Gingered Peach/Ooika/sandwich with Joyce today
- I am grateful for somehow not completely failing the 309 midterm??
- I am grateful that Jourdain is doing wellll

10/8/25 (Day Rating: 7.5/10)
- I am grateful for Ooika farmer’s market going well
- I am grateful that we got to help our jourdain get surgery today and also we got chic fila for him
- I am grateful that we got to sleep the entire day today

10/7/25 (Day Rating: 5.5/10)
- I am grateful that the stupid EEB 309 midterm is done and over with
- I am grateful for not being super tired today and that all of our coffees worked pretty well at keeping us alive
- I am grateful that Lauren was born 21 years ago and we got to celebrate w her after prayer meeting

10/6/25 (Day Rating: 3/10)
- I am grateful that 308 paper is officially done and over with
- I am grateful to study. It’s a privilege to study It’s a privilege to study It’s a privilege to study
- I am grateful for taking a mini nap today honestly that was rly refreshing muahahah

10/5/25 (Day Rating: 6/10)
- I am grateful for a full night of sleep
- I am grateful for a full day at Stone just doing Conservation bio paper work
- I am grateful for free tacoria today muahahha

10/4/25 (Day Rating: 9.75/10)
- I am grateful that we got to refill fridge for manna common room and then bring chocolates for everybody
- I am grateful for spending a very fun birthday celebration in the city
- Good day today : )

10/3/25 (Day Rating: 7.5/10)
- I am grateful for being able to get the second round done with today and also for ooika picnic being amazing weather
- I am grateful that we got to hang out with Joyce, Evelyn and Eric today and try out KSAP dinner
- I am grateful for being official!

10/2/25 (Day Rating: 7.25/10)
- I am grateful that joyce was born 22 years ago (old.)
- I am grateful that set up went okay and Michael helped us carry much stuff.
- I am grateful that we were able to go to EEB 308 precept and 309 lecture since both of them took mandatory attendance that day whew

10/1/25 (Day Rating: 7.5/10)
- I am grateful for apple pie baking tonight with all of the roomies that’s such a core memory
- I am grateful for bible study with payge/ooika company meeting/FSGL prep meeting/dinner w Tim and Payge all being fun
- I am grateful for farmer’s market being cute and Joyce visiting the standd

9/30/25 (Day Rating: 6/10)
- I am grateful that we got to have dinner with Amy and MG and then go on a car ride with Kevin that was fun
- I am grateful that we had a FULL night of sleep after the all nighter yesterday
- I am grateful for being able to hang out with Jenny/Chloe in 309 and learning that we can actually stay with Jenny’s mom when we go to Buffalo :DSLKGJSGD

9/29/25 (Day Rating: 7/10)
- I am grateful for being able to drive back to Princeton safe and sound and 6 hour Ooika shift going well
- I am grateful for Daniel (308 preceptor) being so accommodating to help me out after lecture today
- I am grateful that we got to run into Amy at Firestone today it makes me happy to see her

9/28/25 (Day Rating: 6.5/10)
- I am grateful for church this morning being pretty chill. Drove a lot of cool new people today (David, Max, and Shayel) and then had a fun conversation in the car ride there
- I am grateful for a very cute lunch today with Panda express and pho today such good food
- I am grateful for stumpy’s axe throwing?? And then also to see umma and appa that they got home safe and sound

9/27/25 (Day Rating: 7.5/10)
- I am grateful for apple picking with the frosh today
- I am grateful for Evelyn being born 21 years ago
- I am grateful for costco run with Jocelyn!

9/26/25 (Day Rating: 7/10)
- I am grateful for Brian cooking us dinner was super duper yummy
- I am grateful for Ooika shift and EEB 317 class going well
- I am grateful that we got to spend like 2 hours just talking with Kevin in Anupta’s room watching rocky so college so fun

9/25/25 (Day Rating: 9/10)
- I am grateful for managing to wake up in time for our 7 hour ooika shift haha and then for being able to do FSG, lunch and lecture still alive
- I am grateful that we got to go to Lindsay/michelle/Erin’s housewarming party today super cute and also for tanghulu
- I am grateful for spending time with Joyce today so happy

9/24/25 (Day Rating: 7.5/10)
- I am grateful that we got to go to Bible study today with Payge and then Korean language table and see amy and 김 선생님! sm fun
- I am grateful for farmer’s market being pretty manageable today despite being super duper hot. And then also for Daniel being really understanding about precept
- I am grateful for Joe’s friends from church giving me chocolate!

9/23/25 (Day Rating: 8/10)
- I am grateful for dinner with Sean today it was quite cute
- I am grateful for PCF Bible Study tonight going well and also for Steven so graciously giving us his late meal
- I am grateful for getting a leg day over with

9/22/25 (Day Rating: 7.5/10)
- I am grateful for orientation and zoom thingy going well (somewhat) at least we didn’t blank out
- I am grateful for getting to go to the Prince Tea House today!
- I am grateful for the unders blessing us with their late meal. Shout out to Daeun and Christal

9/21/25 (Day Rating: 6.8/10)
- I am grateful we woke up in time for church td and costco run was fun
- I am grateful for bike fixing quickly!
- I am grateful for the typical day at Stoneee

9/20/25 (Day Rating: 8/10)
- I am grateful for seeing Lindsay and Amysshi today! So much fun
- I am grateful that we got to meet Joyce’s roommate Jason today and also help them grocery shop
- I am grateful for getting to go grocery shopping with Joe today

9/19/25 (Day Rating: 7/10)
- I am grateful for safe travels home and that Joey is okokok
- I am grateful for Ooika shift this morning going well and Red vouching for us LOL
- I am grateful for very chill day of class today no hard work

9/18/25 (Day Rating: 7.5/10)
- I am grateful for yapping with Edalix and Chloe today before 309 lecture today that was sm fun
- I am grateful for for FSG going well, happy hour going well, precept was helpful too, overall good vibes
- I am grateful that we got to eat chipotle today and also that we got to see joyce!

9/17/25 (Day Rating: 8.5/10)
- I AM GRATEFUL THAT WE GOT TO SEE PAYGE AT FARMERS MARKET TODAYYY
- I am grateful that ooika shift was fun and well and therapeutic
- I am grateful for… you kinda know what ;LKSDJG:LKSDJG

9/16/25 (Day Rating: 7/10)
- I am grateful for a day full of doing things that you needed to do. Good job with all of those essays Jonathan.
- I am grateful for being able to see Jocelyn today and walk with her a bit she makes me happy to see!
- I am grateful for a productive shoulder day and also 12 hours of sleep like how did we sleep that long.

9/15/25 (Day Rating: 6/10)
- I am grateful that we learned sm at our Ooika shift today like how to take bitcoin as payment, where to restock the hojicha, making a hot matcha latte with half oat milk half water, and doing weekly chores
- I am grateful that we got to have a healthy lunch today and not be super tired despite running on pretty low quality sleep
- I am grateful for just being here at Princeton university.

9/14/25 (Day Rating: 7/10)
- I am grateful to meet many new frosh/sophs are Jacob’s well today and be able to drive ppl there
- I am grateful that we got to catch up with Michelle for a bit and help her out with her Ooika application
- I am grateful for Michael and Jocelyn just being friends with me.

9/13/25 (Day Rating: 9/10)
- I am grateful for going to wedding today!! I am grateful for Brian and Stella and being able to see so many people
- I am grateful for grabbing brunch with Jessica and catching up after like literally a year of not seeing her
- I am grateful for such yummy food today

9/12/25 (Day Rating: 9/10)
- I am grateful to hang out with Joyce today!
- I am grateful for playing switch with Jenny/Chloe which was super fun
- I am grateful that 317 has Jamil in it now

9/11/25 (Day Rating: 8/10)
- I am grateful for a full day today! Happy hour went well, SF outing went well, we brought Shiala dinner, returned the van, 2 classes, gym, food, not a shabby day at all
- I am grateful that we got to see Bryan Wang today!! I am glad he is doing well
- I am grateful for having cute friends who are excited to spend time with me.

9/10/25 (Day Rating: 7.5/10)
- I am grateful for farmer’s market today going well
- I am grateful for shopping spree in the morning working out
- I am grateful for free onigiri!!

9/9/25 (Day Rating: 7/10)
- I am grateful for free bread at ooika today?? Imaged below. Was quite fire
- I am grateful for shift and class and gym all going well
- I am grateful for spending the entire night at Stone just editing my dream

9/8/25 (Day Rating: 6.8/10)
- I am grateful for Kira being done and over with.
- I am grateful for so much processing happening today
- I am grateful for it being pretty chill at Princeton.

9/7/25 (Day Rating: 7.5/10)
- I am grateful that we got to go to church at JWell for the first time in a while today and meet a lot of new frosh
- I am grateful for lawn parties today so we saw many friends and ate much food
- I am grateful for this small world coffee that I am about to buy since I am getting sleepier and sleepier.

9/6/25 (Day Rating: 7/10)
- I am grateful for the pics from Laura
- I am grateful for coffee with Joyce
- I am grateful for resale with Brian

9/5/25 (Day Rating: 6.7/10)
- I am grateful for first day of EEB 317 today and for being able to see Jessica today!
- I am grateful for Costco runnn
- I am grateful for full night of rest/sleep

9/4/25 (Day Rating: 7/10)
- I am grateful that today was a pretty chill day today with only 1 class!!
- I am grateful for dinner with Michael and Jocelyn today at the ramen place that was quite cute
- I am grateful for first day of cooking/laundry at Spelman today!

9/3/25 (Day Rating: 9/10)
- I am grateful today was also a really full and fun day today with so many friends and things to do and smiling such happiness
- I am grateful for OOIKA WITH AMYYYY and then grateful that Farmer’s market shift went well today
- I am grateful for the weather not being too hot it is honestly perfect weather for this.

9/2/25 (Day Rating: 9/10)
- Today was such a fun day because there were so many people to see and so many things to do and I am so grateful for being with friends! So I am grateful for my roomies and Marvin and Tim and Payge and Amy and Evelyn
- I am grateful for barista shift going pretty smoothly today in terms of us learning a lot
- I am grateful for dinner w Payge and Tim and Target with Michael and Brian!

9/1/25 (Day Rating: 5.5/10)
- I am grateful for last day of the EEB van being put to good use for Jame’s couch, kpot, ikea, and more
- I am grateful that we had safe travels despite dying from our runny nose
- I am grateful for seeing more people today! It’s nice being able to catch up w ppl!

8/31/25 (Day Rating: 7/10)
- I am grateful for safe travels back to pton
- I am grateful for friends here!
- I am grateful for umma and appa helping me move in swell

8/30/25 (Day Rating: 5/10)
- I am grateful for Tik tok keeping us entertained and occupied and for wifi not failing me at the airport LOL
- I am grateful that appa picked us up from the airport and that the flight went smoothly
- I am grateful for celsius to keep us awake as we prepare to pack for pton tmrwww

8/29/25 (Day Rating: 9.5/10)
- I AM GRATEFUL FOR BEING AT OXFORD UNIVERSITY
- I AM GRATEFUL FOR BEING AT OXFORD
- I AM GRATEFUL FOR BEING AT THE UNIVERSITY OF OXFORD

8/28/25 (Day Rating: 9.5/10)
- I am grateful that the seminars went well today despite me not reading a single line from Romeo and Juliet :LDSKJG:SDKGj
- I am grateful that nap was also super duper refreshing for today < 3
- I am grateful for exploring theaters and libraries and seeing old Shakespeare copies and trying out new food places and much much more!!

8/27/25 (Day Rating: 9.5/10)
- I am grateful for photo shoot today and Laura being super duper helpful!
- I am grateful for going to Blenheim Palace today it was super duper cute and I enjoyed it a lot.
- I am grateful for taking a nap today!!

8/26/25 (Day Rating: 9.5/10)
- I AM GRATEFUL FOR SO MUCH EXPLORING
- I am grateful that we enjoyed both seminars about Symposium today (basically old Greek ppl said touching beautiful ppl is bad b/c it’s addicting and u lose self control)
- I am grateful for a full day today. It’s a real privilege to be here.

8/25/25 (Day Rating: 9.5/10)
- I am grateful for FULL FIRST SEMINAR DAY TODAY TWAS SO FUN AND CUTE AND I LOVED. I am grateful to be here omgomgomgomgomgomgomg
- I am grateful for trying out pub and new food places and breakfast/lunch/dinner at Jesus College
- I am grateful for the weather being absolutely and utterly amazing today it was a good day.

8/24/25 (Day Rating: 9.5/10)
- Literally everything about today was perfect. So I am so grateful for my first day alone at Oxford wow I really needed this alone time.
- I am grateful for appa and umma sending us off here
- I am grateful for a full day of exploration, picture taking, vlogging, reading, walking, new experiencing, and enjoying 🙂

8/23/25 (Day Rating: 7.5/10)
- I am grateful that we spent an entire day with the family today at Oxford and saw possibly the most beautiful school I have ever seen in my entire life (actually objectively the most beautiful).
- I am grateful that we got to eat very very yummy lunch and dinner today. Lunch at like 5 restaurants in the Market and dinner at the pub
- I am grateful that appa was able to actually walk throughout the entirety of today hehe it was so nice seeing him not fall behind LOL

8/22/25 (Day Rating: 7/10)
- I am grateful that we made it to Oxford today safe and sound and that we got to eat breakfast and dinner at pretty good food places
- I am grateful for spending much time with family todayy
- I am grateful that we finally got to work out at the gym

8/21/25 (Day Rating: 7.5/10)
- I am grateful for 2 really good food places today. Lunch and dinner were both fire: museum fish and the dinner indian food < 3
- I am grateful that we got to see The British Museum today!
- I am grateful for being able to not be tired throughout today

8/20/25 (Day Rating: 7/10)
- I am grateful for the steak lunch being quite fire.
- I am grateful for umma and appa and Joey quality time
- I am grateful for COFFEE

8/19/25 (Day Rating: 8/10)
- I am grateful for a day full of exploring London there was literally so much we did/saw
- I am grateful for yummy dinner at Happy London the food there was pretty good! I am happy England has some good food at least
- I am grateful for spending time with our familyyy

8/18/25 (Day Rating: 6/10)
- I am grateful for landing in Europe safely
- I am grateful that we napped literally the entire plane ride so super quick
- I am grateful that we were able to find a bar to eat at midnight!!

8/17/25 (Day Rating: 7/10)
- Today was like the most brain rot day ever and I love it. Cs go, tik tok, insta reels, youtube shorts, clash royale. I am so grateful for resetting like this LOL
- I am grateful that we got to go to church today and that Pastor Sam’s sermon was honestly really thought provoking. We always try to “demonize” a group as wicked until we become a part of that group: in elementary school, it’s the cursers. In middle school, it’s the drinkers. In high school, it’s the ppl who have sex. In college, it’s those pyramid scheming rich ppl. It’s this type of mentality that prevents us from seeing the wickedness within ourselves
- I am grateful that umma and appa are going to come to London with usss

8/16/25 (Day Rating: 6.5/10)
- I am grateful that we got to hang out with Michael today!
- I am grateful we got to try out 2 new food places today to add to our beli
- I am grateful that we finally got to COMPLETELY brain rot today as in insta reels, cs go, tik tok, like all of our unhealthy habits LOL

8/15/25 (Day Rating: 5/10)
- I am grateful for safe travels back home
- I am grateful for final day at SF with David!! Last husbandryyy
- I am grateful for being able to see umma and appa

8/14/25 (Day Rating: 7/10)
- I am grateful for pretty much our final day here at Princeton it was a good and enjoyable summer and I am grateful that we were able to do it here < 3
- I am grateful for dinner and dessert with Kelly today she is fun to talk to and I am happy we were able to catch up with her
- I am grateful for decently quick and simple lab work today! Aka trying to return our lab coat and failing, helping Yoon organize swabs, lab meeting, and showing Dr. Graham where we kept our jaws

8/13/25 (Day Rating: 6.5/10)
- I am grateful that we were able to meet so many people in the city todayy! I like new york it’s pretty cute and also I enjoyed that everyone was super duper friendly
- I am grateful for an evening with Kevin Wang today and we were able to get Hiro Asian Bistro with him and shuu cafe as welll
- I am grateful that our bike fall wasn’t as bad as it should have been why do I keep on falling on my bike

8/12/25 (Day Rating: 7/10)
- I am grateful that we were able to finish our cyrobacteria preservations todayyy. And also that Yoon was willing to stay a bit later to teach us about that
- I am grateful that getting our prox was a quick and easy process and also that Kevin gave us his tie super nice of him and great to quickly see him
- I am grateful that both Red and Christa were super helpful today during the 6 hour shift and they are super sweet too! And then I’m grateful that we got to see Kevin (Kwak) at chipotle todayyy

8/11/25 (Day Rating: 5/10)
- I am grateful that today was the most chill day ever where we could basically just do whatever we want hehe
- I am grateful for chipotle and coffee and for my rewards not going through the last time so we got free guac twice in a row now
- I am grateful for this summer in general… finally coming towards our final stretch but we made it so pretty proud of ourself

8/10/25 (Day Rating: 7/10)
- I am grateful for a work day today and getting experience with a morning shift and also learning how to refill the matcha machine there was a lot of new experiences today
- I am grateful for the nap that I took today it was super duper chill and relaxing and necessary
- I am grateful that Joey was born 15 years ago today!

8/9/25 (Day Rating: 7.5/10)
- I am grateful that we drove back to Princeton nice and safely from home this morning
- I am grateful that we got to spend the entire day with Marvin today and so we got to explore the American Dream Mall for the first time and also try out a few restaurants in Pal park and Fort Lee
- I am grateful for friends who want to hang out with us this is super cute

8/8/25 (Day Rating: 9/10)
- I am grateful that we spent literally the entire night today with Chloe just talking that was the cutest thing ever and super chill
- I am grateful that we got to get hot pot with the crew and that we saw final presentation at church today so we made it back to Princeton safely!
- I am grateful that we were able to function well at work today AND drive everywhere despite literally not sleeping at all

8/7/25 (Day Rating: 7/10)
- I am grateful for safe travels back to Princeton from the NIH and for Yoon safely transporting us there
- I am grateful for making it back in time for lab meeting for Charlotte’s birthday cake
- I am grateful that we got to try out the baos!

8/6/25 (Day Rating: 6.8/10)
- I am grateful for safe trips to NIH w David/Yoon 🙂
- I am grateful that we got to try a lot of restaurants today all of which were quite yummy
- I am grateful for everything going pretty smoothly with transportation and hotel!

8/5/25 (Day Rating: 6.5/10)
- I am grateful for like a full day of working today we learned a lot about barista-ing today
- I am grateful for dinner with Jenny and Chloe today!
- I am grateful for being about to drive the audi it’s so so nice

8/4/25 (Day Rating: 7/10)
- I am grateful for going back home today and eating dinner with the familyy (and hence for safe driving there and back)
- I am grateful for haircut and hmart and yo yogurt!
- I am grateful that we got cooking, laundry, and cleaning done today

8/3/25 (Day Rating: 6.5/10)
- I am grateful that today was just a super duper chill day in the house with pudding. We worked on learning about matcha, reviewing the readings, cooking/eating, walking dat dog, and just chilling out overall 🙂
- I am grateful for my final day with pudding!
- I am grateful for having super duper chill summer days where we don’t have to stress out too much

8/2/25 (Day Rating: 7/10)
- I am grateful that Chloe is super nice and understanding I am grateful for her so so much. Had a very fun evening talking with herrr
- I am grateful for finishing our Symposium reading today which took super duper long
- I am grateful for a day with pudding as well!!

8/1/25 (Day Rating: 8/10)
- I am grateful for hot pot with the SF crew today that was fun and nice and I liked talking w everyone
- I am grateful that Francene trusted us enough to dog sit puddinggg SO CUTE
- I am grateful for trying out Shake shack with Zehao/Chloe today and also for Jenny bringing free cupcakess and then movie night today

7/31/25 (Day Rating: 7/10)
- I am grateful for a day full of chill house work today. We cooked 5 chicken breasts, did laundry, took out trash, filled bathroom stock, shopping at whole foods, shopping at woori mart for hot pot tmrw, dinner, cooked rice and coffee, vegetables, picked up our prox and learned how to take care of pudding for Francene. Filled up gas and took a nap. Lots of maintaining life!!
- I am grateful for a fun day with the lab people at woori mart!!
- I am grateful for movie night!!

7/30/25 (Day Rating: 6.5/10)
- I am grateful that our last day of sacrificing and sampling is done and over with so we don’t have to worry about that anymore
- I am grateful that our nap today was kinda absolutely fire
- I am grateful for my friends heree

7/29/25 (Day Rating: 6/10)
- A day full of sacrificing and sampling today is done and over with so I am grateful for that
- I am grateful for a free ooika drink today
- I am grateful that today definitely pushed us towards our goals

7/28/25 (Day Rating: 6.5/10)
- I am grateful that we got to finish a full day of lab today… Bro I am literally so tired how do people do this so much work in one day
- I am grateful for Min Jin being really nice and helpful in our culturing bacteria on plates!
- I am grateful for the lab crew

7/27/25 (Day Rating: 6.5/10)
- I am grateful that we got to go to its a hidden cafe again today and read a lot of our philosophy friendship friend Ralph!
- I am grateful that our lunch and dinner were both healthy and happy
- I am grateful for getting to call Jocelyn and Michael at night!

7/26/25 (Day Rating: 7/10)
- I am grateful that 2 paragraph summary is done and then receipts and stuff is done too
- I am grateful that we finally got to try out Olsson’s food today. The mac and cheese was kinda bad tho
- I am grateful that we got to grab dinner and ice cream w Boya todayy! Funfunfun

7/25/25 (Day Rating: 6/10)
- Bro I had the best nap of our life after husbandry today I woke up super duper refreshed and energized for the day
- I am grateful for a successful morning of doing lab work and we got to also check our agar plates and saw some interesting growth which…. I guess it’s better than nothing at all??
- I am grateful for Jocelyn texting me YAYAYAY I have friends < 3

7/24/25 (Day Rating: 5/10)
- I am grateful that we got to wake up on the later side todayy that was really nice.
- I am grateful for a full day of cooking, cleaning, and laundry
- I am grateful that we got rid of so so many flies today (and then we learned that fly catchers are a load of crap just open the window…)

7/23/25 (Day Rating: 7.5/10)
- I am grateful the day started out with us being able to help a lot of people out! We helped our Dr. Graham with bringing the van to SF to pick up the RW mice, helped Sam out w Transport, helped out Jocelyn with the rice cooker, helped Lindsay w her PFARS, and helped Yoon and Min Jin w their experiment
- I am grateful that matcha place finally followed up YAYAYAY
- I am grateful that the rest of this week is supposed to be pretty chill now that the sacrifice days for this week are over < 3
7/22/25 (Day Rating: 6/10)
- I am grateful that we had our first day of sacrifice today and that it went well (aka we didn’t majorly mess anything up it was pretty standard)
- I am grateful for Tylenol that really helped with getting rid of our headache todayy
- I am grateful for being able to take a nap today and also for grabbing lunch with an entire lab crew that was quite fun!

7/21/25 (Day Rating: 6/10)
- I am grateful that we got one of the most hectic days of this summer over with in terms of lab work… like seriously waking up at 5:30 is not ethical
- I am grateful that we got to spend a lot of time with the entire lab crew today that was nice and then I am grateful that we got to take a pretty fire nap today
- I am grateful that we got our first invitation today!!

7/20/25 (Day Rating: 7/10)
- I am grateful that today was a much more productive day than yesterday so we have recovered a bit from the past 2 days and are getting back on track
- I am grateful that we got to eat at 2 new restaurants todayyy
- I am grateful that the frist dude was willing to give us free ice for our coffee heheh

7/19/25 (Day Rating: 4/10)
- Why am I so lazy…. I literally didn’t do anything today except for eat, cook and watch movies S:DLGKJSD But I am grateful for having lazy days like this
- I am grateful for Daniel and Esther inviting us into their home today that was sweet of them
- I am grateful for sleep. Sleep is so important.

7/18/25 (Day Rating: 5/10)
- I am grateful that we woke up at noon today and got so much sleep 🙂
- I am grateful for H mart!! And then we got to try the icy melon boba shop place thingy
- I am grateful for a very very chill day today we could recover a little bit

7/17/25 (Day Rating: 7/10)
- I am grateful that we slept so well at the Hotel today this is how nights should go and how amazingly we should sleep thank u hotel
- I am grateful for making a lot of progress in terms of figuring out what exactly we are going to do next week on sacrifice day and for Andrea letting us use her office to do work in
- I am grateful for everyone always being super nice to us here at NIH thank u ppl for being nice

7/16/25 (Day Rating: 8/10)
- I am grateful for a full day at the NIH today! It is such a privilege to be able to like do research here this is crazy. And then I’m grateful for the safe travels here and fun conversation with Yoon the entire way
- I am grateful that we got to have a free lunch today paid by Minjin. But then we did spend like 35 for dinner and maybe like another 10 for coffees today so likeee there’s trade offs HAHA
- I am grateful that we got to do some oral swabs today unexpectedly to test out culturing fungi! That was honestly pretty insightful and we feel a lot more prepared about sacrifice day now

7/15/25 (Day Rating: 6/10)
- I am grateful for a full night of sleep dude we feel so so good. And then I’m grateful that we were able to help Yoon out with his swabs today and talk with him a bit he’s fun!
- I am grateful I didn’t have to drive home for my passport SD:LGKJSDG LOL
- I am grateful that we had our mini dance party in the lab today that was quite cute

7/14/25 (Day Rating: 7/10)
- I am grateful for getting to Princeton safely this morning and being able to get coffee and breakfast and everything going so smoothly
- I am grateful for the pizza party lunch and ice cream today after Arthur’s FPO and for the super fun conversations that we had during lunch today with the crew
- I am grateful that we got to see Jo today HEHEHHEEH That makes me happy and then the fact that we are still awake and alive go us indeed

7/13/25 (Day Rating: 7.5/10)
- I am grateful for umma and appa’s 29th anniversary today and to celebrate it with the Lobster dinnerrr
- I am grateful that we were able to drive home safely today and then also drive to City Island safely today
- I am grateful for church today I think Symphony is such a cute church to go to

7/12/25 (Day Rating: 9/10)
- I am grateful for a full day of exploration that is super cute. And then I’m grateful that Michael hung out with us all day today
- I am grateful for SO MANY YUMMY FOOD AND DESSERT PLACES
- I am grateful that we got to go to the aquarium today

7/11/25 (Day Rating: 8/10)
- I am grateful for safe drives to boston today without getting into a car crash hhee here’s to our longest drive ever
- I am grateful for Michael and being able to hang out with him throughout today for lunch/dinner!
- I am grateful for the Bible study we went to tonight that was honestly really fun and then also I am grateful for such yummy food that we ate throughout today

7/10/25 (Day Rating: 5/10)
- I am grateful for dinner with Tim today he is always fun to talk to as per usual
- I am grateful for lab meeting going well and getting free ooika today hheheheh
- I am grateful for being mostly productive today and interview getting done and over with

7/9/25 (Day Rating: 6/10)
- I am grateful that Dr. Graham essentially did all of the husbandry work for us today so we didn’t really have to do much and could go back to sleep
- I am grateful that we are having a really chill day today without much work or thingies to do
- I am grateful that dillon gym exists and also for free lunch/dinner cuz of David

7/8/25 (Day Rating: 6.5/10)
- I am grateful for Whole Foods and that fresh fruit taste so yummy life is so good cause fresh fruit taste yummy
- I am grateful that our volunteer shift at the food pantry was lowkey chill today
- I am grateful that there was no lab today so we could relax a lil bit

7/7/25 (Day Rating: 7/10)
- I am grateful that I think I just got a friend back??
- I am grateful for a full full day at the lab today. Literally started at 5am and ended at 7pm full day. So it’s a blessing to be busy
- I am grateful that it is always fun to talk to our lab crew and get closer with them they are so fun

7/6/25 (Day Rating: 6.5/10)
- I am grateful that we got to wake up at noon again today. Weekends are so nice
- I am grateful for Firestone library, for dillon gym, for Yeh dining hall, and for my bike. All are essentials.
- I am grateful for finding Shane Gills on Netflix this comedy special HAHHAHA

7/5/25 (Day Rating: 6/10)
- I am grateful for free lunch today and then for it being a super duper chill day in Firestone and dillon. I like chill days like this
- I am grateful that we just took a look at the SF schedule for next week and there is very little for us to do which means that we can start locking in for other things kinda sorta
- I am grateful that we are able to enjoy Princeton like this without having to run around like a mad man.

7/4/25 (Day Rating: 6/10)
- I am grateful that we got to take another fire nap after husbandry today. It’s good to be able to balance sleep with doing lab work
- I am grateful that Rebekah let us do our essays in her room today we were honestly decently productive which is something that I am happy for
- I am grateful that we get to have our fourth of july BBQ with other manna people!! Super cute, super fun

7/3/25 (Day Rating: 5.5/10)
- I am grateful that we got to wake up whenever we wanted today because we didn’t have to wake up at an ungodly hour for husbandry
- I am grateful that we were able to eat lunch with ourselves today haha and then talk to Joyce for a little bit it is nice seeing her
- I am grateful for doing laundry today and learning that it takes literally forever to finish

7/2/25 (Day Rating: 6/10)
- I am grateful for the nap that we got to take after husbandry today omg it was so so nice and we woke up at noon
- I am grateful for a free lunch today due to David 🙂 THANK U DAVID I am very very grateful for him
- I am grateful that we finally found the time to hit the gym today it has been quite the hectic past month so I am happy that I finally get to go back gymming I missed it.

7/1/25 (Day Rating: 7/10)
- I am grateful that we honestly weren’t dying of tiredness today despite starting our day at 5:15am without a nap that is something that I do not know how we did
- I am grateful that we got to learn how to catch the mice from the traps, gavage them with worms, and spend the entire day with the lab crew! Honestly a lot of fun
- I am grateful that we got ooika with everybody and getting along well with Jenny, Chloe and Zehao

6/30/25 (Day Rating: 6.5/10)
- I am grateful that we got to volunteer at Arm in Arms food pantry today again and meet some really fun people in Hudson. They all have such personalities and the old ladies called me strong which made me laugh
- I am grateful that we got to learn how to set mice traps today! What an interesting skill to learn
- I am grateful that we got to play with Kaju he’s such a friendly doggo and also that our lab crew is very fun to hang out with

6/29/25 (Day Rating: 7/10)
- I am grateful that we were able to go to King’s today for church and spend time with David and Rebekah and Brian and Dowon and Alexis and it was really good to just go to church today and recenter ourselves.
- I am grateful that we got to watch the rest of Squid Game today with AMYSSHIII and then Gabby and Chae too! So exciting so fun and I am happy I get to do it with people
- I am grateful that David is willing to give us his prox throughout his mission trip this is so clutch omgomgomg

6/28/25 (Day Rating: 6/10)
- I am grateful that today was honestly a pretty productive, relaxing, reset day. It included doing a lot of cleaning, washing dishes, cooking food, grocery shopping, hair cutting, driving, eating, and napping, and all of these things are something to be grateful for
- I am grateful that today is Saturday which means that we woke up at like 1:20pm today and there were no consequences
- I am grateful that that we have a car on campus cuz literally none of that would have been possible w/o a car

6/27/25 (Day Rating: 9/10)
- I am grateful for being able to take a 12 minute nap that was super duper refreshing after we had to wake up super early for husbandry today and do counting of viable eggs forever
- I am grateful that we get to hang out with Amy and Lindsay today YYAYAYAYYAYAY we went to insomnia cookies and then played nintendo switch at colo and the talked until like 4am it was super cute
- I am grateful that we were able to have a 1/2 of Squid Game watch party w Chae and Gabby and Amysshi today it was sm fun and I’m so excited to do this on Sunday again to finish off the season HEHEHEH

6/26/25 (Day Rating: 7/10)
- I am grateful that today is umma’s birthday which means that umma was born 29 years ago HEHEHHE but yes I am grateful for umma and even though we might not get along too well at the moment she is still my umma
- I am grateful that we were able to have a heck of a lot of sleep since even though lab “started” at 10am we could basically pu when needed
- I am grateful for dinner with the family which was very yummy, good cake, good food, and safe driving both there and back

6/25/25 (Day Rating: 7/10)
- I am grateful for taking 2 separate naps today HEHEHEHE that was honestly like so helpful for our productivity and sanity today. Woke up for husbandry work, nap, woke up for Arm in Arms volunteer shift at food pantry, nap, woke up for mice release HEHHEE so much naps
- I am grateful that we got to have fun conversations with Yoon in the car ride today and the fact that our group is getting closerrr
- I am grateful that our meal prep is actually so so yummy and healthy too I rly like meal prepping

6/24/25 (Day Rating: 6/10)
- I am grateful that we have the van back today which means that we can just drive to work with Jenny and Chloe so that is p easy and then also we got free lunch today at CAF which was great
- I am grateful that we have CJL for free coffees omg this is so amazing and then we learned that we can get free ice from Frist so perhaps we can use that! And then I am grateful that we basically didn’t have to do any work in lab today and could just prep for the Kira
- I am grateful that we got to pet Kaju today and then also we are getting back into chess which is pretty fun so I am grateful for chess fun.

6/23/25 (Day Rating: 7/10)
- I am grateful for dinner with Kevin today!! And I’m so happy that he was willing to be very open and buy us food too HEHHEE THANK U KEVIN
- I am grateful that we got to have cake at the Graham Lab meeting today honestly twas very very cute
- I am grateful that we were able to do so many fecal floats today so we have a pretty productive system going on there and then that our meal prep plans are turning out well

6/22/25 (Day Rating: 5/10)
- I am grateful that we got to hit the gym and go to Firestone today both of which I think are places that we really enjoy being at over the summer
- I am grateful that we did some prep for our Kira test today so go us! Productive but we gotta really start locking in for that
- I am grateful that we got to go shoppinggg and eatinggg and doing pretty chill things here. I like this it is good for us to be relaxed and doing normal work. But honestly this is taking a lot of time idk if we are gonna be able to do this during school…

6/21/25 (Day Rating: 5/10)
- I am grateful that we got so so much sleep today that was so amazing HEHEHEH like I woke up at 2pm today and then I took another nap from 9-11… way too much sleep
- I am grateful that we got to have our dship with Daniel today and then call with Michael/Jocelyn and the umma too so all of that was really great
- I am grateful that we got to go grocery shopping today and each yummy lunch and dinner

6/20/25 (Day Rating: 7/10)
- I am grateful that we got to watch the live action of how to train your dragon today with all of the manna people that was super fun! And then we watched Iron man with Amy and Min today too so I enjoyed that a lot as welll HEHEHE
- I am grateful that we were able to have a productive day at SF today and then really learn how to do the fecal floats pretty efficiently
- I am grateful the AC IS WORKING AGAINNNN

6/19/25 (Day Rating: 8/10)
- I am grateful for Amy and Lindsaysshi and being able to play with them for 5 hours today that was fun and yum dinner!!
- I am grateful that we were able to cook chicken for 4 hours today and then also we did our laundry and cleaned so that is all productive of usss
- I am grateful that we had juneteenth off for today so there was no lab work for us to do

6/18/25 (Day Rating: 6/10)
- I am grateful that we were able to help out at Arm in Arms today that was honestly a really amazing volunteer session and I am grateful to have been a part of it to pack and deliver food
- I am grateful that we were able to release the mice today that was super duper cute and then that Sam is so much fun to talk to and apparently she only came in a month ago?? She seems to like really know her stuff
- I am grateful that we were able to try out a new restaurant today! PureGreen (although it was not really amazing I would have probably preferred chipotle).

6/17/25 (Day Rating: 4/10)
- I am grateful that we honestly didn’t have much to do at the lab today so that’s cool. We learned how to pipette better so there’s that LOL
- I am grateful that we had a late meal burger today quite the yummy burger
- I am grateful that we were able to work out with Aji today cool cool and I’m grateful he reached out.

6/16/25 (Day Rating: 7/10)
- I am grateful that we were able to drive everyone to Stony Ford today safely and we learned more about how to keep the mice set up and safe. Like we set up the food, water, RFID’s, we put gravel and drove the mini cart thing which was super cute LOL but lot’s of manual labor
- I am grateful that we ate the lunch that we prepped and it was GAS. Like there was samgyupsal, kim, kimchi, bab, doobo, this is fo funny writing these english romanizations for korean food HAHHA
- I am grateful that we were able to hit the gym and take a FIRE nap today both of which were very much needed to feel like we are getting our life back on track

6/15/25 (Day Rating: 5/10)
- I am grateful that we were able to get home safely, sleep well, and surprise appa for Father’s day that was quite cute and he was very very happy to see me. So I am grateful for him
- I am grateful that we got to see Josh at church today and then also that we were able to grab a family lunch for Father’s day at church today
- I am grateful for a safe drive back to Princeton and also that umma and appa bought us so so many groceries so we don’t have to spend the time someday buying even more groceries.

6/14/25 (Day Rating: 6/10)
- I am grateful that we were able to sleep for SO LONG today so we caught up on all of the sleep that we missed over the past week from running around like a madman. And then also I am grateful that we were able to have a pretty chill day today by just like cooking and doing laundry and such
- I am grateful for the praise night that we had with Bensen, Justin and David at NCW coffee club that was honestly really amazing and beautiful and I am glad that those dudes hosted it. And then I am grateful that we got to have a safe drive back home for Father’s day
- I am grateful that we were able to meet with Daniel today for our dship meeting with him and then also I am grateful that Jamil repaid us for doing his temperature experiment by giving us free DINNER HEHEHEH

6/13/25 (Day Rating: 8/10)
- I am grateful for getting ice cream with Rebekah today and then also we got Mcdonalds with her too HEHEHE and it was cute volunteering at YoungLives today and playing with all of the kiddos. Albeit a bit tiring.
- I am grateful that we were able to get a productive work day in with a bunch of data entry and then we also learned how to handle and scruff live mice!! So that’s kinda cool
- I am grateful that we were able to eat LATE MEAL BURGER LOL IT’S WAS SO TASTYYY.

6/12/25 (Day Rating: 7.5/10)
- I am grateful that today was a very very full day of doing things it feels crazy that we are able to do so much in one day at Princeton like what the what. And then I am grateful for being able to see Tim and Marvin today and get FREE DINNERRR
- I am grateful that apparently the lovely folks at NIH are going to be doing my culturing of bacteria and fungi too?? Like wait what am I even doing for my thesis then if they’re doing my sequencing and culturing LOL. But will not be complaining at all
- I am grateful that we were able to do data entry, lab orientation presentation and tour of the space, meeting with Julie Segre and NIH collaborators, graham lab meeting, van inspection, and then playing MARIO KART 2 ON THE NINTENDO SWITCH W TIM AND MARVIN!!! And then lowkey playing the sports game like volleyball was pretty fire too

6/11/25 (Day Rating: 8/10)
- Literally Cynthia made my entire day better just by seeing her. I AM SO GRATEFUL I GOT TO SEE CYNTHIA TODAYYYY!!! AHHHHH what a pleasant surprise and I am so grateful she is doing well and being a middle school teacher and that we got to see her at the BBQ today. And then I’m grateful for the free food at the BBQ too HHEHEHE
- I am grateful that we were able to volunteer at arm in arms today at the food pantry that was exciting. And I am grateful that we got to feel like we are doing meaningful work today there too and helping and not just standing around doing nothing LOL
- I am grateful for another productive day in the lab where we learned what the heck hesca is and then also how to isolate plasma from the blood. We are learning a lot this summer. Like also how to mail things to the post office???

6/10/25 (Day Rating: 7/10)
- I am grateful that we were able to have a full day in the lab today honestly from 10-5pm is a long time to be there with an hour of lunch in between. But we did learn a lot: we saw how the mice are bled and how ear swabs are taken and how pellets just pop out of the mice so these were all very informative thingies
- I am grateful that I have super duper cute friends here. And then I’m grateful that the casper test is done and over with now
- I am grateful that we were able to grab halal food at the end of the night so that was quite yummy and then I’m grateful that we were able to prep 2 really tasty beef meals.

6/9/25 (Day Rating: 6/10)
- I am grateful that we got to have a full day at Stony Ford today. Basically a 10-5 without lunch but we learned a lot about handling mice and getting the mice and weighing the mice and then David is honestly a really fun/cool dude to talk to. I love how approachable he is despite being a post doc
- I am grateful that we were able to grab dinner with Boya todayy! FREE DINNER WILL NEVER BE TURNED DOWN
- I am grateful that we were able to have a pretty chill day with not too much work. But we kinda gotta lock in for casper now.

6/8/25 (Day Rating: 6.5/10)
- I am grateful that we got to go to the gym for a solid hour and a half today and then did a lot of productive work like file completionss YAY
- I am grateful that we are able to get the netflix log in from appa today and he said that he loves us so that makes me happy. I like my appa. And then josh is being supportive to so I’m grateful for him as well
- I am grateful that we were able to MUNCH on the food we prepped on Wednesday, I think that this meal prep plan is going quite well HEHEHE

6/7/25 (Day Rating: 8.5/10)
- I am grateful that we were able to find a good life hack for when laundry is running. There’s literally a treadmill right there, so while you wait for literal hours you can just use the treadmill to get ur steps in so I am grateful for that and also we can watch movies while walking!!
- I am grateful that our lunch today was honestly pretty fire. Hot dogs and burgers were very yummy and they were free too since it was from yesterday’s haul HEHEHE
- I am grateful that we are going to get Teresas with Amy and Lindsay today I hope that they are doing well and I am very very excited to see them. TERESAS WAS FIRE AND THEN WE WATCHED SNOW WHITE W EVELYN AND JOYCE AND AMY and then we also talked in Joyce’s room for like 3 hours this was sm fun

6/6/25 (Day Rating: 6.5/10)
- I am grateful that so many people are reaching out to hang out with us it makes me feel happy and connected. Thank you friendsss.
- I am grateful that we were able to make a lot of progress on understanding this application process
- I am grateful that we are grabbing chipotle with Jamil today! And also for being able to call Michael and jocelyn today that was very cute too

6/5/25 (Day Rating: 6/10)
- I am grateful that Daniel agreed to disciple us over the summer. We really need to learn how to grow in our faith before the start of next year
- I am grateful that we honestly were functioning pretty well today despite sleeping for only 3 hours last night. Yesterday was honestly quite brutal
- I am grateful that we were able to take a really long walk today to process things…

6/4/25 (Day Rating: 6.5/10)
- I am grateful that we got our ice cube tray todayy!! Hehe it’s the small things to be grateful forrr. And then we also set a day to hang out with Lindsay and Amy today so that is cute and something I am grateful for too
- I am grateful that we got to cook so so much food today and did a lot of cleaning/organizing/prepping for food HEHEH
- I am grateful that we got to listen to so many podcasts today. Princeton over the summer is so great

6/3/25 (Day Rating: 7/10)
- I am grateful that we got to hang out with AMY TODAYYY that was fun and cute and we went to sushi and H mart so super fun
- I am grateful that we got to go to Stony Ford for the first time today and learn a lot about what we will be doing over the summer
- I am grateful that we were able to drive Dr. Graham today and we were super duper safe with that drive so we didn’t end up scaring our PI/Prof S:DLGKJSDG

6/2/25 (Day Rating: 7/10)
- I am grateful that we made 3 meals for ourself today and ate all 3 meals for ourself today and they were all such yummy meals for ourself today wow. We are adulting so hard
- I am grateful that we were able to learn a lot about mouse stuff for our thesis today and that our meeting with Yoon went well and the van stuff went well and the onboarding meeting went well and we are making progress into the person that we want to become so this is all something to be grateful for
- I am grateful that Princeton really brings out the best in us. Like just being here brings out the best in me.

6/1/25 (Day Rating: 6.5/10)
- I am grateful for APPA’S BIRTHDAY!!! We got to eat very yummy food with the entire family and spend basically the entire day with umma appa Josh and Joey so that was something to be grateful for. And then also we are grateful that we were able to see the entire rest of the family too on appa’s side like Soogomo and Lauren Gomo and 할아버지와 할머니
- I am grateful that we were able to bring all of the thingies that we needed from home back to school today like the fridge/car/coffee machine/rice cooker/ice cream maker… damn u r spoiled SD:LGKJSDG I am grateful to be spoiled
- I am grateful that we were able to go to church today and see church people today and then that we got lunch at Fireside today and spent a very yummy day today

5/31/25 (Day Rating: 6/10)
- Grateful that the train ride home went well today and we coincidentally saw Marvin on that ride back! So that was nice catching up with him
- I am grateful for lunch and dinner with the family and Brooke was there too so that was all cute
- I am grateful that we were able to go to sleep really early today (at like 8) I think we have officially fixed our sleep schedule

5/30/25 (Day Rating: 7/10)
- I am grateful to have tried out Nassau Diner!! Look at us adding so many restaurants to our beliii
- I am grateful that we made a lot of progress on our essayss
- I am grateful that we got to watch Lucy today that was a p fun movie too so many movies this summer. I WANNA WATCH MY MOVIES W AMY SSHI

5/29/25 (Day Rating: 6.5/10)
- I am grateful that we finished our essay in the morning which honestly we are pretty proud of so I am happy about that
- I am grateful that we got to try out Thai village today and so we added another restaurant to our beli
- I am grateful that we got to watch a movie today. Behind Enemy Lines is p fun and so captivating omg. And then I’m also grateful for gym

5/28/25 (Day Rating: 7/10)
- I am grateful that today was honestly so so productive and we are getting a lot of work done back at school like this is why Princeton is amazing it brings out the best in me
- I am grateful for the first gym day in a pretty long time and it was a productive gym day too. And then Strong has that new app feature where we can calculate the time in between the sets??? Like that is something that I am super grateful for
- I am grateful that we got to eat at many different eating places today (since like… we don’t have groceries yet :SDG:LKSDJG)

5/27/25 (Day Rating: 5/10)
- I am grateful that our trip back to Princeton went smooth and safely. And then on the car ride here we got to talk with appa for the entire time so that was a really good conversation we learned a lot about politics/money/relationships.
- I am grateful that we got to go to costco today and buy all of the protein stuff that we need to really really LOCK TF IN for the summer physically
- I am grateful that we got to eat such yummy food today (Brooke’s dumplings are actually so fire) and then we also ate mackerel, steak, anyways just such yummy food like yesterday < 3

5/26/25 (Day rating: 4/10)
- I am grateful that our flight went super smoothly and the train ride to Manchester airport was safe and then the train ride from JFK to home was safe too!
- I am grateful that umma and appa cooked us a STORM it was quite possibly the yummiest meal I’ve had this year YAYAYYA I love my family
- I am grateful that we got to add a few new restaurants to our beli ratings HAHAHA

5/25/25 (Day Rating: 2/10)
- I am grateful we finished packing/cleaning cuz we outta here tmrw
- I am grateful for our stay at Manchester!!
- I am grateful that today was honestly decently productive in terms of our app

5/24/25 (Day Rating: 3/10)
- We literally stayed in our room the entire day to just scroll on youtube, go to sleep, cook food and then work on our apps. Did not enjoy it very much
- I am grateful that ppl are asking how our England trip is that is cute
- I am grateful that we are learning how to cook more diverse foods hehe

5/23/25 (Day Rating: 7/10)
- I am grateful for our last day at UoM going well and us pretty much making progress on our app so that was nice. We didn’t really do any thesis research or anything so good on us!
- I am grateful that we got to visit the John Rylands library today and that our eduoram wifi works here and so we could just do work in probably the most aesthetic library that I’ve ever seen in my entire life
- I am grateful that we were able to eat our Korean lunch today at eat goody again with the bibimbap and the soondoobu that was nice and even though it’s not like AMAZING korean food, it’s def 100% better than any other food in the nearby vicinity.

5/22/25 (Day Rating: 6.5/10)
- I am grateful that we got to wake up early today and then go and finish uploading all of our pictures to this gratitude journal heheh. And then I am grateful that we were able to try out Eat Goody (the Korean restaurant) FINALLY at long last it’s crazy that it took this long to try out but honestly the food was pretty decent
- I am grateful that we were able to learn a lot from Dr. Konkel as to how to measure the periodontal bone loss from these mice. Like how to cut them in a way that doesn’t break their skulls and such. And then I’m grateful that Tom let us practice a bit more about swabbing and taking rinses of the mice. Productive stuff which will be helpful back at Princeton!
- I am grateful that we are honestly doing pretty well with exploring England and gaining as much new experiences as possible here. It’s a pretty nice vacation before we gotta go back home and LOCK INNN

5/21/25 (Day Rating: 6/10)
- I am grateful that we got to try our 4 new food places today to add to our beliii (even though every last one of them were pretty bad. Why is food here so bad. Why can’t food here be good. What the heck.)
- I am grateful that we made so much progress on our Senior Thesis…. (bro I was gonna say progress on our JP but JP is done what the hecking heck). But anyways yea it’s cooking I got so much progress happeninggg
- I am grateful that we were able to look at all of our gratitude journal entries today and fill in photos as needed

5/20/25 (Day Rating: 5/10)
- We had a solid learning day at Manchester with practicing swabs on the dead mice, asking a bunch of questions to Dr. Konkel, doing a lil talk at the lab meeting (konkel koffee is so funny), and then we tried out 2 student restaurants today for lunch, both of which sucked. But anyways we learned a lot about growing bacteria on plates today so much so that I am pretty confident I can do it back at Princeton.
- I am grateful for being able to take a 2 hour nap that was honestly like perfectly timed after we ate our lunch and then when Dr. Konkel came to get us. Like I was SUPER duper embarrassed since that nap was not supposed to take that long and I had no clue if Dr. Konkel tried to find us only to see us completely knocked out but it all worked out in the end so I am glad about that
- A- IN KOREAN!!!! Quite possibly the hardest I’ve worked for an A- in my entire life. And then we got our A in 314 too so both of those worked out in our favor (and then also look at the breakfast we cooked for ourself this morning it looks so healthy and was so yummyy!!)

5/19/25 (Day Rating: 6/10)
- I am grateful that we were able to wake up super early this morning and enjoy a good breakfast with egg and chicken while watching the big bang theory. That was a good way to start off the day
- I am grateful that Dr. Konkel showed us a lot about swabbing today and we got to see some cool mice stuff and then we also learned about how to make the plates for the bacteria and such so that was helpful
- I am grateful that Pastor Sam really came in clutch for us just now with the S.B. rec fiasco that we figured out just now

5/18/25 (Day Rating: 5.5/10)
- I am grateful that we explored lots of places today like the Manchester cathedral, the football museum, the imperial war museum, there was this protein restaurant?? And then we also ate out a bit, bought tea for Amy (and also tasted probably the best tea of our entire life)
- I am grateful that we are learning how to cook for ourself for the most part and lowkey the macros are pretty fire so this is good
- I am grateful that we were able to take lots of naps and rest and also we got all of the brainrot out of our system. From here on out no more.

5/17/25 (Day Rating: 3/10)
- I am grateful for sleep. I think I slept a total of 16 hours today dispersed in random time intervals. Like I woke up, and then made food, and then slept, and then woke up to take a shower and eat more food before sleeping again. And then guess how I finished the day? I slept.
- I am grateful for ramen. We had 2 packs today with a total of 6 eggs and 2 chicken breasts inside the ramen LKJLKJ:LKSDJG why are you going back to ur high school habits.
- I am grateful for brain rot and instagram and tik tok and damn we were on our phone so much.

5/16/25 (Day Rating: 4/10)
- I am grateful for short day in lab today. Just counted bacteria on a plate so that was quick and easy but tbh idt Kelly likes me very much LOL idk what I diddd but she is very much avoiding talking to me
- I am grateful for cookies + coffee!! Insomnia was quite mid however and I dropped my matcha
- I am grateful for umma and appa calling todayy. It is cute to talk with umma and appa.

5/15/25 (Day Rating: 6.5/10)
- I am grateful that Kelly showed us a lot about mice today to say the least :DSLKJG apparently you just chop off the heads with scissors, and then you get a scalpel and literally shave off all of the fur, and then you cut straight down the middle of the head to get the two halves, then you pull out the tongue since that’s in the way, and then with each half of the head you then cut horizontally so you have top and bottom, and then with the top you can either keep on cutting everything around the gingiva or you can just flat out use it for calculating bone :SLKJGSDG
- I am grateful that we were able to try a bunch of new restaurants today and that they were all very new experiences. Of course, to say the least they weren’t that yummy, but they were in fact new
- I am grateful that I was able to go to sleep after our 6 hour nap LOL

5/14/25 (Day Rating: 7/10)
- I am grateful that we were able to enjoy really nice weather exploring the UoM today and then we bought like… the most fire merch ever?? I actually love this lil jacket
- I am grateful that Josh taught us a lot today and it was honestly a really productive time at the lab today where we learned a lot. I am also grateful that we got our Student ID all sorted away
- I am grateful that we had our shin ramen for the first time in such a long time today. GRATEFUL FOR SHIN RAMENNNN AHHH

5/13/25 (Day Rating: 6.5/10)
- Today would have honestly been like absolutely and utterly amazing if I wasn’t so friggen tired… This is my first all nighter since like, lowkey forever but we honestly did make a lot of progress on our thesis research and got to meet a lot of super adorable and friendly people so I am grateful for them in the Konkel lab.
- I am grateful that we are literally at the University of Manchester right now and that it is so pretty and that the weather is so nice and that we get to enjoy the country that is England right now
- I am grateful that we managed to get to the air BNB safely, we managed to get the the konkel lab safely we got to do everything very very safely.

5/12/25 (Day Rating: 7/10)
- I am grateful for Timi sushi with josh and umma today and then I am grateful that everything went smoothly in terms of making it to the airport without any hassle.
- I am grateful that our flight to Manchester went smoothly and safely and that we also got to see Xuanying at the airport and hang out with her for a little bit
- I am grateful for the fact that we are literally going abroad rn?? This is so so cool

5/11/25 (Day Rating: 5/10)
- I am grateful that we were able to spend most of the night studying w Amy today until like 3am when my eyes literally couldn’t stay open anymore so that was fun. And then we ate pizza togetherrr
- I am grateful that we got a solid 6ish hours of sleep but we aren’t like super tired going into our study session for our EEB 314 final today. And so I am grateful that we got through all of the lectures and are currently reviewing the notes
- I am grateful that today is Mother’s day and so UMMAAAA I am grateful for umma, and then I am grateful that we get to go home today after our EEB final.

5/10/25 (Day Rating: 5/10)
- I am grateful for a full night of sleep
- I am grateful for a full day at Stone (and then Korean final)
- I am grateful that we got to eat Alfaalfa today that was yummy

5/9/25 (Day Rating: 5/10)
- I am grateful that we got so much EEB studying done today. We need to finish the rest of the lectures but we honestly made a lot of progress today that I am proud of myself regardless
- I am grateful that we got to study with Jocelyn throughout the day since she came with us to Stone and so we locked in at C floor together for basically the entire day so that was fun
- I am grateful that I got to eat halal food again today… So much halal food but now I know it’s better to just get the white sauce on the side from now on instead of on top!

5/8/25 (Day rating: 5/10)
- I am grateful that Dr. Konkel is following up with us and sent the schedule and clearly cares about me not being completely lost when I do get to Manchester
- I am grateful that I am able to study with Jocelyn and Michael and then that we are being productive throughout these final few days here
- I am grateful that the Manny video was done and posted and that’s funny lol

5/7/25 (Day Rating 5/10)
- I am grateful that the Lai’s exist and that they are just super duper sweet to invite us to their home to study and also for dinner they’re cute.
- I am grateful that we were able to study today and that we got a lot of EEB 314 lecturing/organizing done 🙂 And then Dr. Simones is super quick w it I’m grateful for him a lot
- I am grateful that we ate so so much at the Manna BBQ today and it was so yummy food and then also we got an Ooika Matcha and a coffee to help us lock in and they were both very tasty

5/6/25 (Day Rating: 6/10)
- I am grateful that our meeting w Dr. Simones went okayyy hehe and then I’m grateful we got to see a lot of our EEB friends at the review sesh today (although it was not really helpful)
- I am grateful that we got a lot of progress done on our AAS paper today and also free food at guyot. Like we might as well just go there for lunch from now on
- I am grateful that we are going to go to coffee house for Manna since that is always cute and then that colo has their summer BBQ today which I am excited for too. They had fried oreos, cotton candy, MAC AND CHEESEEE. And then umma’s care package came today so I am grateful for that too

5/5/25 (Day Rating: 6.6/10)
- I am grateful that we were honestly pretty productive today and that our meeting with Dr. Belcher went well since she likes our paper topic!! 🙂 And then the fact that we thought of a paper topic today is good too
- I am grateful that we are able to go to Payge’s screening later today I am super duper excited for that. And she put in so much hard work so I am going there to support
- I am grateful that I was able to have my small world coffee today. Coffee is literally my lifeline. And then also I am grateful that we could study at Stone with James/BKook for a little bit and then that our sublease for the summer all worked our pretty well

5/4/25 (Day Rating: 5/10)
- I am grateful that we got to wake up in time to go to Jacob’s Well today that was successful of us to not miss a day of church
- I am grateful that we were able to eat brunch and take the most fire nap today
- I am grateful that we spent the rest of the day at colo just chilling and doing work basically

5/3/25 (Day Rating: 8.5/10)
- I am grateful for a lot of fun at senior banquet today there was a lot of planning going into it but I’m grateful that it all worked out well and even though it was a little bit long, it was definitely a lot of fun and people laughed at our video that we made so I’m grateful for that
- I am grateful for the seniors in Manna who I’ve spent the last 3 years with before they graduate I’m going to miss them a lot when they’re gone like especially James but I’m so happy that I got to know him and become a better person from being his friend
- I am grateful that we got to spend the entire rest of the night at colo basically just editing photos and sitting next to Amy and other colo friends that’s super fun too and a lot of non-work was done today

5/2/25 (Day Rating: 7.5/10)
- I am grateful for spending a lot of time w James today and learning from him during our lil coffee chat. Few points to remember: belief is a choice. This was kind of ground breaking to me. God’s not punishing unbelievers for something out of their control. He proved his point too: why do we believe science? We never see the actual experiments that are being conducted, we kind of blindly trust the professors telling us about things like ATP synthase b/c of their credibility, we choose to believe them without absolute concrete evidence. So when atheists say they can’t “choose to believe” in God, they seem to choose to believe in science just fine.
- I am grateful for our costco run today with Rebekah and Jocelyn that was a fun time and we got our hot doggg
- I am grateful that we got to get to go to Sean’s birthday surprise today and that we got a lot of work done on our Korean final paper (and then we didn’t butcher our quiz grade!)

5/1/25 (Day rating: 7/10)
- I am grateful that our lab meeting was honestly super informative and that we learned a lot about presentations, the experiment that we are literally doing in this upcoming summer, and a lot about how we should be doing our presentation in Manchester haha
- I am grateful that we were able to see Cliff today! That was honestly a really really great surprise. And then I am grateful that we spent an hour listening to him as well and then get colo formals photos
- I am grateful that we were able to take so many naps today and that also we got to grab dinner with Kevin and study with Jocelyn at Stone for the remainder of the day.

4/30/25 (Day Rating: 6.5/10)
- I am grateful that we were able to finally fall asleep today (at like 6) but then Jocelyn’s message to us was super sweet so I am grateful for her being there for me when I need people to be there for me.
- I am grateful that we got to go to chipotle in our car td with Michael, Jocelyn, Kevin and Anupta that was really fun and we tried the chipotle honey chicken for the first time so I am happy about that too
- I am grateful that our meeting with Dr. Graham went well and was really informative since we got a lot of progress done on our plans for the summer done during that time. So I am happy about that.
- I am grateful that PPDA is now over and also that we were able to talk to Boya today. She was super duper helpful and I’m so grateful for her.

4/29/25 (Day Rating: 8/10)
- Field trip to the museum was a bunch of fun with all of the EEB folks and it was super cute and honestly the EEB 314 instructors are a lot chiller than we thought so we should have spent the semester trying to get closer with them
- I am grateful that we got to go to Butcher 360 and then dessert with all of the Korean class folks today and SUSIE SSN and so that was a lot of fun and very yummy indeed.
- I am grateful that we were able to go back home and umma and appa gave us some yummy food and we did a quick switch of the cars today so there was a lot of driving today but I am grateful for it. And then the drive back was also so much fun, having the top down playing music 🙂

4/28/25 (Day Rating: 7/10)
- Lowkey yesterday was more objectively fun but I’m rating today higher simply because comparison is the thief of joy, and trying to just rate my day in comparison to the things I did yesterday is probably not the best way to go about it. I just feel better today. There’s nothing else to it HAHA maybe it was the sleep actually
- I am grateful that the Korean speaking exam went well and that it is done and over with
- I am grateful that we were able to edit the underclassmen video today so that was honestly productive of us and it was really fun work too so I am grateful that I am able to do fun work

4/27/25 (Day Rating: 6.5/10)
- I am grateful that we were able to get a huge chunk of our JP done today so that was productive of us and so I am grateful for that : )
- I am grateful that we got to work at Stone with Jocelyn and Michael today and then we worked at Stone with Christine at the end of the day too
- I am grateful that I was able to go and eat dinner at the Lai’s house today that food was like the cutest meal ever and philo is the cutest dog ever

4/26/25 (Day Rating: 6.7/10)
- I am grateful for colo formals today and eating 3 lobsters and steak since that was so so yummy and then the dessert was fun and then it was a very interesting performance with the hoola hoop girl
- I am grateful that we got some solid progress on our JP done today
- I am grateful for tacoria during lunch time and then also for John Sherk since we got to go to his farewell party today

4/25/25 (Day Rating: 5.5/10)
- I am grateful that the elementary school visit went okay and that also we were able to our Korean individual session by rescheduling it so so late last night. But yes, we are officially done with the second semester of junior year classes so I am grateful that this is done and over with.
- I am grateful that we were able to talk to Amy today and hang out with her during our AAS class by visiting HEHE and then also that they were giving free SC house so that was kinda fire ngl
- I am grateful for life. Honestly it’s interesting to think about: life can really end at any time, there’s some people we just might never see again, and I think I take that for granted way too much. I guess there’s only one thing that we can do. It’s cherish the ones closest to us, take pictures to record these memories, reconcile/forgive past grievances, and just remember to be grateful. Life’s a gift. It’s honestly beautiful in all of its forms. And to take that for granted has been a mistake that no one can afford to make.

4/24/25 (Day Rating: 6.5/10)
- I am grateful that we went to our final GHP precept and our final EEB 314 lecture so I am proud of us for going to those classes all throughout the semester. And I am grateful to officially finish everything related to GHP so now we are done with that class YAY
- I am grateful that we were able to see Evelyn and grab lunch with her at colo todayyy and then I am also grateful that this weather is literally beautiful and amazing and wonderful and it makes me happy
- I am grateful that we got to see/study with Rebekah at Stone today and that dinner at colo with the pizza rolls was fire w Jocelyn + Nick, and then also we got to take the most relaxing nap ever at Stone so that was really nice

4/23/25 (Day Rating: 7/10)
- I am grateful that we were able to study for our Korean exam for the majority of the day and even though we kind of bombed some of it, it’s alright and it’s done and over with and since Daniel cancelled our tutoring session honestly I’m grateful to have another hour freed up in our day
- I am grateful that we were able to sit next to Payge throughout the entirety of GHP this year and then also that we were able to see evelyn at GHP lecture today??? wowowow
- I am grateful that colo’s dinner looked absolutely fire and we are so excited. And then the Tiramisu tasted rly good and we ate dinner w all of our friends so that was fun and then we spent the rest of the day just editting the senior video with Jocelyn/Michael/Christine!!

4/22/25 (Day Rating: 7/10)
- I am grateful that the pig lab practical went smoothly and that we didn’t have to stress too much about it and that it was decently easy HEHEHEH yayayay
- I am grateful that we were able to interview April for the senior video today and that the interview went very smoothly
- I am grateful for the buffalo chicken mac and cheese at Guyot today that was literally so fire and then I’m grateful that we are being productive here at school YAY (korean studyingg) And then I am grateful for yummy colo dinner and also for studying at Stone w friends for the rest of the night

4/21/25 (Day Rating: 6.5/10)
- I am grateful that we were able to study a lot today and get a lot of the biology fetal pig thingies knowledge into our brain.
- I am grateful that the thesis funding all worked out on my end so that makes me grateful and happy
- I am grateful that we got to have lunch with Tim and Payge today and that we were able to study with them after class ended 🙂

4/20/25 (Day Rating: 5.5/10)
- I am grateful that we were able to see Josh today before we went to church and that we were able to go to church today
- I am grateful that we were able to grab our Easter dinner with the entire family like Josh, Umma, Appa, Joey, And all of Appa’s family side and then Brooke too that was a good dinner and I enjoyed it a lot.
- I am grateful for safe travels back home and for the fact that we were able to grab Halal guys bro that place is absolutely fire I am going to go there from now on for ALL HALAL RELATED FOODSSS

4/19/25 (Day Rating: 6/10)
- I am grateful that we were able to grab Ooika with the JSG squad today that was super great and then that lunch was pretty yummy today at colo too and we got to spend some time with Amy before going to JSG 🙂
- I am grateful that we had a safe travel back home today and saw our entire family
- I am grateful that we were able to watch king of kings at the movie theater with umma and joey and then that we played cs go for like 3 games straight HEHE

4/18/25 (Day rating: 7/10)
- I AM GRATEFUL FOR THIS AMAZING WEATHER and I’m so happy that it was so warm outside so that makes us happy. And then I am grateful for good Friday and that we were able to just chill for the entire latter half of the AAS class today since the prof just didn’t rly wanna do anything
- I am grateful that we got to spend time with Payge today and go with her to the GHP Colloquium and then also we did our laundry today so that’s one thing out of the way. And then I am grateful that Andrew bought all of us SC house today!! So yummy
- I am grateful that we are able to serve at the Good Friday service! I need to be grateful also just for the fact that Jesus literally died on a cross for me and I need to really remember that

4/17/25 (Day rating: 7.35/10)
- I am grateful that today we were pretty productive and went to all of the meetings that we needed to like our GHP precept, EEB lecture, Korean individual sesh/class/PPDA meeting so that was all fun and enjoyable and I am happy that we were able to do all of that
- I am grateful that we got a lot of work done today so good on us. We worked on our paper, Korean writing, our GHP thingy, many many things that we were productive on today so go us
- I am grateful that we were able to have a lot of fun with our friends today and had dinner with Boya/Nick and then studied at Stone with Michael, Michelle, and Jocelyn today so all of that is cute and I am grateful for my friends.

4/16/25 (Day Rating: 7/10)
- I AM GRATEFUL FOR SO MUCH YUMMY FOOD IN COLO TODAYY there was like so much multicultural food and I loved every single bite of that and then also I’m grateful for Kevin Yang’s birthday today
- I am grateful for all of my friends that we were able to grab dinner with and then also for the course selection for next semester going very well 🙂
- I am grateful that we were able to get a lot of our paper rewrite done! So good on us for that I am proud

4/15/25 (Day Rating: 7.5/10)
- I am grateful for being able to not have EEB lecture today and instead be able to interview Irene/talk with Celine/lunch with Evelyn/Joyce! So much fun things that could be done if we didn’t have to go to lectures LOL
- I am grateful that we were able to dissect our fetal pig today and then we saw Payge on the way out of lab so that was a super duper cute surprise I love seeing Payge around she makes me happy and then laughs at my jokes
- I am grateful that we were able to interview Joe today for senior banquet and also dinner with Daniel!! So many things to be grateful for, so many people to be grateful for.

4/14/25 (Day Rating: 7/10)
- Solid day today I am grateful that we were able to be decently productive today, learned a lot of Korean, but then bro we ate SO MUCH CHOCOLATE CAKE and it was the yummiest thing colo has ever had but then it was way too much food so we were bloated afterwards. I enjoyed the convo we had w Kevin/Michael tho
- I am grateful that we were able to eat lunch with Payge and Tim todayyy and then GHP with Payge is always fun and productive bro we always get so much work done when we are sitting in GHP LOL
- I am grateful that we were able to see Katherine/Joy/James at Firestone today and then Mia giving us coffee gave us 2 hole punches instead of 1 HEHEHE she is so sweet

4/13/25 (Day rating: 7/10)
- I am grateful that we woke up in time for church and were able to give Michael, Eleanor, Cecily and Daisy a ride to church today (we should make this a habit from now on. Write the names of everyone you give a ride to church so that we do not forget who we are driving). And then I am grateful that the sermon was honestly really good it was about wise decision making
- I am grateful that we were able to take the FATTEST nap every and then also for grabbing matcha (ooika!!) with Amy and Lindsay todayyy super duper cute
- I am grateful that we were able to do some work at Firestone today and be productive and then have so much fun at dinner today with Michelle, Michael, Tiffany and BRYAN WANGGG Asian Bistro was so yummy and then the frozen yogurt was yum too super cute super nice I’m happy.

4/12/25 (Day Rating: 9/10)
- I am grateful that we were able to transfer all of our computer data from our old macbook to our new one despite the screen breaking so thank u digital learning lab people and Rayaan for helping me w that. And then I am grateful for brunch w Kevin Yang today!
- I am grateful for being able to see six14 and support the kiddos and then also buy them flowers are Wegman’s with Michael and Michelle so that was cute and then also I am grateful for the lil nap that we had before it HEHEH
- I am grateful that we got a lot of random non-important work done today like laundry and eating and picking up food for people like dinner for six14 and then posting 100 posts on our finsta!! And then I’m grateful for seeing all of the alumni at the six14 show like Grace FLORES WHAAA/Michelle Huang/Michelle Wang/Bryan and then having a lot of fun with them at the six14 afterparty

4/11/25 (Day Rating: 7/10)
- I am grateful for being able to grab lunch with Daniel today and seeing that he is doing okay that makes me happy. And then I am also grateful that Kim ssn let us come to our individual Korean sesh super duper late and be generous about it
- I am grateful that our AAS class was honestly a lot of fun and pretty interesting and that we were able to go and get our haircut today and it be not too bad of a haircut
- I am grateful for seeing Six14 show todayyy AND THEN the alumni were there like Katherine and Joy and Ellie so that was super duper cute

4/10/25 (Day rating: 6.5/10)
- I am grateful for finishing EEB lecture early today it was super quick and only like 40 minutes so that makes me rly happy cuz we were able to do our meal exchange w Jamil today
- I am grateful for our meeting with Dr. Belcher honestly went really well today and we are working on a paper idea that she seemed to like so I am grateful for that
- I am grateful that we were able to see PAYGE TODAY and then that Jocelyn was in A floor so that’s fun. But then there was so much spontaneous thingies that happened today like the EAS cultural festival and we saw a lot of cool performances, then we had boba from SHARE and got a pizza, then we ate dinner w like Chris/Will and then we went to a pink party at Yeh?? So much spontaneous activities since we planned literally none of that

4/9/25 (Day rating: 7/10)
- I am grateful that we got to have lunch with Tim and Payge today (i love them so much they so cute) and then dinner w Celine today we had a good conversation w both of them
- I am grateful that we got to get a lot of GHP work done today and then we finished Korean class today and my class is so cute, but we really gotta lock in more
- I am grateful that we were able to have our meeting w Dr. Belcher and that Tim was willing to call us for a favor it’s nice to feel needed LOL

4/8/25 (Day Rating: 6.5/10)
- I am grateful that we got our stupid bio exam done and over with and we don’t have to worry about that anymore for the time being so let’s breath for a lil while
- I am grateful that we were able to study ALL morning and so that was really productive of us. And then we got to go to both of our meetings afterwards so yay 🙂
- I am grateful that we got to brain rot for a little bit to reward ourself on colo’s couch!

4/7/25 (Day Rating: 5.5/10)
- I am grateful that Appa bought us our new macbook today and we are currently doing work on OUR NEW FRIGGEN MAC BOOK that is so exciting
- I am grateful that we got to do everything that we sort of kind of needed to do today like the Korean presentation, pick up our new computer, and our GHP class (and then we had a good lunch and dinner)
- I am grateful that we were able to take the fattest nap every so that we could clear our mind and lock in (and then also that we were able to find our airpords and didn’t lose them HEHEHEH).

4/6/25 (Day Rating: 6.5/10)
- Basically today was so much non-academic work but I am grateful for it. I am grateful that we were able to go to church this morning and bring people, it’s a privilege to be able to serve my fellow students like that in driving them to church 🙂 And then I am grateful for listening to the sermon today about not being lazy
- I am grateful for the fire nap that we took in the colo beanbag room today and that the blankets are so soft dude I love these friggen blankets and then I am grateful that I was able to interview Matthew today for the senior banquet thingy he is so sweet
- I am grateful that we got to eat both brunch and dinner at colo today since that is super duper nice and the food is always just yummy here.

4/5/25 (Day Rating: 7/10)
- I am grateful for today because it was a productive day! We were able to go to JSG and ask some tough questions to Esther and then also we were able to hit the gym too and then have a good conversation with Sam over lunch today so I enjoyed that a lot
- I am grateful that we were able to finish our Korean presentation slideshow and the case study thingy today and then do laundry too that is all super nice
- I am grateful that we were able to spend the latter half of the day just studying for bio and catching up with dat.

4/4/25 (Day Rating: 6.5/10)
- Finished our AAS paper and did our presentation in class so that worked out okay and I am grateful that it worked out okay
- I am grateful that we got to grab lunch with Charlotte today and then dinner with Marvin today so that was pretty cool!
- I am grateful that we were able to wake up early today and enjoy a coffee and go shopping with Jocelyn todayyy

4/3/25 (Day rating: 7/10)
- I am grateful for Korean individual sesh going well and that we were able to spend time with Amy, Payge and Jocelyn today so that is all super cute and so much fun and I love them and then also Morgan helped clean out lil water spill which was the cutest thing over omg why is she adorable SDL:GSDKLGJ
- I am grateful for having a lot of fun in GHP precept today since the documentary was honestly really interesting and then being productive during EEB today by writing korean
- I am grateful for the conversation we had w Michael/Kevin (yang) today at lunch about… yk what let’s just not but it was crazy. And then we are lowkey cooking with our AAS paper rn so that’s p cool

4/2/25 (Day Rating: 6.5/10)
- I am grateful for Tim and Payge today it is always so nice to be able to grab lunch with them! And then I’m grateful for dinner with like all of my friends todayy
- I am grateful for finishing our autobiography thingy today and being decently productive and getting thingies done.
- I am grateful for being able to work at the end of the day with Jocelyn that makes me happy

4/1/25 (Day Rating: 7/10)
- I am grateful that I was honestly pretty productive today and I accomplished the short essay thingies that I needed to get done today.
- I am grateful that I was able to survive lab okay today and that I was able to enjoy dissecting the sheep brain with Jamil! And then also I am grateful for really good lunch and dinner today
- I am grateful that room draw went okay today and that we got our spelman room 🙂 We also were able to get late meal from Yoon today (SHE IS SO CUTE i’m grateful to have her), hit the gym, post on instagram, call umma/appa, and chill mostly).

3/31/25 (Day Rating: 7/10)
- I am grateful for John sending us the super cute video of Joanna playing with the turtle stuffed animal that we gave her HEHE
- I am grateful for us not having to pay attention during GHP lecture today that was honestly super duper chill and also the fact that we were able to lock in before and after class was pretty good too 🙂
- I am grateful that Tim and Payge were able to get lunch with me and then that we honestly understood a lot of what was happening in Korean todayy. And then dinner with koki and then poker at colo!! So many exciting and fun thingies to be grateful for.

3/30/25 (Day Rating: 7/10)
- A decently productive day today so I am happy and there was a good sermon on friendship at Jacob’s well today so I am glad that I can have good friends here at Princeton
- I am grateful that we got a lot of work done honestly we were type type typing away throughout today
- I am grateful that we were able to get Mamans with Amy and Josh todayyy that was super duper cute.

3/29/25 (Day Rating: 7/10)
- THE WEATHER TODAY WAS PERFFF I loved it so much and it was so refreshing and warm and nice and we got to go outside and take a bunch of pictures so that was good
- I am grateful that we are doing p important work today and got a big chunk of it done
- I am grateful that we were able to spend the majority of the afternoon with Michael and Jocelyn today that was pretty fun and then I am grateful for semis tonight too!

3/28/25 (Day rating: 6.5/10)
- I am grateful for my friends like Payge and Tim who spent the afternoon talking with me and giving me aliving support so that was so so nice
- I am grateful for dinner with Nick and Jocelyn today!! And then I am also grateful that I was able to have the yummiest dinner ever at colo wowowo
- I am grateful that the EEB senior thesis thingy worked out and that Barbara was okay with it

3/27/25 (Day Rating: 8/10)
- BUTCHER 360 SO YUM
- CAKE SO YUM
- Nap was so good.

3/26/25 (Day rating: 8/10)
- I am grateful for eating ROOTS!! Honestly the food was so fire it was just way too expensive
- I am grateful for my friends and also being able to do the Korean quiz somewhat decently today
- I am grateful for Evelyn for giving me the cute mouse and pen and then Marvin for the card and Piplup and then Manna for the birthday card and cake and Boya for the piggy

3/25/25 (Day Rating: 7/10)
- Solid day today, I’m grateful that we were productive during 314 lecture and that we also were able to get the 314 lab over with today
- I am grateful that even though we forgot about our two meetings with GHP and Korean tutoring and that also we had to push back the Daniel dinner at Cap, it all worked out very well and that I am also grateful to have caught up with Daniel Liu and see that he is doing well!
- I am grateful that my friends are cute and birthday surprised me today 🙂 That was so sweet of themmm

3/24/25 (Day Rating: 5/10)
- Uhhh… I’m grateful for Jamil taking us to tower today for lunch 🙂
- I am grateful for Jocelyn and James keeping me sane through the heck of a stressful day
- I am grateful for being able to enjoy night time w Tim and Payge

3/23/25 (Day rating: 7/10)
- I am grateful that I was able to go to church today and learn more about Proverbs and then also we were able to see lot of church ppl like Michael, Crystal, and a few other people that we drove! And then I am grateful for lunch with Michael and Jay
- I am grateful that we were able to do laundry and go to the gym and clean today that was all productive things to do that were not work so yay for self improvement
- I am grateful that we were able to enjoy a day with very clear weather and nice skies and finish our Korean paper. And then I am grateful that we were able to play basketballs with both Kevins and the other Jonathan Lee today that was really nice.

3/22/25 (Day rating: 6.5/10)
- I am grateful for a full night of sleep and then also being able to spend time with friends today and then planning senior banquet w the other juniors
- I am grateful for being able to eat yummy food at colo cuz the pancakes were lowkey fire
- I am grateful that we were able to go get poke with Rebekah today and that it was 1) super duper yummy 2) super big portions 3) nice catching up with her 4) enjoyable meal!

3/21/25 (Day Rating: 7.5/10)
- I am grateful that field trip was fun and that the entire day was able to be spent with AMYYYY
- I am grateful that Payge and Tim said hi to us in Dillon they are cute and I like saying hi to them and I enjoy 🙂
- I am grateful that we were able to catch up a bit with Moses on the bus ride to LG today and that also we were able to get free thingies from LG today!

3/20/25 (Day Rating: 7/10)
- I am grateful that we woke up in time for our GHP precept even though we lost our prox for a little bit but then it all worked out and we were able to somewhat pay attention in our EEB 314 lecture today so I’m happy
- I am grateful for lunch with Por, Michael and Jocelyn today and then we got to see Joie for a little bit but then also the lunch food was lowkey like really good. And then we got to check out Black Holes for a little bit today so I am grateful for that as well
- I am grateful that I got to send some important emails out and then also get free boba at Kevin’s AI talk and then also do our PPDA study break somewhat decently, and then we went to Jocelyn’s OS thingy so that was fun too.

3/19/25 (Day Rating: 6/10)
- I am grateful for taking a nap at colo today so that was nice
- I am grateful lunch with Charlotte and dinner w Tim/Payge todayyy
- I am grateful for the most part doing somewhat important work like Korean/GHP

3/18/25 (Day Rating: 10/10)
- WE ARE GOING TO OXFORD!! And then also GHP summer thingies all worked out so like many things are coming into order. And then we also aced our EEB 314 midterm so go off Jonathan I think this is the first time we got a midterm score back and were genuinely impressed with ourselves
- I am grateful for Jamil carrying us throughout the shark dissection lab today since that was honestly so so much work. And then I am grateful that we were able to call umma and talk with her during the nighttt
- I am grateful that we got to have lunch and dinner at colo with Jocelyn/Michael/friends and it’s honestly so nice to be able to enjoy colo like this 🙂 And then I am grateful that we got to play b ball with Kevin today and then go to MD with Jocelyn and that the weather was super duper nice

3/17/25 (Day Rating: 7/10)
- I am grateful that today was full of activities and such and we went to all of our classes, did all of our important thingies, and ate all breakfast, lunch AND DINNER!!!
- I am grateful for Payge and Evelyn and Amy and Jocelyn always making our day better literally every single time that I see them
- I am grateful for being able to have really fun conversations with friends like our meal with Tim and Payge at lunch and then meeting Neal at dinner and the Kevin and Celine at breakfast and so much fun

3/16/25 (Day Rating: 7/10)
- I am grateful for a really nice drive back to Princeton with no major hiccups or errors or anything and it was honestly really relaxing and peaceful
- I am grateful that we were able to go to church in the morning and then grab lunch with umma and appa and Joey at the diner
- I am grateful that we got to have dinner at colo with jocelyn and michael that was cuteee

3/15/25 (Day Rating: 6/10)
- Stupid test is over so I’m grateful for that.
- I’m grateful that Kayley made us a super cute goodie bag before our test so that was super cute
- I am grateful that Ronnie Immo is at our house and we were able to see her and then also that we got to brainrot for the rest of the day and then that we hung out w Josh and Jae before they left for school again

3/14/25 (Day Rating: 5/10)
- I am grateful that this is our last final day of studying and that Jocelyn and Michael and Kevin came to C floor of Stone to keep us company throughout the break and now today too
- I am grateful that we were all able to eat outside and have hoagie haven and yummy maruchi rice balls and that the weather was decent enough to eat outside
- I am grateful that I got to go home today before our final LOCK IN DAY TMRW!!! I am grateful so very grateful.

3/13/25 (Day Rating: 4/10)
- I am grateful that Jocelyn told us to lock in at Princeton Public library since there was a wifi outage today I would not have thought of that
- I am grateful for starbucks coffee
- I am grateful to have the energy to get out of bed in the mornings. And then I’m grateful my visiting friends who check up on me and bring me food and we got to eat at Alfalfa today so yummy

3/12/25 (Day Rating: 5/10)
- I am grateful for Michael and Jocelyn coming to Stone as per usual to keep us company
- I am grateful for being able to study at Princeton University and work hard and have friends and then tacoria
- I am grateful for pretty good sleep today.

3/11/25 (Day Rating: 5/10)
- I am grateful for Michael coming to Stone with us and keeping us company as we lock in on C floor of firestone…
- I am grateful that we got to have a full 12 hours of sleep like what the heck how do we sleep that long, but then also that was amazing to be able to sleep for that long
- I am grateful for so many coffees, so many yummy foods like chipotle when Jocelyn brought it to us and Kevin bringing some macaroons to AI lab and so much studying…

3/10/25 (Day Rating: 5/10)
- I am grateful for tacoria today!!! And then I am happy that the weather is super duper nice
- I am grateful for my friends coming to Stone with me and being willing to lock in at C floor despite how depressing it is
- I am grateful for the PRIVILEGE TO STUDY BECAUSE ITS A PRIVILEGE TO STUDY

3/9/25 (Day rating: 8/10)
- I am grateful for church today honestly it was a really good sermon, message, we took some good notes and then Kevin/Xuanying joined us today so that was a fun time at Jacob’s Well 🙂
- I am grateful that Kim/Chung’s family bought us 11 people’s worth of Dim Sum today!!!!!!! Like that was seriously amazing and the food was great and I felt like I was at home they are great people and I am grateful for that.
- I am grateful for getting to babysit John’s 1 year old today that is so exciting and makes me happy and joyful and I get to play with a baby.

3/8/25 (Day Rating: 7/10)
- I am grateful for a full night of sleep!!!
- I am grateful for spending the day with Jocelyn and enjoying her birthday!!
- It’s a privilege to study It’s a privilege to study It’s a privilege to study It’s a privilege to study It’s a privilege to study It’s a privilege to study It’s a privilege to study It’s a privilege to study

3/7/25 (Day Rating: 8/10)
- I am grateful for being decently productive today and a successful planned birthday surprise for Jocelyn!! 🙂 I am happy about that. We got cake and her card and SC house and it was all very successful.
- I am grateful for our AAS class honestly being a really really fun time to learn and discuss about a topic that we are genuinely really interested in. THIS IS SO GREAT BEING IN A CLASS WE ENJOY THE MATERIAL DISCUSSED
- I am grateful for a reunion time with all of our friends but I am a bit sad that we did not take any pictures. OKAY ALWAYS ALWAYS ALWAYS REMEMBER TO TAKE PICTURES!!!

3/6/25 (Day Rating: 7/10)
- I am grateful to be finished with our midterms week at Princeton yay.
- I am grateful that we got to finish a PSET on top of midterms week at Princeton!
- I am grateful that Jamil brought us to tower today for some really good food and then also that there was even more really good food for colo dinner today.

3/5/25 (Day Rating: 5/10)
- I am grateful for Evelyn and Payge being with me in GHP to make me happy
- I am grateful for some yummy lunch and dinner today!
- I am grateful that we got to take a mini study break at FSG junior fireside chat today.

3/4/25 (Day Rating: 7/10)
- I am grateful that the 3 hour EEB midterm is stupidly done with and I think it went decently okay
- I am grateful for appa calling us and talking with us and us being able to talk with appa!!!!
- I am grateful for receiving good feedback on our JP by Dr. Graham. 🙂 She is PROUD OF US I NEED THIS VALIDATION

3/3/25 (Day rating: 6/10)
- Korean presentation done. GHP cumulative quiz done. Productive important thingies today have been done. So I am happy about that
- I am grateful for being able to have friends in my Korean class who are super duper supportive and friendly and lovely to be around.
- I am grateful for being able to just chill and work in colo. This is such a great place to be in ugh im sad I have to leave next year.

3/2/25 (Day rating: 6.5/10)
- I am grateful for a full day of sleeping and we could wake up when we want to so that made us a lot less tired throughout the day. I’m also grateful to be able to go to church with Moses today and have some fun conversations on the way to Kings
- I am grateful for being able to finish some important thesis work today and submitting the stupid proposal draft thingy
- I am grateful for my friends like Kevin and Jocelyn that I can just study and do work with at night that makes the night enjoyable

3/1/25 (Day Rating: 9/10)
- I am grateful for SO MUCH FUN W AMY TODAY the food was very very yummy and then also the vibes were very nice too
- I am grateful for grabbing lunch with Joyce today it was nice being able to learn more about her and see what she’s like. She’s honestly super duper cool
- I am grateful that we did a lot of work and studying and productive thingies today even though we are tired and sleepy.

2/28/25 (Day Rating: 8/10)
- I am grateful that so much friends were had today. I got to spend time with both Payge ANDDD everyone at dinner
- I am grateful for studying tonight in Shered and that there is a new study spot to go to with friends every single night
- I am grateful that the AAS class we are in is honestly very fun and interesting and enjoyable and I like it a lot and also that OH for EEB 314 today was helpful.

2/27/25 (Day rating: 7/10)
- I am grateful for being productive today and finishing a PSET, sending out important emails, doing favors for friends and also class class class.
- I am grateful for lunch w Jamil today so spontaneous so much fun tho
- I am grateful for free coffee < 3

2/26/25 (Day rating: 5/10)
- I am grateful for my friends Michael and Jocelyn to just study with them in colo and eat lunch and dinner w them
- I am grateful for being able to scroll on instagram reels for an hour at night to help with our brain rot
- I am grateful that appa called us today to just say hi

2/25/25 (Day rating: 6.5/10)
- Too much EEB 314 but I am grateful that there was a lot of EEB 314 today
- I am grateful to sit with friends before dinner TIM AND PAYGEEE
- I am grateful for Jamil being fun to hang out with

2/24/25 (Day Rating: 7.5/10)
- I am grateful for lunch with Tim and Payge today and it being super fun
- I am grateful for learning so much Korean today and doing our classes more seriously now
- I am grateful for dinner with so many of our colo friends today. But they forgot to put rice in my wawa bowl.

2/23/25 (Day Rating: 7/10)
- I am grateful for church this morning and being able to see Moses so that was nice
- I am grateful for the beanbags at colo to take 3 hour naps on
- I am grateful for my friends who are studying with me on Sundays.

2/22/25 (Day Rating: 7/10)
- I am grateful for Ooika today w the JSG group that was very yummy
- I am grateful for yummy lunch today
- I am grateful for lots of work today.

2/21/25 (Day Rating: 7/10)
- I am grateful we got to go to the koko pops show with Kevin, Michael and Boya today
- I am grateful that we got to have lunch with Amy and Morgan!! And so many often times seeing Amy makes us so happy
- I am grateful that our individual session with Kim ssn was fun and that also we are enjoying the discussions we are having in our AAS class

2/20/25 (Day Rating: 7/10)
- I am grateful for dinner with all of my friends today that was fun!
- I am grateful for being able to make stuffed animal today and for PPDA study break going well
- I am grateful for finishing essays productively

2/19/25 (Day Rating: 7/10)
- I am grateful that dinner with Amy + Christina was cute
- I am grateful that everything went pretty okay with the Korean quiz and we learned a lot about how to study well
- I am grateful for lunch with Payge + Tim + Joel today that was so much fun too and I could fully feel myself being myself around them so that’s happy.

2/18/25 (Day Rating: 6.7/10)
- I am grateful for lunch with Moses today I learned a lot from him and I’m happy we are friends with him
- I am grateful that I got to have a pretty interesting time in EEB lab today looking at hairy owl poop is always cute
- I am grateful for my friends not stealing my guitar and for Evelyn helping me out HEHEHE

2/17/25 (Day Rating: 7/10)
- I am grateful for our meeting on zoom today that went less stressful than expected.
- I am grateful for how much Korean we were able to practice today with Mother Shin.
- I am grateful for dinner being very very yummy today

2/16/25 (Day Rating: 6/10)
- I am grateful for church today and being able to play with Jocelyn’s jacket at church is a weird thing to be fun to do but it was fun.
- I am grateful that we got to see Por today!
- I am grateful that we are making sure to do the work that we need to do.

2/15/25 (Day Rating: 7/10)
- I am grateful that we got to do some good work today, that we got to spend a lot of time with Evelyn, and that we are grabbing a manna meal with AMYYY
- I am grateful that some studying got done today. That is indeed productive so I am proud.
- I am grateful that we got to go to Large Group for the first time in a while. And I think that we are figuring out that we should really be spending more and more time with James.

2/14/25 (Day Rating: 5.5/10)
- We spent a lot of time with James today which makes us grateful. I’m happy that I get to spend time with him.
- We did our presentation pretty well in our AAS class today so I’m grateful for that
- I am grateful that I got to talk to a lot of new people and learn more about myself today.

2/13/25 (Day Rating: 6.5/10)
- I am grateful for Jocelyn and Evelyn and Payge and all of my favorite people seeing them today
- I am grateful for for finding that Korean barber and getting a somewhat decent haircut that doesn’t make you hate how you look
- I am grateful for most of my meetings today being pretty chill!

2/12/25 (Day Rating: 8/10)
- We got to see Evelyn, Jocelyn, Joie, Payge, AND Amy today and that makes me so happy
- I am grateful for the Popeyes study break. SO YUM CHICKEN
- I am grateful that I got to be decently productive with our work today.

2/11/25 (Day Rating: 7/10)
- IM GRATEFUL THAT DINNER WAS SO FRIGGEN GOOD
- I am grateful for lunch with Kevin, Michael and Jocelynnn!!
- I am grateful that we finally made this stupid lab safety meeting thingy.

2/10/25 (Day Rating: 9/10)
- EVELYNNN! PAYGE!!! I am happy that they exist in my life. And then also I am grateful that we got to get the EEB lab out of the way. 3 hours is wayyy too long omg.
- I am grateful that we got to study at colo towards the end of the day with all of our friends that was super wholesome.
- I am grateful for dinner with Josh today! That was a nice time being able to catch up with him and see how he’s doing.

2/9/25 (Day rating: 9/10)
- I am super duper grateful for today. Super bowl was fun to watch at Kim’s house and Jocelyn + Michael were there too.
- Super yummy food today. Super cute doggo today. Super amazing people today.
- We honestly got a decent amount of work done so that’s good on us.

2/8/25 (Day Rating: 7/10)
- I am grateful that Korean writing assignment could go easier since we did half the work already!!
- I am grateful that we got to see big Jonathan at colo today he is looking really good and seems to be doing quite well so I’m happy for him. And I’m also grateful that we got to spend a lot of time with James Jun today too
- I am grateful that the call with Manny went well!!

2/7/25 (Day Rating: 8/10)
- I am grateful for dinner with joie and amanda today 🙂
- I am grateful that Evelyn is our friend
- I am grateful that AAS class was honestly super duper cool today

2/6/25 (Day Rating: 7/10)
- I am grateful that Payge was born 21 years ago!!
- I am grateful that morning precept was on zoom today and so it saved me so much joy
- I am grateful that we were productive today and got what we needed to do done.

2/5/25 (Day Rating: 6/10)
- I am grateful for Jocelyn and Kevin and Payge and Evelyn and Amy omg we got to see so many people today
- I am grateful that Evelyn carries in GHP 🙂
- I am grateful the Noor saved us at the SGRC interview LOL

2/4/25 (Day Rating: 6/10)
- We had trouble locking in today but I am still grateful that we tried our best nonetheless
- I am grateful for my friends smiling. Honestly there’s so much beauty in seeing people laugh and be smiling and I am happy that I get to see that.
- I am grateful for shadowing it’s super duper fun honestly.

2/3/25 (Day Rating: 7/10)
- I am grateful for doing well on our GHP quiz today. Comeback season
- I am grateful for Payge and Amy and Evelyn and how we get to see all our favorite people YAY
- I am grateful for being at Princeton University and that we can study here.

2/2/25 (Day Rating: 7/10)
- I am grateful for all the reflection that we were able to do today
- I am grateful for michael and jocelyn! They are super duper cute and I enjoy spending my Sundays with them.
- I am grateful for church!!

2/1/25 (Day Rating: 7/10)
- I am grateful that we finally got to grab dinner with Marvin, Shreya and Tim HAHA
- I am grateful for colo flower arrangement being super duper cute.
- I am grateful for learning how to study.

1/31/25 (Day Rating: 7/10)
- I am grateful that we got to have fun at AAS 314 today because it was a very interesting course and I learned a lot
- I am grateful that Day Yi is super duper cute i love him
- I am grateful that Kim ssn laughs at our jokes.

1/30/25 (Day Rating: 6/10)
- I am grateful that Joie is so cute and being friends with her makes me happy
- I am grateful that Dr. Soheili is super duper nice and kind.
- I am grateful that I am finding out more about myself every day

1/29/25 (Day Rating: 6/10)
- I am grateful for chipotle with friends! Michael/Jocelyn/Marvin make me happy
- I am grateful for naps making things better.
- I am grateful that Korean was fun today

1/28/25 (Day Rating: 7/10)
- I am grateful that the train ride home went very smoothly and that the car ride back also went smoothly and that everything in terms of transportation went very well 🙂
- I am grateful for Appa and Umma loving us enough to prepare stuff and pick stuff up for us and everything being well
- I am grateful for my friends at colo who I can study/work with so I am not lonely haha

1/27/25 (Day Rating: 7/10)
- Grateful that I woke up early today and my body wasn’t angry at me!! Good on us for not being tired throughout today
- I am grateful that I got to see so many of my favorite people today. PAYGE!!! EVELYN!!! AMYYYY!!
- I am grateful that I was able to go to a lot of our meetings today and be pretty productive 🙂

1/26/25 (Day Rating: 6.5/10)
- I am grateful for Marvin coming back and everyone is basically back and now the dorm doesn’t feel so empty anymore
- I am grateful that Brendon was born 21 years ago. Pretty much an 18 year friendship going strong
- I am grateful that honestly we are doing everything that we need to be doing and not lazing off. Proud of ourself for that.

1/25/25 (Day Rating: 6/10)
- Grateful for lunch with Stephanie. Well I’m just grateful for Stephanie overall
- Happy that my shoulder is doing better and it’s clearly improving
- Grateful for seeing more and more people in open room and give them some pizza

1/24/25 (Day Rating: 9/10)
- I am grateful for so much fun today with lots of good people, conversations, and food in the city for free winter session.
- Thankful for Princeton’s money.
- I am thankful for so so many things.

1/23/25 (Day Rating: 8/10)
- Productive day today so I am grateful that Princeton pushes us to be the best version of ourself
- I am grateful for Stephanie giving us the winter session thingy tmrw < 3 EXCITED
- I am grateful to learn to put aside my ego for the sake of my mother.

1/22/25 (Day Rating: 7/10
- Evelyn is so cute I love getting dinner w her
- I am grateful that progressive overloading is going well and also that we got lunch w b.kook 🙂
- I am happy that we got to talk with a lot of locals today that was interesting.

1/21/25 (Day Rating: 7/10)
- Grateful for being productive and getting a lot of thingies done
- Grateful for lunch and dinner at D-halls slapping hard and we are getting enough protein
- Grateful that neuro gum exists 🙂

1/20/25 (Day Rating: 6.5/10)
- I am grateful that we finished a lot of the studying that we needed to do.
- I am grateful for Rebekah and how bright she is 🙂
- I am grateful that there were new cafes and bakeries to eat at and enjoy

1/19/25 (Day Rating: 7/10)
- I am grateful that we can wake up whenever tf we want to wake up < 3
- I am happy that we did most of the things that we needed to do today. It was productive.
- I am grateful for having open room be so cozy and accessible.

1/18/25 (Day Rating: 6/10)
- I am grateful van test went well !!
- I am grateful to see Daniel/Elijah at lunch today
- I am happy that we are doing our best.

1/17/25 (Day Rating: 7/10)
- I am grateful for coincidentally running into Joe and having friends here who I can be happy to see 🙂
- I am grateful that Sofie is super duper nice and considerate and that everything went smoothly in terms of planning 😌
- I am grateful that appa said “Choose whichever fits your needs” and actually supports my decisions and thoughts. IT’S SO GREAT HAVING THAT I HAVE A FATHER THAT SUPPORT MY DECISIONS

1/16/25 (Day Rating: 7/10)
- I’m in a better mood cause I was able to sleep lots and sleeping lots makes me happy. I think I had the best quality sleep possible over the past 2 days
- I AM SO GRATEFUL FOR FIRESTONE LIBRARY!!!!
- I am grateful for Kevin teaching us about o1. Like where has this been all my life :SDLKGJS

1/15/25 (Day Rating: 7/10)
- Evelyn visits me in the library so that is cute and I am grateful for that
- I am grateful for being able to wake up whenever I want to without classes
- I am grateful for everything being so accessible… coffee, library, gym, food, dorm. It’s really crazy how much I take this for granted throughout a regular semester.

1/14/25 (Day Rating: 7/10)
- I am grateful that food is yummy hehe I forgot how yummy d-hall food is.
- I am grateful that silence often entails a lot of self-reflection.
- I am grateful that Kevin works so hard that I am motivated to do work because of his presence.

1/13/25 (Day Rating: 7/10)
- I am happy that Evelyn exists to spend time with
- I am grateful for being able to be productive!
- I am grateful for my favorite people who text me 😌

1/12/25 (Day Rating: 6/10)
- I’m grateful for Josh/Jae and that I have friends who I can just be myself around
- Grateful for church and my family there

1/11/25 (Day Rating: 3/10)
- I am grateful for appa and umma!! They make me yummy food.

1/10/25 (Day Rating: 5/10)
- I am grateful that we spent most of the day with Jae at a cafe that was cute.
- Grateful for home. And then also Indian food.
- I am grateful for chilling!!

1/9/25 (Day Rating: 6/10)
- SLEEP ❤ Grateful for it.
- CAR 🙂 Grateful for it
- FRIENDS!!! Grateful for it

1/8/25 (Day Rating: 5/10)
- What did I even do today? I can’t even remember dang. Anyways I am grateful 🙂 Super duper grateful. I’M ALIVEEE

1/7/25 (Day Rating: 5/10)
- Grateful for gym
- Grateful for having this break to process through thoughts/emotions better
- Grateful that we are figuring out more and more about myself.

1/6/25 (Day Rating: 6/10)
- I am grateful that we got to spend a lot of the day with jae/josh
- I am grateful for papa johns and also for halal
- I am grateful that we saw Kara today < 3

1/5/25 (Day rating: 3/10)
- I should really remind myself to be grateful for all of the opportunities that my parents have given me
- I am deeply grateful for Pastor Sam’s reminder today to come to God in all things
- I am grateful. Just be grateful. And then new shoes LOL

1/4/25 (Day Rating: 4/10)
- I am grateful for umma, appa and Joey (and Josh too maybe)
- I am grateful for my friends at home who care about me
- I am grateful for having difficult conversations.

1/3/25 (Day Rating: 7/10)
- I am grateful that Amanda, Michael and Jae came to kidnap us from our house today
- I am grateful that we got to try out a new cafe
- I am grateful that Appa made us yummy food for dinner

1/2/25 (Day Rating: 5/10)
- I am grateful that we got to try out 2 new cafes today to study at 🙂
- I am grateful that umma packed us a yummy lunch again so it’s like we are in high school again hehhe
- I am grateful that we took the most FIRE nap ever. Like I think that this is one of the best naps that I have ever had in my entire life < 3

1/1/25 (Day Rating: 6/10)
- I am grateful that I got to wake up on time for the family lunch today HAHAHA
- I am grateful that we got to see the entirety of Appa’s side of the family today and that we were able to do 세배 and eat yummy food and such
- I am grateful that we got to go to Panera and then talk to a few highschoolers who are suffering with Ms. Steinberg currently as I have… she is a WITCH

12/31/24 (Day Rating: 5/10)
- I am grateful that we got to try out 2 different cafes today! Honestly that was pretty fire and we got a lot of studying done 🙂
- I am grateful that we got to go to church today. We ended 2024 with worship and started 2025 in worship.
- I am grateful that umma made us very yummy food and that Appa brought home also some yummy food

12/30/24 (Day Rating: 4/10)
- I am grateful that we finished all the biological systems today and then we took many many naps
- I am grateful to be home with my family
- I am grateful for my friends at home.

12/29/24 (Day Rating: 6.5/10)
- I am grateful that we got to see Brendon/AD at church today and kinda sorta catch up with them. Honestly it’s good that we are friends and that I know that these are going to be my boys for life
- I am grateful that we got to study for a few hours with Andrew at the library today but sucks at it closes so early
- I am grateful that I heard Pastor Sam’s message on decision making: basically the moral of the story is don’t bother serving in church if you don’t have a relationship with Jesus.

12/28/24 (Day Rating: 5/10)
- I am grateful to be finished with the stupid JP and now we shall be grinding out DAT
- I am grateful that appa made us super duper yummy food again today as per usualll
- I am grateful that we literally spent the entire day lying down in bed today SD:LGKJ

12/27/24 (Day Rating: 5/10)
- I am grateful for all of the sleep that we had today YAY literally woke up at 3pm
- I am grateful for ChatGPT. Like oml how did people live without chat.
- I am grateful for Panera giving us the biggest coffee ever today and that they’re all free for the month HEHHEE

12/26/24 (Day Rating: 4.5/10)
- I’m learning a lot so I’m grateful to be learning.
- I’m grateful for all of the thoughts that we had last night. Honestly was very very important thinking to be had there.
- I am grateful for seeing Azam at the library again today 🙂

12/25/24 (Day Rating: 5/10)
- Merry Christmas. I am grateful of course for JESUS LOL
- I am grateful that we got a lot of studying done today
- I am grateful for yummy food < 3

12/24/24 (Day Rating: 4/10)
- I am grateful that we were able to recover from food poisoning fairly quickly but bro that was awful
- I am grateful that we got to do Christmas eve service and that there was yummy food there!
- I am grateful that my umma and appa love us very very much.

12/23/24 (Day Rating: 6/10)
- I am grateful that we got to see Jynnie and Azam at the library today! They make me happy
- I am grateful that we were able to successfully lock tf in today
- I am grateful that we tried out literally 5 different restaurants today to work on our beli ratings hhehehe

12/22/24 (Day Rating: 4/10)
- I think it’s a little sad that I’m getting kinda annoyed being at home. I should really be grateful that I am home with my family and able to enjoy my own room and such, but for some reason, I’m not finding that joy hmm… But nonetheless this is a gratitude journal and so I will do my best to try and keep a grateful heart
- I am grateful that we got to celebrate Halmony’s birthday today and eat K city!
- I am grateful for church and also that we saw Azam at the library today 🙂

12/21/24 (Day Rating: 3.5/10)
- Today is our last brain rot day before we start LOCKING TF IN. So I am grateful for the rest that we received and now it’s time to get to work
- I am grateful that we could do a pull up today! I think our arm is like marginally better now
- I am grateful that we texted Payge for a little bit today!

12/20/24 (Day Rating: 5/10)
- I am grateful that we able to rest a lot today and chill out after the hell of final’s week
- I am grateful that we were able to watch Gladiator 2 today! It was honestly a very good movie I enjoyed it a lot
- I am grateful for umma and appa cooking us yummy food all the time when we are home.

12/19/24 (Day Rating: 5/10)
- Today was a brain rot day but I am grateful for brain rot days where we don’t do anything 🙂 And I am grateful for being able to see my family here!
- I am grateful that we finished our youtube video today and uploaded YAY
- I am grateful that I got to take a nap today < 3

12/18/24 (Day Rating: 8/10)
- I am grateful that MICROBIO FINAL IS OVERRRR I am free. I am happy.
- I am grateful that we got to go to open room today and then saw James and a bunch of other Manna people and then we watched as James tried to flip a coin to get heads and then also as he was vacuuming which was fun to watch
- I am grateful that umma and appa love us enough to bring us home 🙂

12/17/24 (Day Rating: 3/10)
- I am grateful that biochem and Korean finals are over. Even though they were bad.
- I am grateful that Kim ssn bought us some 빵 and it was very tasty and I love her for that 🙂
- I am grateful to see Amy today and Evelyn always makes us smile too.

12/16/24 (Day Rating: 2/10)
- I am grateful for Jocelyn coming to save us the study room 🙂 I am grateful she exists too.
- I am grateful that lunch today was honestly pretty yummy.
- I am grateful that there is only 2 days left of this misery.

12/15/24 (Day Rating: 6/10)
- I am happy that we got to go to church today with Michael and Jocelyn and that we saw the little kids performing/singing today 🙂
- I am grateful that we were able to really lock tf in today.
- I am grateful for eating 2 meals today and not skipping out on food.

12/14/24 (Day Rating: 5.3/10)
- I am grateful for seeing lots of people today and that Daniel was willing to meet with us for Korean tutoring today and we learned a lot about the Korean political climate at the moment
- I am grateful that Manna Christmas party is a good study break 🙂 And then also the fact that we are able to take a little bit of a rest day today is also good
- I am grateful that we got to call appa today.

12/13/24 (Day Rating: 5/10)
- Basically just studied again but I think we are somewhat figuring out a little bit more on how to study
- I am grateful that we didn’t forget about our roomie lunch today
- I am grateful that I got to see Jocelyn and text Payge a very little bit today. FAVORITE PPL!

12/12/24 (Day Rating: 5/10)
- Why can’t I just become a biochem and microbio expert without studying so hard. But anyways I am grateful that I get to study at a University like this one 🙂
- I am grateful that Firestone library exists to make sure that we can have a place to work and study and be productive.
- I am grateful that I have me, myself and I to keep us company. So honestly I need to remind myself to be grateful for myself. I’m me. I’m here. I’ve always been here. I am grateful that I exist.

12/11/24 (Day Rating: 5/10)
- Today was indeed a day. Like just the most day day ever. But I am grateful that we get to have these day days where we go through biochem and microbio lectures and eat tacoria hehehe
- I am grateful that I have Payge to text and keep us sane for while we are C flooring in Firestone and trying not to die from studying. Why is there so much friggen content oml
- I am grateful that I have tacoria to keep me alive and that putting on phone on recording is honestly keeping us more productive cause it makes sure that we do not use our phone while studying. Anyways I need to remind myself to be grateful that I have the opportunity to study at a school like this 🙂

12/10/24 (Day Rating: 6/10)
- I am grateful that we finished our GHP paper today as we planned to do that was productive of us and I am happy that we are able to be productive like that.
- I am grateful that we got to talk to Jocelyn, Payge and Evelyn today. They are literally like the three people in this world that are keeping me sane and alive so I am happy that all of them are in my life to some extent.
- I am grateful that we got to serve at FSG for praise and then also that we did our Manna meal and learned who Isabella is. And then we learned a lot more about the frosh here too 🙂

12/9/24 (Day Rating: 5/10)
- Today was a solidly average day. I am grateful that we accomplished basically everything that we had on our to do list today though. We did our oral speaking final, and then we had lunch with frosh Brian and then volunteered at the food pantry so that was all productive
- I am grateful that the oral speaking exam was cute and that we got to meet Angie and Barnard at the food pantry volunteering shift today. And then our conversation with Brian went well too so all things to be grateful for
- I am grateful for literally being a student at Princeton University. Like what the heck how am I here right now I’m not supposed to and I need to remind myself how grateful I should be for this blessing every single day.

12/8/24 (Day Rating: 8/10)
- I am grateful that we got to celebrate Kevin’s birthday today and then that there was so much food which was yummy and no peanuts in them 🙂 I AM GRATEFUL FOR FRIENDS and then watching Wicked was honestly pretty fun too and I enjoyed it a lot
- I am grateful that we got to go to church this morning and then also that we finished our EEB paper today so I’m happy that we were productive in that regard
- I am grateful that I have friends who let me play with their hair. It’s a weird thing to be grateful for and write in my journal but I enjoy it so like why am I weird.

12/7/24 (Day Rating: 7.5/10)
- I am grateful that we got to go to Colo Formals today because that was honestly a lot of fun and then the desserts were delicious and then also the LOBSTER AND STEAK!! And I am grateful for jocelyn because she gave us some of her steak and I love her for it
- I am grateful for Evelyn always being such a bright ray of sunshine all the time. She made formals very fun and enjoyable
- I am grateful that we got to spend a lot of the day with friends and then also that we got to go to JSG today and then that we spent some time with Joie today and had pretty good conversations with her and get her perspective on a few of the issues that we are currently facinggg

12/6/24 (Day Rating: 9/10)
- I am grateful because we did literally no work today and that we were able to just rest and relax and spend time with friends so I am super happy about that. And then I am grateful for semis because that was yummy food and a lot of fun with people too
- I am grateful that we were able to go support Grace at the disiac show and see how they danced because it was honestly really interesting. And then we learned what fuzzy dice was…? And then I am also grateful that we played a lot of Cs go today at colo’s computer MUAHAHHA
- I am grateful that we spent a majority of the day with Payge and then that the lab presentation went well and so this was all working out in our favor. PAYGE AND EVELYN ARE FUN TO HANG WITH SO IM GRATEFUL FOR THAT

12/5/24 (Day Rating: 6/10)
- I am grateful for LAST DAY OF CLASSES and we are done with micro bio and Korean quizzes, both of which was decent so I AM GRATEFUL THAT THEY ARE DONE AND OVER WITH AND OUR HORRIBLE THURSDAYS ARE OVER
- I am grateful that we got to study lots and lots today and then that we went to the dentist coffee chat.
- I am grateful for the ability to work hard at this school and give our all into these endeavors

12/4/24 (Day Rating: 9/10)
- TODAY WAS A GOOD DAY. Why was it a good day? Because I spent so much time with people that I enjoy spending time with and talk to and went to all of our classes and I am happy because of that. We talked a lot with Payge and got to eat lunch/walk to/from biochem precept with Evelyn and then overall I’m just grateful for my friends here
- I am grateful for getting into all of our courses today and then waking up early and eating breakfast and then somehow not crashing and dying for the entire day.
- I am grateful that we won first place in the cos council thingy today LOL

12/3/24 (Day Rating: 6.9/10)
- EEB TEST DONE So I’m grateful that it is not out of sight, out of mind. And then I am grateful for Payge being in so many of our classes wait I’m going to miss it when we’re not in the same class anymoreee
- I am grateful that THERE WAS NO FRIGGEN MICROBIO QUIZ TODAY THANK THE LORD gives me more time to study for Thursdays quiz 🙂
- I am grateful that we aren’t too stressed today and that the EEB final went decently well so these are all pluses!

12/2/24 (Day Rating: 8/10)
- The days are getting easier Jonathan . A little bit easier to move on every day. But yes I am grateful that we got to go to both our GHP class and Korean individual session, and then also we were able to wake up early in time for breakfast 🙂
- I am grateful that we got to grab dinner with Brian, Jeremy and David Kwon for Bsuh’s birthday today. That was cute and I am grateful for my community here.
- I am grateful that Evelyn and Payge always make us smile every single day omg I don’t think I can do princeton without them always being so sweet.

12/1/24 (Day rating: 7.1/10)
- I think today was a solid day. I enjoyed that we were able to go on a run for the first time in a while today and are committed to making this month the biggest comeback month of our entire life. So I’m happy about that.
- I am grateful that I got to see Jae today and talk with him a little bit to catch up. And then we also sat with denish on the train ride back to Princeton so it was really nice being able to catch up with him as well. And then dinner with James too and then Amy’s little birthday surprise. Anyways, I think I’m just grateful for people here
- I am grateful that Umma and Appa love us very very much and that we got to say goodbye to Halabogi and Halmony today

11/30/24 (Day Rating: 7/10)
- Today was a solid, productive day. Went to bed at midnight, woke up at 7, and killed a breakfast with the family so that was very cute and I am grateful to eat breakfast with everybody
- I am grateful that we saw so many people at the library today and then sat with ethan and justen. And then I’m happy that we saw Ryun at the library too!
- I am grateful that we finished a large chunk of EEB studying today. That was good on us. Productive. Happy. And then we are going to church in a bit so that should be fun too.

11/29/24 (Day Rating: 3.5/10)
- Learned a few lessons today so honestly today was still productive. Lesson 1: Perhaps we are going to take a gap year. Lesson 2: If you’re ever driving with someone, always, and I mean ALWAYS, know where they parked even if I’m not the one driving because it’s a waste of my time if both of us can’t go home. Lesson 3: Never go black Friday shopping at the mall ever again. That was disgusting.
- I am grateful that we got to finish off the day with some studying at Bethpage library in a private study room. That was quite unexpected but also quite nice
- I am grateful that we got to wake up at 3pm today…. Like, that’s kinda crazy ngl

11/28/24 (Day Rating: 4.5/10)
- I am grateful that we got to see the entire family for thanksgiving today and then eat very yummy food and lots of it
- I am grateful that umma took out our teeth attachments today
- I am grateful that we got to play poker with the family today and win 5 bucks hehe that’s cute.

11/27/24 (Dat Rating : 5.2/10)
- I am grateful for physical therapy that honestly went decently well so I’m proud of ourselves for that and happy that we can expect to go back to the gym hehe
- I am grateful that we got to watch a movie with Josh tonight that was fun. And the movie “Forgotten” had so many plot twists it was so unexpected.
- I am grateful that Ronnie Immo and her family came today and we got to see them and talk to them today

11/26/24 (Day Rating: 5/10)
- I am grateful for sleep
- I am grateful for haircut
- I am grateful that Alice reached out and asked if we could hang even though we couldn’t… it’s nice that I have people who want to spend time with me tho 🙂

11/25/24 (Day Rating: 9/10)
- HOME! And I am grateful for Grace and that we were able to spend time w her on our way home. She gave us lots of good advice
- I am grateful for the conversation we had with Tim, James, and Grace throughout today. All three of them gave us some really interesting advice and found such different paths through their lives. And I’m so grateful that I’m able to go to a school where I’m able to see these diverse viewpoints
- I am grateful that we got to see Halabogi and Halmony today YAY. And then umma and appa too!

11/24/24 (Day Rating: 8/10)
- Such a cute day today I am grateful for Jacob’s well and for a loving family who was willing to invite us to their home
- I am grateful for being able to play tennis for the first time since high school today (we could only play with one arm tho because of our arm haha)
- I am grateful for DOGGO!!! And then cute babies. I love church.

11/23/24 (Day Rating: 6/10)
- I am grateful that we got to study a lot with Nathan today and walk to small world with him. It’s the little things that should bring us joy 🙂
- I am grateful that we got to laugh so much at open room at like 2am today. Delaan is soooo funny dude.
- I am grateful that today is finally the weekend YAY

11/22/24 (Day Rating: 7.5/10)
- I’m grateful that we got to have tteuokbokki making session today that was super cute and enjoyable and I had a good time 🙂
- I am grateful for being able to wake up somewhat early in the morning. And then we accomplished a lot of the things that we were planning on doing so that was productive
- I am grateful that we got to spend a lot of time with Tim and Payge today! They’re cute.

11/21/24 (Day Rating: 5.2/10)
- I am grateful for being able to wear our trench coat for the first time today and feel fancy 🙂
- I am happy that MOL precept ended early today and that EEB lecture was actually so much fun and interesting. And then also the fact that we didn’t have to do anything in GHP was nice, and we bombed our microbio quiz but that’s okay.
- I am grateful that with only 5 hours of sleep, we are functioning pretty well today and not really tired so that is good on us 😌

11/20/24 (Day Rating: 4.5/10)
- I am grateful we got to get boba with Evelyn today that was cute and fun and enjoyable
- I am grateful that we got to sleep pretty well and wake up at like 10:45 so we aren’t tired doing the day. And then grateful for dinner w Kevin, Jack, Steph and Xuanying today
- I am grateful for being able to talk to Anthea until like 2ish. But it led us to a lot of thought hmmm

11/19/24 (Day rating: 5.01/10)
- Today’s not even over but I’m just bored out of my mind in microbio so I’m gonna write progress for today. I’m grateful that we got to have lunch today with Stephanie, Grace, Michael and Monica today that was cute.
- I’m grateful for dinner w Kiran! Having friends is nice. And then I’m happy we were able to get the Korean presentation over with without embarrassing ourself too much.
- I am grateful that we get to serve the frosh by doing praise. Like I really want to grow a heart of gratitude for the ability to serve the unders.

11/18/24 (Day rating: 7/10)
- 7/10 because I am learning more and more about who I am as a person. A lot of work, a lot of self-reflecting, a lot of progress, but a lot of growth so I am content with where I’m at.
- I’m grateful that we got to get lots of work done today like our JP topic thingy and then our GHP project is in the making after our meeting with Arbel today
- I am grateful for Payge and Evelyn. They always make me feel better when I’m just around them.

11/17/24 (Day rating: 7.5/10)
- I am grateful that we got to wake up in the morning and go to Jacob’s well and didn’t miss church 🙂 I am happy Michael and Jocelyn exist
- I am grateful Evelyn was happy to see us at colo today and smiles all the time which brightens my mood
- I am grateful for dinner with Koki! Friends are cute.

11/16/24 (Day Rating: 8/10)
- We got to spend the end of the day with umma so I am grateful that we got to be with umma. And then we talked a lot with her too so I’m happy
- I’m grateful that the dental school tour is done and over with and we don’t have to think about it anymore. SCREW PLANNING THAT
- I am grateful that we spent the rest of the night in open room with other people that is nice.

11/15/24 (Day Rating: 7.5/10)
- Today was a good day. I am grateful that today was a good day since it’s been a while since I had a good day. We went to all of our classes (of course with the exception of biochem) and then we cooked for the sophomores so that was pretty cute
- I am grateful that we got to have a lot of fun with friends today and went to the little ball thingy at dillon and then also
- I am grateful we got to go to open room towards the end of the day and hang out w Manna people

11/14/24 (Day Rating: 6.5/10)
- I am grateful that we were able to go to all of our classes today and then also talk to Kevin at dinner. That was enjoyable.
- I am grateful for Evelyn’s joy as per usual to always bring my mood up.
- I am grateful that the dinner prep went ok today and we were able to bond with our class a bit.

11/13/24 (Day Rating: 5/10)
- I am grateful we were able to go to both of our attendance required classes 🙂
- I am grateful for Evelyn and Payge. They are so cute and always smiles and laugh and are so pleasant to be around so I am grateful for friends like that who can always be a ray of sunshine in my life
- I am grateful that we have James as our discipler and that we can just grab dinner with him and such

11/12/24 (Day Rating: 6.9/10)
- CHIC FIL-A w michael and jocelyn and jocelyn is a very good driver so I am happy that she drove us to grocery store and such
- I am grateful that we got to go grocery shopping for the sophs today and that everything went pretty smoothly there
- I am grateful that we did not have a micro bio quiz today thank u lord haha

11/11/24 (Day Rating: 6.8/10)
- CHOI SSN IS TOO CUTE 🙂 I am grateful to have teachers who care about me like that
- I am grateful for friends who care about me and ask how we are doing healthwise hehe
- I am grateful that we found anki this is such a good study strat

11/10/24 (Day Rating: 3.5/10)
- I am happy that we made a lot of anki flashcard progress today and that we finished both our Korean homework and our microbio homework. So good on you for being productive
- I’m grateful for the combined manna meal that we had today
- I am grateful that the MRI went well and appointment happened

11/9/24 (Day Rating: 4/10)
- I am grateful for Ryun < 3 She gave us some presents from Korea today and I am so thankful for her cause that’s kinda exactly what I needed… I love home friends 🙂
- I am grateful for appa loving us and making us lots and lots of food
- I am grateful that we are feeling ready to go back to school with anki and kick its ass.

11/8/24
- I am grateful that we got an MRI appointment setup
- I am grateful that we got to sleep in our home bed today.
- You know what, this is supposed to be a gratitude journal but I’m going to just make this into a regular journal. DUDE IM SCARED. It’s finally dawning on me that it’s been a week and I still can’t move my shoulder past 90 degrees, and I’m searching up what to friggen do and the only answer from both the doctor and google is just surgery or time AND I DON’T WANT SURGERY WHAT THE HECK I JUST FELL OFF MY FRIGGEN BIKE. Why can’t I move my arm…

11/7/24
- I am grateful that umma came to bring us home and that we were able to get our shoulder approved for an MRI
- I am grateful that I have a loving family and friends who care about me
- I am grateful that we got to go to all of our classes today

11/6/24
- I am grateful that biochem test is done and over with
- I am grateful that we got to have dinner with Tim 🙂
- I am grateful we got to spend the evening with Josh

11/5/24
- I am grateful that we got to watch the PPE concert today that was so fire and undertale < 3
- I am grateful that there was no microbio quiz today
- I am grateful that Kim Ssn was understanding about us skipping Korean 😭😭

11/4/24
- I am grateful for the little walk we had with Jocelyn towards the end of the day that was nice
- I am grateful for my Brian grabbing small world with me today
- I am grateful that we got to talk with Kim ssn today 🙂

11/3/24
- I am grateful that we got to go to Jacob’s well today with Jocelyn and Michael and pretty much spend the entire day with them. Jacob’s Well was such a blessing today so I am happy about that
- I am grateful that we got to fix our bike today at cyco-lab 🙂
- I am grateful for my friends who care about me.

11/2/24
- I am grateful for Esther being at JSG today to answer a lot of our questions about theology 🙂
- I am grateful that we got to spend a huge chunk of the night talking with the frosh at Open room!
- I am grateful that umma is okay after her car accident and nothing was hurt too badly

11/1/24
- I am grateful for having lunch with tiffany today
- I am grateful that Choi ssn was nice to us today and is always smiling when he sees us
- I am grateful for our Manna meal today with Ellie and Kenan and Alpha. I am happy that all the frosh are so tight.

10/31/24
- I am grateful went to all of our classes today: 2 precepts for attendance, 2 quizzes for lectures, and 1 EEB thingy that we recorded and did not pay attention to at all haha
- I am grateful that we had lunch with Sean today 🙂 He is such a sweet frosh
- I am grateful that Amy exists to bring our mood up all the time. And then I am grateful for Grace’s message too

10/30/24
- I am grateful that we got to have dinner with Koki today and finally talk with her more than just a passing wave haha
- I am grateful that we saw Amy today and we got to give her a cupcake!
- I am grateful that chic fila happened.

10/29/24
- I am grateful that we got to have dinner w James today 🙂
- I am grateful that we got to call umma today
- I am grateful that we watched a movie w heather/lynn today and heather gave us her jacket cuz I was cold

10/28/24
- I am grateful that Amy is always happy to see me she is so sweet and I love her energy so much. Fun dinner with her as always
- I am grateful that Tim was able to grab lunch with us today!
- I am grateful that there was only one class today (well, only one that we went to…)

10/27/24
- I am grateful that we got to go to church today.
- I am grateful that we had dinner with Michael today
- I am grateful that we got lots of work done

10/26/24
- I am grateful that today was a productive day even though we rotted at Stone.
- I am grateful for Chloe always being so bright and positive
- I am grateful that we got to see Chris, Rachel and Jordan at Stone today

10/25/24
- I am grateful that we got to spend a lot of time with my friends today. Celebrate 2 birthdays and got to play secret hitler in open room for a while
- I am grateful that choi ssn met with us today and talked with us about things that made us smile. He is such a ray of sunshine
- I am grateful that we got to spend a lot of time with Payge today she is so sweet and I love spending time with her

10/24/24
- I am grateful that we finished our GHP presentation today. That is done and over with and we don’t have to worry about it anymore
- I am grateful that we got to talk with kim and choi ssn today when we just saw both of them randomly while we were walking. I enjoy the korean department so much dude
- I am grateful that we got to learn a lot from Daniel today at lunch. He taught us a lot about emotional maturity, putting others before ourselves, and how thoughts, depending on what they are, can or won’t become sinful.

10/23/24
- Welp I’m grateful that we finally got to grab dinner with Kiran and eat at charter
- I am grateful for seeing Amy at the gym today and she was so happy to see us. I love it when people are happy to see us.
- I am grateful that the GHP presentation is going well

10/22/24
- I am grateful that we were able to successfully do a Michael birthday surprise today 🙂 I hope he had a very very good birthday today and I am grateful that he is my friend
- I am grateful that Graham was so enthusiastic about having us onboard she’s so nice.
- I am grateful for the response we got from her text today.

10/21/24
- I am grateful that we got to see Payge and she showed us the most adorable pictures of her and her family dressed up with matching costumes she has the most adorable family ever
- I am grateful that we saw Amy today at Firestone and she was so happy to see us so that instantly made my mood better
- I am grateful that we were honestly really productive today and got a bunch of work done

10/20/24
- I am grateful that we made it back to school safe and sound and that everything is going to be okay
- I am grateful that we got to have lunch with appa, Joey, Soogomo and Uncle sagun. And then the pho that we ate was pretty yummy too so I am grateful for yummy food
- I am grateful that we got to be productive towards the end of the night at Stone and drop off a bunch of our little errands around campus hehe

10/19/24
- I am grateful that we got to get our haircut today and that we got a downperm for free
- I am grateful that we got to have a dinner with appa and umma today (and Joey was there too)
- I am grateful that we got to take the most fire 5 hour nap today

10/18/24
- I am grateful that we got to go to Arata with umma and halabogi today that was very very yummy and I enjoyed it a bunch since we were with umma and halabogi
- I am grateful that we got to go to Pastor Sam’s Bible study and that lots of the kiddos said hi to me at church 🙂 That means that they actually like me and so I am grateful that they like me
- I am grateful that appa made us some salmon, steak and egg today he really really loves me :LKSJDG:LKSJDG:LKJSDG I’m gonna cry

10/17/24
- I am grateful that we got to see DAVID WANG TODAY and he is doing okay (I think..?) But no I am so grateful that he reached out and we got to grab chipotle together 🙂
- I am grateful that we got to go to the AlignUs college talk today hehe and that we got to see the young people and attempt to help them with college thingies
- I am grateful that NAP happened < 3

10/16/24
- I am grateful that today was basically a day of rest hehe. Like we attempted to do some of our work for GHP but then failed epically but then I am grateful that we failed epically because what we ended up doing was refinding a passion for crochet, listening to sermons, and playing guitar and all of that was fun fun fun
- I am grateful that we got to see Halabogi today!! And then I am grateful that there is lots of yummy food here at home
- I am grateful that we got to be helpful and drive Joey from Bethpage State park

10/15/24
- I am grateful for an entire home day today this makes me lots of happy being here : ) And then I am grateful for umma and appa and Joey and home food which is always yummy and then we had a chipotle bowl today WITH GUAC
- I am grateful that we got to go all across syosset today like the library and then shopping center and then Josh’s house and mongos and paris baguette so I’m grateful that we are home
- I am grateful that we got to splurge a little bit on temu hehehe new clothes >>

10/14/24
- I am grateful that we got to have a productive meeting with Moeller today (a little bit embarrassing looking back on it but it was enjoyable nonetheless hehehe)
- I am grateful that we got to get home safe and sound and see umma and appa and Joey and eat yummy dinner with them and that we are home in our bed rn and home and home and home
- I am grateful that we got to see Vivian on the train ride back from Princeton to Penn station and basically have like an hour long conversation with her for that entire time back home hehhe

10/13/24
- I’m grateful that we got to go come back to Princeton safe and sound from the Manna retreat. It’s so so happy to be back and we also were able to grab dinner at Noodle House with the baos so I’m grateful about that too
- I am happy that we didn’t nap and that we fixed our sleep schedule right after retreat this is honestly something to be proud of ourselves for and pretty impressive ngl. And then I am grateful that we got to really just rest (not physically, but spiritually/emotionally/mentally/socially/academically)
- I am grateful that we had the courage to share during the testimony time of the retreat. I’m proud of us for that.

10/12/24
- I am grateful that we had a super full day of retreat today this was so so nice and I am so so happy that I am here and able to bond with the community here in Manna
- I am grateful that James Jun shared his vision for Manna in such an impactful and convicting way which really stood out to us. We need to learn humility Jonathan. This is the most important and most convicted we’ve ever been about this. Learning to be humble is so important, it’s so hard, but I want to become it so bad
- I am grateful that everyone was so honest during our class sharing time and that we were able to truly see each other’s raw, true hearts. And then I am grateful that we were also able to just have fun with everybody and talk and enjoy one another’s presence. Games are fun, camp fire was fun, everything was fun.

10/11/24
- I’m grateful for the first day of fall retreat today this is so excitinggg. And then I am grateful for being able to go to lab today and then talk with Payge lots and then also we got to talk with Cevina too so I am grateful that went decently well : )
- I am grateful that we got to get to the retreat center safe and sound and that also we were able to get bent spoon ice cream with Jessica and Rachel today!!
- I am grateful that we got to have a lot of fun throughout the night just playing secret Hitler and talking with people and just enjoying being in everyone’s presence.

10/10/24
- Both midterms are done. I am grateful both midterms are done.
- Such pretty lights today I am happy I got to take many many pictures of it
- I am grateful that we got to watch funny reels on instagram to destress after midterms lol

10/9/24
- I am grateful that we got to get so much studying done that was a lot a lot of studying done so I am proud of us for being productive
- I am grateful that we talked with Evelyn and Payge today they make me happier
- I am happy that I am on the final stretch of this studying

10/8/24
- I am grateful Quin gave us a cranberry mocha drink today that was very very good and I am happy that we got to have that experience drinking it hehe and also I am grateful that Yoon gave us some snacks while we were very sad.
- I am grateful that we got to skip all of our classes except for Korean today and that we hit a few PRs on deadlift hehe and then I am grateful that we got to go to a talk thingy with Julia/Heather about a book
- I am grateful that we got to walk with Rebekah towards the end of the night but I am ver jealous of her dorm cause it’s so much more aestheticer than ours.

10/7/24
- I’m grateful that we got to see puppies today hehe and then I am grateful that we didn’t have to go to any classes woohoo
- I am grateful that we got to talk with Kim ssn about her dating life and then also I am grateful that we got to have a very productive Korean tutoring session
- I am grateful that we finished up our EEB lab thingy today

10/6/24
- I am grateful that I got to go to church today and that we are feeling a lot better and are getting in the right headspace now thanks to friends. I am grateful that we got to eat yummy food at colo today
- I am grateful that we got to get a leg day over with at the gym and then also that we were able to find a nice little study room in colo to work in with the baos so that was enjoyable too
- I am grateful that I am able to have so much freedom here and do basically whatever I want with my time at Princeton with my friends.

10/5/24
- I am grateful that we got GHP and Korean done with today and then listened to a biochem lecture that we missed out on yesterday. And then I am grateful that we got to see Katie and lots of Manna people at the cone today heheh
- I am grateful that we got many many free coffees today that is something that I am happy about.
- I am grateful that we were able to study with Stephanie and Monica throughout the day at Stone! That was nice and then we had some interesting conversations about how we view Manna and the hope that we have for our junior class

10/4/24
- I am grateful that we got to see kim ssn today and talk to her about fun things during the Korean session today the fact that she opens up about stuff like that makes me feel so happy
- I am grateful that today was full of people today < 3 I am happy that we were able to talk with Julia throughout lunch today so that was cute. And then also I am grateful that we got to sign in at the club meeting thingy that we just didn’t go to
- I am grateful that I am just not taking the physics test that literally everybody else is worrying about hehe

10/3/24
- I am grateful that we got to finish all of our meetings today which was honestly quite a lot haha. Woke up and then went to GHP, MOL precept, bio lecture, lunch and then mol lecture, korean, ppda, share @ colo, dinner, gym, and work
- I am grateful that we were able to see Michelle today! So that was nice and then also we got to take lots of yummy food from colo today too so I’m grateful for that
- I am grateful that kim ssn was nice that we were fully texting during class today hehe

10/2/24
- I am grateful that I got to listen to 2 lectures that we missed today since it was recorded so yay not going to lecture is still playing out in our favor a little bit and then we did it in half the time hehe from times 2 speed so I’m grateful that we have so much cooler tech now
- I am grateful that we got to talk to lots of people today and go to Korean language table and that also Esther/Daniel gave us a ride back up campus hehe
- I am grateful that we got to try out matcha at the farmer’s market today and it was honestly vv yummy so that is something to be happy about

10/1/24
- I am grateful that we got to get 2 of our quizzes over with today so that is something that I am happy about and then also I am happy that we got to go to all of our classes today
- I am happy that we got to have dinner with Amy today and then I am also grateful that we got a free coffee in the morning 🙂
- I am grateful that we got to go to Cevina’s dorm at night time and are currently laying in her bed cause it’s comfy!

9/30/24
- I am grateful that we got both the biochem test over with AS WELL AS a stupid leg day hehe and then we are switching up our leg day routine to be a bit nicer on our knees so there’s that to be grateful for as well I’m sure that my body will be thanking me in the future for that
- I am grateful that we are going to go to Korean language table with Julia today and that we will see choi ssn there hehe
- Grateful that I have so many friends here who talk to me and make me laugh

9/29/24
- Today was literally just work work work but honestly I’m grateful that I’m able to have days that are literally just work work work. And so we got to biochem studying done and then laundry and then also we did some korean work too so that’s all something to be proud of
- I am grateful that we got to have dinner with Kevin, Michael and Oleg today hehe and then I’m grateful that we had lunch with Evelyn
- I am happy that we were able to not study completely alone today even though we are on the C-floor of the library and that we were able to have company throughout our painful endeavors hehe

9/28/24
- I am grateful that we got to talk with Kevin a bit today and that also we were able to hit the gym with Joie so those were both things that made our day more exciting than we were originally planning
- I am grateful that we were able to grab dinner with Heather, Michael, Stephanie and Lynn today and that was nice and we had an interesting conversation
- I am grateful that we got to go to colo semis today for a little bit and get cool food and then also I am happy that we were able to go to Cevina’s room and study a bit there too ehehe

9/27/24
- I am grateful for the full day of everything that we had today and also I am grateful for the nap that we took I like that we were able to sleep in Frist so that we are not super duper lazy in our dorm
- I am grateful that we got to hang out with Payge and Tim for a bit at FriYeh and have very very interesting conversations with them about religion so that was nice! And then I am grateful that we were able to go to all of our classes today 🙂
- I am grateful that I got to text Cevina a little bit today too that makes me happy to do

9/26/24
- Phew what a day… we had our GHP precept, MOL precept, EEB lecture, study for quiz + send out emails for kick off meetings before MOL lecture, then KOR lecture, and then pick up everything for Kick off meeting before going to kick off meeting, officer dinner, and now we are in the library trying to digest before going gym. And I think I am absolutely worn for the day. DONE.
- I am grateful that I got to do well on the mol quiz today and that we knew the answer since we studied specifically what he tested.
- I am grateful that we got to accomplish every meeting that we had planned for the day…

9/25/24
- I am grateful that we honestly had a pretty productive day today. We studied lots and lots of biochem today for our test that is coming up pretty soon so that was productive and I am happy that we were able to be productive !!
- I am grateful that we got to see Kevin today and then study with Kevin and Jocelyn in the library for a little bit hehe and then Kevin bought us onigiri so that was super cute and sweet of him to do and I am grateful for Kevin and that he is here for the year
- I am grateful that I learned that Xuanying is not leaving us for Cambridge next semester so I’ll have another friend!! YAYAYAYAY

9/24/24
- I am grateful that I got to go to all of my classes today and that there was no quiz in microbio today so that is something that I am happy about hehe And then also that we got to talk to James for a little bit so that was good too.
- I am grateful that we got to get some free merch (not a lot tho) at the giveaway today so I am happy about that too. But the sizes didn’t fit me very well soooo
- I am happy that we are currently sitting in Cevina’s dorm and playing with her volleyball and talking w her so that is another thing that I am grateful for today.

9/23/24
- Hmm let’s see the things I’m grateful for today. Well we woke up pretty early so we were able to get a bit of work done before bio chem today so that is something that I am happy about yayaya. And then biochem kinda sorta made sense today so grateful for that as well
- I am grateful that we got to get a leg day done and over with today hehe that was productive. But I think our knees are starting to give out so perhaps we should be more careful when we are doing our squats… is this normal am I supposed to feel like my knees are giving out…
- I am grateful that we got to meet with prof today and talk and that also we were able to have an extended Korean tutoring session today both of those were a lot of fun and enjoyable and I am grateful that I got to experience both of those. And then dinner with Tina today too is another thing I’m happy about hehhe

9/22/24
- I am grateful that we got to get a lot of the things that we wanted to get done done today. Like we finished our Korean HW, the bio chem PSET, we prepared a few interview question for Moeller and then finished our GHP reading thingy. So that is all productive and all things that I am happy that we were able to accomplish
- I am grateful that we were able to hit the gym today and get a somewhat of a new PR on our chest day. Hehee and then also the fact that we literally ate like 5 times today I think we should start watching how much we eat Jonathan. I think it’s a bit excessive LOL
- I am grateful that we got to go to church today and that we talked with Michael and Heather during brunch, and then also that we were able to get our free Nightly merch so that is exciting I hope that our sleep gets so so much better.

9/21/24
- I am grateful that today we got to have lunch with Rebekah today and speak/practice our Korean with her so that was a lot of fun and enjoyable and I am grateful for that. And then also I am grateful that we got to see Cevina this morning 🙂
- I am grateful that we got to do a lot of work at the library today and that we were able to hit a lot of new PRs at the gym today with our back/bi day. 255 deadlift for 4 is a first hehehe
- I am grateful that we got to listen to a lot of podcasts today and then pick up a few packages and then also just organizing our academics hehe

9/20/24
- I am grateful that we got to wake up p early today and hit a few new prs at the gym and that we were able to go to our bio chem class and Korean class today and the Korean individual session was super enjoyable I had a really really great time 🙂
- I am grateful that we got to have lunch with Julia at Terrace today and check out a new eating club and that there was David, Michelle, Lynn, and Koki there (what an interesting group that we somehow know everyone like that)
- I am grateful that we got to spend time with Payge and Tim today that was super duper cute

9/19/24
- I am grateful that I was able to go to *most* of our classes today that was nice 🙂 And then also we were able to get a leg day over with today so that is something else that I should be grateful for. Squats and leg day suck.
- I am grateful that we got to honestly be pretty productive today and that we were able to make the cutest tiger at the stuff a tiger thingy tonight : )
- I am grateful that I got to get lunch with Steph/grace and then dinner with Charles/Chris both of those meals were enjoyable and the fact that we don’t eat alone always is such a blessing so I am grateful for that
- I am happy that I got to play with Cevina’s hair today 😌😌

9/18/24
- I am grateful that today we were able to go to all of our classes and be decently productive in most of them (like I think this was the first bio chem precept that we were able to completely follow) and then we also went through about 500 Korean flashcards during GHP today which was pretty impressive if I do say so myself. And then also we were as always left in the dirt in biochem lecture but it’s okay
- I am grateful that we are able to grab dinner with Lindsay today 🙂 YAY And then we can practice our Korean with our chingoos so that is something to always be happy about
- I am grateful that we moved up to 70s for our incline bench now and also I am grateful that we got to wake up early today and get a decent amount of work done before we started off the day so yay for that

9/17/24
- I am grateful that we got to have dinner with cevina today and that we were able to talk with some of the profs at the EEB meeting thingy that was cute
- I am grateful that we were able to talk with Jessica too and she is such a cute human being and so observant I love her sm for that
- I am grateful that we got to see Tina today! It was a nice coincidence and she’s cute too and I’m happy to see she’s doing well

9/16/24
- I am grateful that today was a productive day and not too stressful and that we got to hit new PRs at the gym and see lots of friends and improve myself in a lot of ways < 3
- I am happy that I got to study lots of Korean today and that I was able to grab the most fire colo lunch ever like that was so friggen tasty idk if i’ll ever ever EVER eat something that good at Princeton ever again so I’m grateful
- I am grateful that 김 선생님 moved the presentation slides back a few days so that we can have more time to prepare and made that slide show hehehe

9/15/24
- I am grateful that we were able to go to church today and that we were able to be decently productive and spend the entire day w Michael/Jocelyn so that was a lot of fun. We got a lot of work done 🙂
- I am grateful that we got to eat such yummy food at colo I love colo food sm and idk how I’m supposed to live next year w/o it as;dlkgjasdg
- I am grateful that we got to get a leg day at the gym over with and that we were able to have a lot of super funny conversations with our friends today < 3

9/14/24
- I am grateful for the entire day we had since we were pretty productive, learned a lot, hit the gym, and got to see Cevina and know that she is doing alive and well (somewhat) so I am happy about that.
- I am grateful that we saw Cevina eat fruits and protein today 🙂 YAY I feel so accomplished
- I am grateful that I got to have lots and lots of yummy food throughout today too at colo I think the dinners here just go so hard idk how I’m going to go back to no colo.

9/13/24
- I am grateful that we got to have our first EEB lab today! That was a lot of fun and Payge and Rachel are in it so I am grateful that we are going to have a super swag EEB lab group for this semester
- I am grateful that we got to have our little photo day of taking a walk while listening to a podcast and taking pictures on campus that was super duper relaxing and stress free and I love it sm and it’s so great 🙂
- I am grateful that we got to see Cevina today

9/12/24
- I am grateful that we had a full day of so much meetings and classes and such. We woke up for our 9am GHP class, then 10am mol precept, then 11am EEB class, lunch and 1:30pm Mol lecture, and then 3pm Korean class, and then 5pm dental meeting and then dinner, and then gym before going to bio chem review sesh, and then open room before tutor joey, and then we went home to do work
- I am grateful that we got to see so many of our friends today and I very much hope cevina does not get any worse : (
- I am grateful that we got to call umma and appa today they are so cute

9/11/24
- I am grateful that we were able to go to all of our classes today! It was a fun day too and we were able to accomplish much (when it comes to Korean I think we found a pretty good system. I think we just need to find a working system for everything else now)
- We got to have dinner with Joie today and then Kevin and Nick and Jerry so that was all nice! And then we had our GHP lunch today where we learned everything
- And I am grateful for getting a leg day over with 🙂

9/10/24
- I am grateful that today was a pretty productive day and we figured out a lot of what we should do for learning Korean (meals with Lindsay, talking w Cev, reading during gym, and flashcards during boring classes!) So I am grateful for this session
- I am grateful that we got to go to all of our classes today and that we had dinner with Stephanie and Grace today that was enjoyable and the food was honestly pretty gas as well 🙂
- I am grateful that we had an easy MOL quiz today and that we were able to be decently productive throughout our entire day

9/9/24
- I am grateful that we got to go to only 2 classes today and honestly we were very very productive throughout those lectures hehe we got to study an hour of anki Korean flashcards LOL
- I am grateful that we got to study a lot today and be very very productive with learning 🙂 That’s kinda a few feeling lol
- I am grateful that we got to hit a lot of new PRs in the gym and we finished our workout in a record time today which is something to both be proud of and impressed about

9/8/24
- We had a very VERY fun day today so I am grateful that it was fun < 3 We got to take lots and lots of pictures for our friends today so there’s always something to be grateful for in that
- I am grateful that we got to go to Lawn Parties today and eat some (probably unhealthy) yummy food so that makes me smile
- I am grateful that we got to have dinner with Stephanie, Grace and Joie today we had a very fun conversations with them so I am happy about that too

9/7/24
- Today was also a very enjoyable day so I am grateful that it happened even though there were a lot of minor inconveniences that we learned about. We were able to switch our MOL 380 and our GHP precept times so that we can have our EEB junior tutorial thingy so that was convenient (I guess)
- I am grateful that we got to go to the first Manna Large Group today and then also that we had colo carnival that was pretty cute and fun as well heheh
- I am grateful that we got to get a leg day out of the way today and also that we were able to meet a lot of the frosh throughout large group at manna today

9/6/24
- We only had one class today (biochem) so I am grateful that we only had one class today 🙂 And then the rest of the day was free and then we somehow got all of the clicker questions right (although they didn’t count lol)
- I am grateful that we got to have the interview for Kesem and also we finished TCIF shift super duper early so that was happy
- I am grateful that colo dinner was very very tasty and that we were able to hit a good chest day with many many PRs and that we were also able to take a few pictures today. Now we know that cloudy and nighttime are the worst times for pictures

9/5/24
- Today was a good day since we were mostly productive and did a lot of thingies outside the dorm 🙂 And then appa delivered our bike today so that is going to save us so much time and then also I love him since he drove all this way and fixed our bike for us < 3
- I am grateful for being able to go to all 4 classes today, hit the gym, meet new people, and finish our application for the Kesem officer position today we had a decently productive day so that is always something to be grateful for.
- I am grateful that Cevina was born 20 years and 1 day ago LOL

9/4/24
- I am grateful for another full day (sort of) of classes 🙂 We got to sit with Payge in both MOL and GHP so that was both fun and then we had BBQ with Michael and Jocelyn which was a surprise for our day! We ate a double cheese burger HEHHEE
- I am grateful that we got to have a productive PPDA meeting and plan out thingies for the year and then I am also grateful that we got to hit the gym today and hit lots of PRs for shoulder day (the rear dealt exercise goes crazy)
- I am grateful CEVINA WAS BORN 20 YEARS AGO and her birthday hangout was fun < 3

9/3/24
- I am grateful for a full day of classes today it was honestly pretty enjoyable and I am happy that I got to see so many of our friends 🙂
- I am grateful that we got to have like a 1.5 hour walk with Cevina that was the cutest thing ever and it’s really nice to be able to just take meaningless walks like that
- I am grateful that we got to eat chic fila today and then that we were able to go and see Kevin with Michael so that we can see how he is doing! And then open room after that was pretty fun as well.

9/2/24
- I am grateful that today we got to have a lot of fun at the ice cream social and we got to take pictures of everybody so that was exciting to practice our photography abilities hehe. And then I am grateful for all of the people that I met there and all of their hearts
- I am grateful that we bumped into Heather and Julia on our way out of the gym and got to have fun stretching with them. It was so much fun and Julia tried teaching us hand stands and the skipping thingy where you don’t touch the floor and then how to be flexible and there were so so many cool things that we are never going to be able to do that Julia can and it was so cute what a way to end the night
- We got to grab dinner with everyone in the baos group so that was fun too. And then we also met lots of new people today and then went to the PCF prayer thingy so lots of happy vibes

9/1/24
- I am grateful that umma and appa came today and delivered this fan which was SO NEEDED OML like I slept like a baby throughout the night solely because of that and I am so so grateful that they came all the way over here and then bought us dinner too 🙂
- I am grateful that we got to finish off the day in open room and play super smash with everyone that was a lot of fun too and James seems to be doing so much happier and vibes were good and I am so grateful that I know so many great people here on this campus
- I am grateful that we were able to get a decent amount of work done today since we woke up early in the morning and then I am also grateful that we finished applying to the Rose Castle thingy hehehe

8/31/24
- I am honestly really grateful for today since we moved in quickly, fastly and okay. And then I am grateful for umma and appa who helped us move in very very fast. And then as much as I am not looking forward to the school year, I am grateful that we are literally at Princeton University.
- I am happy that we got to see a lot of our friends today and do puzzle with Cevina/Rebekah/Heather/Lynn and then go to Cevina’s home later in the night to take pictures muwahahah
- I am grateful that we got to have a manna dinner with a lot of the sophomore guys that was fun to see them all and it is so weird that I am a friggen upperclassmen now

8/30/24
- Today is our very last day at home so we are grateful for the past entire summer. ❤ So much thingies to be grateful for this summer so that makes me happy that we were able to do this entire summer with very minuscule amounts of stress
- I am grateful that I got to hit a final gym day at blink today 🙂 That was the end of a productive workout summer too and I think we hit a lot of new PRs there
- I am grateful that we got to eat lunch with Brooke and Josh today at Mad for Chicken 🙂

8/29/24
- Today we got to go to Old Westbury and take a bunch of photos there and practice a lot of photography so I am grateful and happy about that this hobby is actually so much fun lol
- I am grateful that we got to have a very relaxing day today full of naps and such and that we were able to also have dinner with umma and appa 🙂
- I am grateful that we put on the paperlike protection screen case and didn’t have to spend like 5 hours on it like we had to last time. And then we also got our temu order today 🙂

8/28/24
- I am grateful that we got out new IPAD today for FREE HEHEHE apple warranty is the bestest thing ever. And then we found our apple watch and the charger and got to set that up too so I am grateful for that
- I am grateful that we got to go to the gym today and hit a productive chest workout
- I am grateful for ninja creami omg it is actually a life saver. And then we also ordered like protein powder and the screen protector today so all the more reasons to be grateful

8/27/24
- I am grateful that we got to go on a nature walk today and take a few pictures there that was honestly a lot of fun, really relaxing, and I think we figured out how to triple task this hobby now (walking + photos + audiobooks/podcasts)
- I am grateful that we also got to practice taking pictures at stillwell and see the little wildlife there HEHE we are going to become a professional national geographic photographer nowI am happy that we got a leg day over with so we don’t have to worry about that for a hot sec

8/26/24
- I am happy that we got to practice PHOTOGRAPHY TODAY we need to become an expert in this field so tmrw we shall go to… OLD WESTBURY GARDEN to practice our pictures
- I am grateful that we got to try a new halal restaurant today which the combo was really good, never ever get the specialty again tho that was nasty
- I am grateful that we found EMPRESS KI AGAIN YAY

8/25/24
- I am grateful that we got to eat POKE TODAY MUAHAHHA that was so yum and then we also didn’t absolutely die in church from pulling an all nighter like an idiot
- I am grateful that we got to have a productive morning with cleaning, organizing, and hitting the gym and ICE CREAM and then we finished our last shift as the church slide maker 🙂
- I am grateful that BABIES came today LOL

8/24/24
- We went to the apple store today since our ipad was broken and we are getting a new ipad for FREE NOW?? Okay this warranty thing is so broken idk why I don’t abuse it more. But yea we are happy for that
- I am grateful that we got to get a haircut today so now we don’t have to be annoyed at our super long hair anymore
- I am happy that today was a good rest day from the gym and that we got to spend a lot of it driving around with umma and appa cause we also got to eat out. And then we saw Halabogi too and he said that we made him mood happier just by seeing us 🙂

8/23/24
- I am grateful that we got to do a back and bi day today muahaha and we are getting stronger too! Making some comeback progress.
- Appa made us the most FIRE meal today. And when I say FIRE, I mean FIRE. There was steak and tteubokki and makeral and (idk how to spell anymore geez) but I felt so happy
- I am grateful that we got to work a bit on our blog post today I feel like that was a good thing to get on paper. And then also I am happy that we got to meet with Soonho today as well

8/22/24
- I am grateful that we got to set out a bunch of fits today to prep for the upcoming school year. But we probably should start organizing lol.
- We got to hang out with josh for a little bit today and then show off the new car LOL I think I feel so cool for having this car
- I am grateful for a productive chest day at the gym

8/21/24
- I am grateful that we got a new car today?? A convertible is so over the top LOL but that is also of course obviously something to be immensely grateful for. And then I am grateful that appa took us to the car dealership so that we could see what it is like purchasing a new car
- I am grateful that we got to have yummy foods at Smithtown mall today hehe we got pizza and tacos and sortas and chinese food and it was all very yummy and best of all, we got to add all of it to our beli
- I am grateful that we got to eat 2 ICE CREAMS TODAY HEHEHEHE MUAHAHHAH

8/20/24
- Today we got to go to a Mexican restaurant with umma and it was a very very aesthetically pleasing restaurant so I am grateful for that
- I am grateful that we got to hit the gym today and have a pretty good shoulder day! And then also we got to basically spend today with the fam so that is always something to be grateful for. We went to costcooo
- I am grateful that today was so much rest and that we can relax before hell starts in like 2 weeks

8/19/24
- I am grateful that Alice made chocolate for us and then delivered it to our house hehe that was super kind of her and for Michael too cause he came to our house and we greeted him in our underwear idk why that was important to include
- I am grateful that we got to go to the gym TWO TIMES TODAY that is the first time we ever did that but we hit a chest day and a back day
- I am grateful that we got to have so so much rest today and then we took a nap too after waking up at like 11 so much sleep 🙂

8/18/24
- I am grateful that we got to hang out with Michael and Alice and Anita today and see how they are all doing before they go back to school and such. I am grateful that they are all doing well and happy and that it was a lot of fun
- I am grateful that we got to try Michael’s top Thai place and BRO IT WAS SOOO GOOD so so yummy and I am so so grateful that we got to go there today I enjoyed that very much
- I am grateful that we got to go to church today and that also it was at the AFAM service and we heard Pastor Andrew’s sermon which was a helpful reminder to go out into the world and spread God’s message to nonbelievers

8/17/24
- I am grateful that we drove safely home from the retreat today and that also we had a good very last day of the JHAFAM retreat. I am going to miss my small group since they were honestly very well behaved.
- I am grateful that they got us MASA sushi YAYAYAY it was so yum and so much and amazing and I loved it so much
- I am grateful that the JhaFam staff got us $100 as a gift…? That was quite interesting since it kind of defeats the purpose of the volunteering aspect LOL

8/16/24
- There was a full day of the Jhafam retreat today and it was pretty tiring but I’m happy still that I get to serve here and see all of the kiddos. I am grateful for them and their hearts to learn more about Christ and grow their faith. But I am also realizing that I am in need of my own faith to increase as well
- I am grateful that we got to go to the beach today for the first time this summer! That makes me happy since I was honestly starting to think that I would go through an entire summer where I wouldn’t go to a beach once. But I guess I was proven wrong heheh. And then also I got to go to a pool today so I am grateful and happy for that as well
- I am grateful that we got to buy taco bell for the kiddos to show them that we really do care for them a lot hehhee. And then they were really happy too so I am super duper happy about that.

8/15/24
- Today is the first day of the Jhafam retreat so I am grateful that we got to drive here safe and sound without any major hiccups. And then I am also grateful that appa packed us some blueberries and a protein shake to take before we headed over to the retreat center
- I am grateful for the kids that I am going to be a small group leader for. They are all so cute and so squishable and I love them. And then I am also pretty grateful for Jaden and the fact that he knows how to handle kids pretty well it’s been pretty helpful.
- I am also happy that we got to see all of the people who are also small grouping for this retreat like Jae, Erin, Amy, Sophia, Darren, etc. It’s nice to see that they all were willing to be a small group leader too and it’ll probably be my last time seeing them for quite a while so I am happy that I got to see them again.

8/14/24
- Today was the last day of camp and so I am grateful that we ended a great camp Kesem and no major emergencies or anything happened. And then we got to have a safe drive back from the retreat center, from Princeton to Evelyn’s house, and from Evelyn’s house back to our home. So much driving much it was all safe
- I am grateful that we got to see umma and appa today and so that was nice and I am happy that we got to talk with them. And then I am also grateful that I got to learn a lot more about Evelyn throughout our time driving her. So cute she is adorable.
- I am happy that we got to text Cevina a little bit today and hear that she is moved into Queens and is still alive. So I am so grateful for her and that she is doing ok. And then omg I am also grateful that WE HAD PROTEINNN that was soooo needed I can’t even tell you how much I needed that protein

8/13/24
- I am grateful for the full day of camp that we had today! It was a pretty fun day full of camp kids and joy and such. WE WON FIRST PLACE IN PANIC (the skit thingy in case you forgot because we incorporated Jesus into our skit) and then ALSO FIRST PLACE IS SCAVENGER HUNT. Our crew is just that good and so amazing. But I am also really grateful for not just my crew, but every single living person at this camp.
- I am grateful that the kids seem to be really be opening up and being more comfortable just talking, having fun, and enjoying themselves. All of them have such unique personalities: I’m writing their names here so you don’t forget. Cat, Johomes, Buddy, Axilatle, and Conuk. Every last one of them is a joy to be around and I am so inspired by how much strength, joy, and life they have inside of them despite the issues that they might face at home. I am so grateful that they are here, and so grateful when I see them smiling.
- I am grateful that we got to have SO MUCH FUN TONIGHT WITH THE KIDS! Bro, gaga, the dance party, LOUD??? CMON NOW THAT WAS WAYYYY TOO MUCH FUN. I honestly think that I enjoyed that more than some of the kids LOL. And then also star gazing at night was insane too. There honestly is something magical about this camp. I know that sounds cringe and cliche but it’s 100% true as well. They are magical kids

8/12/24
- I am grateful for a full day of camp today and I think that most of the campers are starting to warm up to me so that is something that I am happy about. And I am also grateful that the food that they give us here is really yummy (albeit small portions and not enough protein imo…)
- I am grateful that we literally spent the entire day outdoors it’s been so long since that LOL and then also the camp songs that we did, it might have felt a little bit awkward at first but after getting into it I honestly had a really good time doing those songs so that is another thing that I am grateful for
- I am happy that we took a shower today LOL showers are important. And then the fact that we got to play with the kids always is another thing to smile about. So so much to smile about

8/11/24
- Today was a pretty hectic day and we did a lot of driving/work hehe but we met a lot of good people and enjoyed our day for the most part. I am grateful that we got to get to Princeton safely and also the fact that we drove everyone safely to camp
- I am grateful that we got to meet all of the campers today and see how happy everyone is and excited they are for camp. I really love their hearts and the joy that they have despite all of the hardship that they might go through back at home so I am grateful so so much that each one of them are here 🙂
- I am grateful that EVELYN! She is so cute omfg. And then also I am grateful that we got to have a night full of sleep at 10pm MUAHAHHAA

8/10/24
- I am grateful that we got to eat at Gallagher’s today with the entire family ehhe and then shopping and there was the super cute watermelon that unfortunately we lost immediately wth is wrong with you Jonathan
- I am grateful that we got to finish packing and everything before heading over to camp tmrw
- I am grateful that Joey had a good 14th birthday

8/9/24
- I am happy that today we got to watch Joey’s final presentation today that was fun. And then we got to see Julia/Millie/Jasmin/Joyce/Andrew/Josh/Jae so many many people so I am grateful for that
- I am grateful that we got to go have a shopping day with umma at Costco/Hmart/Deer park so that was all fun hehe
- I am grateful that we got to hit a leg day at the gym today WOOOO

8/8/24
- I am so grateful for the amount of sleep that I got today LOL that is so amazing and I love sleeping so so much hehehe. And then we don’t have to worry about going to class anymore it’s so great. And then also we got an A in physics so congrats
- I am grateful that we got to have our NINJA MACHINE COME TODAY MWAHAHAHA ice cream is going to taste so so good
- I am grateful that we got to add 2 new restaurants to our beli hehehhe

8/7/24
- PHYSICS FINAL DONE. THANK YOU JESUS. I am grateful for all of my physics friends who made the class a little bit more bearable. And then I am grateful that I got straight 100s on the midterm and final
- I am grateful for ANITA ANITA! I am super duper happy I was able to grab a meal with her and catch up to see how she is doing. She is so so chill and I LOVE ANGEL (her dog) SM! SHE’S ADORABLEEE I LOVE IT I LOVE ANGEL ANGEL ANGEL
- I am grateful that we got to spend the day with Aidan, Evan and Joey today. Honestly Evan is such a funny person LOL I never knew. But yeah it looks like we have the same exact humor HAHHAA

8/6/24
- I am grateful for being done with the last day of classes and then tomorrow is just we take our final and be done with physics forever and ever and I never ever want to go back to that class every again and see Dr. Padilla’s ugly face ever again.
- I am grateful that we got to go to the gym today and try out our new back/bi workout split. Honestly it works pretty well and I think we should stick with that from now on because it really targets the back. And then I am also grateful that we got to do that with Micheal hehe
- I am grateful that we BOUGHT AN ICE CREAM MACHINE HEHEHHE MWAHAHAHHA sorry appa don’t get mad but it’s too late

8/5/24
- DONE WITH SECOND TO LAST DAY OF CLASSES SO I AM SO GRATEFUL FOR THAT
- I am grateful that we got to see all of Ronnie immo’s family (except Kayley) today that was nice! And we got to hit the gym and eat chic-fila with Aidan so that was nice as well. I am glad to see that he is doing well
- I am grateful that we DID NOT take a nap today so we are really trying our best to stay awake LOL and then I am grateful that lab today was relatively short heheh

8/4/24
- I am grateful that we got to serve at both church services and then pastor sam also gave a pretty good message about praying when we are desperate. It is important to make ourselves busy to put ourselves in those desperate situations to reach out to God. If we find contentment where we are, then we will honestly never improve and it is important to make ourselves busy so that we can constantly push ourselves and draw on God’s strength rather than our own
- I am happy that we were able to NOT take a nap today since we have class tomorrow that was honestly a LOT of effort to not fall asleep heheh
- I am happy that we were able to catch up with Viv today I LOVE HER SM OMG. She is such a bright ray of sunshine and so enjoyable to be around I am so grateful that we have friends like her at home!

8/3/24
- I had a pretty relaxing and uneventful day today hmm what did I even do. We got some philly cheesesteaks from joshy today so that is something to be grateful for since it was very very yummy
- I am grateful that our uniqlo order came in and that we were able to pick up our clothes and go clothes shopping for a bit heheh YAY
- I am happy that we were able to hit a pretty good leg day at the gym and get that over with. And then also the fact that we are going to get our workout routine back on track

8/2/24
- I am grateful for how much rest there was today. We woke up at noon AND took a four hour nap LOL So much sleep
- I am grateful that we got to each chipotle with guac today 🙂 HAPPY
- I am grateful that we got to do all of our habits and organize I lot of things today heheh

8/1/24
- I am grateful that we finished our class today and that it was a super quick class with just a little bit of questions
- I am grateful that we got to hit a shoulder day and that we worked pretty hard today even though we were not running on a lot of sleep
- I am grateful that we got to go to the Dr. Uzma talk at the library today it was honestly a lot of information and I appreciate her spending her time to teach the younger generation.

7/31/24
- I am grateful that we woke up at noon AND THEN ALSO we got to take a 4 hour nap LOL. Many many things to be grateful for since we don’t have class 🙂
- I am grateful that we got to hit a productive back/bi day with progressive overload again hehehe. And then I am grateful that we got to accomplish all of our habits today too 🙂
- I am grateful that we ate burger king today and then also that we got to rearrange our phone lock screen

7/30/24
- I am grateful that we got to go to physics class today and finish everything well 🙂 And then I am grateful that we did NOT fall asleep and take a nap today YAYAYAY
- I am grateful that THERE’S NO FRIGGEN CLASSES TMRW hopefully the teacher is okay but I am happy regardless lol
- I am grateful that we got to hit a productive chest day today with progressive overload. It’s good good good

7/29/24
- I had a pretty good day today which was decently productive so I am grateful for that. We got to finish class today so that is always something to celebrate Jonathan
- I am grateful that we got to finish up a leg day today and then also that we got to take a nap AND wake up without going back to sleep. Little victories heheh
- I am grateful for food we had so much protein today < 3

7/28/24
- I am grateful that we got to have a full day at church and that we were able to serve on tech team today, and then also that we were able to hit a good shoulder day at the gym and get back in church just in time for lunch.
- I am grateful that we got to see so many of chingoos today and spend some time with them that was fun. And then also grateful for Pastor Sam’s message today to the college students: it was quite interesting. It is our duty as Christians to help each other carry burdens, but not each other’s loads. If it is someone’s job to do something, then they HAVE to do it. Being a good Christian is not always about helping each other with things they need to get done.
- I am grateful that we got to have KBBQ today with friends that is something which makes us happy 🙂

7/27/24
- I am grateful that we got to finish editting our youtube video today that is something to celebrate for accomplishing
- I am grateful that we got to get dinner and dessert with umma and Joey! And then there was much yummy food hehehe POPEYESS
- I am grateful that today was a day full of rest and comfort and that we are home

7/26/24
- Today was a productive AND fun day so I am grateful for that hehe. We woke up and got a full 8 hours of sleep, and then worked on Korean and habits and youtube video 🙂
- I am grateful that we got to go to the church revival today and that was a whole lot of fun and then Josh came over and we caught up a bit
- I am grateful that I got to hit a back and bi day at the gym

7/25/24
- Today WILL be a good day and I am grateful that it is the last day of classes < 3
- I am grateful that we got to take a nap nap nap. And then I’m also grateful that we got to do many of our daily habits today.
- I am grateful that we eat yummy food always at home cause appa and umma love us.

7/24/24
- I am grateful that we got to finish class AND lab today and that we woke up on time and that we are still alive after that. But I hated it still
- I am grateful that we got to hit a few new PRs on chest day today so that makes me happy. AND THEN SMASH BURGER ❤
- I am grateful that I got to do most of our daily habits today so that’s something to celebrate

7/23/24
- The highlight of my day was that the teacher canceled lab today because she had a doctor’s appointment and that allowed us to NAP HEHHEHE I am so grateful for napping
- Something that I am grateful for is that we got to walk on the treadmill for 2 hours and do work so that is so helpful in getting out steps in for the day.
- Also I am grateful that we got a leg day done and over with and now we can have more fun gym days hehe

7/22/24
- Thank GOD we finished Monday class… I HATE CLASS SM OMG. But I am grateful when it is over I guess…
- I am grateful that we got to be mostly productive today and also that our nap was only an hour and didn’t become 4 hours of our life wasted
- We got to hit new PR’s for shoulder day today so that is something to celebrate!

7/21/24
- We had a pretty relaxing Sunday today and had fun at church so that is something that I am always grateful for. And then we got to see a lot of our friends and then eat church lunch ehhe
- We got to help out Dr. Uzma at Paris Baguette today and then also hit lots of new PRs at the gym today with a back and bi day so I am grateful for that
- We finished all of the Kesem training thingies today so I am happy that we were able to get that done today too hehe

7/20/24
- Today was a fun day and we made many memories so I am grateful for that. We got to hang out with the family today and then also grab miko with Joshy’s girlfriend which is something that I’m grateful for cause I always like sushi
- I am grateful that we got to hang out with a lot of church people today at the BBQ that was honestly a lot of fun and very very tasty. THEY BROUGHT FAMOUS STAVES
- I am grateful that we moved up to the 60s on incline now WE ARE GOING TO GET A HUGE CHEST S:DLKGJ

7/19/24
- We were a lazy ass today which is something honestly that I really wanted and really needed 🙂 We woke up at like noon and then did laundry, most of our habits, read a chapter of our book before our dship meeting, and then we picked up Joey, ate, napped, and pretty much lazed around for the rest of the day
- SO MUCH YUMMY FOOD TODAY so I am grateful for that. Umma and appa made us samgyupsal 🙂 HAPPINESS
- We got to learn a lot at our dship meeting so that is honestly pretty nice! And then we also got to catch up on this website which we fell behind on

7/18/24
- Yesterday we finished our STUPID PHYSICS MIDTERM SO GRATEFUL FOR THAT
- I am also grateful for the fact that we were able to eat lunch with umma and then also take a nap afterwards for 4 hours long ;lkadjg;laksdjg
- I am grateful that the entire family is home hehe. And then also viv wants to hang out so I am grateful for her!

7/17/24
- I am grateful that we got to see Jae, Michael and Amanda today it was fun to hang out with them
- I am grateful that we got to finish that stupid physics class I absolutely hate this class with a burning passion omg.
- I am grateful that Sabrina is now on our finsta hehe

7/16/24
- I am grateful that we got to finish stupid class today and also for the fact that we got to meet our cousins…? What is appa’s cousins daughter called? Idk. Anyways, that is something that I am happy about since it was a new experience and also I am realizing that I am out of my league in terms of Korean-ness
- I am grateful that I got to hit a shoulder day at the gym today 🙂 That is fun. And then I am also grateful that we got to have a family dinner today
- I am grateful for naps hehehe

7/15/24
- I am grateful that we got to take the most fire nap after class today and that our eye mask can help us have the most pristine naps ever
- I am grateful that we got to have a family dinner today as hot pot! Even though I didn’t particularly think it was tasty.
- I am grateful that we got to go to the gym today hehe 🙂 Back and bi day and still progressive overloading so I am happy about that.

7/14/24
- I am grateful that we got to serve as the slides person for church today and that we were able to find the time to hit a killer chest day
- I am grateful for the food that was at church today because we ate so much yumminess 🙂 And then I am also grateful that we got to see Josh/Jae today and talk with them a bit since honestly it’s been a while and Josh got better at poker…
- I am grateful that we got to eat halal food today hehe and then a sandwich on top of italian food I think we eat a little bit too much Jonathan

7/13/24
- The things that we accomplished today are so funny. We learned how to complete a rubix cube all by ourselves and by memory so that’s fun: and we can do it in 3 minutes 19 seconds which is our new record hehe.
- We got to have dinner with Pastor Sam and the entire tech/media team so that is something that I am grateful for. And then we ate even more thai food which was pretty yummy so I am grateful for that too
- I am grateful that we got to also have the most fire home food EVER LIKE STEAK + AVOCADO + EGG IS THE MOST INSANE BULK MEAL EVER

7/12/24
- Today was an enjoyable day. We got to practice driving in the city today which was quite a good experience I am grateful for that since it had to happen eventually hehe
- I am grateful that we got to see Will today and then hang out w michael and try out a bunch of different food places today
- I am grateful that we got to still do all of our habits today ev en though we were out for most of the day

7/11/24
- I am grateful that we are done with physics today hehe and that we can rest for the rest of the weekend.
- Appa made us the most KILLER salmon dinner today and that made us the happiest person on the entire planet earth cause it was YUM and also sm protein
- I am grateful that we got to grab lunch with Sabrina and Kate and everyone so that was nice hehe. And then we got a leg day over with at the gym so that was good too.

7/10/24
- I am grateful for sleep because we had a very very good night of rest today so that was great. And then we woke up not completely tired and dead
- We got to have a good day at class today for the most part (I don’t think she likes me)
- I am grateful for the food that we ate today and then a bunch of family time. And then also I am grateful for Cevina cause she is not going to make sure we don’t use instagram.

7/9/24
- I am so grateful that there was no lab today because idk if we could have survived a lab today was absolutely brutal it was just a fight to get energy a;sldkjg;alskdg
- I am grateful that Panera is giving us free coffee so we snagged 2 coffees from there today, and then we chugged a celsius, and then after that we drank another coffee from Paris baguette, so I guess what I’m trying to say is that I am grateful for caffeine
- I am grateful that we got to have our meeting with Dr. Uzma today that was nice 🙂 And then I am grateful that we got to write a blog post today too hehe

7/8/24
- I am grateful that today we got to go back to class and see a bunch of familiar faces 🙂 That made us happy and I am very grateful for that. And then also class today was pretty doable and our teacher is honestly a much better teacher than last sem so yay for that
- I am grateful that appa took us to go get a haircut today and also that we got to eat popeyes and then that we got to see Halmony all of this is something to be grateful for
- I am grateful that I got to hit new PRs at the gym for chest day today 🙂 And then also Panera is giving us free coffee for the literal rest of the summer?????

7/7/24
- Happy Sunday Jonathan! Today we got to go to church and then there was so much yummy food for lunch there it is definitely something we should be grateful about.
- I got to have dinner with the entire family today so I am happy about that
- We got to go biking around the neighborhood for the first time in a while so that was nostalgic

7/6/24
- Got to have dinner with halmony and appa today at a pho place so that is something that I am very very grateful for
- We got to get lots of rest today so I am happy about that 🙂 And then also we got a leg day over with
- I am grateful that we got to watch a movie with appa today too hehe

7/5/24
- Today was a very very relaxing day. We are grateful cause umma looked at our teeth and also we get to see the cousins hehe
- I am grateful that I got to eat lots of yummy food today and that umma/appa took us shopping for protein snacks that is very thoughtful of them
- I am grateful that we got to watch movies with umma at night 🙂

7/4/24
- Happy July 4th! I am grateful that we get to live in America. Honestly I don’t think I really thought about that before but seriously it is something that I should be more grateful for.
- We got to go to the city today with umma and appa and they planned a pretty fun city day so we got to try lots of new food places and then also ice cream and coffee so that made us happy
- We got to eat mandoo tonight with the family and also we got to talk with Brooke for a little bit for the first time so that was interesting.

7/3/24
- We got to grab dinner with the family at mad for chicken and then that disgusting chinese restaurant but it was nice since we got to eat with everyone
- We got to start Cev’s birthday card like 2 months early so that was actually pretty fun hehe I’m excited to give it to her
- Got to relax and rest a lot so grateful for that

7/2/24
- Twas a very relaxing day today so I am grateful for that. And also we got to buy lots of clothes today for the gym so that is something else I am grateful for too
- Umma bought us a chipotle bowl with DOUBLE STEAK and GUAC for lunch so that was absolutely amazing and something that I am super duper grateful for
- We got to eat ramen for the first time in like a year today so I am super duper grateful for that 🙂

7/1/24
- Today was a cute day. We woke up and then went to go volunteer at camp so I am grateful that we got to do that and help out with all of the kiddos at camp and see people that made us happy
- I am grateful that I got to go get dinner with Halabogi and Halmony today with umma appa and Joey that was fun and I don’t know how many of those in the future we will have. But I think we should start becoming more and more in the present when we are spending time with them Jonathan. Idk how much more time we got
- I am grateful that we got to get a leg day done and over with at the gym and also that we are not super duper tired afterwards that makes us happy.

6/30/24
- Happy last day of June Jonathan. That is crazy that the month is already over I am grateful for this first month of summer it was very very helpful in getting my life back on track. But I really gotta start grinding academically now instead of just our health 🙂
- I am grateful that we gotta go to church today and have fun with the friends and eat lots of yummy foods
- I am grateful that we gotta hit a good gym day today. We finally understand what progressive overload is hehhee

6/29/24
- I had a pretty good day today. Got to hang out with Michael and Alice today so I am grateful for that
- I am grateful that we got to try crumbl cookies today that was very very yummy. And then also we got to have pizza! And then we hung out with the rest of Alice’s family so that made us happy
- I got to hang out with the fam today and spend some time with umma and appa so that was nice 🙂

6/28/24
- I am grateful that we got to serve at VBS today and see all of the little kiddos that was fun. And then I am also grateful that we got to see lots of the little kids serving at VBS 🙂
- I am grateful that we got to take a FIRE nap today at home I love napping. But at the same time why do our naps take so long…?
- i am grateful that I got to watch the second inside out movie today with umma that was cute cute cute

6/27/24
- I am grateful that we are now officially finished with Physics 1 hehe and that all of the tests were pretty easy. I think we should start to focus on DAT now so I shall begin grinding for that. No more volunteering for thingies and saying that we have time for other people.
- I am grateful that we got to hit the gym with Michael today and get Chipotle with him afterwards that was fun
- I am grateful that we got to see Eva today and have a fun day in the city with her that made me happy and then also the fact that we got to eat ice cream there ehhehe

6/26/24
- I am grateful that we got to celebrate umma’s birthday today that was quite cute. Everybody got to have dinner together so that made us happy and also the food was very very yum
- We finished our physics class today (the class and lab portion) so I am grateful that today was the ending day for that
- I am grateful that we got to have a leg day at the gym today and that also we took a FIRE nap cause I love naps.

6/25/24
- I am grateful that we got to go to Adventure land today with the physics team that was fun and we are not having a completely boring summer with no friends or plans or people to hang out with so that is something to be grateful for
- I am grateful that he didn’t really check the lab today.
- I am grateful that we got to take a fire nap today and then watch the wizard of oz movie that was lots of fun hehe

6/24/24
- I had a pretty productive day today and we did all of the things that we wanted to do which made us proud of ourself. Accomplished all of our habits today so that is something in and of itself a successful goal.
- We got to hit a chest day at the gym today and honestly it was such a fire chest day. And then also since this is the last week of our first class (which is pretty crazy), we also got to finish the entire lab DURING class today so no lab report 🙂
- Got to have a very relaxing time at like 3am cause we were just studying after attempting to go to sleep early. But still nonetheless grateful that we got to be productive and not waste the entire time trying to fall asleep.

6/23/24
- I am grateful that we got to have a good day at church today and that there was mad for chicken at lunch it was very very yummy (but perhaps it is also the reason my skin broke out a little bit..)
- I am grateful that Tim showed us the ropes for media team cause now we can learn more about that and hopefully help out a bit more during services from now on
- I am grateful that we got to have a super duper nice nap today 🙂 That was not in the cards but it happened anywaysss.

6/22/24
- We got to practice driving with appa today and then he complimented our safe driving skills so that was nice
- We got to see Halabogi so I am grateful that he is doing well and that he gave us some peppers
- I am grateful that we got to do lots of work at a cafe today and that we Od’d on coffee so that was yum

6/21/24
- I am grateful that today was full of rest and caring about ourself so that makes me happy. We got to hit the gym today and honestly it was a pretty fire shoulder, ab and calf day.
- Got to go to Pastor Sam’s Bible study today and we learned a lot about Mark 14. Hmm a few things I remember: the charge that was actually brought upon Jesus was that he claimed to be the son of God, not any of the other accusations that the high priests tried to charge him with. It shows that God is in control even when it doesn’t seem like it. Another thing he said: Peter went to go see Jesus because he thought Jesus would probably do what he always does and outsmart the Pharisees, but he sees a defeated Jesus instead which is why he rejects him.
- I am grateful that we had enough time to finish the entirety of Itaewon class today lol. Bro summer is the best time ever.

6/20/24
- I am grateful that we finished our Physics exam today and we got last week’s exam back too which we got a 99 on so I am grateful that physics is easy
- I am grateful that we got to take a super duper long nap today 🙂
- I am grateful that we got to accomplish all of our habits today so yay for that.

6/19/24
- I am grateful that we got to study for our physics exam today. We got a lot of good studying done and so I feel proud
- I am grateful that we were able to figure out another good habit to add into our life! It’s helpful to just be aware of these types of habits we can implement anywhere and everywhere. It is true that we know already know what to do, we just gotta do it
- I am grateful that we got to have lots and lots of yummy food today that was quite good.

6/18/24
- I was very stressed out today. Honestly it wasn’t too great of a day. I was tired, mad, and I couldn’t really shake the feeling and it still pisses me off a bit to even think about it in this journal. But I guess if I’m going to be completely honest, I’m grateful that this means I actually have emotions lol.
- I am grateful that I got to have yummy food today.
- Grateful that I bought $100 worth of clothes on yesstyle..

6/17/24
- We had a mostly productive day today and new experiences so that is good. Every day I should probably journal at least one new experience hmm. Or do you think gratitude journal is enough cause there’s new experiences every day. Anyways, I am grateful that we got to go to church and watch the NBA finals game and then learn a new card game
- I am grateful that we got to see Paul at the library today and study a little bit with him and then also that we were able to hit a pretty good gym day today. Creatine really really works lol
- I am grateful that we ate lots and lots of food today and tried cheese crust for the first time which was honestly fire. Pretty unhealthy of course, but def worth it to try. Yum I love.

6/16/24
- I am grateful that today was a very happy day cause of Father’s Day (For the most part except for the family fights LOL). Anyways, everyone was able to come over safely and we enjoyed a very very nice meal with the family which I am grateful for
- I am happy that we got to see Ellie at church today! It was super nice seeing that she’s doing well and unfortunately we prob won’t see her again in a while since she’s off to cali…
- I am grateful for the college space place where we can hang out with people and enjoy time with chingoos.

6/15/24
- I am grateful that today we got to have dinner with mimi immo and her entire family which is something that we haven’t done in a while
- I am happy that we got to eat a FULL ON STEAK YUM YUM YUM that was 100% worth and super duper yummy so I am grateful for that
- I am thankful we got to hit the gym today and get lots and lots of sleep as well. All of these are important for health hehe.

6/14/24
- I am grateful that today was just a COMPLETE rest day and we literally accomplished nothing of substance which is something to be happy about.
- I am grateful that we got to go to Bible study and learn lots and lots from Pastor Sam
- Grateful that we got qdoba today 🙂 And then burger king too. Lots of junk food so we should probably lay off junk food from here on out.

6/13/24
- We were decently productive today but not actually as productive as we would have wanted it to. But we did get to have a lot of rest and relaxation and learning Korean today (aka watching Korean dramas) so that is nice
- We got the physics test done and over with today so I am grateful for that and our ability to not utterly massacre those exams
- I am grateful that we had a lot of yummy food today and make food for ourself that we really enjoy and is healthy hehe

6/12/24
- Today was an enjoyable and somewhat productive day even though we honestly didn’t really study physics that much. Anyways, it’s okay, I am grateful for God. God has it all in his hands and because of that, I really should not worry all that much.
- I am grateful that our standing table and our treadmill came today that is nice. We got to finish setting it up and then Halabogi helped us with that so we are grateful for him.
- I am grateful that I was able to have a family dinner today (with everyone except for Joshy). But yeah, we ate dinner with umma, appa, Halabogi, and Halmony, and that is something that has not happened in quite a while (Oh yeah Joey was there too much he was kind of moody. But honestly I understand why he’s moody, I guess academics are just not for everybody).

6/11/24
- I am grateful for today which was mostly productive. It always falls off when we get home but I still am grateful for home because home is great and awesome and amazing
- I am grateful that we got to hit the gym today with Michael and then for all of the yummy food that we were able to eat throughout the day like the Salmon and chicken with rice and a burrito it was all quite yummy. And then we also randomly saw Jennifer today at Broadway mall which is something to be grateful for as well cause she looks like she’s doing good!
- I am grateful for this new habit tracking app 🙂 Hopefully we continue to use this to accomplish all of the goals that we want to heheh.

6/10/24
- I am grateful that today was a productive and mostly activity filled day so that made us happy. I am grateful that basically everything went pretty smoothly today
- I am happy that I got to chill for a while since I did all of the work that I wanted to accomplish today and also that I got to eat a pretty yummy lunch
- I am grateful for the waiter who protected us from eating peanuts that was extremely nice of her.

6/9/24
- I am grateful for church today and we got to have a bunch of free food b/c of the BBQ so that was yummy. And then we also got to see BABIES! Baby baby baby was cute.
- We got to see/talk to a lot of church ppl like Jasmin, Julia, Joyce, Andrew, Erin, and more so that was a happy time being able to catch up with them for a little bit.
- I am grateful that cevina talked to us for a bit that made me happy.

6/8/24
- Got to see lots and lots of chingoos today so I am grateful for all of the friends that we got to see. We saw Michael, Alice and Steven today and then met a few of his friends so we are grateful for that.
- I am grateful that I got to get 3 TACOS from the super yummy taco truck that was quite enjoyable and very much something to be grateful for.
- I am happy that Steven had an apartment in woodside which we were able to crash at for a little bit. And then also that we were able to hit the gym this morning too

6/7/24
- I had a good day today so I am proud of ourself for that. We got to hit the gym and get a leg day done and over with so that is something that I am grateful for 🙂
- I am grateful that we got to go to the BASIC revival and see all our little kiddos at the auditorium in the high school. And then I’m also glad that we got to see like Sam Park there so that was fun as well
- I am grateful that we got to get some focused work in. Albeit not as much as we would have liked, but there was still lots of work that we did which I am grateful for.

6/6/24
- Today we knocked out our physics test which was honestly pretty easy so I am grateful for that
- I am grateful for the lunch that we got to eat with umma, Halabogi and Halmony today because the food was quite fire
- I am grateful for all of the exploring we did today on the app store LOL. Hopefully we can use these apps to make ourselves into the best version of ourself possible.

6/5/24
- I very much enjoyed our day today. Especially our conversation with Peter it was pretty interesting. I am grateful for that. He went on a little rant about fish and his research and it was all very very fascinating stuff
- I am grateful that we got to go to classes today and got to hit the gym and have a pretty good chest day. Grateful grateful grateful.
- I am happy that my entire family is here in my house right now so I get to see them. Kayley, Kelsey, Halmony, Halabogi, Appa, Joey, everyone. And this makes me happy that the house is not completely empty. I should be grateful for having a family here that I can spend time with. Not annoyed. Grateful. I am grateful.

6/4/24
- Lovely, productive, summer day where we actually have ENERGY! I enjoy having energy so I hope that I continue to have energy as I continue throughout the rest of my work days here at home.
- I am grateful that we got a lot of studying done (about 5 hours) even after classes ended so that was productive. And then we also hit the gym and got to have some halal guys which was yum yum yum 🙂
- I am grateful that we got to see Ronnie Immo and Evan! They came to our house (i’m assuming for teeth work…?) But it’s strange since I haven’t been to their house in such a long time. Grateful for them cause we have a little family reunion now hehe

6/3/24
- Today was a good/productive day. We woke up and then went to classes and then lab, got chic fila and worked in the library with Jae for like 4 hours, and then we ate at home, did laundry, hit the gym and then ate some more and watched k drama until we went to sleep.
- I am grateful that I have friends who I can study and gym with heheh. I am not completely alone this summer, but I will be soon enough so that is exciting
- I am happy that I got to get chic fila today and that also the time at the gym was pretty good.

6/2/24
- Enjoyable day today. We went to church and got to see all of the church people and then had a FIRE lunch with sushi for the college thingy so that was very very yum and I am super grateful for that
- I got to go to head pastor’s house today and play with little kiddos and then also talk to a lot of church people so that was enjoyable as well 🙂 We are being able to SOCIALIZEEE LOOK AT THAT! GO US
- I am grateful for all of the yummy food that we were able to eat today because that made me happy.

6/1/24
- I am grateful for family and all of the people that I got to see today who I haven’t seen in a very very long time. It was really nice to catch up with everyone on appa’s side of the family
- Halmony and Halabogi came today (umma’s) and so we got to see them after a FIRE nap
- I am grateful that we got to eat so much good food today and then also that we were able to drive to the chajangmyun place all safely because we are an EXPERT driver now

5/31/24
- I am grateful that today we got to see Sam Chung! And then we caught up with him for a bit which was pretty nice and fun and I really liked seeing him and so that made us happy
- Church had a bunch of food for praise night which was a happy surprise I am grateful for that.
- I am grateful that we got to get lots and lots of rest today and also that we had our d ship meeting with Soonho. I’m always wanting to improve and Soonho and Sam today really gave me that push to try to be better in every way that I can.

5/30/24
- Grateful for someone in class asking me to be in their physics lab group! Hehe I think that means we can actually make friends…? hopefully? probably? idk we shall see
- I am happy that we got to see the Haikyuu movie today that was honestly a pretty good movie and the final point HAD ME ON THE EDGE OF MY SEAT quite the unforgettable experience
- Julia and Cevina are crazy. But that’s exactly why I love them and are grateful for them. But they are insane.

5/29/24
- We had a very good day today albeit pretty unproductive. We gotta lock in though tmrw. But I am grateful that classes were pretty quick today so we didn’t have to spend 4 hours listening to him lecture
- I am grateful that we got to hit the gym again today and have a pretty good back and bi day 🙂 That was fun
- I am grateful for having appa make us food all the time and also the 4 hour nap that we took. However, we realized that we can no longer come home before dinner time since then we will just take a nap.

5/28/24
- Grateful that we had no problems with the first day of physics classes @ farmingdale today. We went on time, found our room, no parking ticket, got our ID, and followed everything in class so far so that is a win in my books
- Got to do so many of the things that we’ve been wanting to do for so long like get new bag, buy protein, gym, etc. We are getting back on this grind this summer I can feel it and I am very excited
- Appa made us the most delicious dinner today so we are super duper grateful that he gave us that cute plate which we put as our favorite photo of the day.

5/27/24
- I’m pretty happy about today I think that we did everything that we wanted to do so we feel pretty accomplished. We are grateful to be back home after the retreat and for the ride home being safe
- I am grateful that we got to go on a little hike today at the Hudson Valley bridge thingy because that was a new experience and I love new experiences
- Grateful for the dinner that we had at the soup place thingy with umma, appa, joey and patrick. It was a pretty good korean resturant and I was happy to eat that food

5/26/24
- I think I’m pretty happy about the retreat today. We got to see a lot of people and eat some yum food so that is always something to be grateful for. I’m happy that I have a church community here that I can feel a part of
- I am grateful to have watched all of the skits that happened today Arumdaun old people are so funny and I think we are learning a lot of Korean b/c we are here LOL
- I’m happy that we got to take the most FIRE 3 hour nap in umma and appa’s room today so that was really really nice 🙂

5/25/24
- I am grateful for another recovery day and we actually got to have solid foods today and even though it hurt and it took a very very long time to eat the food and it got stuck in our teeth and everything hurt, it’s a sign of recovery still which I am grateful for
- I am happy that the family and I got to the retreat center safely and everything went well in terms of travel and that we got to eat some yum foods today all of which were from outside resturants
- I am grateful for this retreat that we are at! We got to see Anita and Joyce for a little bit too and catch up with them as well which is another thing that I am happy about.

5/24/24
- I am happy that today was a more productive day than previous days. So that is something to be grateful for. 🙂 We went to the library and spent about 2 hours there so that was fun
- We got to have lots and lots of yummy soft foods today so another thing to be grateful for is umma and appa buying us soft foods
- I am grateful that we got to get lots and lots of sleep today 🙂

5/23/24
- More recovery today so that is something that I am grateful for. And then we got honestly a lot better since we didn’t have to use the ice packs so I am happy about that
- We experienced a new sensation today which is… interesting to say the least…? I think we overdosed on the pain killers and then everything felt like a trans so I think perhaps that is what it is like to be high LOL But I guess new experiences are always something to be grateful for
- Got to clean our room today and talk to friends so grateful for friends < 3

5/22/24
- I am grateful that appa brought home some soup that we could eat so we don’t have to worry about our mouth 🙂
- BOGUM! I am grateful for doggos
- Grateful because of a very chill day where we really didn’t do much other than literally finish the entirety of haikyu

5/21/24
- I am grateful that today was a good recovery day I think we are feeling a lot better and can see our face start to swell less and less
- I am happy that umma won the election that she cared a lot about and so I am grateful for the people of Syo voting for her lol
- I am grateful for being at home and having a very chill day.

5/20/24
- Today I got my wisdom teeth out and everything went smoothly so I am grateful for a safe and successful surgery 🙂
- I am grateful that umma and appa care about me a lot so they were willing to make me food and get me thingies to make my after surgery experience comfortable.
- I am grateful for today being such a chill and relaxed day since all we did was sleep, nap, and movies.

5/19/24
- I am happy that we went to church today. Pastor Sam’s sermons are always something to be grateful for and was very convicting about him wanting to see genuine spiritual growth rather than just people who show up every sunday
- I am happy that babies came over today cause they were very cute and I love seeing the little ones walk
- I am grateful that we got to see lots of church friends today 🙂

5/18/24
- Got a haircut today so I am grateful that appa and umma drove us there
- Grateful to have gotten lunch with umma and appa at chachangmyun so that was yum
- I am happy that cevina got home safe and her bones didn’t break on the flight so that is something that I am grateful for as well

5/17/24
- Grateful to have spent the day at HOME HOME HOME
- Lots of unpacking was achieved today so happy for that
- Grateful that umma brought us to bible study with Pastor Sam and also brought us to eat at Mad for Chicken

5/16/24
- Today was a good day cause we FINISHED THE STUPID FRIGGEN ORGO TEST AND NOW WE ARE FREEE. I am happy 🙂
- We got to say bye to lots of our friends today so that was bittersweet. And cev gave us a hug which was cute and is something I am grateful for. I enjoy hugs.
- Umma and appa came to pick us up and take us home (so they drove like all day) so I am grateful for them.

5/15/24
- Today I am grateful that it is my last full day at Princeton for my sophomore year. And then after today I get to go home and then enjoy home and being home and home and home and home
- I got to have lunch with all of the baos today and then see Por before he leaves for Switzerland so that’s literally the last time I am going to see him for an entire year which is kinda crazy but at the same time I’m excited for him
- Got to get lots of studying for orgo done today so that is something that I am grateful for. And then also did lots of errands which lessen our workload for tmrw move out 🙂

5/14/24
- Welp. There are always things to be grateful for. Today we got to get some orgo tutoring and got to get a lot of our questions answered so grateful for that.
- We got to deliver Julia her present and then talk with her for a little bit in her dorm so that was cute as well. And then Cevina offered us Melona which is nice of her too.
- Today was an ice cream day. So in other words, we had ice cream. And that made me happy. I am grateful for ice cream.

5/13/24
- Wow days really don’t feel like days anymore cause there’s literally nothing to do besides orgo and I DONT FRIGGEN WANNA DO ORGO. But anyways… grateful for today cause God made today.
- Got to go on a maruchi run with Steph, Grace, David and Kristen today so that is something that I am grateful for.
- I am grateful that we got lots of studying done for orgo. Grateful grateful grateful.

5/12/24
- I am grateful that cevina and julia came with us to church. Either it shows that they enjoy having new experiences or they actually care about the things that are important to me which is both good things to be grateful for.
- I got to call umma today for Mother’s day so that was cute. And then also we wished Julia a happy mother’s day too
- Grateful that I got to study a lot today and get some more knowledge into my brain hole. So that’s good. But also grateful that there’s 3 more days to cram thingies into my brainhole.

5/11/24
- Enjoyable day. We woke up and then went to small world and then drank some coffee, studied a bit and then went to chic-fila and ate with cevina, and then we got popeyes and took a FIRE nap, studied for orgo, and then got more popeyes
- SO MUCH CHICKEN. YUM CHICKEN. I like chicken.
- Good day today. Lots and lots of sleep

5/10/24
- Today was fun. We woke up and then went to Marvin’s room and then devo, breakfast, and then went to swimming, and then Cevina got us the octopus ball thingies so ate that at Stone before doing dship meeting, and then worked at la biblioteca for rest of day. So fun/relaxing/enjoyable day
- We got to swim today which is something to be grateful for. We literally go to a school where we can just swim… in swimming pools… that’s so random, and so fun
- Grateful for cevina and the octopus balls which were very filling I am so full.

5/9/24
- I am grateful that we were able to sleep a lot and wake up at 2:30. But that’s also us being SO FRIGGEN LAZY. But still grateful for it and not having to worry about classes to go to and such
- We got to get a lot of POL studying done so that is something else that we should be grateful for and having the time to do. AND STUPID POL FINAL IS DONE WITH NOW SO WE CAN FOCUS FIRE ORGO
- Grateful to be at this school and live right now in the moment before sophomore year ends. 🙂 THANKS GOD.

5/8/24
- Happy post dean’s date Jonathan. Twas a super fun day. We woke up and then baked cookies with the ppda officers, and then we went to julia’s b day and had a lot of fun before heading over to the study break to watch some how to train your dragon, and then we walked around w cevina for a bit before heading to MASA, then spent some with with the Davids before taking a nap, and then we woke up and just did random thingies for the rest of the day
- SO MANY THINGS TO BE GRATEFUL FOR TODAY. We got to have lots and lots of fun at the julia b-day thingy today so I enjoyed that a lot and we got to meet a lot of her friends so that was cute too. And julia is such an amazing person too im grateful to be friends w her
- I am also grateful for cevina she is fun to talk to and we spent a lot of time w her today. AND THEN ALSO GRATEFUL THAT MASA WAS FREE. We ate SOOOOO good it is kinda crazy I think we were about to pop.

5/7/24
- Today was a really great day. Dean’s date done so we finished POL paper and SML project and then we also got free hat which I liked a lot. And then ACAI BOWL!
- Manna Coffee House was so cute cute. We got to hear Bryan’s AMAZING singing and James Jun’s guitar skills. And then also we shoved 9 marshmellows in our mouth
- Lots of rest was had today < 3 But now we really gotta lock in.

5/6/24
- You were lazy AF today but it’s okay I am grateful for these rest days. So we woke up and then we worked on our POL paper for a bit, took a break by sorting through Katie’s photos, went to late meal, took a nap and then did our laundry, and then we went back to being lazy and worked on some SML, got another late meal and then worked on the POL paper until we finished the night. But dang we were LAZY it’s kinda insane.
- We finished our POL paper today so that is something to be grateful for < 3
- Lots and lots of rest today which is exactly what we needed 🙂

5/5/24
- Today was an okay Sunday. We woke up and then we did some of our POL paper, and then we got to enjoy nomads pizza and ice cream and butler merch before heading over to Cevina’s dorm and attempting to do work there, and then we picked up our Manna merch and got some food from Alastair cooking for us which was honestly pretty yummy, and then we went to Stone to do some more POL papering, and then we went back to our dorm and watched a movie and could not bring ourselves to do anymore POL paper stuff unfortunately
- We got to get like 4 ice creams 🙂 Quite cute indeed. And that is going to make our freezer actually do some good. And then the butler merch was cute as well
- Today was honestly just us attempting to do our POL paper and then bothering our friends so those are the types of days that I genuinely do enjoy a lot. Grateful for friends that I can annoy

5/4/24
- I enjoyed today a lot albeit not as productive as we would have wanted it to be. So we woke up and then we went to the Korean heritage event with Julia, and then we went to Manna BBQ, spent a bit of time in Julia’s dorm before heading off to the gym (and coffee), did our Dship meeting and then got some dinner before taking a KILLER nap, and then for the rest of the day we just fooled around and now we are going to start our POL paper so that we are not completely and utterly behind on everything
- We got to hear some REALLY great singers at the Korean heritage cultural event thingy so that was honestly amazing. And then we also got to have a lot of fun at the Manna BBQ and get some vv yummy food
- Julia’s dorm is SO COMFY TO BE IN I like how soft everything is we can just fall asleep there so so easily.

5/3/24
- There was SO Much fun that we had today but also completely unproductive. But it was so worth it we took so many photos and made so many memories that I think we kinda had to. I am grateful for all of the events that we were able to go to today like Shrave/Senior banquet/Yeh field day
- We took SO MANY PICTURES with a lot of different people and a lot of different events so that was a lot of fun. And then we also got to watch Shrek 2 at Shrave with everybody so THAT WAS HONESTLY SUPER DUPER CUTE. And then they made lil baked goodies and then watermelon with sprite and honestly so many different memories that we absolutely love
- We got to get lots and lots of free stuff from the Yeh field day event thingy today. So I am grateful that they do not check proxes so that we are able to just leech off of them and get free stuff like nomads and blue berries and watermelons and photoshoot cards and FROZEN BANANANNAANNA

5/2/24
- A day full of rest and taking our time with things. Loved it. Didn’t feel like everything was in a rush or whatnot, was much slower and more leisurely. We woke up and then we went to our meeting with Daniel and had a pretty good conversation with him, and then we went to our POL review sesh, got some pizza at Frist and had late meal with Cevina and then we attempted to do work in the library, failed, went to our PPDA dinner meeting after cleaning for a bit, and then we took a nap, woke up, finished our HUM paper, and now we are trying to think of how to intro Bryan
- Lots of pretty good rest was had today so that is great. But we should really start locking in now
- We had a really good convo w Daniel today at the Dship meeting so that was pretty thoughtful.

5/1/24
- I think we had a good day today and accomplished… most of what we wanted to do I guess. We woke up and the we worked on our POL paper outline before heading over to late meal, and then we did our POL paper meeting and then we attempted some SML for a while, got dinner at colo and just did a bunch of unneccessary/helpful work and then eventually we just finished the rest of the day doing literally nothing
- We got to catch up on some suits so that was fun and brain numbing. I enjoy being able to do brain numbing tasks like that haha
- Enjoyed some pretty nice weather todayyy 🙂 I am grateful for nice nature

4/30/24
- Was a pretty good day today. We woke up and then worked a bit on SML and our POL final paper outline, and then got breakfast and went to the library, then hit the gym, ate lunch, learned some squash, took a nap, did interviews for PPDA, went to colo for picnic, talked with Cevina/Jenny/Rebecca, and then we went to the library and just attempted to do work for the rest of the day
- We had a lot of fun at the colo picnic today so I am happy about that. Lots of cute memories and pictures
- We got to learn squash today from Alaister which was a one of a kind experience. Look at us getting new experiences every day here.

4/29/24
- Twas a pretty relaxing day. We woke up at like 2 THERE WAS SO SO MUCH SLEEP 🙂 And also our elbow is feeling a lot better which is something that we can be grateful for.
- We got to have a pretty FIRE dinner today at the dining hall so honestly I might be a bit sad when we change our plan to colo and have to go there for every single meal that we eat. But anyways Melissa is killing it as always.
- The Frosh bombarded us with food the second we stepped into Stone so that was honestly super cute. I’m grateful for the frosh and their hearts.

4/28/24
- Today was a lawn parties day which was pretty fun. We got to take many many pictures with everybody and since it’s spring now the vibes were so nice. AND ALSO CREPES AT COLO IS SOMETHING TO BE GRATEFUL FOR
- We got to take a FIRE nap at Michelle’s dorm cause their floor is so comfy…
- Had a 4 hour long conversation with Jocelyn last night which was nice! I think that was our first time going deep into something and I like talking with Jocelyn a lot she’s easy to talk to

4/27/24
- We went to a Kesem training for the first time today and so that means we were somehow able to wake up at 10 (GO US) and so I am proud of us for that and also grateful that we are able to work there this summer 🙂
- TODAY WE GOT TO HAVE COLO FORMALS That was honestly such a great experience and I am so grateful to be at Princeton cause we can have such unique experiences like that.
- We got to eat SUCH GOOD FOOD TODAY. There was lobster, steak, and then also the dessert was so fire. Like literally they lit a banana on fire…? BUT WAS GOOD

4/26/24
- Today was a cute day and full of NO WORK TOO so that was nice. We woke up and then we attempted to eat a bit before going to chem checkout, and then we went to Frist late meal, made some cookies, and then we ate dinner and did a bunch of nothing until semis so that was super cute
- The cookie making thing was cute : ) I am grateful for cookies, for cevina, and for julia. They are fun people that I can be myself around so that is honestly something that I’ve been really unable to do
- Done with stupid classes. END OF CLASSES. Now is going to be grinding but also joy. SO FUN FUN FUN

4/25/24
- All of the important things that required our attention to be done with were done with so I am grateful for that. We did our SML midterm and then also knocked our orgo lab report out of the way so GO US
- We got to have a lot of closure today with the end of POL lectures and then DAY YI BROUGHT HIS ADORABLE LITTLE DOG AND I LOVE HIM SO MUCH AND HE’S SO CUTE
- WEATHER WAS AMAZING so I am grateful for weather that makes us not want to kill ourselves

4/24/24
- Let’s see what did we do today that we are grateful for.. WE FINISHED OUR FINAL ORGO LECTURE SO GO US. And then also we went to POL lecture, POL precept, and then HUM precept and then another POL precept so there was lots of classes that we went to for the final time this week which is something that we are grateful for. And then also we went to the PPDA officer meeting so lots and lots of work has been done which makes me proud
- We got to finish up some final studying for the SML midterm and honestly we are feeling quite prepared for it so WOOO
- Watched Prince of Egypt LOL FIRE SOUND TRACK

4/23/24
- We got lots and lots of rest today (3 hour nap + waking up late) meant that we enjoyed lots of sleep so I am grateful for sleep
- We got to try out the burger place on Nassau which had some AMAZING burgers so that is something to be grateful for. And then also we got to eat that and also lunch with Cevina so we are grateful for her as well. She gave us the red bean bread!
- Accomplished next to nothing today hehe. But it was worth it cause we finished our stupid orgo test. We also got our photo thingy with katie today so happy about that too

4/22/24
- ORGO EXAM IS COMPLETE. Grateful that I can breath a bit now. And it honestly wasn’t too bad so go us
- We had a pretty fire lecture from Dr. Brooks today about Douglass and slavery and honestly I am really really liking this statesmanship class I’m going to be sad when it is over
- Last pre-orgo exam dinner with Lindsay! That was cute and thankful for her for grabbing dinner w me every single time before orgo

4/21/24
- Today was enjoyable day, we woke up and then we went to the city and then ate some food and then went to the CUNY library to lock in, and honestly we did lock in so that was quite nice. We got into a flow state for the first time for a few hours so that was productive, and then we also got some snacks from H-mart and then we came back and just worked on chem for the rest of the night.
- We got to have lots of good food today and so that was very very yummy and I enjoyed that a lot. And we also got to meet a lot of new people today so GRATEFUL FOR THAT!
- H-Mart snacks were very very yum < 3 so so worth the money I spent.

4/20/24
- We are kinda dying but also at the same time I am grateful to be busy. So we woke up at 10 to just do some more studying before our tutoring sesh with jess, and then we went home and took a nap, woke up and ate dinner while doing laundry, hit the gym and then went to the six14 show, got hoagie haven, and then just finished the night doing random thingies that aren’t very productive but help us renew our mindsss.
- We got to learn a lot of orgo today from Jess so that was quite nice and she is such a sweet person who is also so smart I am in awe that we go to a school here with people like that
- The six14 show was cute. I am happy that I was able to go to it and be able to see all of my friends on stage absolutely KILLING it.

4/19/24
- I really really enjoyed today. We tried our best to do as much as possible so I am grateful that we get to do lots and lots here. Woke up and then we went to the elementary school for the PPDA event thingy, and then we came back and had lunch before our chem lab, and then we went to declaration day and took a BUNCH of photos which was super cute, and then we did a bit of work in the library before grabbing dinner, watching some movies and coming back to the dorm and knocking out, then we woke up, did some more work… and that’s basically it.
- We got to have a lot of fun at the elementary school today with all of the PPDA members so that was super cute. And then we took cute pictures and everything honestly worked out pretty okay so I am really grateful for that. And then we also hopefully got to make a lot of kids days today with those goody bags 🙂
- We took SO MANY CUTE PHOTOS at declaration day today I am really really grateful for that and for the friends that I’ve made here. We really need to learn how to move on from the past though and I think that we are somewhat succeeding at that…? I don’t really know to be completely honest…

4/18/24
- Personally here dude we are STRUGGLING to catch up on our work… We woke up and the we went to POL precept and then SML lecture, got lunch with Cevina before going to POL lecture (after late meal), and then we picked up our dry cleaning after signing a few b-day cards and then we went to Chem precept, and then we took a BOMB nap, woke up and ate dinner, and then we got late meal and attempted to do work in the library but failed so we ended up just going to the gym and then watching videos for the rest of the night
- We got to have a pretty fun conversation with Cevina at lunch today so that is something I am grateful for. And then also I am just grateful for Cevina in general cause her existence makes me happier
- We got to hit SHOULDERS AT THE GYM for the first time today. We probably should have studied… but Daniel convinced us to go to the gym and forget orgo so that is exactly what we did.

4/17/24
- I am grateful for being able to have such a chill day today. We got all of the classes that we wanted in all of the sections that we wanted so I am honestly really grateful for that. We are TAKING KOR 301 NEXT SEMMM YAYYY. Which means that we are actually going to be able to relearn this lost language and try to catch up on everythingg. We are learning this for ourself Jonathan. Nothing else. But ourself.
- We got to go ice skating tonighttt and then also Butler gave us free tacoria so that is something to be majorly grateful for ❤ And also the fact that we were not super lazy and went to both of our precepts today is something that I am proud of us for (wow the bar is pretty lowww). And then also we got to get lots of rest today so that was great
- We saw Colton at both lunch and dinner today so that was quite the nice coincidence! I’m grateful for those mini coincidences like that 🙂

4/16/24
- Today was a pretty good day today. We woke up and then we were 30 minutes late to SML lecture, but we actually didn’t even do anything. We just shopped for shoes and did a bunch of calendaring and organizing and stuff but nothing really of substance. And then we had lunch with Michael, Jonathan and xuanying so that was fun and we had an interesting conversation about evolution vs. creationism, and then we went to POL lecture, and then met some pre-frosh at the ice cream social before going back to our dorm to go to sleep and then we woke up for the PPDA coffee chat, got dinner with the officers and then we just did some lame work for the rest of the day
- We got to enjoy really really nice weather today and have 2 ICE CREAMSSS. It was super duper yummy and then we also had trail mix which was yum too!
- I am grateful for Tim. And also for friends here. They are fun to talk to.

4/15/24
- We did a lot of things that we love today because of the amazing weather. So we woke up and then we went to chem lecture, and then POL lecture, and then we clipped our guitar strings before late meal, then bought six14 tickets, and then we went to Stone and did a little bit of work before heading off to enjoy the outdoors and read, and then we got free chic-fil-a, and then we spent a little bit more time outside just enjoying the weather while editing our video, and then we helped tutor someone in orgo before resting in our room for a bit, and then going to late meal, more editing and then we got stuff from the Ustore and just finished off the day
- We got to have SO MUCH FUN OUTSIDE TODAY. We went to the grad school and worked on our video a bit there, and then we got to lie down outside and just touch grass, and then we got to see the lil fluffy doggo again, there was so much to love today 🙂
- We got to go to 2 lectures today so GO US! And then the lecture on frederick Douglass was honestly really really fire so I am happy that we got to learn about that today. There’s so so much to be grateful for at this school. And then obviously chic-fila is SO AMAZING

4/14/24
- Let see what did we do today… So we woke up and then we went to church with Xuanying, and then brunch, and then we went to Firestone to do a little bit of work before hitting the gym, and then we did a little bit more work before umma and appa came and then we ate at SC house with the and then ate at colo with them and just overall spent a lot of time with them so that was a lot of fun. And then we took a nap, got wawa, and now we are here just wasting time
- We got to see umma and appa today and they dropped off the predental association teeth thingy for the little kids fso that is super duper cute and I am happy that we get to be able to see our umma and appa. And then they also bought us some food ad I LOVE EATING UNTIL I AM FULL.
- We got to check our Nassau Presbyterian church today and it was honestly a pretty good church ngl. I didn’t see any major red flags but I do think that we are going to go to Ecclesia from now on anyway. But I am grateful for new experiences and that we have friends who are willing to go on those new experiences with me

4/13/24
- What did we do today… we woke up and then we went to lunch after dropping off our clothes to dry clean, and then we studied a bit with James Jun before hitting the gym, then we did our last Manna praise sesh before going to TASA night market for a bit, and then when we got back to our dorm we literally just went on our phone for the entire rest of the night and wasted so much time
- We got to really enjoy our last Manna praise night and then also the food that was at TASA night market was honestly very very good so I am grateful for that indeed
- We hit the most fire gym sesh today so that is another thing to be grateful for. And that’s only cause we realized we can just hit 16 sets of bench press to hit literally everything for chest day lol

4/12/24
- We had a pretty good day today. So we woke up and then we went to lunch after finishing our SML precept, and then we went to orgo lab and DID NOT HAVE TO REDO IT SO THAT’S GREAT, and then we went to the EAS culture party thingy which was honestly really really fun, and then we took a nap before dinner with Brian Seo at colo, and then another nap before going to the ice skating event with Jessica and then we U store, laundry, and watched the train to busan sequel < 3
- We got to have dinner with Brian Seo and catch up with him about how he is doing and how he is feeling about this upcoming year without all of the seniorsss. And then we took 2 FIRE NAPS TODAY WHICH WERE SUPER CUTE
- We got to watch the ice skating show with jessica and her friend and we got to see how talented these people are Princeton are like it’s kinda super crazy how we are at school with people who are that much cooler than us.

4/11/24
- Lovelyyy day today albeit not as productive as we would have hoped for. So we woke up and then we went to POL precept, and then SML lecture before colo for lunch, and then we did a bit of SML before going to orgo office hours, and then we worked a bit on our chem lab report with Kelly before going to orgo precept, then we took the most FIRE NAP EVER before having dinner with Daniel, and then we late meal, hit the gym, read our chapter before just goofing off the rest of the night
- We got to have a very very interesting conversation with Daniel about lots of different topics about questions we have regarding the faith like being able to ask questions in church or the women in leadership positions in church. We literally agree with him on so so many things so I am grateful that there’s a christian staff member we can look up to who is also super duper caring and considerate.
- We got to study for like an hour with Kelly today and talk with her a lot so that was super nice; she’s a fun person to talk to and I enjoyed that little catch up time with her 🙂

4/10/24
- Todayyy, we woke up and then we went to our Odus Credit card meeting, and then we went to orgo lecture, lunch before attempting to figure out rooming, got that all sorted out and have a quad in little and then we got late meal before doing a bit of work before HUM precept at the library, and then we went to HUM precept, picked up some thingies for the PPDA study break, and then we got fresca bowls, korean language table, went to POL precept, got late meal + our tote bag from TASA (Jessica’s club thingy), and then we got more food from tiger noodles and ate that until we were full, and then we walked to little with Marvin to check out the dorm, played some foosball, and then we are back in our dorm and ready to call it a night
- We had a lot of fun at the PPDA study break and made all of the goodie bags to give to the little children so that is super duper cute. And then we also got to have dinner with the korean professors so THEY ARE ADORABLE AS WELL
- We GOT A ROOM! We don’t have to worry about the stupid waitlist and it was all thanks to meeting people at sympoh bootcamp and them reaching out so honestly I am really really grateful that they did that so that we can actually have a group to room with LOL. Perfect perfect perfect.

4/9/24
- NOOO WORKKK DAYYYY YAY. So we woke up and then we went to SML lecture for a little bit to work on our orgo lab report LOL, and then we went to have this super duper cute picnic with Julia and Cevina which was really fun, and then we we got to see some pre-frosh during the ice cream social before going to prayer meeting, and then we got dinner with Anthea before going to our PPDA officer meeting, and then we took a NAP, and then we hit the gym after late meal, talked with Marvin for a bit and then just went back to our dorm to go to sleep
- We had the absolute BEST WEATHER TODAY EVER I AM SO SO GRATEFUL FOR THE WEATHER OMG IT WAS LITERALLY PERFECT AND IT MADE ME SO SO HAPPY I LOVE AND AM SO GRATEFUL FOR THE WEATHER 🙂
- We got to have a pretty good talk with Anthea and she is a very very fun person 🙂 And then we also got to spend a lot of time with Cevina/Julia today and our picnic was great I am grateful for that

4/8/24
- Today was a decently productive day. So we woke up and then we got our new prox and then we went to orgo lecture, then pol lecture, and then we went to late meal, did our orgo lab report, saw the eclipse, finished orgo lab report at lab TA office hours, and then we did guitar, took a fire nap after eating dinner, hit the gym, late meal again, and then we went to Stone to do a little bit more work and then went to finish the night with just goofing around.
- We got to grab dinner with Marvin and talk about how we would never ever get a good room and then we got lunch with Tim and then enjoyed the eclipse with Andrew and Tim! So that was quite fun as well
- We FINALLLY POSTED OUT MOMBASA YAY! That is done and we can friggen forget about that song now. And then we also heard the most fire POL lecture today so that was honestly really great

4/7/24
- Super unproductive day today… I feel like we should kind of get our productivity back. We woke up and then we went to church with Grace and Xuanying at Ecclessia, got brunch with them and worked at Stone for a bit until we went to our dorm to take a nap, then we got dinner with Joie, worked out for a little bit before heading back to our dorm and just going to sleep
- We had a very very interesting conversation at lunch with Grace and Xuanying which was nice. And then we also figured out how Joie’s parents met which is also a super fun conversation to have like I love hearing people’s stories.
- We got to do a few deadlifts today to get out some stress so I am grateful for the gym. And then we tried out Ecclessia and heard a pretty fire message that I really really appreciated a lot

4/6/24
- Today was a super duper unproductive day but I think a much needed rest day. So we woke up and then we went to brunch at colo, and then we did a bit of work at Stone (which we failed at), when we went to JS foodies with Xuanying and then went back to our dorm to take the most FIRE NAP EVER, and then we went to Manna LG, got hoagie haven, and then just fooled around until the end of the day
- We got the most FIRE BRUNCH EVER TODAY and it was SO SO EXPENSIVE but also the most worth it thing ever. Lots of pictures of food were taken today
- The frosh KILLED it at takeover today and they were so so cute and the video was absolutely amazing. They roasted every last one of the seniors ever and I LOVED IT SM.

4/5/24
- So today we woke up and then we went to colo for breakfast (after the very interesting earthquake), and then we picked up our toothbrushes from Frist before going to late meal, then we dropped off our thingies at our dorm before going to chem lab, and then we came back to our dorm and just took a nap before our dship meeting at 5-6, and then we got dinner with marvin and tim which was fun, and then we went to the PSAT show about willie wonka which was quite the experience, and then we finished the night with just thingies that we enjoy doing like rest.
- We got to have a pretty interesting conversation about Soonho regarding the evolution vs. the Bible… I’m realizing that they honestly are pretty incompatible theories and so I completely understand why Christians don’t believe in evolution. But at the same time… how can we be that ignorant of the evidence..? In any case, that is something that we just have to think about some more
- We got to have a pretty fun conversation at dinner with Tim and Marvin today so that was quite fun! It was very much brain dead, but also a conversation that was very much needed since I feel like I’ve been restraining myself so much at Princeton lol

4/4/24
- What did we do today… Hmm so we woke up and then we went to our POL precept, and then we went to SML lecture, got lunch with Julia, Yashica and Cevina before heading to our POL lecture, and then we got late meal before our chem precept, went to the projects board meeting, then hit the gym before going to dinner with Cevina, and then we went to bible study with pastor steven and then just finished the night with doing absolutely nothing of productivity.
- We got to see Jessica after we came out of dillon which was really nice cause we got to walk with her for a bit. And then for some reason I think we overshared at our dinner with Cevina today..? Idk why like I told her things that I haven’t even told the baos yet but in any case, I think I was in a very very good mood today so it is okay.
- We had a very very fun lunch conversation today about vetoing each others lives..? And then we also got to run into Jam today and quickly catch up with him as well so I am grateful for people ❤

4/3/24
- Today was an enjoyable day where we didn’t have to worry about orgo < 3 Woke up and then was super late to HUM lecture but it’s okay the only reason we went was the submit the paper, and then we went to orgo lecture, then POL lecture, and then had lunch with Daniel for our dship thingy where we had a pretty interesting conversation about biblical issues, and then we did some reading before going to HUM precept, and then we went to the gym, got dinner at colo, and then we went to our PPDA officer meeting, and then we went to POL precept, had dinner with Jessica at late meal, and then just finished the night doing absolutely nothing of productivity
- We got to learn a lot with our meeting with Daniel today so that was great; and then dinner got to briefly talk to Ozi and Jocelyn so that was fun too. And then we tried these healthy lollipops at the PPDA meeting..?
- DINNER WITH JESSICA WAS NICE I enjoyed catching up with her a lot 🥳

4/2/24
- So today we woke up and then studied for orgo… and then dinner and then we TOOK OUR FRIGGEN IMPOSSIBLE ORGO EXAM and then we got late meal, called umma, gym, wawa, and finished the night with just doing things that I love like guitar playing and instagram reels 🙂
- We got to have dinner with Lindsay today which was super duper nice. The only reason I don’t absolutely hate orgo with all of my heart and soul is that we get to have dinner with her before the test so thank you Lindsay for making my life a little bit more bearable.
- We got to play a lot of guitar today so grateful for that. And then we also blew off some steam at the gym with a back and bi day so that was enjoyable

4/1/24
- Today was literally just a study day idek what it was. We woke up, and then we went to POL lecture, and then we studied orgo… and then we got dinner, and then we went back to studying orgo… what a fun day LOL
- We got to have dinner with Celine today which was quite nice of her to introduce herself! I’m grateful that she came up to say hi.
- We got lotssss of orgo studying done today so that is something else to be grateful for. But also I HATE IT

3/31/24
- I enjoyed today a lot and it was honestly pretty productive so I am proud of us for that. We woke up and then we went to church for easter sunday, and then we had lunch at Roma, and then we studied at Firestone until we got dinner, and then we studied a bit more before our tutoring session, and then we went to colo for pizza, and then we went back to our dorm, took a nap, and then called umma and did some more studying before going back to sleep for the night
- We got to grab lunch with Michael, Xuanying, Boya and Andrew today so that was honestly a really great lunch so I am happy and grateful for that. And also today was Andrew’s birthday so I will say that I am honestly grateful for his presence in my life and to have met him before he graduates. He is really a good person and I am thankful that I got to know him throughout these past two years.
- BRO IM SO GRATEFUL FOR THESE ORGO UCA TUTORS CAUSE I NEEDED SO MUCH SAVINGGG. I am completely screwed for these exams and the only reason that I’m only partially screwed and not completely screwed is because of them so I am grateful for them…

3/30/24
- Today was just a lot. We woke up and then we went to Shanghai bun with everybody and then we got to try out subway cookie and then mango mango and then we went to Praise team practice for Manna, got dinner, and then we did our Manna LG, cleaned up after praise and then watched KS for a bit before going to coffee club and then finishing off the night with just some studying for orgo.
- We got to have a lot of fun at the lunch today and there was SO MUCH GOOD FOOD TO BE HAD TODAY that I am super duper grateful for that and enjoyed every single moment of it 🙂
- We got to have a lot of fun at large group today with everybody so that was pretty good and then also, apparently today is Holy Saturday which is all about how God left the disciples alone with their thoughts, with nothing to distract them with. Interesting how we didn’t do any work today.

3/29/24
- We had a pretty good day today so I am grateful for that. We woke up and then we went to our funding meeting, and then we went to Office hours for HUM after eating, then we worked a bit before chem lab, and then we went to late meal where we got to talk a little bit with the korean teachers, and then we went to the library to do some studying for orgo, and then we went to the gym and then we went to dinner with Jocelyn, then we went to good friday service and then fellowship afterwards where we talked with Geoff and his wife, and then we went to do a little bit more work at Green cafe before heading back to our dorm to just rest for the rest of the day
- We got to have some really fun conversations with the Korean teachers, Jocelyn, and we learned a LOT about different church denominations from Geoff so that was really nice
- We got to have good friday service with all of the different christian fellowships on campus so honestly that was really great just being able to see and talk to everybody there worship together ❤

3/28/24
- Today was an enjoyable day today Jonathan and sort of productive so I am grateful for that. So we woke up and then we posted on our finsta, did a bit of cleaning and organizing and a bunch of very unnecessary work to procrastinate on studying for chem, and then we decided on studying chem for about an hour before napping and then literally missing our entire POL precept, and then we went to SML lecture and did some more orgo studying before grabbing lunch with Julia/Cevina and we had a very very fun conversation with them, and then we went to our POL lecture and then got late meal and then went to orgo precept, and then we went to do some light work in the library until we got dinner with Stephanie, and then we went back to the library to do a little bit more work, and then gym, late meal, happy hour wings, guitar, and then back to orgo studying before going to sleep!
- We had a very very good conversation with both Julia/Cevina and Stephanie today and both of those conversations were really great and I am grateful that I have friends here who I can both joke around with and then also be serious with. Julia is such an amazing person what the heck I’m so so grateful that I have someone like her in my life and that I met her.
- We got to honestly get a lot of orgo studying done today and so I consider that pretty productive go us! That was some really good work Jonathan!

3/27/24
- What the hell was today Jonathan you accomplished literally NOTHING. So we woke up at like 4, and then we practiced guitar, and then we went to the pizza/abortion talk thingy which was honestly pretty interesting, worked on SML and then submitted that before POL precept, then late meal, u store, gym, and then we came back to our dorm and literally went to sleep. Wow we are so so lazy. But anyways, good day I guess
- The abortion talk thingy was very very interesting and we had an honestly really great time there (and I enjoyed the pizza there as well). They were very very understanding and willing to answer my questions and so that was honestly so worth our time and super happy to have done that.
- We got to have some really funny conversations over text today about Dan Park LOL so I enjoyed every last second of that.

3/26/24
- LOVELY BIRTHDAY HAPPY 20th. I am grateful for life and being here for literally 20 years wowowow I’m so so proud of myself. So today we woke up, played guitar, and then went to SML lecture, and then we got lunch at colo, and then we went to POL lecture, and then we did a bit of work, picked up our pants and then headed back to the dorm to play some guitar, and then we went to Stone to do some work, had a lovely birthday surprise and then we headed to PPDA, and then we got dinner and dessert with Cevina which was cute, and then we got random memories for the rest of our birthdayyy
- We got to have lunch with the group today and they were honestly really really good with the surprise so I AM SUPER GRATEFUL FOR THEM AND FOR THAT! AND THE CAKE WAS SO YUM TOO SO YAY
- Conversation with Cevina today was cute. I’m grateful for her!

3/25/24
- Today was a TIRING day… we woke up at like 3 and then we practiced guitar, did our laundry, cleaned our room, did our POL question, ate breakfast, and then studied for orgo before going to orgo lecture, and the POL lecture, and then we were STRUGGLING so we enjoyed the outdoors for a bit before heading to Stone to do orgo grind part II, and then we failed at that so we went back to clean/practice guitar before dinner, and then followed Joie and Kevin around, attempted to do some more orgo studying Part III but then failed again and then we decided to just call it a day
- We got to spend at LEAST an hour enjoying the sunlight outside so that was honestly really nice being able to feel that breeze and get some of that vitamin D 🙂 It’s crazy to think that I am literally living of the dream of my high school self literally RIGHT NOW
- We got to stay awake (mostly) for the entire day today which means, and I really hope it means this, that we will be able to go to sleep tonight without too much trouble and will actually be able to STAY asleep for the entire 8 hours so we can be well rested for year 20?? YAY

3/24/24
- We had a very very good day today albeit extremely unproductive. So we woke up and then we went to grab everything for the PPDA event thingy, and then umma talked, and then we went to dinner with umma and appa and everybody, and then we walked around campus for a bit before dessert, and then we went to the library to do a little bit of work before ending for the day
- We got to have a LOT of fun with the family today and it was really really nice spending time with everybodyyy. We got to have food at the sushi place and then we also got dessert at junbi!
- Umma talked lots and lots at the PPDA meeting today and that was honestly really nice. We are so proud of our umma and she gave some very very good advice.

3/23/24
- I think that today was a good day; very restful. So we woke up and then went to lunch, and then napped before praise team practice, and then we go dinner, Manna LG, and then we just did a bunch of works that we procrastinated on. So it was a good day today
- We got to have lunch with Kellen and dinner with all of the Manna praise team group so that was pretty nice! I am grateful for that and having people we can eat with
- Cevina is supporting out guitar endeavors so I AM GRATEFUL FOR HER. WOOOO I am excited to learn more guitar

3/22/24
- So today we woke up and then went to our academic advisor meeting, dropped chem and sent out a few emails before PPDA thingy was successful, ate lunch and then watched the prelab video and practiced guitar until we went to lab, and then our Dship meeting and then we took a FIRE nap, woke up and then did a little bit more on guitar, and then colo to help clean up, and then we watched a movieee.
- We were VERY unproductive today, but that is alright since WE VERY MUCH NEED THESE UNPRODUCTIVE DAYS. So we had a very very interesting conversation with Soonho about what church we should end up going to so that was a very productive and fruitful conversation so I am grateful for that.
- We got to learn a LOT of guitar songs today and rekindle our love for playing guitar. I’m grateful that I get to do stuff I enjoy now and not be so friggen stressed out all the time.

3/21/24
- I think today marked the end of our little anxiety driven week. It was pretty bad, ngl. However, that moment has passed and we are now going to get back on our normal routine and not stress out about literally everything in life now. So we woke up at 4 again, finished our POL 396 dean’s date thingies and the SML problem set (what the hell is ur problem), and then we practiced guitar, went to breakfast at colo and then did our orgo pre-lab for next week before POL precept, SML lecture where we literally just bought clothes, and then we had lunch with Julia/cevina, POL lecture, and then we got our love for guitar again before orgo precept, and then we took a NAP until PPDA dinner, and then movie, and then we made Pablo, late meal, gym, and back to dorm and just chilled.
- We got to have so many fun conversations today that I am really really grateful for all of the friends that I am making here. We got to have an interesting conversation about murder with Cevina and Julia at lunch, and then we had SO much fun with Payge and Elle at the campus rec stuffed animal workshop thingy that was super duper cute. ❤
- We are recovering our love for playing the guitar again. I am so grateful for that. I MISS IT.!

3/20/24
- We are really all over the place in terms of… literally everything but I am grateful that we are still alive, that we are still functioning, and that we are still working hard. So we woke up and then went straight to working on the SML precept 6, and then we finished and submitted our GHP application, and then we practiced guitar for about an hour, and then we headed to colo for breakfast, decided on a few thingies to buy for our pre-dental meeting Sunday before going to talk with Dr. Kelly about our major (he gave us some good advice: Hamlet’s quote –> “there is nothing either good or bad, but thinking makes it so” which really means we can’t make a “wrong” decision here!), and then we went to HUM lecture, and then we went to SML precept instead of orgo lecture to check our assignment, and then we went to the library to do a bit of orgo self-studying before going to POL lecture, and then we had our dship meeting with Daniel and heard a lot about his life story which was really great, and then we went to HUM precept, gym, and then worked for a little until we got our tacoria dinner from the religion in government talk thingy, and then we went to POL precept, and then sushi study break before going to late meal and then talking with Boya and Keith, and then we went to Stone to finish up the visual analysis before going to bed.
- Lots of thingies were accomplished today so I am grateful for that and for all the things that I am able to do here. And I am also grateful that despite our SEVERE lack of sleep, we are still functioning extremely well and are getting on top of all of our stuff. But this is very very interesting I don’t know how far I can push my body, but I am very interested in finding out the answer to that question soooo cool!
- We got to have SUCH FIRE FOOD TODAY that I am super duper grateful for that. So we got to eat the most fire tacoria and the guac tasted SO FRIGGEN GOOD and then the breakfast at colo is literally fire as per usual and then sushiiii.

3/19/24
- It’s kinda crazy how we think that we did so much today but then when we actually think about how much we did… I can’t really think of that much. So we woke up at 3, tried studying for orgo for a bit, then cleaned out our computer, did some belli ratings, organized our reading notes, and then headed to breakfast at colo, and then we did some work in the library (study for orgo) before buying the Prince, and then going to SML lecture, and then we walked around with Julia for a bit which was honestly really really nice, and then we went to POL lecture, then CHM office hours, and then we worked on our lab report and the GHP minor application until we went to PPDA, had our meeting, talked a bit w Cevina, and then went to grab dinner at colo, came back to Stone to finish up the GHP minor, and then late meal, call umma, tutor Joey, gym a little, and then went back to dorm to sleep.
- We are grateful for the conversation that we had with Julia today! That was honestly a really really amazing conversation and she is such an easy person to connect with I am grateful to have her in my life. And then also we got to have breakfast with Inwoo which was also a nice treat.
- We got to get a lot done today even though we were running on not too much sleep (literally 3 hours Jonathan) but you were productive so I am proud of you for that. Good job.

3/18/24
- We are an EEB major now. Seriously Jonathan, how many friggen times are you going to be changing your major??? But yup it’s pretty much decided so I am grateful for that and having the realization before it is too late…
- We woke up, went to HUM lecture, then chem lecture, then POL lecture, and then the other chem lecture, and then worked on our lab report and sent out emails until it was dinner time, and then we went to Firestone, gym, did some researching on EEB majoring, and then headed back to dorm and rested for the rest of the day
- We got to have dinner with Joie today which was quite nice! It’s always super duper nice seeing Joie and being able to talk with her spontaneously she is such a beautiful person!

3/17/24
- It is quite crazy that this morning, we were eating croissants in Paris and then by night time, we are now sitting in our dorm at Princeton waiting for our laundry to be done. I don’t know when and how this world got so small, it used to take people months to get from coast to coast and here I am doing it within a single day. Anyways, I am grateful for the entirety of that trip and am grateful for umma for bringing me there
- We got to grab dinner with umma and appa at the Myeongdong Kalguksu place which was pretty nice! I enjoy being able to eat all of thattt. And then also we got to have the best croissants ever this morning at the famous bakery so that is another thing to be grateful for!
- We didn’t actually think that the flight back to the US was very long since we literally slept for 7 hours of it so I am grateful that we are back in the US and not completely jet lagged (I may be speaking too soon honestly), but I am of course grateful that the flight went by so fast so I didn’t have to spend so much time wondering how to pass the time.

3/16/24
- We got to go to Mont St. Michael today which was a SUPER duper experience. I loved it so much. There was so many aesthetic thingies and so much fun and so much wow experiences since it was actually real, not a movie set
- We took a FIRE nap on the car ride back home from St. Michael and we knocked out for the entire 4 hour ride. So grateful for that
- We got to spend the entire day with umma today and I love spending time with umma and I am happy that umma exists and I love umma. I am grateful for umma.

3/15/24
- Today was also a very very full day. We woke up and then we went to see Luxembourg and then a bunch of other super cool places and the opera house and the Eiffel tower at night and then montmarte and I had so many new experiences today that I am grateful for all of them.
- We took 2 NAPS TODAY I AM GRATEFUL FOR NAPPING B/C THAT IS HOW I AM ABLE TO GET RECHARGED AND BE ABLE TO DO MORE COOL STUFF
- We got to eat the world’s best croissant today. It was genuinely the world’s best croissant. I love it. DELICIOUS.

3/14/24
- Welcome to PARIS! We had a lot of fun today but omg it was honestly the most tiring day EVER but I think it was completely worth. So we got a total of like 3 hours of sleep, and then we got off the airplane (on this lil bus), took an hour to get through customs, another hour to get our transit card, and then another hour to literally ride to our hotel and then we ate lunch at this Italian place with FIRE mozzarella sticks and then we went to the louve, the arch thingy, Eiffel tower, took a NAP, and then we went to make a reservation, walked around enjoying Paris like Notre Dam or Shakespeare book store before grabbing dinner, and then we came back and KNOCKED out
- We got to take a BUNCH of super duper cool photos here and then also we got to spend a lot of time with umma which I am grateful for. And the food is honestly not too great, but it is a FANCY experience so I am enjoying it. Especially since we’ll only be here for the weekend
- Bro im grateful to be here. FIRST TIME IN PARIS!

3/13/24
- We are grateful that we are going to Paris today 🙂 So we woke up and then we went to Woodside with umma and appa and then we went to Queens Public library to attempt to do some work, lunch @ sushi place, and then we walked around and fooled around until it was time to go to the airport, and then we ate dinner at a bunch of different airport lounge rooms and then we took our flight!
- We got to walk around with appa around the cemetery which was interesting… And then we also got to have a pretty good conversation with him about literally everything. I am grateful that he is our appa since he’s a very very wise person
- We got to try out airport lounges for the first time which was pretty coolll They have like lil all you can eat thingies there and the couches were pretty nice. And then we are going to get to spend the rest of this vacation with umma so that’s PLENTY exciting

3/12/24
- Today was a relaxed-filled day today so I am grateful for that. We woke up and then we ate a bit and then went to the library, then gym, halal, then Starbucks, then Paris baguette, then home, then movied TWICE with umma and appa and then we scrolled through Instagram for like 2 hours before we went to sleep. Lots and lots of rest today I love it
- We got to work at Paris Baguette today and honestly that was a lot of fun and the coffee there was kind of bomb so I liked that too. And then the work environment at Paris Baguette is very very helpful for studying so it was honestly really helpful in writing our blog post and then getting some orgo studying done. And then we also got to eat some very very yummy halal food today which I am grateful for.
- We got to watch Pretty Women (ITS A MOVIE NAME) with umma and appa today and that was honestly a pretty good movie. I was told that it is a classic so I am happy that I was able to watch a classic movie with my parentsss.

3/11/24
- Today was an… okay day today. We woke up and then we got ready for a little bit and then we went to Josh’s house to try and get him up but he is a lazy butt face so he didn’t get up, and then we went to the library to do some work, and then we went to poke bowls, and then we came back and took a FAT nap, woke up and watched some movies with umma and appa and then we ended the day with just a little bit more orgo lab reporting
- We got to have some fun annoying Josh today so honestly that was a lot of fun. But he didn’t end up coming so that was sad. And then we got a poke bowl which was probably the yummiest thing ever.
- We got to see Isabelle at the library today so that was the interesting surprise! Super duper sweet that she came up to us to say hi though

3/10/24
- Good day today overall. We woke up and then we went to church, and then we got lunch with Josh and Jae, and then we went to our house to play poker for a bit, and then we got to enjoy time with babies and eating here, and then we took a nap, then we woke up and then helped Joey with a bit of homework, took a bath, and then studied a bit for our POL midterm before taking our POL midterm and then we finished off the night with just watching some TV/movies so it was both a relaxing and productive day today.
- We got to get our POL midterm out of the way so we don’t have to worry about that at all anymore so that is something to be grateful for. We are officially completely done with midterm season go yay for that!
- We got to see Josh and Jae today and then talk with them for a bit so that was nice. It’s always an interesting time spending time with them so I am grateful for that and having friends here that I can just hang out with !

3/9/24
- Today was a rest and home day so there was not much that I really did. I woke up at around 1 and then went to breakfast at Yeh, did some laundry, and then went back to sleep… woke up at around 6, went to dinner, and then cleaned/packed a little bit until we got picked up by appa, and then we went to see Joshy and drop off a hoagie, and then we went to home and then just bummed out enjoying home until it was time to go to sleep (we started watching a bit of Avatar so that was quite nice 🙂
- We got to GO HOME! I am grateful for being home. I LOVE BEING HOME >> Happiness
- We got to have a very very good conversation with Appa on the car ride home today he honestly taught us so much about how money works and how to not go broke when we are older. And then taught us that we have to get a better mindset about going to dental school. It’s do or die. There is no “if I don’t make it It is okay.” Nah I gotta lock in and go for this. And he is a very very wise man I am happy that he is my dad.

3/8/24
- I am grateful that today was a day full of rest (towards the latter half of it LOL). So we woke up and then we got breakfast before giving the card to Kevin, and then we worked a bit on our POL paper before going into chem lab, and then we worked some more on the POL paper, and then we bought Jocelyn’s cake, gave it to Katie, went to SC house, and then we ate cake, barnes and nobles, went to movie, saw Kung fu panda 4, and then we went back home and then watched Schindler’s list and dude that movie is an emotional rollercoaster wow…
- We got to have a lot a lot of fun today from 5pm onwards to celebrate Jocelyn’s birthday so I am super duper happy and grateful for that! That was super duper nice and exciting and happy 🙂
- We finished our stupid POL paper and so we are grateful that is completely over with 🤩

3/7/24
- I’m hanging on by a thread, and all I’m clinging to is prayers. And every breath is like a battle, I feel like I ain’t come prepared. Those are the lyrics of I’ll Find you and honestly they apply to my life so much right now that I am grateful for tori kelly and lecrae for making this song for me to listen to right now as I’m writing this journal LOL
- So today, we woke up and then we went to POL precept, and then we went to SML midterm, and then we studied a bit for chem before our POL lecture, and then we bought Jocelyn’s birthday card before just studying in Frick and then working a bit on our POL paper, and then we took our stupid chem midterm, and then we went to Robertson and just worked a bit and planned a bit for Jocelyn’s birthday before going to colo and PIZZA, and then we slept. So a very very busy day today but I am grateful for the business.
- WE ARE ALL DONE WITH THE STUPID CHEM AND SML MIDTERM SO YAYAYAYYAYAYAY Go us I am thankful for that and now I only have to worry about POL

3/6/24
- Today was a decently busy and somewhat productive day so I’m decently proud of ourselves for that. So we woke up and then we went to breakfast with Daniel, and then we went to our HUM lecture on zoom (while taking a shower LOL) and then we worked on our paper for a little bit (skipping orgo lecture), and then we went to POL lecture which was honestly really great and it was an excellent lecture on the conclusion of the Education of Cyrus, and then we went to CHM lecture (where we basically just studied for SML), and then we went to Stone, worked a bit before going to HUM precept, and then we worked on our paper for a bit before going to colo for dinner, and then went back to work before POL precept, and then we got sushi at colo before finishing off the night with just some more SML and CHM studying… I WANNA BE DONE W THIS
- We got to grab dinner with Ashley today so that was quite nice! I like coincidences and being able to just see people and grab meals with so that was nice
- We got to get lots of progress done on our POL paper so that was helpful. And then our breakfast conversation with Daniel was great too! He is a very very wise man and so so considerate, nice and happy and knowledgeable so I am grateful that he is a Manna Staff Member.

3/5/24
- Today was an okay day. We learned a lot so that’s something, but it was also a lot of work… So we woke up and then we went to SML Lecture, and then we studied for SML and did some POL reading before POL lecture, and then we went to Stone to attempt to study some more for chem and do some pol papering, and then we got dinner with Jocelyn and Xuanying, we went to Office hours for chem, did some chem textbook questions, knocked out another practice SML midterm, and then we finished the night with some spontaneous chem studying, pushups and politics paper.
- We got to grab colo dinner today which was pretty nice! And then also they gave us midterm care packages to make sure that we don’t die studying so I am grateful for that. And I am also grateful that I got to grab dinner with Jocelyn and Xuanying.
- We got to get a lot of studying done today for SML and chem so honestly I’m decently proud of us for that. GO US!

3/4/24
- We are finished with our first midterm of midterm’s week so that is something to be grateful for! I am happy that we are all done with HUM and don’t have to worry about that anymore 🙂
- We woke up and then we did HUM, then orgo lecture, then POL lecture, and then the next chem lecture before taking a FIRE nap, and then we went to dinner at colo, got to watch some nemo before late meal, and then we went to Stone to just grind out some chem and sml studying before heading back to wawa and getting ice cream
- WE GOT TO WATCH NEMO AT COLO TODAYYY that was honestly super duper fun I LOVE NEMO and I forgot how fun those pixar movies are. I like being able to just take a chill pill every once in a while and just relax.

3/3/24
- Today was honestly not a great day but I know that we should always be grateful so it is okay. We woke up and then we went to church, lunch, playa bowls, attempted work before pizza, failed attempts at work before just going to sleep, and then more attempted work before going to maruchi with Jocelyn, and then we had our 1 on 1 meeting and then finished the night with just some HUM studying and then finishing the day.
- We got to hear a pretty good sermon today about the importance of unity within the church so that was quite refreshing to hear honestly We really do need to be unified. And then also we got to get a playa smoothie today which was honestly really really good but it kinda was pretty expensive.
- My jaw was KILLING me today, but in the end, it all worked out somewhat okay because we got some tylenol and numbed the pain a bit. So grateful for drugs 🙂

3/2/24
- Today was a pretty good day today. We woke up and then went to Brunch at whitman before heading off to Stone to do some work, got a free mug, and then more work, went to tea party, and then more work, and then went to U-Store and then bought toothpaste and razors, and then we went to Manna large group and then we did praise team practice, manna large group dinner, and then praise team at Manna, and then we finished off the night with just some working on our POL paper
- We got to get honestly a decent amount of work done today so that was pretty exciting! We did our chem pre-lab assignment and then finished our POL question so that was pretty productive. And then also we got to serve on praise as per usual so I should be really grateful about that.
- We got to get a free mug at campus rec today and it was a super duper nice mug so I am really really happy about being able to get free stuff like that. Honestly that’s really op GO US!

3/1/24
- Happy first day of March Jonathan! Today was honestly super duper fun. Very good balance of work and fun today. We woke up and then we worked on our chem pset, and then we got lunch and then went to chem precept, and then we went to orgo lab, and then finished up our chem pset before heading to colo to have our dship meeting with Soonho, and then we got dinner with Jessica before heading over to the sympoh show, and then we went to hoagie haven and the NOVA house before going to late night show, and then we headed back to our dorm, had an interesting conversation about infant baptism with a bunch of PCF people, and then we went back to go to sleep. So there was a lot of thingies done today.
- We got to have a lot of fun at the Sympoh show today so I am happy about that! That was honestly such an interesting… show and we got to cheer on Xuanying and Ozi and Skywalker so all of those people did pretty well. But it was a bit sus LOL… to say the least.
- We got to watch the late night show with Mary Grace and Jamil and honestly that was the best show ever I am so impressed. It’s like honestly better than any of the shows that I’ve seen online. There was humor, dancing, singing, skits, motivation, Mia, AND SO MUCH FUN! And like honestly I never thought I could have that much fun from a show before so I am grateful that I got to see it. And then we also got to see the voice actor of Boots singing so like where else in the entire world would we be able to get something like that??

2/29/24
- Productive day. Busy day. Good day. We woke up and then went to POL precept, and then SML lecture, and then did some work before POL lecture, and then late meal before CHM precept, and then a bit of work before meeting with Projects Board for funding, and then dinner and then office hours for chem pset, and then worship night thingy, and then more work at the end of the day
- We got to have dinner with Inwoo which was pretty nice! She is a very very fun person to talk to and it was so interesting cause she knows a lot of syosset people so it is nice to get a taste of home. And also the food at colo was pretty fire so very very yum
- There was a lot of blessings at the worship house night thingy tonight. I am glad that I get to recenter myself and focus on what’s really important.

2/28/24
- Bro so much happens every day there’s always something to be grateful for… We woke up and then we went to our HUM lecture, and then we went to orgo lecture, and then went to POL lecture, and then late meal with the next chem lecture, and then we did a devo before going to our HUM precept, and then we got a free shirt at measure your mood before going to Firestone to do a bit more work, and then dinner with Bryan, chilled a bit with the other Brian at Stone before we went to POL precept, and then Colo for some aunt annes, and then late meal, empanadas, and then we just tried to eat and work on our Chem pset for the rest of the day
- We got to have a very very enjoyable lunch with Bryan Wang todayyy. I am happy that I get to grab meals with the seniors before they all gooo. Who else is there that I want to grab a meal with before they graduate? Maybe Kevin Kim? Idk but they are all such great people and I am going to miss them lots when they are all graduated and I am so happy to have met them
- We got to get a free t shirt with super duper cute tigers on it so that’s cute! And then looking at the thingies at the Firestone special collections and seeing all of those super duper old books was pretty interesting as welll

2/27/24
- Very very good and relaxing day today so I am happy. We woke up and then we went to SML lecture (which we did not pay attention in at all, we just sent out random emails and signed up for random events), and then we headed to POL lecture and then just did some readings as well as signing up for a few events, did POL lecture, and then we headed to grab late meal, went to Stone to do some meaningless work like 3D printing training or just organizing, and then we hit the gym, went to Colo for dinner, and then we went to our PPDA officer meeting, went to learn 3D printing, went to our SML precept to check our project, went to late meal again, and then went to Stone to finish the SML precept, and then went to Frist to just do more meaningless work while watching the Big Bang theory 🙂
- We got to grab dinner with Joie today which was exciting and she is super nice to talk to. And then we also had lots of fun talking with people just in random places throughout the day. I am grateful for friends.
- We got to learn how to 3D print today which was honestly SUPER DUPER COOL that was really fun and then we printed a bird whistleee. And then we gave it to Jessica! Loved today it was great great great

2/26/24
- Good day. Done with the stupid orgo test. Am grateful that I am done with the stupid orgo test. I no longer have to worry about that and can just enjoy chemistry for what it is 🙂 ❤
- We got to have dinner with Lindsay so I am grateful for that! She is such a fun person to talk to and I am glad that I am going to spend the next few years in chem department with her
- We got to go to all of our classes today which was a pleasant surprise despite the fact that we had a test to study for. So grateful that we aren’t too overwhelmed to not go to classes.

2/25/24
- We have got to STAY IN THE GOOD MOODS JONATHAN! STAY IN THE GOOD MOODS. We woke up and then we started our laundry, got breakfast and then studied for orgo, and then we finished our laundry before going to colo to study some more for orgo, and then we ate lunch and then got to spend some time with Edward before going back to Stone to study for orgo… So much studying. I am tried. But I am grateful that we get to even study in the first place 🙂
- We got to grab junbi and take a really nice walk around campus with Edward which was quite the pleasant surprise! I am happy that we get to just see people like that so spontaneously and spend time with them and then catch up with how his life is goinggg
- We got to eat a pretty fire dinner today at colo because the chicken was actually overwhelmingly good. 🙂 SO TASTY I LOVE IT >> And then also we got to drink some junbi today too!

2/24/24
- We had a pretty enjoyable day today! We woke up and then we went to the engineering library to do some orgo studying right away, and then we went to UCA office hours after we got lunch at colo and then afterwards, we went to our SML group meeting and divided up the work, and then we went to praise team practice then manna LG afterwards, and then we ate before just studying for orgo for the rest of the dayyy
- We got to have a lot of fun at Manna LG today which was really nice! And also it’s always great to be able to do praise and recenter ourselves on Christ. We really need to get our priorities straight about Christianity and start taking our faith seriously. Dude if you’re going to spend so much time here, then you might as well take it seriously.. But grateful for Manna for re-orienting ourselves on Christ
- Geoff gave a very very helpful message today which was a reminder that our priorities should be to serve those around us. To put ourselves in a position to interact with the lost/forgotten.

2/23/24
- I think that we had a pretty decent day today with some sort of productivity so I am proud of us 🙂 We woke up, studied a bit for orgo before grabbing lunch, and then we went to CHM precept, then orgo lab, then we got late meal before heading over to colo to study a bit, and then we had our dship meeting with Soonho, ate dinner at colo, and then we went to Frist to study for orgo a bit, and then we watched the Koko pops show, and then we went to a random room to study some more, and then we also ate hoagie haven before heading back to our dorm to rest up for the day
- We had a very very enjoyable time at the Koko pops show today. It was honestly a LOT of fun and very very funny and THE PEOPLE WHO WERE DANCING WERE SO COOL. I am really really grateful to be able to see my friends up on stageee
- We had a very very enjoyable meal at Colo today and there was clam chowder which was super duper yummy 🙂 AND ALSO WE GOT TO EAT HOAGIESSSS They were so yum and I am so happy to have eaten them < 3

2/22/24
- Today was a… decent day today. We woke up at like 4am, and then we went to DC and then we got to tour the House of Representatives, we got back at 6, took a nap until 10, and then we went to get tylenol, open room for dinner, and then finished off the night with just some studying for orgo.
- We got to sleep on both the bus ride to and from DC which was a lot of sleep, and the nap afterwards was pretty good too 🙂 So I’m glad that we weren’t bored out of our mind on our way back to Princeton
- We got to see the room where FDR gave his day of infamy speech which was honestly super duper cool and very very interesting. And then we got our lunch paid for and it was nice as well for that : )

2/21/24
- Today was a good, fun, and happy day so I am proud of us for that. We woke up and then we went to our HUM lecture and printed out our HUM paper, and then we skipped orgo to submit our SML precept, grab a coffee, and then got lunch at colo before we headed to our POL lecture, and then we went to the first half of our chem lecture, and then we went to the POL precept before heading directly over to the HUM precept, and then we got a haircut before picking up our guitar strings from Frist, attempting to put the guitar strings on the guitar before going to dinner with Karen Swallow Prior, and then we went to the first bit of her lecture before going to POL precept, and then got late meal before heading back to our dorm to finish putting the guitar strings on our guitar and then studying for orgo a bit before we went to sleep
- We got to have lunch with Jocelyn, Joie and Jenny today at colo which was really really nice, and the food was REALLY REALLY GOOODDDD DUDE I AM SO SO BLESSED TO EAT YUMMY FOOD LIKE THAT I AM SO HAPPY. Colo actually has the best food ever it beats dining halls by FARRR. And then dinner was all paid for and we ate until we were very very full but it was chicken parm, pasta and eggplants which was all super duper tasty and we got to eat it with Manna people
- We got to go to most of our classes today which is good on us! And then we also learned a lot about… just everything in general. Today was a much needed rest day from the gym, but honestly I don’t think that I’ll find much time to go besides after the orgo exam because I need to spend LOTS and lots of time studying for itttt

2/20/24
- Today was an okay day today; pretty productive, but also a little bit tiring so there’s ups and downs to it. We woke up and then we went to our SML lecture, and then got lunch with Julia before going to POL lecture, and then we went to late meal before heading back up to Stone and then we worked a bit before going to the gym, then colo dinner, then our PPDA meeting before an attempted SML precept, but then we decided to leave to just go to late meal and the library and do other work
- We submitted our HUM paper and finished our youtube video and it’s all set to be uploaded tmrw morning and then we also got our SML precept done which is honestly REALLY really productive Jonathan I am proud of us for accomplishing tasks and getting thingies done. But actually right now you don’t have the SML precept done and you are just saying you have it done because you’ll work on it right after this… right? right??
- We got to have lunch with Julia today and then we grabbed dinner with Jocelyn and both of those meals were very very spontaneous, and both of those meals were really really great. I am happy that I get to have both deep and fun conversations with people and can enjoy their companyyy. I’m gonna miss being able to see people at dining halls when I join the eating clubbb. I won’t be able to just start randomly grabbing meals with people that I like.. in any case, nonetheless grateful for being in the moment right now. 🙂

2/19/24
- Today was a surprisingly productive day so I am proud of ourselves for that! We woke up and then we went to our HUM lecture, and then we went to chem lecture, POL lecture, late meal and then the next chem lecture, gym and then worked a bit on youtube video until the Colo Event thingy where we became an official member, and then we had dinner there before going to Stone and honestly getting a decent amount of work done sooo go us! And then we headed back, got wawa, and then bunch of other work as wellll
- We got to grab dinner with Michael, Xuanying, Joie, Por, and Boya which was really nice to have a majority reunion there 🙂 And then we also had a pretty fun conversation about kicking people in the face or getting mugged and…. idk why I’m like this. Or why they are friends with me. Like seriously I am so grateful for my friends cause they put up with my weirdness…. < 3
- We got to have a pretty productive time at the library cause Starbucks closes at 8. We are happy that Starbucks closes at 8 cause then we can get coffee at night! And honestly that helped us stay awake soooo GRATITUDEEE.

2/18/24
- I think that today was a SUPER fun and enjoyable day I am so happy to have done everything that I did < 3 We woke up and then we went to the Wicked Show, watched wicked after grabbing some lunch with Chimwyewye, and then we came back to grab some dinner, hit the gym, and then do some work in the library until we got tired, and then we went to studio 34 and then just messed around until it was time to go to sleeppp
- Bro Wicked was absolutely WICKED I loved the broadway show sm omg. It was super duper cool and also the singers were amazing and the graphics was great and the story made it so that I don’t actually want to just fall asleep in the middle of it like all of the other shows that I’ve been to, and then the nap back from the show was the bestest nap ever, and then we got to enjoy Halal guys and overall I am so grateful to have went and seen that showww
- We got to see lots of people both at the library and at the gym today so I’m happy that I get to see peopleee 🙂 And then also we got to have a very very interesting and informative talk with Chimwyewye throughout the bus ride and throughout our lunch as well. He is a very very good speaker and quite thoughtful in everything that he says so I am grateful to know someone like him that’s kinda insanely devoted and dedicated and cool and awesome

2/17/24
- Today was the MOST unproductive day we have ever had in our entire semester, but I think that it is completely worth it since it was an extremely fun day as well. We woke up, took a shower and started our laundry before heading to lunch, and then we came back and took a nap, finished our laundry, hit the gym, got dinner with umma and appa and shopped around with them, went to a ceramics class with the rest of PPDA, went to COLO initiations, and then finished off the night with literally just random chore thingies.
- The Colo Initiation was a really…. interesting time so I enjoyed it a lot. We got to hit people with shaving cream and then wrestle in a tub of jello and play jenga and get free dominos pizza so it was all pretty fun and unique and quirky! I’m glad I can have college experiences like that LOL
- We got to have KOREAN FOOD with umma and appa and I LOVE IT CAUSE I LOVE KOREAN FOOD ❤ And also we got to see lots and lots of people at the gym today so honestly I’m really really happy that I’m able to take some saturdays off… Lowkey I think that we should start having more time to ourselves to be able to explore and do things random than over commit to Manna. Of course I am still extremely grateful for Manna and being able to do everything in Manna, but I also think that there really should be no pressure to go to literally every Manna event so that I can become more well-rounded.

2/16/24
- Today was on the more unproductive side as well butt it’s alright. We should be enjoying the unproductive days too. We woke up and had some lunch before going to chem precept, and then we went to chem lab, and then we went to late meal to submit some work, and then we went to Stone to do some more work, and then we went to the manna ST meeting, and then we hit the gym before prepping for the Orange Key interview thingy, then we got pizza and then we went back to our dorm and just went to sleep
- We had lots and lots of chemistry today but honestly I really liked it. It was pretty enjoyable and we were able to do everything in mostly a timely manner so go us! We are pretty efficient in lab and are able to get some stuff done so I am grateful for that and the ability to work efficientlyy. Also chem precepts are super duper helpful but I am also realizing that I am no where near as smart as everybody else LOL
- The Manna ST meeting was good and helpful today. But it did prompt a lot of thinking and self reflection which I am honestly pretty grateful for… Do we pray to make ourselves feel better? And if that’s the case, then what the heck do we pray for other people for cause that is kinda selfish then… Anyways, we also were able to get a free pizza from a random pizza store so I am grateful for this lady for being super duper nice.

2/15/24
- Today was quite an enjoyable day so I am happy about that. It probably was not as productive as I would have hoped for, but it was still a pretty good day. We woke up and then we went to our POL precept, and then we went to SML lecture, and then we did a bit of reading and work before our POL lecture, and then we got late meal before chem precept, then we took a FAT nap before going to grab dinner with Matthew, and then we went to chem office hours to get some help, and then we talked with Kayley a bit before grabbing some more late meal, and then going ice skating, and then finishing off the night with just some SML and youtube.
- We got to see Julia a lot throughout the day so honestly I am always grateful to see her since she is a very very big ray of sun shine. And then also grabbing dinner with Matthew was pretty nice 🙂 We had a pretty good conversation. And then office hours today was super duper helpful so yay for that.
- We got to go ice skating for the first time in quite a while today and mannn it was honestly really really fun. I enjoyed it a lot. We got to first relearn a bit of ice skating, and then once we relearned it, it was just a matter of trying to get our foot not to cramp and die on us. But since it didn’t, everything pretty much worked out in the end < 3

2/14/24
- Happy Valentine’s day. Essentially that means happy regular day that is absolutely no different than any other day! Honestly I really really liked today and am super duper grateful for today so I am happy about that. We woke up at like 8:30, and then we got breakfast with Daniel and really learned a lot from him. It’s not about balance, it’s about tension. We should learn how to lean far on both ends on both directions to support solid structures, not a 50-50 balance. And then we went to our HUM lecture, then chem lecture, and then late meal and coffee before going to POL lecture, and then we went to another chem lecture, and then did some HUM reading before HUM precept, and then we went to colo to do some work before we got dinner with Marvin, and then we went to our POL precept, and then we went to the gym, went to late meal, and then went to stone to finish up the SML assignment 🙂
- We got to have breakfast with Daniel, dinner with Marvin, and then late meal with Kellen and Daniel (frosh) which was honestly really really nice I’m glad that I’m able to catch up with all of them and see how everybody is doing. And also Marvin is super duper nice I’m glad that I’m going to be able to room with him next semester.
- We got to do a few new exercises in the gym for our back day since there is LITERALLY no back machines anywhere. And then we also figured out that instagram reels are literally the funniest thing on this planet earth BUTT NO ONE ELSE UNDERSTANDS OUR HUMOR SO THIS IS SAD but also I friggen love my humor it’s SO funny.

2/13/24
- We had a pretty good day today; but probably because we literally slept through the majority of it. But honestly I am grateful for sleep. I am super duper happy that I get to have as much sleep as I could possibly need at this school and not be completely dead all the time. I LOVE SLEEP. But we are kinda sacrificing our social life for sleep and grades. But that is ok. We need sleep. I am grateful for it.
- We got to grab dinner at colo today which was a first! Super duper cool. And then we also had a lot of fun doing work w James, Xuanying, and Joseph today at Frist. It was super duper funny being able to talk with all of them and the interesting conversations that come out from us being weird… I love that I’m able to just be myself now around people it’s super great and I’m happy that I am here.
- We got to get a decent amount of work done so I am honestly pretty proud of ourselves for that. We got to get the rest of the chem lab report done, and then we edited our chem 373 pset while also reading some of the HUM thingies so look at us doing workkk. But also at the same time we are falling behind in other ways for other classes sooo that’s not good. Anyways, happy.

2/12/24
- We had a pretty productive and fun day today! We woke up and then we went to breakfast where we got to see Erica and talk to her for a bit, then we went to our HUM lecture, then went to our orgo lecture, then late meal before pol lecture, and then another chem lecture, and then we went to the judge meeting talk thingy where he convinces people not to go to law school, and then we went to the gym, went to the library to do some work before going to roma for dinner with Brian, and then back to the library, then back to Frist, then attempted to do work in coffee club area where we ran into Angel, and then we headed back to our dorm for sleep time 🙂
- We are super duper grateful for being busy here and also productive and seeing lots and lots of people ❤ I like seeing people. And also I am grateful to be at Princeton. We had a pretty good catch up with Brian over dinner and all of our classes today were pretty interesting so I am grateful about that as well..
- We got to grab a pretty fire dinner today and also we got to have a lot of dessert at the James Madison thingy with the judge who went to Columbia and Oxford and everywhere super duper cool and he was a really real person and also talks super well. And then it was also really really nice being able to cash in on all of the fancy sandwiches and cookies and cakes and such afterwards ❤ And the still water is yummy too. I like James Madison Fellow Program.

2/11/24
- Lovely day today. We woke up and then we got to go to church, and then laundry + lunch + gym, and then we submitted our SML PSET before going to grab dinner, and then we went to open room to watch some of the super bowl, and then we went back to our dorm, took a 4 hour nap, and now it’s 2am and there’s 0 chance that you are going to be sleeping any time soon so might as well make the most of being awake rn!
- We got to grab lunch with Michael and Jocelyn and then we had dinner with Paul and then it was also pretty nice to steal some dominos pizza from open room during the super bowl todayyy. All of that was super duper fun and enjoyable and FOOD YUMMY and I like food so I am grateful for food.
- We got to honestly hear a very very interesting sermon today at Hope so I am honestly really grateful to go to that. And then we also got to spend much of the day relaxing and not stressing about thingies to do so that in itself is another thing to be grateful for ❤

2/10/24
- Today was a good day. We woke up and then we had lunch with Timmy, and then we worked for a bit before heading over to get Tacoria, and then praise team practice, then large group, then finished manna and then we went to studio 34 and talked with umma before going back to our dorm and kinda bumming out for the rest of the day
- Timmy is a super duper great and friendly guy I am really grateful to have met him here! And his testimony is really really powerful and he’s so nonjudgemental and so welcoming and friendly that I am super grateful that I have him in my life.
- We got to serve at Manna Large Group again today, and that in itself is something to be grateful for. We are grateful to serve. We must be grateful to serve. I’ll obey and serve the Lord… or at least I will try to and will strive to. But I’m not doing such a great job at that….

2/9/24
- Honestly today was a pretty good day despite the fact that we started it super duper late. First we woke up at like… 12 and then we went to our chem precept (honestly I really really like the precepts for chem), and then we went to chem lab, and then we hit late meal before going to the gym, and then we went to the library to do a bit of work before heading off to our discipleship meeting, and then we got dinner at colo, we tried out the computer there for cs and taught Jocelyn and Xuanying a bit, and then we we went to Firestone to do some work with Jocelyn before we headed back to our dorm to do some work after Studio 34
- We had a very very productive conversation with Soonho today for our discipleship meeting which was quite nice! We talked a lot about if people can be Christian if they hold non-Christian viewpoints, and he explained how it depends how we read the Bible. If we genuinely think that this is what the Bible says, then this is what we should be doing. But if it is not what we genuinely think the Bible says and our decision is influenced by our culture, then we should not. Very very informative.
- We got to see everybody (except kevin) at the dinner at colo today which was pretty nice! And then also we worked with Xuanying to teach her how to do cs go FUN

2/8/24
- We had a super duper lazy and unproductive day today which was honestly really needed and super duper nice so I am grateful for that. We woke up and then we went to our POL precept (late), and then we skipped SML lecture to just get lunch and write an essay, and the we went to POL lecture, and then we went to late meal before Chem precept, and then we played some video games at Fine hall, and then we ate dinner before attempting to go to the lunar new years celebration, and then we hit the gym, and then went to chasing magic tap dance performance, and then we got late meal again before NCW coffee club, and then we finished the night with LAZINESS!
- Bro there were many many new experiences today which I am honestly really happy abouttt. We got to go to Fine Hall bottom floor and we PLAYED CS 2 ON THE BESTEST COMPUTER EVERRR. Yeah yeah yeah I loved the computer. It ran so so smoothly and even though we lost, we played pretty well LOL. And then we watched the tap dance performance which was interesting, good experience. I wouldn’t go again tho. And then we watched a coffee club acapella performance which was FIRE! BRO they are so so good at singinggg
- We honestly overall had a really really relaxing and pretty fun day today so I am overall grateful for that. I am happy that I can relax sometimes and take a chill pill. CHILLING is so so much better when we genuinely deserve to chill LOL

2/7/24
- We had a pretty good day today so I am thankful about that < 3 We woke up and then went to Chem lecture, and then dropped a HUM class which we then immediately re-enrolled in, and then we went to late meal before going to POL lecture, and then another chem lecture, and then we had a crisis before going to HUM precept, and then we went to the gym, and then we went to Stone to do a bit of work before going to dinner with Ryan, and then we went to another POL precept, and then went a little bit to colo, late meal, and then back to Stone to do some more work
- We are super duper grateful for our dinner that we had with Ryan today because he is a very very knowledgeable and mature person. He is super duper cool and gave very insightful points into Christianity that I had not considered before. People coming to Christ is a miracle, God does not lie because he is not intentionally deceiving, rather, he really was going to destroy the Israelites when he said he was going to.
- We went to 6 classes today, had a pretty productive dinner conversation, went to the gym, and wrote a few essays. We are KILLING it jonathan I am super duper grateful for being here and all of the thingies that I can be productive about. GOOD JOB JONATHAN 🙂 Super grateful for all
2/6/24
- I honestly don’t know how exactly we felt today, lots of ups and downs in terms of emotions, but overall this is a gratitude journal so I shall journal what I am grateful for! We got to sit next to Julia in SML lecture today and also see Cevina there too so both of those thingies are something to be grateful about. I LIKE HAVING FRIENDS!! And also we spontaneously got lunch with Boya WHICH IS MORE TO BE GRATEFUL FORRR
- We got to have dinner with… 4 other Manna sophomores so I am grateful for community and fellowship and people >> I also am overall grateful for my politics class which is super duper understandable and fun and enjoyable so yay for that
- We got to talk with Xuanying a lot towards the end of the day in Firestone and had a very very honest conversation with her. She is very very easy to open up to and talk to so I am grateful that I have her in my life. And am grateful that she is my friend who I can be real with!
2/5/24
- I think today was a really really great day I am happy. I don’t know why I think it was better than any other day, but I really enjoyed it. We woke up and then we went to HUM lecture, and then we went to CHM lecture, and then we went to POL lecture after getting late meal, and then we went to CHM lecture for 373, and then we got coffee before hitting the gym, and then we went to the library to do a bit of work, and then got dinner, and then we went back to Firestone before we headed back to our dorm to finish off the night and just sleep
- We got to have a lot of really great conversations today so I am super duper happy about that < 3 We got to talk with Jessica at dinner today and she is such a sweet and thoughtful and contemplative person I love her for it. And then we also got to talk with Ryan and Maya at Firestone today which was a very very fun conversations, and then also we walked to chem with Sua today so that was fun as well! Lots and lots of fun was had todayyy
- We got to do… some work today so that was interesting. But it was also really really great being able to go to lectures today and actually understand everything (well not everything but most things) that was said throughout the lecture so I am glad about that. I like learning. Like I genuinely like learninggg. I want to learn more and am super duper grateful to be at Princeton.
2/4/24
- Today was a pretty fun day so I am grateful for that < 3 We woke up and then we went to church, and then we had lunch, hit the gym, did our laundry, went to the library, got dinner, bent spoon, back to library, Studio 34, and then went to sleep
- I am grateful for friends 🙂 We got to go to Stone with Xuanying and then we also got bent spoon with Brian, David and Xuanying so that was funnn
- We are grateful for umma and appa and God. There was a bit of a realization today. Jesus actually died for us. What more is there to be grateful for.
2/3/24
- Today was our first Saturday at Princeton so that was lovely < 3 We woke up, ate and then we went to Firestone to do some work, and then we went to praise team practice, and then did some praise team stuff during large group, and then we also finished off the night with going to home and eating some wawa at night
- We got to see all of the Manna people today and then also today was the first LG that Geoff, Esther, and Daniel were at so that was quite refreshing! It was nice being able to see all of them and being able to hear all of them talk during LG. And also of course it is always nice being able to see all of the Manna people
- We got to have a lot of fun during LG today and also we got to have a pretty interesting conversation with Michael and Jocelyn after LG today which was pretty nice and very very fun so I enjoyed that a lot. Very very good day today < 3
2/2/24
- We had a pretty good day today so I am happy about that and our progress in life. We woke up and then we had breakfast before going to chem precept, and then chem lab, and then doing a bit of work before gymming, and then back to the library to tutor Joey and then dinner, and then FNF, and then we went back to our dorm and finished off our dayy.
- We honestly understood everything that was happening in chem precept today which I am super duper grateful and happy and proud of ourselves forrr. LIKE LOOK AT THAT. We CAN do this. We CAN SUCCEED THIS 6 COURSE SEMESTER. And even if we can’t, then we can probably just drop HUM right cause I don’t like HUM. Orrr we can actually pay attention in HUM perhaps? Well let’s find outtt.
- We went to FNF today and honestly I am super duper happy that I went there because there was cake for starters, but also BECAUSE PEOPLE THERE ARE SO HAPPY and it is actually really refreshing being able to be a part of worship and a sermon and not be tired and still have energy and not be doing piano. Of course I am still grateful and happy to serve on Manna praise team, but it’s refreshing to be able to just sing and worship without playing in it.
2/1/24
- That is kinda crazy that it is already February… HAPPY FEBRUARY THO. I am grateful that we made it this far and that now we can enjoy being here at Princeton and alive and doing life. We woke up in the morning, and then we went to our SML lecture, then we went to grab a quick lunch before going to POL lecture, and then we went to Chem precept, and then we hit the gym, then got dinner, then went to the T8 show, and then went back to the dorm to just chill
- We got to have dinner with Rebekah, Heather, and Lynn today so that was fun! Also seeing Heather for the first time in a while was nice. I am very very grateful for them, having friends at Princeton, and then also just being able to enjoy meals like that
- Bro the triple 8 show was FIREEE. It makes me really really appreciate all of the talent that is here at Princeton. Like I’m at a school with people who are capable of doing such amazing feats it’s kinda insane and I am super grateful to be in an environment like this one where I can enjoy the abilities and talents of those around me. And also we got to call umma today so I love that as well < 3
1/31/24
- Today was a productive day full of thingies. But I am grateful for having productive days full of thingies to do. We woke up and then we went to HUM lecture, and then we went to chem lecture, and then we got late meal before POL lecture, and then we got coffee before going to another chem lecture, and then we did some reading before going to our HUM precept, and then we went to the library to do some work before hitting the gym, getting dinner, and then going to a cancelled POL precept, and then we went back to the library, worked on a few essays for a bit, got late meal, and then went back to our dorm to finish off the night
- Evelyn is absolutely adorable. I am grateful that I have her as a friend. We got to get dinner late meal with Evelyn today so that was quite nice! And then we got coffee from Lindsay so she is super duper nice for that. And overall we are just grateful that we got to see many many people today < 3
- We honestly are feeling pretty ready and willing to take on this semester and be a chemistry major so go us! WE GOT THIS. YAYAYAYYA. I am grateful for everything that I have up to this point, all of the support that I have received along the way, and all of the memories that I will make this upcoming hell.
1/30/24
- Happy second day of classes Jonathannn. We are making the most of these enjoyable days where we don’t have to stress much so I am happy about that 🙂 < 3 We woke up early in the morning, ate breakfast, coffee, then did some work before going to SML lecture, then picked up some chem stuff before shoving down lunch, and then POL 396 lecture, then late meal and then firestone to do some work for a bit, and then we went to the PPDA interviews, then dinner, then Orange Key Tour thingy, and then late meal, and then gym, and now we are back in our dorm after showering for a bit.
- We got to have a pretty good day today so I am happy that we are enjoying our days before all hell breaks loose. We got to have dinner with all of the PPDA officers (probably for the final time before people leave) and so I am grateful for that and the experience of being an officer < 3 It’s super duper great I love it. And also we got to see so so many people today so that was quite nice as well! Like Ashley, James, Boya, and a bunch of other people that I am happy to see and talk to.
- We haddd pretty chill classes today so I am SOOOO grateful for chill classes. Like SML and POL seem so chill and the professors are so amazing I am very very excited to be in this class. Also I’m excited to just overall be here at Princeton. LET’S WORK HARD
1/29/24
- There are many many things to be grateful for today. We got to enjoy a BUNCH of cool thingies today since school just started and there were many many events happening. We woke up and then we went to our HUM lecture, and then we went to our orgo lecture, and then we went to get lunch, and then we went to our CHM lecture, and then we went to the gym, then we went to Firestone, then we got dinner, then we went to ballroom dancing, then we went to get late meal, then we went to our dorm to do laundry. So there was much fun thingies to do today 🙂
- We got to see so many people and familiar faces so I am super duper happy and grateful for that. We are meeting such amazing people and reconnecting with such amazing people I am not going to worry about socializing anymore. I just need to focus up on the studying aspect. But all in all I am grateful for people.
- We got to have lunch with the entire gang minus boya and then dinner with Jocelyn and Michael today so that was very very enjoyable. And also lunch today slapped pretty hard and it was super duper tasty so I am grateful that I was able to go to colo today for that !
1/28/24
- Babies. We are grateful for babies. I like babies. WE GOT TO SEE LITTLE BABY TODAY. Joe’s baby is the cutest baby. Baby baby baby. I am grateful for babies. I want a baby. I want to steal a baby. I love babies.
- We are grateful that we got to go to church todayyy and then we also got to go to Pastor Sam’s house for the first time and there was very very yummy food there so I am super duper grateful for God giving me such an amazing community and amazing people to spend time with and break bread with. 🙂 And also I am grateful for my friends at church who are just always there and I can always count on to seeee.
- We are grateful for umma driving us all the way to school again, taking our refrigerator, and also buying us hoagies. THANKS UMMA! Umma loves us. I love umma. LET’S GO ON AND TAKE THIS SEMESTERRRR.
1/27/24
- Today was an enjoyable day! We went homeee so that is something to be quite happy about. So we woke up, had breakfast with Kat before boarding the train that took us back home, and then we went to the eye doctor, got dinner, and then came back home and watched a movie and then eventually went to sleep after binging some youtube videos.
- Josh gave us this pokemon sweater thingy which was super duper cute and there is a squirtle on it so I am very very grateful for that.
- I am grateful to be home. I like home. And also we went to the eye doctor and they are giving us new lenses after 2 years so that is something else to be grateful for. And umma and appa bought us dinner which is something else to be grateful for. And then we had breakfast with kat which is another thing to be grateful for. Lots and lots of things to be grateful for.
1/26/24
- So I think I am going to start this day off at 12am since we slept from 10am-7pm today…. yeah our sleep schedule is kinda messed up. So I am going to include what I did throughout the night as this day LOL. So we first got to play some uno with PCF people, and then we changed to volley ball, and then we changed to basketball, and then we ended up talking for like 6 hours straight, then got breakfast, loaded the bus, and then when we got back to our dorm we KNOCKED out until like 8. Then we took a shower, got ready for bed, and now we are writing this LOL
- Honesty volleyball is super duper fun I am honestly really enjoying being able to play the sport with everyone and I kinda hope that I will be able to play it like in the gym sometime in the future. I wanna learn how to playyy. And then we also scored like 2 points in basketball soooo good for that too!
- We got to have a very very in depth and personal conversation with Katie, Brian, Michelle, and Sam throughout the last night of the retreat (Daniel was there too but he doesn’t count because he fell asleep). But honestly I really enjoyed the conversation that we had it was super duper productive
1/25/24
- We woke up at like 11:47am which was just in time for the picture, and then we headed to lunch and then got ready to go on the hike, and then we played chess and had some fun for a bit before heading over to dinner, and then we wrote letters to God, had class sharing, and continued on with our day!
- Today was so full of rest and relaxation and I am genuinely happy I get to have so much fellowship with other believers before going into the hell that is going to be school. We have to continue to surround ourselves with believers so that we do not get lost in the faith, but manage to keep it strong and healthy and goinggg.
- We had a lot of fun on the hike today because we got to talk with many new people, and then we really enjoyed our class sharing time because I think we kinda hogged up most of the time through asking our questionsss… haha I feel bad for anyone who has to be in the same class as I am because it is just going to be filled with extra questioning and doubting, but honestly I think this is really helping me to strengthen my faith. I need to figure out where I stand in terms of this.
1/24/24
- Another full day of retreating and so this was something to be grateful for. We woke up and then went to a roundtable about honoring our parents, and then we ate some lunch before going to the bowling alley, and then we played chess with Bryan for a short time before going off to a prayer meeting, eating dinner and then a bible trivia, and then we had evening worship, small groups/skits, and then volleyball + line dancing was super duper memorable.
- We really had a fun time with the skits today which was trying to replicate Moosho from Mulan going to a party and not being formally dressed or knowing how to give a speech…? We played the role of the messenger who orders Mulans dad to go to war so that was interesting. It was also super duper fun and cute seeing all of the other groups do their skit. Dude WARREN IS SOOOO FUNNY. LIke it is absolutely insane how funny these PCF people are LOL.
- We scored a 97 in bowling!! LOOK AT THAT. And then we also got to see how smart the other Christians in our group is when it comes to Bible trivia. Bro, Chimwyewye, Tim, and Noelle are absolutely insane when it comes to knowing the exact Bible verses like what in the worlddd. And then also line dancing was really really fun too! We learned like 4 new dances and the Virginia line something, and I LOVE THIS CULTURE. PCF culture is so much different from Manna culture, but it is SO MUCH MORE FUN ALOKDJG:LSKJDG:
1/23/24
- Today was just a FULL day of retreating so YAY for that. We woke up, got breakfast, and then prepared for a prayer meeting with Mack, and then did a bit of a devo before heading over to play some games, played dodgeball, volleyball, then practiced for praise team, lead the prayer meeting, got dinner, and then went to worship, and then went to small group, and then finished off the rest of the night with just fellowship with other people 🙂
- We had lots and lots of fun today and felt lots and lots of love. And also Ryan is such a good speaker and is super duper intentional about everything that he speaks/does so I am really really hoping that I can emulate someone like him in the future. I want to be not just waiting my turn to lash out and speak, but to thoughtfully open up like he does and share encouragements with us. Today, he opened up with 1 John 3 which explains how sinners are not in Christ Jesus, but then shows that even though this is true, we have an advocate in Christ Jesus which is shown in 1 John 2.
- I think that perhaps I am thinking about Christianity all wrong. Christianity is about sin. It’s about being saved from sin. And I have always interpreted it as merely a religion which follows the teachings of the BIble. Christians can be Christians without knowing the Bible. They can be saved without adequate knowledge in the word. What is a Christian then? It’s someone who has just been called by God to be cleansed of their sins. It’s someone who acknowledges they are a sinner, and has the son of God advocate on their behalf so that they can be called children of God. Then, does everything else in the Bible matter at all? Of course to an extent, but perhaps it is not that important to be called a Christian… right? Well anyways, I am grateful for this realization which I think is going to help me a lot in my spiritual growth with Christ.
1/22/24
- Going on the retreatttt! Today we got on the bus and headed towards the retreat center and played lots of games, heard messages, ate dinner, and got to spend a lot of time with the people around us so that was pretty nice 🙂
- We got to have lunch with Bryan, Andrew and Kevin today and saw them for the first time in quite a while so that was quite excitingg! And then we had dinner with some people as well. And then during the bus ride towards the retreat center, they made us talk with each other so I got to catch up with lots of peopleee < 3 I like people
- We played volley ball for the first time in a while today and dudeee that was super exciting and fun and enjoyable and I really think that I want to continue learning how to play more. I get why Jaemin likes volleyball over us now.
1/21/24
- Happy Sunday Jonathan! Honestly we had a really really relaxing and pretty okay day today. We didn’t do much; we woke up and did laundry, showered, cleaned a bit, ate a bit, then worked a bit, before coming back to our dorm and then napping for a bit, and then calling umma for a bit, and then wasting time for the rest of the time a bit.
- We are back on campus which means that we can officially start doing work now! We don’t have the excuse to be lazy because we are no longer at home anymore so I am grateful that I am here, at Princeton, and I AM READY TO TAKE THIS SUCKER ONNNN
- We got to see Richard today at the library and so that was quite nice! And then we called umma and appa and told them all about the David Network conference so yay for that too. We called them for about an hourrr.
1/20/24
- I had a very very fun and super enjoyable day today so I am very very grateful and happy about that. We woke up, and then we packed up, went to the David Network conference thingy, heard from lots of speakers, had some good breakfast with DJ Nordquist (head of the world bank), then we got to see cool speakers like Mike Pence, more panels, lunch with a Rabbi, more panels, explored the Museum a bit, had some interesting conversations with people about pro-life and religion, and then we got chic fila and had a very very interesting conversation with Bethany on the way back to Princeton where we ate more chic fil-a.
- WE HAD 4 CHIC-FILA SANDWICHES. If that is not something to be grateful for, Idk what is. And also the rest of the food that we ate today was also pretty fire fire fire. We got to eat SO MUCH YUMMY STUFF >> And then we learned so much when we were talking with people there and having some interesting debates.
- I am very very grateful for this opportunity to have been able to go to DC and be able to see all of the monuments and talk to all of the people here and listen to the conservative movement that they are trying to accomplish here. It was very very informative and honestly I do think that I am leaning more and more towards pro-life now. Obviously I am not full fledged pro-life in all circumstances, but I learned a lot that pushed me a little bit towards that direction. And also meeting and talking with so many diverse people from different backgrounds gave us so much more insight and knowledge so I am super duper grateful for this opportunity.
1/19/24
- Today was an absolutely AWESOME day full of so many new experiences I am very very grateful to be able to be here at this conference 🙂 We woke up at like 7 in the morning, got breakfast, and then we walked around DC for a bit before heading over to the Museum of the Bible to have our introductory meeting to the David Conference, and then we left for a march, and then we got to tour all of the main memorials in DC before we headed back to the Bible Museum and then saw all of the super duper cool Bible stuff, and then we headed back to the dorm and got ready for dinner and then ate at the social, and then we headed back to the hotel and got a work out in before we got ready for bed to go to sleep 🙂 Was a very busy but very packed and honestly really fun day today
- We got to talk with a lot of the Princeton people here so that was really really nice! We didn’t talk to many of the people from other schools as we don’t really have the opportunity to see them as much later, but I am still grateful that I am able to meet people from all over the country at the Ivy league schools all here so that was enjoyableee. And then I need to mention that the Bible Museum was SO SO COOL OMG OMG OMG. Like it’s 30 dollars to enter normally, but we got to get in FOR FREE so how sick is that, and there is a reason that it is so expensive to enter the museum, and that’s because it is quite possibly the coolest thing to ever exist on this planet earth we should really really go here sometime with our family
- We got a LOT of exercise in today… like 31,000 steps throughout the entire day, as well as getting a chest day in at the gym so that is something to be grateful for. And there was also LOTS of food that we ate today so yum yum yum for that. I am happy to be here in DC, thanks God!
1/18/24
- We had a very enjoyable day today and honestly it was not completely unproductive! We woke up and then went to go pack for Princeton, and then we went to Princeton and umma/appa bought us some Korean food, and then we wasted a bit of time before heading for DC, and then we made it to DC safe and sound and everything went very very smoothly so we are happy 🙂
- Umma and Appa showed us that they loved us by just stopping driving and then buying me Korean food and bread on the way to Princeton < 3 Bro I just said, “I want bread” and then immediately they pulled over and bought bread. They are amazing and I love my umma and appa and I am going to miss my umma and appa. And then also I was able to find my wallet today despite losing it for a little bit so I am grateful about that.
- We got to ride on the bus to DC and we talked to a lot of people back at Princeton so that was pretty enjoyable! Very very nice that I get to quickly reconnect with everybody and say hellooooo. And then also we had a pretty interesting conversation with Bethany on the roadtrip to DC and it was also quite the treat to figure out that she is coming on this trip with us! And then we also saw people from Arumdaun…? interesting!
1/17/24
- We had a pretty good day today so I am happy about that 🙂 We woke up and then we went to Woodside with umma and appa and then got yummy food at the pho place and then we sent a lot of emails and did a lot of work throughout the day at woodside before getting halal for dinner, and then we went to Lincoln Center to watch Madam Butterfly with umma and appa which was a super duper cool opera
- We got to spend so so much time with umma and appa throughout this break I am so so happy that I was able to enjoy this break with them. I love my umma and appa. They are the bestest umma and appa in the entire world. And they bought us yummy food and wanted to spend time with us and I LOVE MY UMMA AND APPA. I am super duper grateful for them in my life and them being my number one supporters.
- We got to somewhat figure out what was happening with our transfer course application, got to apply for the refund with KLM, and sort of made progress on the FSU application which is all decently productive. But none of them are complete or anywhere near done soooo yeah. nonetheless I am grateful that I got to work on those 3.
1/16/24
- Very very unproductive and lazy day today, very very full of rest day today. We got to get SO MUCH SLEEP today so I am very very grateful for that and happy that we are able to enjoy ourselves
- We woke up early to help appa and umma shovel snow in front of her office which I think we were honestly pretty productive and it was a good workout (ish) so I am grateful for that! And the fact that it was snowing today was an added bonus
- We got to finish band of brothers today soooo YAY. Now we are all done with all of the “leisure” that we wanted to do this break so we will go back to school fully recharged. We also got to have a discipleship meeting with Soonho today
1/15/24
- We got to go shopping with umma and Joey in the morning today! We got to return our sweater and get a new one so that was niceee. And then umma also bought us some chic-fila SO YUM YUM YUM and much protein was in that so I am very very happy about that
- We took a FIRE nap afterwards and it was so so amazing. And then we also got to eat some kimbap and other yummy food that umma made so I is happy.
- Bro every day is just so full of rest and relaxation I am very very glad to be at home and to be able to enjoy life here.
1/14/24
- Happy Sunday Jonathannn! So today, we woke up and then we went to church, and then ate a little and played some undertale before taking a FAT nap, woke up, ate again, and then we literally went back to sleep somehow after like a 3 hour nap LOL
- We got to see BABIES at church today… ACTUAL BABIESSS. I love love love babies. I want a baby. I want babies. OMG WHY IS SHE SO CUTE.
- We got to eat some samgyupsal today as well as talk with Soogomo/Uncle cause they came over so that was niceee.
1/13/24
- CITY TRIP DAY TODAY! We went to the city with umma, appa and Joey and went shopping for a little bit at like Uniqlo and then we also got to go and see the Rockefeller tree; and then we also ate some Vietnamese food which was SO FIRE dude SO FIRE and then we had shake shack burger, and then we had chajjangmyun and so we ate so good today 🙂
- We got to spend lots and lots of time with umma and appa today so honestly I am very very grateful for these opportunities to just spend time with them and enjoy life with them! I LOVE MY UMMA AND APPA. THEY ARE THE BESTEST UMMA AND APPA. AND I AM SO GRATEFUL FOR MY UMMA AND APPA.
- We saw Joshy today after we came back home from the cityyy. And then umma also gave us the Great Divorce to be able to read so that’s cool toooo.
1/12/24
- Hihi! So today we went with umma and appa to a Holocaust Museum which was honestly really interesting and quite sad because…. self explanatory reasons. But I had a really really interesting time there and it was enjoyable; especially since there was umma and appa there! And then we also went to Mad for Chicken and then after that we went to the Basic Revival!
- We got to see all of our little kiddos at the Basic Revival and so IT WAS SO CUTEEE! I love seeing all of the children serving and worshipping together. And then we also got to see Mr. Chae and Jen and all of our old advisors. And all of the Basic officers are so dedicated and devoted and UGH I LOVE BASIC.
- There was LOTS and LOTS of food to be had today. All very very yummy food. We got to eat pizza and sushi and coke and FOOD THAT WAS TASTYYY
1/10/24
- We went to Columbia with umma today in the morning and then we went to this steak house restaurant which was very very enjoyableee. And then we explored the city for a bit with appa afterwards! STEAK WAS YUM AND SO WAS THE MAC AND CHEESEEE
- We got to see a lot of what umma does at Columbia and I WANNA DO THAT TOOOOOOO. But it is gonna take a lot of hard work and dedication so honestly I am getting more and more prepared to do that.
- Appa showed us a lot of the city today and pointed out a bunch of brands that we never ever even heard of before. And then we also got a haircut with him which is something that we’ve been meaning to get for a while now. MY PARENTS ARE SO GOOD.
1/9/24
- Today was a pretty lazy but honestly a pretty good day. We woke up at likeee 12:30 and then we got lunch with umma and then we watched a movie and worked out at JCC, and then we finished the night with just doing random other work
- We got to get sushi with umma and hear a bit about friends so that was nice to be able to spend some time with her
- Appa came with us to workout at JCC today which was quite funny seeing him workout lolol
1/8/24
- We literally did absolutely NOTHING of substance today so that was excitingg. We woke up, ate, watched a movie, and then went back to sleep, drove Joey to dermatology, and then literally just stayed at home and attempted to do work like look at naviance, look at Farmingdale classes, and tried to get a refund from KLM but got ghosted.
- We honestly had a lot of fun just bumming out today. Bumming out is absolutely amazing. And then we watched the first purge movie today and then another Korean movie.
- We got to do a back and bi day IN THE HOUSE since we have a pullup bar and dumbbells which allow us to workout in the comfort of our own home and honestly it was a pretty fire workout.
1/7/24
- Happy Sunday! Today was honestly a lot of funn. We woke up and then we went to church, and then we got hot pot with Jasmin, Joyce, Erin, and Millie, and then we got to see babies, and then we went bowling with Andrew, Daniel, their roommates, and Brendon which was honestly pretty fun as well and it was nice being able to catch up with all of them.
- We got to get 2 rides from Brendon and catch up with him about how life is goinggg so that was pretty fun. And then we also got to realize that we are not absolutely awful at bowling if we actually tried.
- Jasmin was super nice to invite us to hotpot today so I am honestly very very grateful for that. It was very very nice of them.
1/6/24
- Happy Saturday Jonathannn! We did absolutely nothing of substance as per usual so that is nice as always. We got to spend some time with Josh and Jae today so that was pretty fun, and then we also got some free Starbucks from Melvin which I am pretty grateful about.
- We got to get a LITTLE bit of work done at Starbucks and then we played poker with Josh and Jae for a large majority of the night which was honestly pretty funnn. We also got to watch passion of the Christ which was… interesting.
- Lots of fun conversations were had today so I am grateful for friends and the ability to talk with other people
1/5/24
- Soonho showed us the new years journal thingy of Jonathan Edwards which was really really neat to take a read of. I liked what he said a lotttt. And I am honestly going to try and incorporate that into my life.
- We got to write a blog post about our thoughts on Christianity and what the problems that we think are in it so I am proud of us for sharing our thoughts with the world and not backing down from what we honestly think. I know it might receive some ill-responses, but I think that it is worth it to share our mind.
- We got to see Eva and Sophia at the library today and we waved to them for a brief moment! They did not come over to say hi however….
1/4/24
- We had a really really lazy day today but honestly it is okay since lazy days are the bestest days. We woke up early, wrote the message, and then went back to sleep until 12, then we watched 2 movies and tried playing a bit of CS2 before heading over to church, and then we came back and then just bummed out for the rest of the day in our bed.
- We got to see all of the other college kids at church today which was honestly quite the treat! it’s nice that we are all able to get reunited through church because school is outtt. Church honestly does offer a pretty tight community and I think that is something that people should not be giving up so easily. Anyways, it was a fun time and we got to play badminton with Josh
- We got SO MUCH rest and relaxation it is absolutely amazing. I love when I’m able to not be stressed out about school and life and work and such so I hope that this trend continues throughout the rest of break 🙂
1/3/24
- We woke up at like…7:30am today so that we could go with umma to LIJ and then observe some of the cleft pallet patients which was honestly pretty interesting… And then we went to Woodside to watch umma do lots of other thingies in real time which was pretty cool as well. And then we came home, rested up, and went straight to sleep which was honestly very very relaxing.
- We got to see all of ummas co-workers and honestly Orthodontics seems really cool and I think this is something that we would genuinely have a good time enjoying so long as we are able to make it that far sooooo LET’S TRY OUR BEST. I think it solidified my enjoyment of dental.
- We got to eat Halal AND japanese food today since we went to umma to woodside and then appa taught us a lot about taxes and such so that was pretty informative as well. We are learning a lottt.
1/2/24
- Today was honestly a pretty good and decently productive day. We woke up at like… 10ish, and then we went to the library to do some work, and then we went to get lunch at Chipotle, went to CVS to try and pick up Joey medicine, read a bit at French workshop, and then we drove Joey to his dermatologist appointment, went to the gym with Josh, and then picked up Jae and went to Broadway mall with them and then also played poker/watched movies for a whileee
- We got to work out for the first time in an actual gym in FOREVER so honestly that was a really really good workout. I’m glad that our first day back in the gym was a chest/shoulder/tri dayy
- Today was pretty much a perfect day. We did literally everything that we genuinely enjoy doing if we have the time and if we have nothing else to do so I am happy that the start of 2024 can be a day like thattt.
1/1/24
- This is going to be so hard to write the dates all as 24 now, BUT HAPPY NEW YEARS JONATHAN!! Congrats on making it an entire yearrr. We are grateful for the entirety of 2023, and we really really hope that God will continue to work in us and change us little by little every day.
- We woke up and then we went to Appa’s Halabogi’s house to do some sebe, and then we went to H-mart and got some food, ate at home, watched some TV before going to sleep, and then we bummed out a bit, applied for this summer camp thingy, and then played minecraft until we went to sleep so honestly a very very relaxing and fun day 🙂
- We got to eat SO MUCH YUM FOOD TODAY so I really really enjoyed that! We got to eat kimbap and odang and a bunch of tteukmandoo guk for new years so that is all something to be grateful about.
12/31/23
- HAPPY NEW YEARS EVEEEE. We had a pretty good day at home today so I am super duper grateful and happy about that 🙂 We woke up and then we went to church, and then Fireside, then some movies/laundry, and then the most FIRE nap ever, then back to church for New years eve service
- We got to see many many church friends today which was quite nice 🙂 We got to talk to Matt, Sam, Jongwon, Josh, Anita, etc etc. MANY MANY FRIENDS SO I AM SUPER DUPER GRATEFUL ABOUT SEEING THEM ALL BEFORE WE GO BACK TO COLLEGE
- Bro the nap today was FIREEEE. Like absolutely amazing I loved it so so much. And then we also got to have some pretty good food today which appa made for us which was really nice as well!
12/30/23
- Driving. Driving. Driving. I am grateful that we are safe and back at home now. But 13 hours of driving in a single day. Driving. Driving. Driving.
- We got to eat at Crack and barrel which I am kinda thankful for…? But lowkey was getting very much sick of that food. But then there was dinner at chic-fil-a and DUDEEE that was fire.
- We spent SO much time on our phone I think our eyes are going to pop out. But at least we got SO sick of tik tok, instagram, plants vs. zombies, clash royale, youtube, and every other possible dopamine giver that we can spend the rest of the break without using those types of apps.
12/29/23
- It was time to start driving back…. So we drove back to Georgia and spent the night at Halmony’s house. That is basically the entire story there. Dude…. SO MUCH DRIVING.
- We got to eat at Waffle House for breakfast so that was honestly really really yummy, and then for dinner we went to this Korean nangmyun place and I got galbi tang and DUDE IT TASTES SOOOO GOOD 🙂 I LOVED IT. And then umma bought us a smoothie and everything was happy again.
- We got Joshy and Joey to watch El camino and get on some breaking bad action which I honestly was pretty excited about because I LOVE breaking bad.
12/28/23
- We woke up super duper late today (like 12ish) because we were watching cars all night, and then Halbogi was kind enough to pick us up so that was super duper convenient. And then we got to have a conversation with Halabogi one on one in Korean on the way there so go us!
- We went to this super duper aesthetic mall/outlet thingy that was outside and had all of the Christmas decorations up which was really really pretty. And then we had the entire family there and basically just went shopping with all of them.
- We got to go fishing for a very very brief time with all of the guysss. It was cold. But they caught 2 squids which we ate for a bit and that was honestly pretty good. And then we also got to have conversations with Uncle Bryan and Ronnie Immo so it’s nice to be able to catch up with the entire family.
12/27/23
- Today was the first “real” day in Florida anddd honestly it was not that bad. We got to see miso a lot today which was quite fun and HE’S THE MOST ADORABLE DOGGO EVER TO EXIST. We also ate breakfast with Robert today and he is a pretty cool dudeee. Easy to get along with.
- We got to just hang out with a lot of the guys todayy; we went to the beach for a photo, then this airforce museum, and then attempted fishing; overall we just spent time with the familyyy.
- The night was pretty fun. We spent the entirety of it watching both cars movies…. BUT I HONESTLY REALLY LIKE THE CARS MOVIES.
12/26/23
- Today was spent driving to Florida. Nothing more to say about that… ENTIRE DAY IN THE CAR. But we are grateful for safe travels and the fact that we were able to get to our destination safetly
- We got to see EVERYBODY in the family today so that was quite nice. It’s been such a long time since everybody gathered together in one place so I enjoyed seeing all of the familiar faces. But there was really no need to travel all the way to Florida to do that LOL. But not complainingggg; it was still super duper nice to see everybody.
- We got to sleep in a room that DIDN’T have appa snoring in it which meant that we got to actually have a somewhat of a decent night’s rest so LOOK AT THAT. And then we got to play poker w the cousins which was a treat in itself. (we didn’t win ofc).
12/25/23
- MERRY CHRISTMAS. Today did not feel like Christmas. But it is still Christmas and for that, we should be more than grateful enough already 🙂
- We got to make it to Halmony’s house today and see Halmony and Halabogi today so that was super duper exciting. And then we basically just chilled at their house for the rest of the entire day watching youtube and playing video games because umma is sick and then everyone else left for Florida lol.
- A lot of people wished up happy happy Christmas so that was quite nice 🙂 And then also we got to see the arumdaun christmas presentation on live stream so that was fun too. But I kinda want a christmas where we get to celebrate it at home with church friends tbhhh
12/24/23
- MERRY CHRISTMAS EVEEEE. We are still on our journey down to Florida and we have made it to Halabogi’s house so that is super duper exciting. I am happy that God provided safe travels all the way down here and we still are all in one peace.
- We got to try waffle house for the first time today and honestly the food was pretty fire. Like the menu was a bit weird and the staff made me feel offput, but the food was absolutely killer so I think that we should honestly go to waffle house more often. Like taste alone is better than any diner that I’ve ever been to. So I’m grateful for the experience of waffle house.
- So umma is unfortunately sick, but I am still grateful that we are on a vacation and able to spend time with her. Even if it’s not the type of time/vacation we hoped to spend, I am happy that I am with my umma. And I hope she feels betterer soon…
12/23/23
- We had our first day of travel today as we trek in our car ride on our way to Florida and honestly, time is passing by much quicker and easier than it was when we were a kid so that is nice. I think it is because we actually have a phone that can keep us entertained for hours on end, but in any case, I am grateful to be able to travel with my familyyy.
- We got to get dinner at cracker and barrell today which was yummy and then lunch today was from the Japanese place and there was chicken, tatsu, and salmon with california rolls so again, SO MUCH YUMMY FOOD
- We got to make it to the first hotel today and appa’s snoring wasn’t absolutely a deal breaker and we were able to get somewhat of a decent night’s rest so that was nice as wellll.
12/22/23
- We had a pretty good day today; especially since we do not have to worry about finals… But we woke up and then picked up our chem exam which was a total horrible show, BUTT IT’S OVER NOW SO WE HAPPY. And then we went to lunch and had a pretty interesting conversation with Daniel, and then we packed, went home, and then watched movie after movie after movie.
- We got to see Ronnie Immo, her kids, and everyone else in the family today so that was quite nice. I enjoy being able to relax at home and see everybodyyy. And APPA CAME TO SAVE US FROM HELL
- We got to eat the BEST FOOD EVER AT HOME TODAY. And when I say the best food ever, I MEAN THE BEST FOOD EVER. Like Chajangmyun, and Chammbbong, and chicken, and lobster, and curry, and such random other food but it was tasty so that is all that matters.
12/21/23
- Today is our FINAL DAY AT PRINCETON SO THAT IS EXCITING. We woke up, lunch, and then guess where we went. I bet you will NEVER ever guess it… Stone. And then after Stone we got some dinner with Kevin, Xuanying, and Jocelyn, and then after that we went to take our Politics final, and then we spent the rest of the night bumming out.
- We honestly got to have a lot of fun at Stone today because it basically only consisted of talking with other people rather than actually studying so that was nice. We were sitting with Stephanie, David, Arak, and a few other people I don’t really know the name of but it was fun
- We are FINISHED WITH OUR FINALS SEASON WHAT WHATTT. Honestly the politics final went decently well and wasn’t too difficult so that was pretty enjoyable.
12/20/23
- We had a day full of… studying as per usual. I HATE STUDYING. But we must do it anyways, We woke up and then we went to grab some lunch, and then we went to Stone to study, and then we went to get some Thai food before eating it and then coming back to Stone… and then we studied a bit more before we went to Maruchi, and then back to Stone… and stone… and stone… and stone.
- We got to sit and talk with Xuanying for a bit of today which was quite enjoyable and fun so I liked that a lot. And then also we got a lot of studying done as well which was quite productive
- The food we had today was pretty gas as it wasn’t from any dining hall (except for breakfast). But yeah we got to eat out a lot so that was nice and enjoyable as well. I WANT TO GO HOME THO.
12/19/23
- Today was honestly pretty chill. We woke up at like 1:30, and then we got lunch, did laundry, and studied a bit for POL before heading over to the library to do some more POL studying, and then we hit the gym, and then we got to study a bit more for POL and then got Maruchi and late meal and such so nothing to complain about throughout the day.
- We got a TON of sleep so we were very very well rested throughout the entire day. And also we got to hit a back and bi day for the first time in quite a while which was a treat.
- Also we got to see lots and lots of friends in Stone thoughout the day so it’s nice to see that I am not suffering alone and that we are all suffering together. 🙂
12/18/23
- We honestly had a pretty okay day today so I know that I complain a lot, but there’s not much that I should be complaining about. We woke up and then we studied a bit before taking our orgo exam, and then we took the orgo exam, and then we headed back to our dorm and took a FAT nap before heading over to get late meal, and then we went to the library, then we went to the gym, got dinner, then watched a few movies before late meal #2 and then library again.
- We got to finish our stupid orgo test and even though it didn’t go exactly that great, it is over now, we are finished with all of our stress, and we can survive okay. Also it’s finally time to relax and rest a little bit which was quite enjoyable.
- We got to go to the gym and do a good chest/shoulders/tri day today which was good good good. It has been such a long time since we’ve been able to do a gym day so I am happy that we finally have time and less stress where we can focus on thingies like our health.
12/17/23
- Dude we are hanging on by a THREAD. And this thread is about to snap… But I am still grateful for everyone who is willing to smile and laugh and be with us throughout these horrendous times… Anyways, we woke up, and then we got lunch before heading to Stone to study some bio, and then we got tacoria, and then we took a nap, woke up, studied for bio and then took bio, and then we went to wawa and studio 34 to eat some, and then we took a bit of a rest before we spent the rest of the night studying for orgo.
- We got to see lots of people today and the fact that everyone is still managing to smile and be happy is amazing to me.. I AM NOT THO. I AM DYING. But still grateful that we have people who are still happi.
- We got to study with April for a bit today and then talk with Esther for a little bit as well, and then we also got to talk with Zehao a little after the test which was quite nice. BUT THERE’S MUCH WORK TO BE DONEEEE.
12/16/23
- Today was restful, study filled and all around I want to die and go home I don’t want to do work anymore. But I guess this is how we are supposed to feel around these timesss. We woke up and thennn went to Stone after getting lunch, then we got some food from tacoria before continuing studying, and then we went to office hours for chem, and then it was dinner before we took a nap, and thennnn back to studying. I want to die at this point. But there’s still much to be grateful about likeee…. idk.
- We got to learn a lot at the chem office hours today which was quite nice. He was a really really good teacher and lowkey jacked. I feel like all of the chem majors just have their lives and priorities so together and they are so smart I want to be just like them, but then also I am struggling so it’ll be ugly trying to get to their level. Anyways, we will do our best.
- We received the quizlet from Zehao to study some of the EEB thingies which was very very kind of him to do. And then also we slept like a baby 🙂 Sleep is important.
12/15/23
- Twas a very very filled day with lots of work and studying and exploring and such so it was interesting. We woke up at like 7am to go to the shadowing thingy and we honestly learned a lot and had a really great time, and then we also after that went to Frist, got late meal, then worked in the library until it was time to go to…. Manna secret santa with the sophomores, and then dinner and then back to Stone to study more for orgo, and then we went to studio 34 and then just worked in butler basement until sleep time.
- We got to get a car light for the secret santa thingy which was super duper funny and honestly quite nice! I appreciate being able to have secret santas like that even though we are all super duper busy with life and such…
- We got lots and lots of studying done today even though we are going a little bit crazy… Also there was the dean’s date celebration so we got a free mug and a picture with Xuanying so that was fun fun
12/14/23
- Even though today was much less productive in terms of work, it was productive in other ways. We woke up after taking a BUNCH of sleep and rest, and then we started our laundry, got lunch, finished our Christmas card, folded our laundry, went to the library to kill some work, then went to dinner at SC house, and then we went back to our dorm to do some more light studying.
- We had SO MUCH REST it was absolutely amazing < 3. We got to wake up at like 12:30 so that was very very nice, and then we also got to spend a lot of time making a Christmas card which was a very very nice throwback to happier times when we weren’t dying of stress and work. And then we also got to watch lots of NonStampCollector which was quite interesting
- We got to have a FIRE dinner today. And when I say fire, I MEAN FIRE. it was the BESTEST food EVER. Like ever ever ever. We got to go to SC house and from there we got to have some fun conversations with all of the Manna guys so that is something to be grateful about.
12/13/23
- We had a pretty productive and enjoyable day today so I am happy that we are still keeping afloat throughout these finals period. We woke up and then we finished the final touches on our english paper, and then we headed to lunch after taking a shower, and then we went to the library to go through some bio notes and practice before we headed back to our dorm for a supposed prayer meeting that didn’t end up happening; however, we did manage to submit our english paper and eat dinner within that time, and then after we took a FIRE nap, we headed back to stone and then just studied orgo until we went back to our dorm and slept
- There was SO SO much good food to be had at the D hall today so that was quite nice. There’s this lomein that they make for you on the stop which was super duper amazing and great and happy and so I really much enjoyed that a lot 🙂
- We are honestly really really proud of our english paper. I think that is quite possibly the best paper that I have ever written in my life; I think that this was quite the way to finish one of our favorite classes here. ANYWAYS, grateful for that.
12/12/23
- I would say today was very very productive and not only that, but extremely restful as well! So I am very very happy about that. We woke up and then we had our call with the person who wants us to go to the DC trip (which we probably will do), and then we took a shower and headed to do some work on our english essay, and then we went to do prayer booth, and then we did some work in the library before going to office hours, and then back to the library until we eventually got hungry and then we went to dinner, and then we went back to the library for a little bit before heading over to the gym, getting some more late meal, and then finishing off the night with sleeping at literally 9.
- We got to have dinner with Grace and Stephanie today which was quite nice! And then we also got to study with them for a while as well which I very much enjoyed 🙂 And then also we got to see Grace’s dorm! Cute cute cute
- We got to do prayer booth today which was quite an interesting and very very cute idea. We were taking prayer requests and praying for the people in Frist who happened to walk by so that was nice of prayer team to set up and everything. And then we also got to work a LOTTT on the english essay 🙂
12/11/23
- We had a very very productive day today so go go us! We woke up and then we went to our Pre-dental funding meeting and then we ordered the playa bowls, and then we went to Firestone and knocked out the politics paper, and then we went to knock out the EEB museum lab report before heading to pick up playa and then also going to the pre-dental study break, and then we went back to stone for a little bit before we went to the PiK reunion which was super duper fun, and then we went back to stone to start an English essay and we got our idea down which was very very productive!
- We got to have a FIRE food today! Twas a super duper good pik meal and then we also got to get some maruchi which was SO YUM AS WELL. I love sushi omg omg omg omg. And then there was also late meal to be had todayyy.
- We got to see all of the PiK people which was pretty nice. And then we also got to have a productive study break (in terms of everything for the most part worked out smoothly for our study break so that is good good). And our carving materials came in time so yayayayyay.
12/10/23
- We had a decently productive and pretty restful day so I am pretty happy about that! We woke up and then we went to church, and then we came back and got lunch, and then we took a FAT nap before waking up, grabbing some PPDA thingies and AASA merch, and then we went to Firestone and just did a bunch of work before dinner, and then went back to Stone and just did more work until we went to sleep.
- We got to have lunch with Brian, Nathan, Bryan, and Stella and it was honestly a really fun lunch and the food was absolutely FIRE. And then for dinner, we got to eat with Jocelyn, Kevin and Joie and that was also pretty fun as well. THERE WAS SO SO MUCH PROTEIN AND I LIKE PROTEIN.
- We got to get a lot of work done today; we finished the majority of the museum lab and then we also finished the other bio assignment about spider evolution and thingies so that was nice that we are able to get a lot of work out of the way. ANYWAYS, WE GOTTA GET BACK ON THIS GRINDDD.
12/9/23
- I enjoyed today even though we did absolutely nothing of productivity. We woke up at like 8:30 and then we helped Payge with her film assignment, and then we bought a secret santa present before heading over to do praise team, got dinner with Praise team, and then went to large group and then just finished off the night with calling umma before going to sleep
- It was honestly really really fun being able to record the video with Tim, Payge and Calvin today that was quite enjoyable and really funny. There were many many laughs to be had and it was overall a super duper great study break (even though we really should be “studying” for a study break to actually occur).
- Manna large group today was such a blessing since there were so so many frosh who were willing to help out and move praise equipment and sing and it was so amazing just seeing how willing they are to serve. Also we got to have lunch with Payge, Tim, and Calvin and then we also got dinner with the praise team so both of those meals were really really quite a blessing as well!
12/8/23
- TODAY WAS A GOOD DAY. We woke up and then we went to Kevin’s birthday lunch, and then we headed back and read a chapter of the Reason for God before our discipleship meeting with Soonho, and then we headed to the gym with Marvin, got dinner with him, and then we took a FAT nap before waking up and then doing a bit of work before heading back to sleep
- We got to get off Princeton’s campus today which was super duper quite nice. I love being able to see normal civilization and not just gothic architecture everywhere and just being bounded to this school. WE GOT TO LIKE EXPLORE MALLS AND STUFF. and then the food was also quite killer. HOT POT HITS SO HARD
- We got to hit a really really good chest day today so I am happy about that. And then dinner with Marvin was also a treat as well and we learned a lot during the Soonho meeting cause he is just such a well versed and knows his Bible super duper well so I am grateful that we have him.
12/7/23
- We woke up and then we went to our POL precept where she gave us cookiesss, and then we went to our chem lecture where we got even MORE cookiessss, and then we headed for lunch with Payge and Tim and Kat and then we went to chem lab for check out, FINISHED THAT STUPIDLY HARD LAB REPORT, and then we also took a FAT nap.
- We got to hit the gym today which was quite enjoyable. It was a back and bi day and WE KILLED OUR LATS. Bro I’m still sore…. Anyways, it was pretty good
- We got to grab late meal with Daniel today and we are taking SML and CHM next semester with him which is quite quite exciting 🙂 And then we also got to watch Thor late at night which is honestly a really really fire movie. Kinda underrated
12/6/23
- We did nothing really of substance today other than showing up for all of our classes (except for bio.. but bio is kinda a lost cause now). We woke up and then we went to our POL lecture and then got our booked signed by Prof Bass, and then we went to Peter Singer’s last lecture and then we got our book signed by him and also got to take a picture with him, and then we got lunch, and then we went to our english lecture for the last time and payed attention since it was about Revelation, and then we bummed out in our dorm before going to prayer meeting, grabbing dinner, and then going to the last chem precept (SO MANY LASTS).
- We got to see Sophia today at prayer meeting which was a treat! She hasn’t been back in so so long so it was really nice seeing that she is doing alive and healthy
- Just more and more movies tonight so I love the fact that we are being able to rest. BUT ALSO WE GOT TO SEE PETER SINGER TODAY WHICH IS SO COOL
12/5/23
- We had SUCH a lazy day today.. We woke up and then we went to our chem lecture after going to a funding meeting for our pre-dental club thingy, and then we went back to sleep… and then we went to our bio lab, then we got late meal, and then we went back to our dorm and just bummed for the rest of the day without doing much work… But it was nice. We got to see a lot of attack on titan. Sometimes, these days are necessary
- WE GOT SO MUCH FAKE MONEY FROM POKERRRR. And then we also decided to get some dinner with Michael which was quite nice as well
- We got to study with Grace, Rebekah, and Jocelyn towards the end of the day which was fun as well
12/4/23
- We had a pretty good day today and it was quite productive as well! We got that STUPID CHEM MIDTERM DONE AND OVER WITH. So that is something to be proud of ourselves for. We tried our best… hey! It’s okay…. we kinda bombed it, but now we gotta start studying our butts off for that now.
- We got to grab dinner with Lindsay today which was quite nice and enjoyable 🙂 We talked to her a little bit about just life in general so we are looking forward to post-grad life to seeing how everything will pan out. We completely bummed out for the rest of the day though so that was pretty nice 🙂
- We got a ton of studying done for the orgo final… However, we still need to do a ton more so that is…. great 😉 And then we also hit the gym tonight!
12/3/23
- CHEM IS NOT CLICKING AND WE ARE TRYING TO FORCE IT TO CLICK BUT IDT IT’S WORKING. So we woke up and then we went to our debate judge thingy, but then they forfeit so we ended up just doing some work; then we did our laundry, got food, took a nap, then went to our next judge thingy, and then we headed to the library to do work, then went to grab malaysian food, then went to chem office hours, then we went to the gym, then back to the library, then wawa, and then back to the dorm
- We got to have such FIRE food at the Malaysian food event thingy today and there was a lot a lot of fun and ALL OF THE GC MEMBERS WERE THERE NO WAYYY. It was a while since we were all able to reconvene so that is something to be vv grateful about. AND THEN THE FOOD WAS SO SO SO SOSO FIRE AND NONE OF THE THINGS I ATE HAD NUTS SO YASSSS
- We got a lot of studying done so that is something to be happy about 🙂 GO US! BUt then there is much to still learn. AND THEN ALSO OUR CHEM UCA IS SO SWEET IDK HOW SOMEONE THAT SWEET CAN EXIST ON THIS PLANET EARTH.
12/2/23
- We had a very very enjoyable day today; albeit not as… successful as we hoped. Anyways, we woke up and luckily we were not called to judge throughout the entire morning so we got to sleep in. And then we ended up just finishing up an english essay and studying for chem the entire day. But then eventually we got called to judge later at night, and then we watched some aot before going to sleep
- KEVIN SAVED OUR ASS AND GAVE US HIS COMPUTER FOR ONE OF THE JUDGING ROUNDS WHEN THE ROOM WAS LOCKED AND WE DIDN’T HAVE OUR COMPUTER SO THAT WAS AMAZING. I LOVE HIM. Anyways, he is also super duper jacked.
- We got the Arumdaun care package so that was super duper nice of them 🙂 And then also we got to grab dinner with Brian today which was also quite nice! I enjoy being able to grab meals with people. AND THEN THE BEN SHAPIRO vs. ALEX O CONNOR DEBATE IS OUTTT so that is something to watch.
12/1/23
- We had a pretty good day today for a Friday! We got so so much sleep that it was absolutely amazing. And then we woke up, went to get lunch, and then headed over to Firestone to do some work, and then we headed over to ask about how funding works, and then we went to go and work on our English essay for a little bit before heading out and then going to judge for forensics, and then we we went to see all of the Syo kiddos before heading back to our dorm to eat, and then study a little bit more before going to sleep
- We got to see Kara, James, Nathalia, and a bunch of other new syo kiddos and it was super duper nice to be able to see the youngins and see them debate. And then it was also super cute seeing the little kids debate. THEY ARE SO LIL.
- We got to have a lot of fun at the forensics debate today which was quite quite nice. And then we also got to finish the rest of our english essay which was very very productive and good 🙂
11/30/23
- Happy last day of November Jonathan! That is absolutely crazy how we already finished the entire month of December and we literally only have 1 week of school left… Anyways, we had a pretty productive and tiring day so go us! Good job working hard… We woke up and then we did our course selection and got… some of our classes that we wanted? And then we went to POL precept, and then we studied a bit for orgo before going to our manna meal with Isabella and Jill, and then we went to do some work before our chem lab, and then we stayed after chem lab to confirm our answers on our lab report, then we finished our lab report and then headed to our USG funding meeting, and then we got money and then we got dinner with Kulsoom, and then we headed to firestone to just do some work for the rest of the day until we got late meal, and then back to Stone 🙂
- We got to have 2 kinda unexpected meals today so that was quite nice! And Jill is super duper sweet wth and then also Isabella was a joy. And then dinner with Kulsoom was really really nice; she’s honestly such a fun person to talk to I enjoy having conversations with herrr
- We got to get a lot of work and studying done today; and then a lot of extracurricular work done today as well; and then we met a lot of people, talked with a lot of people, and even though we are tired, we pushed through and we are here! We did well. Good on us. Now we should really be studying our ass off for orgo. BUTT we have the debate thingy this weekend so that is something that we should look forward to.
11/29/23
- Today was a pretty good and pretty productive day today so we are grateful about that! We woke up and then we went to POL lecture, and then we went to Firestone to just study chem, and then eventually we went to English lecture, then late meal, then back to Stone to do some more work, and then we went to prayer meeting, then we went to Korean language table, and then we went to chem precept, then late meal, and then back to Stone to do some more work before we tired out and then headed back to our dorm to call it a day
- We got to see so so many people today so I am very very happy that we are able to see that many people 🙂 We saw Brian, James, David, Choi and Kim teacher, Anna, and a BUNCH of other people just randomly throughout the day so that was very very nice that we are able to have fun and enjoy time with our friends while also putting in our best effort to study and do well
- We got to go to Korean language table today and that is such a fun and collaborative space and I LOVE THE TEACHERS SM OMG I WISH THAT I HAD THEM BACK but anyways I am now not in Korean anymore so that is super duper sad… ANYWAYS I LOVE KOREAN DEPARTMENT HERE AND I WILL MISS IT SM
11/28/23
- We had a bit of a less productive day but we learned a lot of valuable lessons that we should be grateful for. And the few lessons are: We should pray if we are unable to fall asleep. Praying is never a waste of time and we should probably do that over the stupid imaginary scenarios you make up in your mind. And the other lesson is that it is better to be tired and fall asleep instantly than to be not tired and waste time rolling around in your bed all day. But anyways, we learned quite valuable lessons about when we should and should not nap LOL
- We got to have dinner with Chris’s chemistry major roommate Sam and we learned a lottt about the chemistry department and got to get a bit more insight on how we should prepare ourselves for the future that is coming. But yeah I think we are pretty set on being a chemistry major. And we also always have to keep a attitude of gratitude and remember that it is such a honor and a privilege to be able to call ourselves a Princeton Tiger. It’s a PRIVILEGE to be able to study chemistry and when it gets hard, just remember that there are people who are dying to be in the school you are at right now. We are here to WORK.
- We got to get some decent amount of work done today so that is good. We finished the bio lab report that is due in a week and then we also got to do a bit more of chem studying for the test that is coming up next Monday so there is a lot of studying that still needs to get done, but we are grateful that we are still in this race and haven’t died out yet 🙂
11/27/23
- Today was a very very productive day and full of rest so that is something to be grateful for. We woke up and then we went straight to the library to do some work, and then continued working all the way up until we went to English lecture and precept, and then we went back to the library to do some more work, once we got sick of work we hit the gym, then dinner, and then we went to James’ birthday surpirse thing, and then we went to the all ST meeting, and then we went to late meal and had a very very random conversation with Xuanying, Michael and Oleg, and then we went back to the library to do work until we got tired, then we got wawa, and then we went to sleep.
- We had a lot of fun at James’ birthday surprise thing so that was quite enjoyable! And then we got to have dinner with Bryan and then talk with Grace for a little bit on the way to the birthday surprise thing so all of that are something to be grateful for as well.
- We got a lot of work done so that is something to be proud about. We finished the stupid bio lab report that took forever but I am happy that it is done and over with now. And then we also got to have a very very interesting conversation about babies, homosexuality, and abortion with Xuanying, Michael, and Oleg that lasted like 2 hours so that was pretty cool too
11/26/23
- Today was a good day 🙂 We woke up and then we went to church, and then we played some basketball before heading back home, and then we made our Christmas tree before heading back to Princeton, we got dinner along the way, and then we continued on our journey back to school where we cleaned up a bit, and then did some work before going to sleep
- We got to talk with Josh and Jae for a bit today which was quite fun. And there were BABIES. AGAIN. I LOVE SEEING THE LITTLE BABIES. AGAIN. Babies are amazing omg I want a baby. AND THEY ARE SO CUTE. But anyways I am grateful for babies.
- We got to have a pretty fire dinner today at Myongdong Kalguksu so I enjoyed that a lot < 3 And then the care ride back to Princeton with Umma and Appa was pretty fun as well! We have very very supportive parents and a very very blessed family that is super duper amazing.
11/25/23
- We had a pretty fun day today so I am happy about that! We woke up and then we picked up hilda before going back to taking a nap, and then we went back to sleep before waking up and then we went to grab lunch with Michael, and then we got food again with umma and appa and Joshy, and then we came back home and took a nap, woke up, watched a movie after taking a bath, and then finished the night with doing some work
- We had a pretty good lunch and conversation with Michael today and so that was nice! But there were a lot of restaurants that did not work out but honestly it all worked out for the best LOL. And also the food was absolutely amazing.
- We took the FATTEST nap ever and that was amazing. And today is our last night at home so it is good that we are enjoyableee 🙂
11/24/23
- I liked today it was pretty good. We woke up and then we went to our church college lunch thingy, and then we went to the library to do some work before heading to the mall to see if we can do some black friday shopping, then we did our d-ship meeting with Soonho before taking a fat nap, and then spending the rest of the day w Josh and Jae.
- We got to have a free lunch today at Global buffet, and even though the food was not really that good, it was still a free lunch and it was fun being able to see a lot of familiar faces and talk with everybody!
- We got to play poker and burger king with Josh and Jae and just spent like 5 hours hanging out doing nothing so that was honestly pretty fun
11/23/23
- HAPPY THANKSGIVINGGG! This is practically the entire purpose of having a “gratitude” journal: to be able to be thankful for everything LOL. So we woke up, and then helped a little bit with the thanksgiving set up before we actually had thanksgiving meals with the familyyy.
- Mimi immo and her family, halmoni and halabogi, and Soo gomo came over and we had a thanksgiving meal togetherrr. It was pretty fun and tasty. We got to play poker and then we also won a lot a lot of money from poker as well so that was nice LOL. And thennn we had a pretty restful night full of sleep and such
- We got to watch ground hogs day with the entire family which was pretty fun. And then we also watched basically the rest of attack on titan to the point where we remember up to and finally understood the story a lot better so go us! But now after all this rest we should probably get back to work.
11/22/23
- We also basically didn’t do anything of substance today LOL. I honestly don’t even remember what we did today because it was SO unproductive. We picked up Josh towards the end of the day and then hung out with him and Ryan for a little bit and then just wasted time in random ass places which was pretty fun.
- We did a bit of work regarding some email sending and some Penn Medicine work. And then we also got to eat a lot of food today it was absolutely amazing. And when I say a lot of food, I mean A LOT of food. We ate some of Joshy’s friendsgiving food, and then we also ate some food from a Thai restaurant with umma and appa, and then we also just ate everything.
- We got to get dinner with umma appa and Joey so that was quite nice. And then also we figured out that Joey is like less than a year away from beating me in an arm wrestle even though I hit the gym so this is absolutely unacceptable. I need to get that mentality back to not let him do that…
11/21/23
- We woke up and then we went to the library and honestly just got a lot of work done. We also got to text Sora teacher (wickes) for a little bit which was very very nice and then we also got to eat at Mad for Chicken for the first time and it was honestly pretty good. We ate it with umma and then talked with her for a little bit!
- We read like the first 50ish pages of Professor Bass’s book and OMG he is literally the best writer there is. It was so much fun to read and so much knowledge to learn and wowowoowow he is such an amazing writer. And it provides for a really really good study break which was pretty good.
- We got to go shopping with umma for a little bit at the end of the day which was nice. And then we also ate curry with umma and appa at the very very end of the day so I liked that as well!
11/20/23
- We had a pretty good day today so I am happy about that. We woke up and then we went to our course advisor meeting, and then we went to our politics lecture, and then we went to buy his book before heading over to EEB lecture, and then we got lunch with Tim and Payge and then we headed off to our English lecture, then english precept, then bummed out in our room before going to the volunteering advisor fair for Penn Medicine, then we got dinner and then headed home where we watched a movie 🙂
- We got to grab lunch with Tim and Payge and have some pretty interesting and fun conversations which was pretty nice and then we also got to go home and then we saw Eddie on the way home which was a very very big coincidence so we ended up talking with him for a bit of time
- We got to watch a movie before going to bed and we went to sleep like instantly when we hit the pillow so that is something to be grateful abouttt.
11/19/23
- We woke up and then we went to church for our photo with the family, and then we did service and then got breakfast with everybody, and then we went home and took a FAT nap. Like the fattest nap ever. And then we woke up and got to see BABIES. THEY WERE ALL SO LIL. And then we ate, spent more time with the babies, and then we had our lil chemistry meeting with Brianna, and then we left on the train to go back to Princeton and then spent the rest of the night just watching attack on titan.
- We got to see a lot of people at church today so that was quite nice! I like seeing people we know at churchhhh 🙂 We also got to HOLD BABIES THEY ARE SO SMALL AND SO ADORABLE AND SO BABY LIKEEEE. It’s crazy that I don’t get to see babies as often
- We got to watch SO much attack on titan last night and get our entire memory refreshed on the story it was so nice. And then also we got to see a lot of babies today. Did I mention that I got to see babies todayyy.
11/18/23
- Happy Saturdayyy! So we woke up and then we got lunch, and then we headed over to Firestone to do some researching over what to do this summer, and then we went to praise team practice, then we got dinner and then large group, and then we headed home and sleep 🙂
- We had a pretty fun large group today and John gave an absolutely fire message about why we both should and shouldn’t follow Jesus. That was pretty cool. And then we also got to have large group dinner with Michael, Xuanying, and Jocelyn and talk with them for a little bit so that was also pretty nice as welll
- We got to gooooo HOME! WE ARE HOME. And then we are going back tomorrow night but we are home anyways so I am excited about that
11/17/23
- We had a pretty good but unproductive day todayyy. We woke up and then we ate, and then straight to Stone for 5 hours, and then we left to hit the gym, eat dinner, and then we watched the PPE concert, and then we literally bummed out for the rest of the day.
- We got to have a lot of fun at the PPE concert today and played pokemon showdown literally the entire time. So that was honestly very very enjoyable and the music was quite fire as welllll
- We got to grab dinner and go to the gym with Marvin which was really nice. He’s one of the few people that I can just be 100% real with which I really really enjoy. I like not being able to kinda fake how I am around certain people.
11/16/23
- We had a very very unproductive Thursday, but it’s okay Jonathan since break is literally right around the corner and we had a decently productive beginning of the week. We woke up and then we went to POL precept, and then we skipped Chem lecture to eat lunch and take a shower and do laundry and take a nap, and then we woke up and then we went to our chem lab, and then we came back to our dorm after getting some late meal and then we folded our laundry, and then we went to coffee club and waited until the doctor got there, and then we did our pre-dental meeting which turned out quite well, and then we got dinner, and then we went to Firestone and was very very unproductive, and then eventually we headed back to the dorm to go to sleep
- We got to have dinner with Cevina, Kulsoom and Kathleen today so that was quite nice. And then there was the EEB major guy who also skipped chem lecture that we ate lunch with so that was fun as well!
- We got to have a pretty good conversation with the dentist who came in today to speak with everybody and it worked out quite well so I am honestly pretty happy about that event! He was extremely nice and also very very assertive and knows what he wants, but he is a really really good person. I like Dr. Abrams a lot.
11/15/23
- Today was Wednesday; and honestly, it was a pretty good day until we kinda screwed up our productivity at the very end of it. We woke up and then we got breakfast with Grace and Pastor Sam, and then we headed to our POL lecture, and then we went to EEB lecture after getting a coffee, and then we took a FAT nap before heading over to English lecture, and then after that we got late meal and then talked with Michael and Katie for a bit before heading back to our dorm to pick our songs for prayer meeting, and then we went to prayer meeting, and then we went to our Chem precept to do some work before the precept actually started, and then we did the precept, and then we got late meal, and then we headed back to our dorm and just knocked out until 12, and then we just watched thingies on our phone until night time
- Pastor Sam came to visit us and bought us some pancakes so that was quite nice! It was very very yummy too and he is such a sweet pastor so I am very very glad that he came to visit. And then we got to talk with Grace for a little bit as well so that was enjoyable as well 🙂 AND GOOD ON US FOR SHOWING UP TO EEB LECTURE FOR THE FIRST TIME IN FOREVER
- We got to have an extremely relaxing night time because we ended up just watching tik toks and youtube for the entire night so that was nice as well 🙂 I’m happy that I am able to bum out when there’s nothing to dooo
11/14/23
- We had a decently productive day todayyy; we woke up and then we cleaned up a little bit, took our trash out, filled our water jugs, and then we headed out for lunch, and then we came back to the dorm to do some work before heading to lab, and then after lab we went to the library to work on our lab report for chem, got dinner, and then back to the library to do some more work before going to the gym and then going to sleep after getting wawa.
- We got to have dinner with all of the EADs people today so that was quite nice, and then Grace came to sit with us in the library for a little bit as well so that was nice as well! And then we also got to have some fun during lab today cause we were just poking a spider for 45 minutes
- We got to eat some very very yummy food today 🙂 And then we had a pretty good back and bi workout at the gym today. ALSO WE FINISHED THE STUPID CHEM LAB REPORT WHICH MAKES ABSOLUTELY NO SENSE
11/13/23
- We had a very very productive day today so I am pretty proud of myself and grateful about that 🙂 We finished our English exercise assignment, then we finished our bio lab report, and then we finished our Chem rewrite lab report, we researched a bunch of possible summer options, and then we got 2 late meals and 2 dining hall meals and then we also went to the gym so GO US. This was all made possible through…. skipping lecture LOL
- We got to eat some pretty fire lunch today. Like the burgers at late meal always hit SO HARD it was absolutely amazingggg. And then for late meal dinner, we got to eat with Jocelyn, Xuanying, and Brian so that was enjoyable as well 🙂 We downed like 2 coffees today too so go us!
- We got to call Angel for a bit and check our bio lab report answers so that was nice as well. And then we also posted on our Finsta today with a bunch of memories so happy 🙂
11/12/23
- We had a very very fun day in NYC today! We got to go to the AMNH with Tim, Payge and Anne so that was all super duper exciting. We got lunch there and got to see a lot of super cool thingies and took a bunch of pictures too so that was a very very fun field trip.
- We finished our English exercise today soooo good on us for being produtive! And then we also thought a lot a lot about our major and we are leaning more and more towards chemistry…. YOU CAN DO IT JONATHAN. YOU CAN DO CHEM
- We overall just had a lot of fun today so I am grateful for that 🙂 We got lunch and dinner with Payge, Tim, and Anne and it’s so nice cause I can just be myself around them !
11/11/23
- We had our last day at home todayyyy. We woke up and we picked up Hilda, and then we headed home to get a haircut and then we went to the library, then we took a FAT nap, and then we ate dinner and then Soo gomo came over so we talked with them for a little bit, and then we got another haircut from umma’s friend, and then we drove back to Princeton with umma and appa
- We got to have some fun family time today with umma, appa, Josh, joey, soo gomo and uncle. So that was really really nice 🙂 And then we also got to see Halabogi today for a little bit and deliver him some fish. And then also it was just really nice being able to talk with umma and appa on the way to school today
- We got to finish the night with a lot of fun youtube watching and seeing the Last of Us, and we slept pretty quickly today even though there was a lot of studying to be done.
11/10/23
- We woke up and then submitted our politics paper before we headed over to the block party, and there we spent the majority of our day before we ended at around 4 and then we took a FAT nap and then we woke up and then we went to Panera to finish off the day before appa brings us chajangmyun so that is going to be nice 🙂
- We got to have some fun at the block party today and even though it was super duper cold, it was really really nice seeing our neighborhood come toget and seeing all of the young little kids! However, it was a little bit of a shock when we realized how old we are because everybody there is so so young… so what the heck are we doing
- We got to have some… FIRE food today. I think we had like 5 burgers, 2 pizzas, and pasta, and chajangmyun and there was just so much yummy food today that it was absolutely crazy how much I let myself go… SO MANY POTATO CHIPS BUT THEY WERE SO GOOD
11/9/23
- We woke up and then we went to our POL precept before skipping Chem lecture to work on our POL research paper, and then we ate some lunch before grabbing our chem test, and then we did some more work on our POL research paper before we headed to Chem lab, and then after lab we went straight on a train heading home where we grinded out our POL research paper for that entire time and then we went to our officer PPDA meeting before talking with the fam and taking a bath, and then we finished the night with some of the POL research paper 🙂
- We are… HOME I AM GRATEFUL TO BE HOME AND I AM HOME AND HOME IS GOOD SO I AM SUPER DUPER HAPPY.
- We got to finish the majority of our POL research paper today and the only thing that is really left is proofreading and submitting and honestly I am not too upset with our paper… we will at least get a B or B+ so good for us… but perhaps we are not a Politics major if the best writing that we can produce is only a B. But I guess we shall find that out next semester.
11/8/23
- What a hectic past 2 days… we are finishing up our 15 page POL paper and it has been quite the struggle… We woke up and then we went straight to work for an hour grinding out our research paper, and then we went to POL lecture where we then continued to grind out our POL research paper, and then we went to office hours to talk about our POL research paper, and then we headed to grab some lunch at Roma and then we went to the library to grind out some more of our research paper before heading over to our English lecture.. where we grinded out our POL paper, then we headed back to the library to….. grind out some of our POL paper before heading to late meal and then back to the library, and then we went to prayer meeting, and then we got dinner, and then we headed over to our chem precept and then we finished off the night with late meal… and POL 🙂
- We got to have dinner with Bryan, Stephanie, Brian, David, and Grace today after prayer meeting and it was a pretty fun dinner! We got to see everyone when they were young, and then we also spilled a cup of water on Stephanie so that was also fun… But in any case I am grateful for that today
- We got to get a lot of work done for our POL research paper today surprisingly so I am very very proud of us 🙂 GO US
11/7/23
- We had a pretty relaxing day today but honestly we should really be working a bit harder so that we can finish this POL paper and actually make it something that we are proud of haha… We woke up and then we got lunch, and then late meal, and then went to the library and did our pre-lab, and then we attempted to work on the paper a bit before getting distracted, and then a bit of work on the paper got done before we headed to the gym, then got dinner, and then wasted time until Bible study, and then we headed back to our dorm to work on the paper some more and then we went to bed after getting some wawa
- We got to see/talk with Tina for a little bit today so that was super duper nice! She is going to study abroad in Singapore next semester which is SUPERRR cool and I am very very happy for her. And also I think she is doing well 🙂 She is super duper sweet too
- We got to have a pretty interesting Bible study with Pastor Steven today and we did learn a lot which was very very nice. Apparently Jesus was not always Begotten, there is a difference between the Son and Jesus, the Son was with God in the very beginning of creation and that the universe was only created through the son somehow, and then a bunch of other super duper cool Christian information that I enjoy learning about 🙂
11/6/23
- We. are. done. with. the. orgo. exam. and. I. think. that. we. did. okay. 🙂 I’m grateful that the orgo exam is all finished with and that we can leave that exam not feeling too bad about it! Soooo go us I am very very happy
- We got to grab dinner with Lindsay today and quickly catch up with her to see how she is doing and boyyyy she is BUSY; it makes me feel like I’m not half as busy as she is because she is going THROUGH it so hopefully she is able to make it out of this semester alive and well 🙂 ROOTING FOR HER. But grateful that we got to eat with her. And then we also got some late meal with Evelyn and got to walk/talk with her for a little bit so that was enjoyable as well 🙂
- We got to go to the gym FINALLY! At long last… we did a back and bi day and we are definetly going to be hitting chest and tri sometime soon; however, we are in a bit of a pickle since we gotta finish up this research paper pretty soon…
11/5/23
- Good and productive day full of studying and such 🙂 We woke up and then we went to church, and then we came back and had lunch before going to Firestone to do some studying, then LCA to get some of our questions answered, and then we went to study for a bit before grabbing dinner, and then we took a FAT nap before heading over to Firestone to study a bit more, and then we got some food from wawa and then headed back to the dorm where we just finished off the night with some….. you guessed it; STUDYING 🙂
- We got to have lunch with Michael, Xuanying and Nathan today so that was quite nice. And then we also got to have some fun at church today cause Tim came along so we could bully and insult him the entire time 🙂 We also figured out a very very interesting thing about pressure points that only work on people from New York for some reason.
- We got to talk to Julia for a bit during dinner today and then we got to eat with her and Rachel so that was nice! And we also learned a bit about people in general so quite quite nice. We also just talked with a bunch of random orgo tutors today so that was quite nice as well 🙂
11/4/23
- We got to get a lot of sleep tonight because of no classes being today, and then we also had daylights savings tonight so that gave us another hour of sleep for today 🙂 We woke up and then we went to the library to do some studying, we got to eat at olives today which was pretty yum, and then we also got to do praise for Manna which was always nice serving, and then we finished off the day with… AOT!
- THE FINAL EPISODE OF AOT CAME OUT SO THAT WAS ABSOLUTELY FIRE! omg dude the episode was so so fire and we got to watch it in open room with the rest of the Manna people which was pretty enjoyable 🙂 BUTT DUDEEE, the episode was SO FIRE so I am very very happy that I did not get it spoiled by anybody
- We got to have dinner with James, Katie, Por, David, and a bunch of other people at pre-large group dinner. And then at large group itself, we had a very very good message given to us by pastor Ian about the Book of Genesis so I enjoyed that a lot 🙂
11/3/23
- Happy Friday Jonathan! We have no class today so we volunteered to give a high school group of students a tour around campus for Dr. Choi! It was super duper fun and then WE ALSO GOT TO HAVE KOREAN FOOD WHICH WAS GREAT :))) We toured with Marvin, and then we also got to eat lunch with Marvin/Julia, and then we went to POL office hours where she gave us a couple of helpful tools for our politics hw, and then we went to firestone to do some work before grabbing dinner, and then heading over to attempt a practice test for orgo which was honestly not that bad
- We got to have a hoagie at hoagie haven today which was absolutely FIRE. I enjoy being able to eat good food 🙂 and then fact that we got to eat that AND korean food all in the same day was such a treat wowowoow
- We got to call umma today and talk to her about her trip to Rome, and then we also talked a bit about how there was a kid in HBT who got arrested, and Idk why I am mentioning that in this gratitude journal but in the end I am grateful that I have my parents who I can talk to when we are halfway across the world from each other 🙂
11/2/23
- We had a pretty productive day today: we woke up and then went to POL lecture, then did some work on our research paper outline before heading over to grab some lunch, and then we went to Frick to work on some chemistry and lab report before going to lab, and then we just rested for a bit until we went to chill for a bit and decide on some classes for next semester; then we went to dinner for the pre-dental association and met some new people, and then we had our pre-dental association call, and then we went to some orgo UCA office hours, and then we went to the disco ball thingy before going to Firestone to do some work and then we went to wawa to get some food and chill for the rest of the night
- We got to meet a lot of new people at dinner today for the pre-dental association so that was quite nice! And then we also got to have some lunch with Grace which was the first meal that we grabbed with her 🙂
- We had some fun at the disco thingy tonight so I enjoyed that 🙂 And then we also got a LOT of learning done cause we had a one on one session with the UCA and she was very very nice and helpful for learning the material so GO US
11/1/23
- Happy November! First day of the realll fall season. And dude the weather just PLUMMETED to cold. But I am super grateful that I was able to make it November alive in and in one piece. It is literally through only God’s grace that I am here right now; and I learned SO much that I am very very happy to be here right now.
- We got to grab dinner with the Korean language table today so that was nice being able to see everybody! And then we also got to talk with Julia for a little bit and catch up with her so I also really really liked that as well! She is such a fun person to talk to and also SUPER sweet
- We got to get a bunch of work done today at Firestone, and then got an intro to a lot of the questions that were confusing on past tests so that was good. I’m grateful that I have teachers who are truly dedicated to helping me learn LOL.
10/31/23
- We are getting closer and closer to our D DAYS so lets make sure that we are working our hardest and actually learning smth 🙂 We woke up and then we went to our CHM lecture today, and then we got lunch and then yogurt from late meal before heading over to EEB lab, and It was a super duper long lab, and then we went to the library and tried to work a bit on the lab report before heading over to the Peter Singer Whig Clio event thingy, and then we got dinner, and then we went back to Firestone and just did work for the rest of the day.
- We got to have dinner with David and Celestine so that was enjoyable 🙂 I like being able to catch up with people and eat with people and not be all alone…
- We got to see Peter Singer alive and in the flesh for the first time today so that was honestly very very exciting. And then there was also pretty good food today because of Halloween and the weather is getting much much colder so I am happy that I will get to wear baggier fits now.
10/30/23
- A day FULL of sleep. We woke up and then we went to POL lecture, and then EEB lecture, and then we got lunch and then headed to English lecture and then precept, and then we took the FATTEST nap ever before heading over to late meal and getting some sushi and then going to firestone and basically just studying for the rest of the day before getting some wawa and then sleeping 😉
- We got to have lunch with Rachel, Jessica and Angel and even though it was very very loud, it was nice meeting another new person. We got to catch up with all of them and then also it was nice meeting another person from Long Island so that was pretty nice!
- We got to study with a bunch of Manna people at night and then got to eat some very very yummy food tonight from marauchi and wawa so yum yum yum 🙂
10/29/23
- We had a decently productive and very very fun day today so I am very very happy about that. We woke up and then finished our chem lab report and then got some maruchi for lunch, and then we started the research process for our POL paper and then we also got some of the bio lab report and work done 🙂 And then we also got to get dinner with Joie and Kevin and then we went to the Sinfonia concert so I enjoyed all of that
- THEY PLAYED HOW TO TRAIN YOUR DRAGON AT THE SINFONIA CONCERT TODAYY. Bro that was actually magical and had me feeling some sort of ways.. I LOVE HTTYD
- We got to talk and walk a bit with Ashley after the Sinfonia concert today so that was pretty nice 🙂 I like being able to catch up w people 🙂
10/28/23
- We had a pretty average Saturday today BUT WE DID GET TO HAVE 2 CHIPOTLE BURRITOS WHICH WAS VERY VERY YUMMY SO I ENJOYED THAT A LOT. We also got a TON of sleep which was pretty nice 🙂 We woke up at like 2 and then we also did laundry and worked on some papers and lab reports which was good on us. We finished our paper today so that is now officially submitted
- We got to go to Manna Large Group today and do piano for praise as per usual and then we also heard a very very fire message today given by Pastor Bill so that was really really nice. He pretty much spoke about being more moderate and not being super duper far leaning liberal or conservative. Which is honestly a very very good message to give in my opinion
- We got to just have an overall pretty relaxing day today and so I just enjoyed it a lot 🙂 But we should not be relaxing here at Princeton that much we should be getting to WORK and that is what we will be doing
10/27/23
- We are sleeping LOTS and LOTS so I enjoyed Friday today 🙂 We woke up at like noon, and then went to the library and then worked on our English paper and a bit of our lab reports before having a discipleship meeting with Soonho and then heading over to get dinner with Kulsoom, and then we went to do some more work in the library before going to the gym with Marvin and then just playing cards for the rest of the night so that was pretty fun
- We had a very very good conversation with Kulsoom today and potentially majoring in Politics so that was nice! I enjoy being able to ask her about what politics classes to take and such it was very very nice. And then we also got to learn a new card game with Marvin called Cappa which was honestly very very fun as well 🙂
- We got a decent amount of work done today so that is great 🙂 I am happy that we are able to get work done and be somewhat productive this weekend so good for us.
10/26/23
- I enjoyed today a lot so that is good 🙂 We woke up and then we went to our POL precept, and then we studied orgo for a bit before heading over to get lunch, and then we went down to CHM lab, and then afterwards we got our chem lab report checked, and then we headed over to Frist for Xuanying’s birthday surprise, we went to a a restaurant off campus and then came back and then we went to our pre-dental officer meeting, and then we bummed out for the rest of the day
- We had a VERY very good dinner today so I am pretty happy about that. And the food DIDN’T HAVE PEANUTS IN IT so that was very very enjoyable 🙂 I like not having peanuts in my food. And then also lunch was pretty good at roma today.
- We honestly had a pretty good overall day today 🙂 We are stressing out about what to major though however; CHEMISTRY is now on our list of thingies to possibly study?? Omg we really need to figure this out I am super duper curious what I will actually end up majoring in.
10/25/23
- We had a very very… full day today. I wouldn’t call it too productive since there was not a lot of thought going into what we were doing; but we did stuff! We woke up and then we went to POL lecture, and then EEB lecture, and then we got some lunch before heading over to English lecture and then went to office hours to talk about our english paper, and then we took a quick nap before going to prayer meeting and then doing worship there, and then we went to language table, and then we went to chem precept before grabbing late meal, and then wasting time before Xuanying’s surprise
- We honestly had a very very fun time at language table today! We got to see Yong professor and then we got to practice our Korean a little bit which was nice; I don’t want to lose my Korean speaking abilities I worked WAY too hard for this. And then we also got to do worship for prayer meeting today and dude our fingers were burnt OUT by the end of that… We really need to start playing guitar more because my fingers can’t afford to do that every week
- We got to have some donuts and surprise Xuanying at her dorm for her birthday at the end of the day which was very very fun! We were with Michael, Xuanying, Jocelyn, Kith, Boya, Kevin and Joie which was enjoyable 🙂 That was very very fun and also HAPPY BIRTHDAY XUANYING.
10/24/23
- We had a pretty productive day today until the very end of it so I think we had a good day. we woke up and then we skipped our first chem lecture to study for chem… and then we worked on our lab report for a little bit before heading to get lunch, and then we went to bio lab and then finished our lab report before heading to grab late meal, and then we went to Stone and just did work until we got dinner, and then we went back to Stone to do some more work before we got late meal, went to the gym, and then back to Stone to do more work 🙂
- We got to grab dinner with John, Bryan and the other Bryan today so that was quite nice. And then we also got to study with Lindsay for a little bit and then Jocelyn came too so there was lots and lots of people to be seen today so that was fun fun fun
- We got to finally do a back and bi day and it has been such a super long time since we got to do one of those that I really enjoyed it.
10/23/23
- First day back so we are getting back into the grind of Princeton thingsss. We woke up and then we went to our POL lecture, and then we went to EEB lecture, and then we went to get lunch before English lecture and precept, and then we took a FAT nap before heading over to the library and then studying for a bit, and then we got dinner and then went back to the library before heading to open room and then hitting the gym and then staying up the rest of the night just reading random internship thingies
- We got to grab dinner with Stephanie and Monica today so that was quite nice and fun. And then at open room we got to see Brad which was a treat since he is now graduated so I am happy that he came back to visit 🙂
- We had the most FIRE nap today it was absolutely insane. Likeee I don’t know how I slept for THAT long but it was the most amazing nap EVER EVER EVER
10/22/23
- LAST DAY OF BREAK JONATHAN. I am super grateful for this break it was absolutely amazing and so full of rest and friends and sleep and FOOD. THAT WAS AN AMAZING BREAK I AM SO HAPPY TO BE BACK AND READY TO KICK SOME ASS. ALSO WE FIGURED OUT THAT THE ENGLISH PAPER IS PUSHED BACK A WEEK SO THAT IS SOMETHING TO BE GRATEFUL ABOUT
- We got to see a bunch of babies todayyy 🙂 I LOVE BABIES THEY ARE SO CUTE. Maybe I should get a baby. Maybe I should get a baby. Maybe I should get a baby. I LIKE BABIES. I AM HAPPY. I WANT A BABY. I LOVE BABIES. That sounds weird but I promise that I am perfectly normal. But yeah there were a bunch of babies that we got to see at our house today after church which was super duper nice. And then also church today was fun as well since we got to see all of our church chingoos 🙂
- We got to have lunch at SC house with Michael, Kevin, Joie, Boya, Xuanying and Jocelyn today so that was very very enjoyable as well 🙂 The food was honestly very very good and there was many good vibes to be had today
10/21/23
- We had a pretty fun day today so I really enjoyed this fall break Jonathan 🙂 We woke up and then we went to meet up with Marvin in the city, and then we went shopping and touring around in various places like central park and a bunch of different cathedrals before we got all you can eat hot pot, and then we came back home and visited the Syo Carnival where we saw a bunch of youngins hanging out
- We got to see Kara today!! That was really nice she is such a sweet human being I am very much happy to have seen her. And then we also got to see like Mark, Elden, Hailey, Nathan, Anthony, and many many other underclassmen
- We honestly had a very very enjoyable shopping experience today. I am glad that we bought the clothes that we did even though it did cost a lot of money… and then also it was really really nice to get our food in the city as well
10/20/23
- We had a pretty relaxing and decently fun break day today so I enjoyed everything that I did today. We woke up, ate some breakfast before driving over to pick up Jaemin and then heading over to go to Stony to see Josh, and then we got lunch with Josh and chilled out at his dorm before taking a nap, and then going to our discipleship meeting, and then we went to the library and did some “work” before just heading back home and then enjoying some yummy food with the fam
- We got to see Jae today which was quite nice. We haven’t seen him for a while so we got to catch up with him on the car ride here and then also just overall see him throughout today so I enjoyed that much 🙂 And then we also got chic fila with Matt, June, Jae, and their friend so I enjoyed that as well
- We had a really really good conversation with Soonho at our meeting today so that was very very interesting. We talked about a lot of interesting topics like the 3 barriers to faith, and then about hell, what our calling is to talk to nonbelievers, and a lot of other really interesting topics so that was very informative.
10/19/23
- I HAD SO MUCH FUN TODAY AND THERE WAS SO MUCH GOOD FOOD, PEOPLE, AND CONVERSATION I REALLY REALLY ENJOYED TODAY. This may have been one of my favorite days like.. ever. We woke up and then we went to the city and met up with Jocelyn, Xuanying, Michael and Boya and we really had a fun day overall just hanging out with them and we got our steps in for the day and ate such yummy food too so I really am grateful for being able to eat yummy food
- We got to go to the 9-11 memorial which was very interesting as well I love being able to visit new places in the city. And then we also got to go to a board game cafe, a bubble tea shop, BCD tofu house, a dessert place with ice cream, and SO MANY MORE OTHER GOOD FOOD PLACES IT WAS INSANE. And there was just overall so much fun that we had hanging out with other people and eating good food and yummy dessert. We got to get bubble tea for the first time in a while from Tiger sugar and then also there was dessert from the ice cream shop
- We had a lot of really good conversation with everybody today about religion and our viewpoints on political issues and just a bunch of other really random topics as well so that was very very interesting. I love being able to talk with other people and not worry about getting hardcore judged for just sharing viewpoints
10/18/23
- We got to go to the Orthodontics lecture with umma today which was quite the experience. We got to listen to a bunch of doctors talk about different ways to drill screws into people’s mouths… And then we also got to meet so many Orthodontists and Oral surgeons and everybody else which was very very interesting.
- We got to eat some pretty good dessert and food at the oral surgery lecture and there was, as per usual, very very good food at home. We are realizing that appa and umma are really making good food for us when we are at home… I LOVE BEING AT HOME WHY DO I HAVE TO GO BACK TO DINING HALL FOOD EVENTUALLY THAT IS SO UNFAIR
- We got to spend a lot of the day with umma today so that was nice I enjoy being able to spend time with umma. BUT SHE IS SO BUSY. I don’t get how she can just run around from meeting to meeting and be involved in so many different things on top of already working and then she is still just able to function normally I am no where near that level of competence.
10/17/23
- We went to visit Josh today at Stonybrook so honestly that was quite fun. We got to have a pretty lame lunch with him, and then we went to visit Eva at her work place, and then we hung out at Josh’s dorm for a bit before we got dinner with Eva, and then we headed home and got pizza to go to Joshua Hyong’s place
- We are super duper grateful that we actually have friends here to visit 🙂 We got to see Eva’s dorm and meet her roommate and honestly all of that was quite fun. I enjoyed being able to meet new people and also just reconnect with Eva overall since she is such a sweet human being ahhhhh. No getting kidnapped.
- We got to eat Pho and also get a pizza pie and there was halal food and there was overall such good food I was super duper amazed that there was so much good food that we ate today 🙂 But we are really really slacking on the gym so we gotta start getting back on that grind.
10/16/23
- We had a really really relaxing day especially since we spent the entirety of it at home 🙂 We woke up at like 1 and then did laundry and then we went to the library to work, came back to help Joey with some algebra thingies, left to the library and then Panera, and then we took a nap and then went with appa to pick up umma, and then we watched a movie
- We got to see Sabina and some of the other Basic officers at Panera today so that was quite nice being able to catch up with them a little bit.
- We got to see Umma today so that was quite nice! We picked her up at the airport with appa and then we also got to get some work done in the car as well
10/15/23
- We had an extremely tired, but again, an extremely spiritually rejuvenating Sunday today. We woke up and then went to praise team practice before doing the first service, and then we ate lunch, wrote some cards, took a walk, and then went to a time of Testimony sharing, and then we loaded the buses and headed back to campus, and then we rested for a little bit before Halmony, Halabogi, and Appa came, and then we ate dinner with them and got to show them some of my favorite places on campus, and then we drove back home and I knocked out so easily on that car ride home and then we ate some really good food before watching a movie about kids with superpowers…?
- We took like SO many pictures with Halmony and Halabogi today and then when we walked around campus there was so many people that we ended up seeing and talking to so I really enjoyed that too haha. It made it seem that we weren’t completely a loner on campus and showed appa that we actually have some friends. And then we also had the most fire naps on the bus ride and car ride back home.
- We are. HOME. WE ARE HOME WE ARE HOME WE ARE HOME. I am home. And I am happy to be home. I like home. I love home. WE ARE HOME.
10/14/23
- We had our second day of retreat today and even though we were really tired today since we actually didn’t get to sleep too well tonight, it was an EXTREMELY spiritually resting day. We woke up and practiced praise before the first service, and then had small groups before lunch, and then we went to take a group photo before going to a Q and A session with Pastor Bill and then we went to do some more praise practice before grabbing dinner, and then we did service and it was honestly a really great time of spiritual rejuvenation for me personally. I’m actually coming out of that with a little bit a hope that it’s going to be somewhat different this time; and then we had some ramen and then class sharing so everything today was honestly just really a blessing
- We got to have a really great time at Q and A today; like honestly Pastor Bill is such a well-versed and intelligent individual that I am really glad that he was the speaker for this retreat. Like there’s just so so much to learn from him. But yeah we got a lot of our questions regarding the immoralities seen throughout the Old Testament answered. Moses doesn’t actually sacrifice 32 virgins, Jephthah isn’t someone to look up to, not everyone was killed in the genocides led by the Isrealities, and all of the cases in the Old testament should really be taken by a case by case basis. But there is no clear-cut answer that is going to get rid of all of the doubts that we have, but we can continue to wrestle with it. Also, Pastor Bill is literally friends with Tim keller so I am actually so grateful that I can go to a school like Princeton and have access to meet people like that.
- We had a really great time at class sharing today and even though we were super tired and went to bed instantly, it was 100% worth it and I got to talk with everybody in our class 🙂 Michael was not here so I was like the only guy so that was a tad bit awkward but I think that I am comfortable enough with everyone else to not be THAT awkward. And then there was ramen today and that kinda messed up our stomach so I don’ t know how worth it that was
10/13/23
- We had a super lazy morning today and woke up at like 12:30, got lunch, and just did laundry and ate some tacoria before we went to the retreat. First day of retreat today so that was quite exciting; we are doing piano for praise and although it was a little bit stressful to have the music given to us on the day of, it was very very worth it and there was so much praise today 🙂
- We honestly heard a very fire sermon today given by Pastor Bill about 8 lies we currently believe about faith and work and it was extremely informative. And then also we got to see a lot of the other Manna people that we do not normally talk to (like Yedoh!) So it was pretty nice to see her face again and be able to serve together with her.
- We had TURTLE CHIPS TODAY! And then we spent a lot of time practicing praise with James, Yedoh, John and Jocelyn so it really was a true blessing to be able to serve alongside these other brothers and sisters in Christ
10/12/23
- Guess. Who. Is. All. Done. With. Midterms. I AMMMM I am so so happy and grateful that I have finally finished these stupid midterms and thankful for all of the friends and support and living that got be through it. It was very very tough, buttttttt WE MADE IT. And now we can enjoy a super duper fun fall retreat and also a very very relaxing break
- We went to POL precept in the morning and took our quiz, and then we went to orgo lecture, got some lunch before heading to chem lab, and then took a nap before studying for a little bit before we went to the ReMatch research thingy, and then we went to take our EEB test and then afterwards we got late meal and then went to Rebekah’s room with Cevina and just talked with them for the rest of the night which was very very fun
- We got to see everybody in such good spirits today after midterms were all over so that was really nice 🙂 Everybody was so willing to talk and smile and I am thankful that people are always so friendly and approachable 🙂
10/11/23
- We are almost out of this hellhole Jonathan… only one more day. I’m grateful for all of the friends, study sessions, and for God who has been able to bring me through this midterm season but I am so much so in the DUMPS right about now. But we are making it through this 🙂
- We had a decently productive day today; we woke up and then we went to POL lecture, and then EEB lecture, and then we had lunch before going to english lecture, and then we studied a bit before heading off to prayer meeting, closing the pre-dental association tab, and then going to get dinner with Michael, Kevin, Xuanying and Joie and then we went to our orgo precept, and then we went back to studying before going to the gym, and then getting wawa 🙂
- We had a super duper fun conversation during dinner today with everybody so I am really really excited for fall break and for everybody to come over 🙂 That should be super duper exciting and I am very much looking forward to that
10/10/23
- We are halfway through this hellhole of a week. WE ARE IN THE DUMPS RIGHT NOW. But I’m sure we will make out of it alive… I hope. We woke up and then we went to our orgo lecture, had lunch, and then took a nap before another POL lecture, and then we went to Stone and studied a bit before getting dinner, going to a predental meeting, and then back to Stone to study, and then we got late meal, called umma and then went back to our dorm to unwind for the rest of the day
- We got to have lunch with Daniel and then we got dinner with Michael and David so that was quite nice. I love being able to grab meals with people and talk and laugh and such. But also it was also such a busy busy day I couldn’t spend much time talking and had to just leave pretty quickly. And then we also got to call umma during late meal today so it was nice being able to talk to her as well
- We had the BEST COOKIES EVER made by Monica at Murray Dodge and dude those cookies were absolutely fire I don’t think I’ve ever had a cookie that tasted that good. I think that I am going to have dreams about those cookies from now on because dudeee… it was SOO GOOD
10/9/23
- We had a pretty fun day today; we woke up and then went to our POL lecture and then we went to EEB lecture, and then we get lunch, took a nap, and then went to English precept, got some late meal before locking up in the library, and then we got dinner, went to the gym, got late meal, and then barely did any work before realizing we are super duper unproductive and might as well just go back home
- We got to have dinner with Kevin today and then we got late meal with Xuanying, Jocelyn and Stephanie so that was nice. And Kevin is such an easy person to open up to and talk to it’s so amazing how he’s really open minded. And then also we got a lot of studying done today too with all of them which was pretty great as well
- We got accepted as a James Madison fellow so that was exciting. And then also our pre-dental coffee club tab is all set, and then also we had a really fun time at English precept today cause our conversations there are always super interesting.
10/8/23
- I enjoyed today and we were pretty productive (although we did spend a lot of time doing random thingies). We woke up and then went to church, got lunch, and then went to junbi and then after we studied for like 3 hours, and then we got dinner and then went to get some more coffee and then spent the rest of the day studying… Wow now that I reflect on it that is quite the sad day
- We got to have free Onigiri because Aliaster paid for us and so that was really really nice and fun. And then we also found a bunch of new songs because of the super cool spotify playlists that were made for us so we jammed out to that while we were working on our orgo pre-lab.
- We got to have lunch with Boya, Bryan, Michael, Lu, and Xuanying today so that was fun and it was pretty interesting conversation. And then at junbi, Boya dropped a major bomb on us out of nowhere so a lot. oftea was spilled today and Jocelyn wasn’t even there so it was funny how much she missed by missing out on one singular day of church.
10/7/23
- Today was a pretty fun and unproductive day. We woke up and then went to get lunch and then we went to do our laundry, got this super cool new fun app, went to the gym, went to praise team practice, got dinner, went to large group, went to open room, and then finished off the day with just a very very little amount of work in our dorm.
- We got to have lunch with Colton today so that was nice being able to catch up with him. And then we had dinner with all of the Manna people and we got to hear a lot about how Stella and Brian met LOL. so that was kinda funny.
- We got to hear a guest speaker preach at Manna today and he was really really funny so that was quite the treat. And then we also heard Aliaster give his testimony today which was a treat as well 🙂
10/6/23
- Today was decently productive; we woke up and then got a quick lunch before heading over to Stone to start studying for bio, and then we did some English reading and then some random work before heading over for dinner, and then we just went back to Stone and did some more work, went to hit the gym, wrote an application for the James Madison fellowship, and then finished off the night just being at our room and chilling out
- We got to study with Xuanying and then Stephanie for a little bit today and so that was nice being able to study with friends and be productive that way 🙂 And then also we talked with Brian for a little bit and saw Michael as well
- Appa called us today to literally just ask how we are doing so that was super duper cute and I am happy that he did that. I should probably call him a little bit more because now that umma is in Paris Idk if he is lonelier butt Josh and Joey are going to be home so there’s that. But anyways I am grateful for famil.
10/5/23
- Make sure to be grateful Jonathan. We did get a little bit upset and mad tonight BUT you need to make sure to have a heart of gratitude. We got a lot of sleep, we went to a lot of meetings, even though we were not as productive as we would have liked to be, we still need to be grateful and content with everything that we were able to do today.
- We woke up and then went to our POL precept, and then went to our orgo lecture, got some lunch (after we got locked out of our room) and then we went to orgo lab, and then we went to Whig Clio to hear the debate on Supreme Court term lengths, and then we had our meeting with Soonho for the first time and honestly it was pretty great and we got to meet his son Toby who was super cute, and then we went. toUSG and got to read a lot of 1 Samuel, and then got late meal and then went to bed.
- We scored an A+ on our first orgo exam…. GO OFF JONATHAN. I am very very proud of us BUTT we still need to be on guard and study just as hard if not harder for the next one.
10/4/23
- We woke up a bit early and took a shower and breakfast for the first time in forever, and then we went to POL lecture, EEB lecture, ate lunch and then went to English lecture before heading some late meal, having a flu shot, and then going to our pre-dental association officer meeting and then we had the most fire dinner ever in Roma before going to our orgo precept which was honestly really fun. And then we finished off the night with some more late meal and also talking with Evelyn for a bit so that was quite nice
- The ribs at Roma were absolutely insane and they had it with the little bread and spread thingy which was insane as well and then there were these vegetables and pasta that I could not stop eating and then the grilled chicken was literally better than what I would eat in restaurants and overall I just loved the food that I ate today
- Evelyn told us about the Firestone children’s library and also the museum that I just never ever knew about so now I am going to go and explore there. And then also just overall the conversation that I had with her was pretty fun too 🙂
10/3/23
- We woke up and the immediately went to our orgo lecture which is great because that is at 11 instead of the ungodly hour of 10, and then we got lunch and headed to our EEB lab which was quite the adventure. We measured tree distances and got to go out into nature which I really loved. And it was also really fun since we got to talk to Jessica a lot and learn about her and her life a bit so I liked that! Learning about people is fun. And then we studied before going to the Whig Fireside chat and we actually asked a question there about Ukraine, and then we went to the library and studied with Richard until we got late meal and then headed back to our dorm.
- Honestly the fireside chat really showed me that I loved American government and Politics but I am still a little bit at a loss of whether or not to do EEB since I think I just overall fit in better with the EEB people whereas I am a little bit of an outsider when it comes to Politics. But I guess I have not given Politics enough of a fair shot whereas I already have friends who are in EEB.
- We got to talk with lots of people today overall which was really nice and I guess I am just really grateful to be at Princeton and have friends and be able to meet new people. It’s just great 🙂
10/2/23
- WE FINISHED OUR STUPID ORGO TEST SO I AM HAPPY ABOUT THAT. Honestly, we did as best as we could so I’m not too upset about anything butt…. yeah it was still not perfect. I WANT TO GET BETTERER AND SMARTER
- We woke up and then went to our POL lecture, and then went to EEB which was pretty useless, then we had lunch and then went to our English lecture and precept which were both really really fun, and then studied, got dinner, and then took our orgo test before getting late meal and then studying at Stone and then talking with Kevin for the rest of the day.
- We got to have lunch with Jessica today and then we got dinner with Lindsay and then we also got late meal with Jocelyn so I am very very happy and grateful to have friends here and be able to catch up with everybody 🙂 I enjoy talking to people!
10/1/23
- We had a very very productive day today so I am happy about that. We woke up and then went to church, and then we went to get lunch with Jocelyn and Xuanying and then we went and did work at Frist and got tutored for a bit, and then went back to the library to do a little bit more studying before getting dinner and then going to Mcdonald to get some more orgo help and then we went to the gym to do a quick chest day before starting our laundry, taking a quick nap, and then going back to Stone to do some more studying before getting some food at the Ustore and just ending the day with relaxing.
- We learned SOOO much orgo today that is absolutely insane.. Idk if I want to know this much orgo it’s kinda annoying and fills my brain too much. But anyways I think it’s kinda nice to feel productive.
- Church was fun today; we got to talk to new people and then see how helpful these orgo tutoring sessions really are.
9/30/23
- September went by sooo quickly that was absolutely insane. But yeah happy end of September Jonathan; hopefully you are able to make pace with everything at Princeton now and can get into the flow of thingies better. But we are really enjoying every single day here and I am very very grateful to be surrounded by such amazing people
- We woke up at like 12:45 today and then ate a bit before heading over to Firestone and then just studying… and then we went to practice for praise team, did large group, got a hoagie and ate it in open room, and then continued to study until the end of the day. It was both a fun and productive day so I am proud of us 🙂
- We got to eat tacoria AND hoagie haven today so honestly… we should just become independent at this point we are basically eating out more times than in the dining hall haha. BUTT the food was SOOO worth it I love eating 🙂
9/29/23
- We woke up late, we went to bed late, but we got a lot of sleep. So that is something in and of itself to be grateful about 🙂 We got a lot of studying for orgo done today too so that’s something to be proud of as well. And then we finished our English paper which was pretty fun to write honestly I enjoyed writing it
- We went to the orgo mock exam and got our butts whopped; HOWEVER, we did learn a lot and now we know that we are very much screwed for this upcoming exam… HOWEVER there’s also the motivation factor to push ourselves to get better and better and learn more and not suck at orgo so that’s something… And then we also got a philly cheese steak hoagie to make ourselves feel better
- We basically had a Saturday today 🙂 And then we called umma and got to talk with her for a little bit as well so I enjoyed that too. And then we got reminded of Your lie in april which was so so nice
9/28/23
- I enjoyed today; we woke up and then went to POL precept, and then orgo lecture, and then went to take a nap before orgo lab, and then got late meal after that and then did some work in the library until we went to the PPDA dinner thing, and then we took a nap and then went back to the library to study for a bit until we got wawa and chilled in our dorm for the rest of the night
- We got to have a very very fun dinner conversation with all of the PPDA officers so that was quite nice! And then also we got to have a late meal conversation with daniel which was the first time we really talked to him and he is quite possibly one of the nicest people everrr
- We called umma today so that was fun, got to talk to Anna a little bit and try some of her snacks, and then studied with Stephanie at Firestone for a little as well which was also quite nice! Everything about today was good
9/27/23
- We had a decently busy day although not as productive as we would have liked it to be. We woke up and went to our POL lecture, and then we went to EEB lecture, and then we got lunch and then went to english lecture, and then we got some late meal and then spent a bit of time studying in the library before going to prayer meeting and doing worship there, and then we got dinner with Jocelyn and then got to eat a little bit with Kevin on his birthday, and then we went to orgo precept and then after that we went to late meal and then went to sesh and then attempted to do work but then failed cause we are tired
- We got to have KOREAN FOOD TODAY at Kevin’s place cause it was his birthday and his mom brought him kimbap and kimchi fried rice and a bunch of other Korean food and we got to sample it ALL so I am so so happy about that 🙂 I love eating Korean food
- We got to go to sesh for the first time today and WE GOT THE TURTLE FREEZE DOWN LET’S GOOO. It took absolutely forever and we thought we would break our wrist but fortunately it all worked out in the end 🙂
9/26/23
- I enjoyed today even though we did not get too much orgo studying done today. But I think that everything except for the night time was decently productive. We woke up and went to our orgo lecture and then went to get lunch, and then got some late meal before going to EEB lab, and then we went to tutor joey and then worked at firestone for a bit and finished our bio lab which was kinda productive and then we attempted to study a bit more before heading over to wawa and then practicing guitar for tmrw
- We got to study a bit with Monica, Stephanie and Daniel so that was pretty nice being able to work with all of them and socialize a bit today 🙂
- We called umma after an attempted late meal so I am happy that we are able to call home and talk with umma
9/25/23
- Today was honestly very very fun, and decently productive as well so I am proud of us. We woke up and then went to EEB lecture, and then got lunch and did some laundry and errands, grabbing late meal and cleaning up a bit before studying and doing work, and then we wrote our chem pre-lab and then studied a bit more by doing our preliminary problem set, and then we went to orgo office hours and got to study a little bit with Chrstina so that was pretty nice and then spent the rest of the night in open room organizing english notes.
- We got to have a lot a lot of fun during open room today; there were so many people and we got to have a lot of fun conversation. Unfortunately however, there. is not a lot of work that we are doing. BUTT nonetheless I am super duper happy that I have a community like that to just study, do fellowship and spend life together with.
- We got to get a lot of our chem questions answered by the TAs so that was very very helpful and then watched some youtube videos and then Christina explained a lot of lab thingies to me so I really really appreciated that as well. I am glad to be surrounded by such smart people it’s great
9/24/23
- We had a pretty good Sunday today although not as productive as we would have liked it. We went to church, and then ate lunch at Whitman, and then had a quick nap before going to get a haircut, and then we went to the library and did some work before going to the gym with Marvin and then grabbing dinner with Anthea and then we did some of our laundry before coming to open room and “working.”
- We got to have lunch with all of the Hope people today so that was pretty nice talking to a few people who we have not talked to in quite a while. And then there was crepes at Whitman which was decently yum as well. And then we also got to have a pretty good conversation with Anthea for dinner which was vv interesting I enjoyed that lots
- We took a fire nap today which was absolutely delicious… And then haircut + laundry + eating + church + gym + work + nap + church = very very good day today.
9/23/23
- We had a very nice Saturday today; we woke up at like 12 and then did a lot of work until around 4, and then got some food with Umma and then went to PCC for Manna large group today and we got to do praise for that so I enjoyed that a lot
- There was soooo much good food today because umma brought us a lot of Korean food so I really enjoyed that a lot it was quite yummy and then we also ate some more after Manna large group so that was even moreee yummy food
- We got to have some dessert at PCC today which was very very nice and on top of that when we were eating our Korean food today, some person just left a chocolate lava cake in the middle of the common room which we ate…. don’t ask if it was allowed or free or whatever, I still ate it 🙂
9/22/23
- I enjoyed today a lot even though we are always very very unproductive at night so I need to learn how to switch that. We woke up and then ate at Whitman before heading over to the library and doing some work, and then we went to late meal and then we went back to the library to do some work and tutor Joey, then we went to get dinner and then the MASA dinner and then PCF FNF and then we bummed out in our room for the rest of the day
- We got to have dinner with 2 Frosh today so that was nice meeting new people and getting to be an upperclassmen LOL. They were both very very nice so I am happy about that
- We got to get a lot of studying throughout today done which was decently productive so go us!
9/21/23
- We had quite an interesting dayyy; we woke up and then went to our POL precept, and then orgo lecture, had some lunch and then chem lab where we spent the majority of our day failing and sucking. And then we went to our dorm to do laundry, went to pick up our paperlike I pad screen protector and FINALLY GOT IT ON, but then we also accidentally ate a peanut and then spent the rest of the day in Mccosh and also resting so that was not fun.
- We got to have dinner with Santiago and learn a little bit about him and where he came from so that was very very fun and interesting. I am glad that we are able to meet new people from such diverse backgrounds here.
- We had a bit of a scare with our paperlike screen protector but luckily it came with. an extra one so we are able to finally get it right on our third try…
9/20/23
- Weee got about 12 hours of sleep today so that was the most restful night ever. I think I was a little bit worried I would wake up and not be able to go back to sleep but it all worked out and we are not sleepy so that is good
- We woke up, went to our POL lecture, then EEB lecture, then got lunch and then went to our English class, and then got late meal, practiced a bit before prayer meeting, went to dinner and got ice cream and then went to orgo precept, got late meal and then knocked out
- We got to have lunch with Angel today and then dinner with Brians so that was fun. And then Brian kook bought us ice cream from bent spoon which was pretty yum so I am grateful for that
9/19/23
- We had a decently productive day today for the most part; we woke up and then went to our orgo lecture, and then had lunch, went to our EEB lab, then came back and did some work at the library, got dinner, went back to the library and took a nap and did some work, got late meal, went to the gym, and then bummed out for the rest of the day
- We got to go on a field trip for the EEB lab today which was quite fun and pretty interesting. We also got to talk to a few new people and enjoy pretty nice weather today so I am happy about that
- We were decently productive in terms of doing work and getting things and studying done so go us!
9/18/23
- I am grateful for today :). We woke up and then went to our POL lecture, and then our EEB lecture, and then lunch, then our english class, english precept, then bought some thingies at the UStore, went to Stone and did some research, went to get dinner with Anna, went back to stone to do some more work (kinda), went to the gym after getting late meal, and then bummed out for the rest of the day 🙂
- We finally figured out that we are going to major in Politics so I think that this is probably the most “productive” day that we have ever had at Princeton. I think we are pretty set on this major and are going to stick with it and we will possibly have an EAS minor underneath that as well. I am so so thankful that God gave me this opportunity to study Politics at Princeton and also still stay pre-dental like what in the worlddd
- We got to see Anna and Tammy for dinner today and practice some of our Korean which was pretty nice I enjoy being able to talk with friends and also at the same time practice our Korean speaking abilitiesss
9/17/23
- Happy Sunday Jonathan ! We were able to go to church this morning, and then surprise Boya for her super late birthday, and then got to study at Frist, went to the gym with Marvin, ate dinner, and then worked in genomics until the end of the day which was decently productive
- I am very very thankful that I have friends who are not only willing to just take time out of their day to help me with orgo, but also are so considerate enough to plan these surprise birthday parties for each other haha. That is such a cute community and something that I do not think that I can find at home so that’s great 🙂
- We got to do a leg day with Marvin and also catch up with him about how his life is going and then also got to see a room tour so that was quite nice being able to talk to him about our old Korean class. I miss it ;-;
9/16/23
- Eventful day today; we went to six14 auditions in the morning, and then went to triple 8 call backs after, and then we went to praise team meeting, got some tacoria and bought cake/card for Boya’s super late birthday, and then went to large group and finished off the night with playing smash in open room
- We got to do a lot of dancing today which was very very enjoyable I like dancing a lot 🙂 Hopefully I can continue it throughout this year butt Idk if that is going to be happening soooo I guess we will not be disappointed if we don’t get in
- We got to have a lot of fun at open room tonight and then got to talk with Bryan’s friend who is from California. It’s nice being able to meet new people 🙂
9/15/23
- We had a pretty fun day today albeit a little bit unproductive… but we got a lot of the work that we needed to do done today so that is good. We woke up and went to our advisor meeting, and then went to Frist to get some food, and then worked at Stone for a little bit, and then went to the career and study abroad fair, and then studied outside because the weather was pretty nice, and then we practiced dance, tutored Joey, had dinner with Tina, went to PCF FNF, got some more food, took a quick nap and then practiced dance again until the end of the day
- We got to study together with Alaister, Jocelyn, Grace and Monica today so that was quite nice. I enjoyed being able to talk with them and catch up over a very very nice weather outside and then also I guess get some work done. Also grabbing dinner with Tina and catching up with her about how her life was going was really great as well so I’m happy about that : )
- We were able to talk to a lot of the PCF people that we have not been able to see in quite some time so I enjoyed that a lot. And then there was also suchhh good desserts there that tasted soooo good so I am eating very very unhealthy unfortunately. We had cookies and cakes and ice cream and everything you could possibly think of that is not good for my health.
9/14/23
- Today was quite the interesting day… we woke up and went to our POL precept which was the first time for that, and then we went to orgo lecture, and then we ate lunch and then went to orgo lab, then we went to junbi and then picked up a few drinks for our PPDA meeting right after, and then we went back to our dorm and rested a bit before the massacre that was from 7-10, and then after fully exhausting all of our energy we went to wawa, got some fairlife, and then ended the day with just chilling and youtube in our dorm
- I am glad that we were able to have such an informative PPDA meeting today! We got to find a lot of information regarding courses we need to take and stuff about HPA and all that fun stuff that we will soon be facing in the coming days so that is excitinggg.
- Our orgo lab TA was quite possibly the nicest person that I have ever met in my entire life I am glad that he is going to be showing us how not to screw up lab in the upcoming semesterr. But also I did realize that I am a bit stupid so I need to start catching up on all of my work and everything so that I do not completely fail all of my classes!
9/13/23
- We had a pretty productive and eventful day today so that was nice. We went to pol lecture, and then EEB lecture, and then ate some lunch at Forbes, and then went to our English class, and then got late meal and had dinner with Dimiana before heading over to chem precept
- We had a very very interesting conversation with Dimiana for dinner today for our Bible as literature class. She is such an interesting person and I am super grateful to have met her and be able to discuss our different backgrounds and personal viewpoints on Christianity and the Bible. Also superrr cool person.
- We got to go to our first orgo prcept today and we weren’t completely lost so that was exciting! Good for us for being able to actually follow along in a class and not get left in the mud. And then there is also Kelly, Evelyn, and Cevina in that class so that is something to look forward to for the rest of the semester! ALSO WE GOT TO TEXT HEATHER A BIT TODAY WHICH WAS SUPER CUTE I am glad that we got to catch up for a bit with her
9/12/23
- I am so grateful we have an iPad cause when the school Wi-Fi goes out for some reason only on computers I still can do work on this thingy hehehe. Anyways, today was a good day; we went to orgo lecture, and then had our bio lab, and then we went to Firestone to do some work, got dinner and junbi, and then went to friends to do some more reading, and then went to colo and got some s’mores, and then went to the gym and finished the day with a solid chest workout
- we got to have lunch with noe today which was very very nice i enjoy being able to catch up with people like that. And then we also had dinner with Jocelyn and Xuanying which was yum as well. the food was pretty good and also we tried Forbes lunch for the first time and it was actually not crowded so I am very happy about that. Also spent some time eating s’mores and trying hard seltzer which was interesting
- EEB lab was very very fun todays we literally got to just go out and explore different species so I am super duper grateful to be at this school lol. We also got to get a lot of reading done today and I am realizing I enjoy reading sooo much more than bio
9/11/23
- We had a very very fun day today albeit a little bit unproductive in terms of actual school work… We woke up and went to our POL lecture, and then we went to our EEB class, and then had lunch and then went to our english lecture and precepts. And then we got late meal, and then did some editing of our youtube video before heading off to work out, and then going to grab dinner and then going to colo and having some fun at their bubble tea event, and then we went to late meal again and wasted time until the end of the day at the East Asian Studies library
- We got to talk to lots and lots of people today so I am very very happy about that. We got to have lunch with Jessica and then we also got dinner with Shreya and then had late meal with Michael, Jocelyn and Xuanying and then we also got to play some super smash with the other Jonathan and then just overall hung out with so many different people today that it was such a blessing to see everybody. And then also apparently Kevin is in our POL class so that is so so clutch.
- We got to call umma today and talk to her about how her day is going and then also we talked a little bit about Joey and our uncle Andrew who died in 9-11. It’s so interesting to learn more about my family and where I came from and about the other people that I am connected to in addition to my personal school work. But I really should be working on my school work a little bit more than I am right now so I will be productive tomorrow I promise
9/10/23
- We had a pretty fun and productive Sunday today Jonathan so good for us! We went to church in the morning, and then went to lawn parties for a bit, and then studied at genomics with Jocelyn, then got dinner, and then stayed in our dorm and chilled out for pretty much the rest of the day so that was pretty fun
- Lawn parties were very very great; we got to have lots of good food like taco bell and pizza and there was also pizza at church so there was lots and lots of pizza today, and then there was also cheesecake on a stick with oreo and chocolate so even though it was the same food as last year, it was still really really good. And then we also got to take lots of pictures today with Manna and Six14 and a bunch of other friends so that was very nice as well 🙂
- We got to get a lot of reading done today: I think we did all of our reading for our english class tmrw and then there is a bit more reading for POL lecture but I am not going to bother with that. But I am happy that we were able to be productive with our time today and actually get things done instead of just wasting the afternoon so good job for that Jonathan!
9/9/23
- I really much enjoyed today despite it being a little bit unproductive considering we woke up at 12:30. Everything else today was pretty nice though; we went to the Butler basement and did a little bit of orgo studying there; and then we went to Firestone and did our pre-lab and studied a bit with Grace and Jocelyn, and then we ate lunch at tacoria, and then did praise for Manna Large Group today
- Large group today at Manna was very very fun and there were many frosh that came too so it’s nice being able to meet new people and have new conversations. Also after large group we went to wawa and we found out that the chicken, bacon ranch quesadilla is quite possibly the best thing on this entire planet (with chipotle sauce ofc) so I think that we will be getting that from now on instead of our hoagies that were cold and disappointing.
- We got to do piano at praise today so that was super duper nice and such a privilege to be able to serve on the priase team with our piano. Mmm we messed up a little bit during the songs but I know that it does not really matter because as long as we are worshipping and giving our hearts to God, then it really does not matter what I sound like.
9/8/23
- We had a pretty good day today; albeit a little bit shorter and unproductive than we originally hoped for. We woke up and then went to MC to do some work, and then we went to go and table for Manna, and then we ate late meal and then tutored Joey, and then went to our pre-dental association meeting, then our praise team dinner, then did some work with Boya and Jocelyn, and then practiced piano for a little bit, went to wawa and spent some time with Skywalker, Jonathan and Chris so that was kinda fun
- We were able to see Sky today for the first time in quite a while so that was nice. And then also we decided to audition for Triple 8 because he is doing it too so I think that it is good that you are pushing yourself to go out of your comfort zone even though you will probably not get in. It’s important that you are trying new things and putting yourself out there so I am proud of us for that
- We got to see lots and lots of people today and there is no classes on Friday so that is something that I am super duper happy about. But make sure that you are prioritizing studying and doing school work as well Jonathan because studying is very very important.
9/7/23
- We had a very very fun day today and also it was super relaxinggg. We woke up and then went to our orgo class, and then for the rest of the day we actually had absolutely nothing. We got to see Lindsay for a little bit today after orgo lecture and talk to her for a little bit so that was nice, and then we did our laundry so now we have a fresh set of clothes, got dinner with umma and appa who dropped off a lot of stuff for us, and then we took and nap and then finished off the day with working a bit on anther youtube video and then practicing piano in the basement of Butler and then talking with Michael and a few of his friends there so that was really nice as well
- We got to hear Kellen’s piano skills tonight and sing along to some karaoke so that was a very very fun night tonight. I wish I had the ability to play piano like that too LOL and then we also got to eat some Italian food with umma and appa at this new restaurant so we are being able to try out new restaurants which is pretty fortunate! And then we also had pizza at Studio 34 and then a cliff bar so that was pretty yum food as well I am happy that we are able to eat yum foods.
- We got to have some very fun conversations with with umma and appa so that was nice. And they brought us a fridge and some rubber bands and a bike and lots and lots of other stuff as well so that is going to be very helpful in the future to come 🙂
9/6/23
- There was lots and lots of thingies to do today so I am really grateful that there are lots and lots of thingies to do 🙂 We woke up and went to our politics class, then EEB lecture, then got our chem PPE and then ate lunch at CJL and met someone named Angel, and then we went to our english class, and then we worked at Frist for a while until going to get dinner with Koki, and then went to get late meal after working out and then we went to Firestone to do some more reading
- We got to see lots and lots of more people as well today so that is quite nice 🙂 I am really happy that I am seeing familiar faces and everyone is still in decently high spirits so that is encouraging to see haha. And then also we are really enjoying most of our classes; the politics class is actually the most interesting class I think I will be taking so even though it is a lot of work, I think I am going to stick with it. And then EEB 211 seems manageable as well so that is nice. And then also Katherine is in our english class so it’s great that we are able to have a familiar face in that class
- We got to eat lots and lots of yummy food today and so that was pretty nice. And then got lots of free stickers throughout random places today so I love this ability to just get “free”ish merch. We ate lunch and talked with Angel for a little bit so that was nice, met a few freshmen on our wait for the chem equipment, and then got to see lots of our chingoos today
9/5/23
- Happy first day of classes Jonathan! There was SOOO much things to do today it was absolutely insane so make sure that you are finding the times to just sit tight and study because there will always be times to socialize, laugh, and talk with people. We got to take our first day of class photos today which was pretty fortunate, and then got breakfast with Xuanying, then went to our first Orgo lecture which was pretty doable, and then we went to lunch and ate with a guy named Ryan, and then we did some work, went to Frist, went to one of Jocelyn’s classes and got to see what that was like, ate late meal, went to get dinner with Bryan, James, Kevin and Tim, went to the pre-dental officer meeting and got lots of venting done, and then just finished off the rest of the day with work
- We got to see SOOO many people today and have so many great conversations I am super duper happy that we were able to talk to so many new people. It’s so nice to be in an environment where I can say hi to familiar faces and then continue to meet more and more people as well that is very very nice
- We got all of our four classes for this semester I think…? I am a little bit nervous for the POL class but honestly you were fine with it before Kulsoom mentioned 200 pages of reading a week so you should be fine with it now right..? Right?? Nono we are trying our best to get out of it but I think it is done and we are going to have to lock this class in unfortunately 😦
9/4/23
- Every day at Princeton is like… 4 days worth of activities that I would do at home LOL. But yeah there was much to do today; we met so many of the new frosh so that was pretty nice as we are expanding our social circle. I think that we will have lots and lots of new friends this upcoming semester because there are quite a lot of new people who are interested in joining Manna! And thenn we finished our ST pre-retreat which was quite long but in the end I am happy that we are all done with it. And then we also bought our books from Labyrinth and it all went smoothly so that is happy as well
- We got to have pizza for lunch today and then we also went to Colo for their carnival and food which was very very fun. They had water balloons and we got to play with Kevin and Michael while the girls watched because they are no fun to play with. And then we also got to see the other Jonathan today which was pretty nice as well! He had his shirt off.. And thenn the reunion of all of Kevin’s backup friends was also very very nice and Xuanying bought us gifts from Singapore so I am superrr duper happy about that. She is such an amazing friend I am happy that I was able to make friends 🙂
- We got to meet so many new people at the Ice cream social and the frosh are all extremely extremely friendly and I am so happy that I am able to be a part of a community like that. We got to explain a bit about Manna to a few frosh which was fun and then also we went to carl’s center and were able to get a bunch of free merch like a free shirt and cup and pen and such so that was fun as well. I think Brian is such an amazing underclassmen I am happy that he is planning on joining Manna and being a part of the community there.
9/3/23
- We had our first full day here at Princeton and we are already becoming super duper busy what in the world. We left the dorm at like 9:45 and then we get back at like 10 sooo very very busy day indeed. We woke up, went to church, met a bunch of cool new people, went to lunch, then went to the beginning of Manna Pre-retreat and did the retreat thingies for basically the rest of the day which was quite long
- We got to grab lunch with Kevin and Joie today so that was nice. It was an interesting conversation we had so I am happy that we were able to do that; and then we also got our class of 2026 pre-raid shirt so that is another souvenir that I am going to be able to keep in handy. And then we also got to see so many familiar faces today like Quinn and every one of the Manna ST members so that was nice as well! Grateful to have friends where I can just see again and catch up with
- We got to have chipotle for dinner today and that was the yummiest thing ever; a little bit salty but we had like 2.65 worth of guac which was able to balance it out and then make the meal a little bit more balanced and healthy. And also we basically gulped down a gallon of water like Idk how my body even holds that much water but it did.
9/2/23
- We have officially moved back into Princeton today so that is quite excitinggg. Yay for being backkk; but honestly a little bit scary as all the nostalgia and memories from last year came hitting back so quickly so you are realizing that you didn’t dream the entirety of first year and you are actually at PRINCETON. WHAT THE HECKING HECK HOW ARE YOU AT PRINCETON RN THiS IS SO UNREAL. But anyways; thankful for this opportunity to study at such a school
- We got to have a last family lunch with everybody for the first time in quite a while and then we had dinner with umma and appa at this Mediterranean restaurant which was quite yummy. I got the baby chicken which literally looked like a chicken in some hay with eggs around it. But anyways, the bread was probably the best part of that dinner because Mediterranean people really know how to cook their bread and hummus. I think everything else was a little bit mid however.
- We got to see Halabogi today which was nice. I think it’s been like an eternity since the last time I went to see his dry cleaner work place but we were able to get to see it on the way! And then Josh helped us fix our ipad and sync our ipad and computer together which is going to be very very helpful when taking notes so that is good as well. THANKFUL FOR FAMILY. But now let’s go and kick some ass this year.
9/1/23
- We got to have a pretty good first day of September today, we went to see bogum today too so that was very very fun. He is such a cute doggo and I absolutely love him when he is not being a pain in the ass. He’s soooo huggable I get why everyone loves him
- We got a new Ipad today which was the best thing ever. I love this new Ipad it was like so much money and then we also got an apple pen which was more money but it was very very worth it because we are going to use this for notes from now on. I enjoy that a lot
- We got to eat some of the chicken and rice again at the Japanese food place at Broadway mall and that is so worth it omg I don’t know how they make just chicken, rice and vegetables taste sooo good.
8/31/23
- We got to have a very very fun beginning of the day today. We got to go to the city with Umma, Appa and Joey and honestly we had a very very fun time there. We went to Serendipity, then we got to walk around the highline, and then we walked at this island thingy which was very pretty and heard the most insane trumpet player of all time doing his thing there, and then we went to this aesthetic starbucks and looked around, and then we finished off the city trip with some very yum japanese food
- We got to have some really really good desserts at Serendipity today. We tried this iced hot chocolate for the first time and omg it was super duper good. And then we also had this ice cream and chocolate cake mixed together which was quite yum as well. And then the Japanese food place that we was very very aesthetic there was some pretty good food there too.
- We got to do so much walking and the weather was absolutely perfect today so I am very very grateful about that. We got to see very very pretty things today, the high line was super duper aesthetic, and then we also got to enjoy the scenery at the piers
8/30/23
- Today was just a control and paste of Monday. We did NOTHINGGG and I am so happy about it. We drove Joey around and found his trumpet today and then ate some chicken and rice at the Japanese restaurant place thingy so that was very very yummy. And then Joey had some subway and we got a bite of that which was pretty yummy as well
- We got to play trumpet for the first time today in such a long long time and I am happy about it. We have not completely forgot how to play trumpet which was fortunate but also our tone sounds a little bit off but it is alright.
- We got to play a few or rounds of cs today which was quite fun and we are basically playing cs every day so I am happy about that but I know that once school starts we will not have any free time to just play video games anymore so make sure that you spend as much time enjoying this off time.
8/29/23
- We had a bit of a more productive day today so that was nice. We hit the gym and did a chest day, then we went to the library and wrote a little bit of a blog post and then went to Starbucks and did some work there as well
- We had some very very yummy food today as per usual I think we gained like 5 pounds since being home
- We got to have lots of rest and relaxation today and are getting so so much sleep
8/28/23
- We had SUCH a lazy and unproductive day today that was absolutely amazing. We woke up, and then watched like 2 movies, played like 6 cs go games, and just did overall nothing. We stayed in home ALL day and pretty much didn’t even talk to anyone which was such a needed thing for introverts like me haha. But honestly I think that with days like this, it’s getting me more and more ready to get out there and start doing some work
- We got to play 2 rounds of cs with some of our old friends like Jayson, Ryan, Jared and Justen so that was quite the throwback. I think it’s been like YEARS since the last time I played cs with them so that was a treat. And also like a once in a life time reappearance from me haha
- We watched a Man called Otto and the first half of the Titanic today so that was really fun; we got to watch 2 movies that were actually pretty decent so I am grateful for that. And then also we did like 3 loads of laundry so that was decently productive as well good job jonathan
8/27/23
- We came home from the retreat and got a full ride from Sophia which was fortunate; she is such a good driver despite being like a year younger than me I don’t understand this. But yeah she drove us to the chajangmyun place and then we got driven to church as well; and then also we got cuddled by Nathan so that was also a little funny as well
- We had a FIRE nap on the ride home from the retreat center. I feel like it’s been so long since I remember what it felt like to be tired… That is such a thing to be grateful for causee that is ending as soon as school is starting haha.
- We got to have some really good food today at the retreat center and also at the chajangmyun place so that was good. And then also we said bye to all of the little kiddos today and then to Darren, Rachel, Sophia, and the rest of the retreat staff because that is the last time that we will see them in quite a while
8/26/23
- We honestly had a really good day today at this retreat. I am having a lot of fun talking with all of the kids and getting to serve with the other people here 🙂 Also the food is decently yummy so I am happy about that. We are having lots and lots of cheat meals here and have had 2 ramens, 2 desserts, carbs, chips, and much much more unhealthy food throughout our time on this retreat but I’m going to go and say that they are completely worth it because they taste good and everyone else is doing it too
- We got to take the most killer nap on the floor today LOL. During the movie when everyone was watching Madagascar, you just knocked out on the floor and almost got stepped on by little kids and then you woke up when everyone was just basically leaving. Also Benjamin sat on your lap today and even though he didn’t even speak a single word I think he is the most adorable little child to have ever come into existence
- We got to have a lot of fun practicing and doing praise/worship today with Sophia, Darren and Rachel. We had pretty fun conversations throughout all three meals today and then after everything ended, we ate ramen together before we practiced for tomorrow’s praise which was such a vibe. We got to learn a lot about them and their personal lives throughout that little conversation so that was nice. And also the fact that Darren and Rachel came today is great in and of itself I’m happy that they are here and we got to talk with them for a bit!
8/25/23
- We got a free lunch at Myeongdong Kalguksu by church people so that was quite ummy. There was so much food I ate a lot and was content so I am very grateful for the ability to eat until I am full. Also we got to eat cup ramen for the first time today in quite literally forever so that was very very delicious as well 🙂 And then kimbap and chicken was on the menu as well
- We got a free ride from Sophia to the retreat center and got to talk with a lot of the little ones today! That was quite enjoyable 🙂 We got to see Erica and Hayn and Shaun is literally the most intelligent 8th grader that I have ever met in my entire life and also we talked a little bit with all of the parents
- We FINALLY decided on a 4th class after ages of searching (literally the solution was phone a friend… THANK YOU CEVINA but yeah we are going to most likely take causes of war)
8/24/23
- We helped Josh move in to his dorm today so that was fun. Honestly his room is a lot better and bigger than our room and it was such a vibe to have the “college move in” day so that was nice. We got a little bit of free Stony merch as well
- We got to have some really really yummy food prepared by umma tonight. There was steak, the Korean pancake, egg with tofu, and tofu soup so all of that was really yummy and also full of protein so I enjoyed that a lot
- We got to text hsu hsu train for a little bit on the train ride back and that’s always fun! Let’s see… if there is one thing I’m grateful for in general throughout this summer, I’m grateful to have friends to talk to who make me laugh
8/23/23
- I think we had a decently fun day today; we got to back Oreo Cheesecake with Hsu hsu train and honestly it tastes pretty fire. I think that is one of the best cakes that I’ve ever made in my entire life. It was a little bit… bad when it was hot but once it became colder I think it got a lot better
- We got to watch El Camino today and that is honestly one of the best sequels I have ever seen of a show I’m very very happy to have watched it and be able to enjoy just spending pointless time on things. Break is ending soon… HOWEVER, we are still in this and enjoying every last moment of break
- We picked up Joey from his retreat today and had a somewhat family dinner (without Josh of course since he is now in Med school which is absolutely crazy) but anyways, I think it was decently nice to have a dinner all together and be able to enjoy a meal as a family. I DONT WANNA GO BACK TO SCHOOL
8/22/23
- We had a pretty fun but I think a bit short of a day today. We woke up at like 1 and then went to the gym with Josh and Brendon and then ate at the mall, talked for a little bit and then we went back to my house and watched a movie. Then ate dinner and now am at home finishing off my day 🙂
- We got to have some decently good food today. We had the insane chicken and rice and vegetables at the Japanese food place at Broadway mall and Josh taught us about getting extra chicken so that was so so yummy
- We got to see a few people at blink today so that was quite nice. We saw Kevin and also Shawn’s sister (idk her name) but it was interesting to see people that we have not seen in quite a while
8/21/23
- We pretty much spent the entire day with Josh so that was fun I guess LOL. We went to the gym with him, ate some chicken and rice at the Japanese restaurant thingy, and then we just debated him on random thingies for basically the rest of the day since he slept over
- Umma and Appa made us some FIRE food today so. Iam very very happy about that. It was chicken, asparagus, and potatos with this fire garlic bread and it was perhaps the yummiest thing in the entire world 🙂
- We had a sleepover with Josh for the first time in a while so I guess that was fun LOL. He’s kinda…. josh. I don’t really know what else to say about that. And then also we had pretty good conversations about random stuff so that was also a nice time to reminisce about the past
8/20/23
- We got to have a lot of fun at church today since we were able to get lunch with Brendon, Josh, Steven and Jeff. And there was some of the funniest conversations that I ever had during those few hours. Bro I can never get those types of conversations anywhere at Princeton because it’s like lowering my IQ and Princeton only brings out the best in me but it’s always nice to relax a bit and talk about stupid stuff
- We got to have a VERY yummy dinner with Halabogi and Halmony at this all you can eat Asian buffet restaurant and we also got to talk with Halabogi a lot during the dinner. It was interesting being able to practice our Korean and show off those skills that we got in Korea. He called us a “true grandson” because we were able to have a genuine conversation with him so I am super happy about that and that kinda motivates me to want to continue studying Korean. And also about the dinner, we had SO much unhealthy foods but Ima say it was worth it 100%
- We got to see a lot of familiar faces at church which was pretty nice and also the sermon today was absolutely fire. It was a guest speaking pastor today, I don’t really remember his name but he was from Columbia and is Pastor Sam’s friend if you ever want to ask him about that. But he talked about what it means to have no bitter roots and I think that I should really start trying my best to have none of those bitter roots anymore either…
8/19/23
- We got to have a very very good chest/shoulders/tri workout today and honestly we are starting to realize that Midway JCC is not a bad gym at all.. It even has a pool, the locker room is honestly pretty decent, and I think that it rivals a worse type of Lifetime for a gym membership so I think I need to stop complaining about that and start being thankful for having a gym like that to go to.
- We got to grab dinner and dessert with Alice and Michael today so that was quite fun! We had this galbi restaurant and the food was honestly very very yummy and then we practiced driving since we went to flushing all by ourselves (in terms of driving). It was also really nice being able. tocatch up with the two of them (but Michael did accidentally pay the wrong Jonathan Lee about 100 so that was quite funny). And then we got dessert afterwards and I am starting to realize that we are eating lots and lots of dessert
- We had a decently interesting conversation with Michael today about choice/born and so I guess nature/nurture and I think it was quite interesting to see what people have to say about that. And then it also took up like another 30 minutes in the car late at night so that was quite the vibe. I enjoy just driving and listening to people talk
8/18/23
- We had a pretty good day today; we read “Letter to a Christian Nation” by Sam Harris which was a decently interesting and fun book. Also that man is very very funny, and then we got to grab lunch with Azam and then we went to the gym and then we had dinner with umma, appa, and joey which was very fun.
- We got to have some VERY good food today. We had chicken and rice for lunch today which was just objectively yummy and then our dinner was the most fire dinner that I’ve ever had. Granted, it was $370 BUTT I loved every bite that I had. I think that was the best fried calamari and mac and cheese that I’ve ever eaten in the entirety of my life. And we got to have some pretty good conversation with umma, and appa during the dinner today
- We are pretty much grateful for every day that is passing that we do not need to go back to school for LOL. So I am grateful for today. We ended the day with Breaking bad and cs go which is an amazing end to the day, but also a little bit unproductive so I think it is time to get back on that productivity grind.
8/17/23
- We had a pretty fun day today so I am happy about that 🙂 We got to see Eva today and grab dinner with her at this KPOT restaurant which had all you can eat KBBQ and I got as much protein as my stomach could possibly handle. Maybe likee 1,000 calories worth of just meats so I hope that I made my money’s worth but honestly not too sureee. But enough about food I am happy that we were able to see Eva and catch up with her about life. She is very very good at telling stories and talking LOL and also super sweet I am grateful that I have her as a friend that I can force to hang out with me 🙂
- We got to watch videos of our little childhood with appa and umma. It’s so interesting how they only look at videos of us instead of videos of themselves when they were younger? I guess it’s probably because they don’t have videos of themselves when they were younger but I also think that it maybe be because they care more about us than themselves so it’s super duper sweet to see that. I hope that when I have kids too I can love them just as much
- We had a pretty killer 3 hour nap today which was pretty unnecessary considering that I already slept for 9 hours the night before. But I really liked being able to sleep and not be tired.
8/16/23
- We had a decently good day today full of things that we enjoy doing 🙂 We woke up and watched some suits and cosmic skeptic while cleaning up, doing ab workouts, and folding laundry. Then we went to Jericho Public library to do some work, ate lunch and bought some fair life milk, then we went to chase to deposit some money, went to the gym to do some deadlifts and squats, went to the Syo library to do some more work, and then finished off the day with chilling out at home
- We got to have some pretty fire and healthy food (ehh ish) today. We had 3 eggs, an avocado and some blueberries for breakfast, and then chicken and rice for lunch. Still have not eaten dinner yet but I’ll probably do my best to make it healthy. Also the coffee that we got at the Jericho public library was literally only a dollar so that was very very worth
- We decided to go to the Agape retreat and help out there so that was quite the decision. I’m grateful for these opportunities to go and serve and give back to my church community which invested so much into me 🙂
8/15/23
- We haddd a pretty long day of socializing today LOL. So we got lunch with William at 12 and hung out with him untilll about 7:30 so I was pretty surprised at how long we were able to catch up with him for! But it was quite fun I enjoyed being able to catch up with old friends and see how his life is doing. It’s nice to see that he learned a lot from college but mostly didn’t change 🙂
- We got to have reallyyy really good food today. We had chicken and rice for lunch at this Chinese food place at Roosevelt field mall, and then for dinner we had pork and rice which was also super duper yum, and then after that we went to power poke and had a poke bowl from there with spicy salmon and tuna which was honestly a little worse than I remember.. I don’t think I will be getting poke again on my own any time in the near future but it was a good experience and I am happy that we were able to try all of the restaurants near our home again before going back to school.
- We got to see Michael Lan at Bethpage state park which was very very random I did not know that he worked there. But it was really nice cause he drove us around in his little golf cart thingy and we talked for a very brief time about life until his boss told me I had to go. But it was a nice memory/experience so I am happy about that. And also we got to play cs go at the end of the day and honestly we did quite well so I am happy to see that my cs go skills are not completely gone. I am a bit confused though as to how I was strictly in silver 1 for so long and then I come back after not playing in ages and I am suddenly gold nova now.
8/14/23
- Happy Mondayyy. We got to solidify a lot of plans with friends in the upcoming days so I am grateful about that. We are going to Roosevelt Mall with William tmrw, and then we are grabbing dinner with Eva on Thursday, lunch with Azam on Friday, and then hanging out with michael/alice/jerry on Saturday which is all quite exciting. I am thankful that we have friends we can hang out with before school starts againnn
- We were able to get our Midway Jewish community center membership today so we can go to the gym whenever we want to now which is quite fortunate! And then we also went to do a chest day today, actually got a compliment from Josh, and then we went to Panera and got a well deserved meal
- We finished another one of appa’s type of leggo wooden set thingies? I have no clue what it is called but we finished the big ben and now appa has it in the house as something that I have accomplished 🙂 And then also we did our laundry today and got an Invisalign case from umma so now we do not have to wrap our Invisalign in toilet paper anymore.
8/13/23
- We got to go to church today which was fun as per usual and WE SAW LITTLE BABIES WHO WERE THE CUTEST PEOPLE IN THE ENTIRE WORLD. I WANT A BABY. I would sooo kidnap one. But anyways I guess I should have talked to the parents more rather than just ignore them and play with their kids LOL. Anyways I liked being able to see the little kids, Pastor Sam honestly gives really good sermons but I would absolutely love it if we could have like a Q and A session, and we saw many familiar faces at church
- We got to go to Yoobin’s house for the first time in quite a while. AND MISO IS SUCH CUTE DOGGO. Wow there are so many cute things that we saw today, I loved being able to play with Miso, and then umma and appa bought sushi to eat with Yoobin which was also very very yummy.
- We got to go bowling today for the first time in a long time and honestly you absolutely suck at bowling but you did get better as the games went along. And it was very fun being able to actually play with your cousin and spend some time with him I guess? Honestly Yoobin gives off very very mixed vibes like I can’t tell if he wanted to spend time with ur or not but anyways time was spent with him which is a good thing objectively.
8/12/23
- We got to have a pretty fun Saturday today and spent a lot of it with Josh… which now that I think about it makes it much less fun screw Josh. But anyways we went to Broadway mall and did a back/bi day with him, and then we got to eat some food and then watched Oppenheimer, after which we went to Chic-fila which was very very good
- Oppenheimer was honestly a very confusing movie, I do not understand the hype about it, but I am grateful that we are able to be able to go to these movie theaters and then just enjoy time with familiar faces. And then we got to try the Chic-fila grilled chicken nuggets for the first time in quite a while which was very very yummy
- We got to see some of the youngins at Broadway mall like Mr. Zach, and Mark and Eunice so that was quite interesting to see how old we are compared to the new generation of peoplesss. I am happy that we are growing up and being able to appreciate the little things now.
8/11/23
- Today was the last day of camp which means that you got to see Final Presentation todayyy. That was quite fun I enjoyed being able to see the little kids and all of the teachers on stage. It made us really happy and also those kids put on quite the show. I’m glad that I can leave camp with the knowledge that it’s going to run fine without us 🙂
- We got to see lots of people today like Sam, Matthew, Amy, Jae, Darren, Rachel, Eddy, and then we also got to say bye to a lot of the kids!
- We had pad thai for dinner today which was absolutely fire. We had the noodles and also bought sticky rice which I did not know tasted so good and then we got pad thai grilled chicken which was absolutely fire chicken what what
8/10/23
- We had a pretty relaxed day today so I am grateful for that. ALSO TODAY WAS JOEY’S BIRTHDAY AND HE IS 13 NOW WHAT WHAT. He is officially a teenager and I honestly am grateful to have a younger brother in my life. Hopefully I can be someone that he can look up to and respect…
- We got to eat cake for the first time in quite a while (because today was Joey’s birthdayyy). Also we ate like 5 pounds of food today LOL and it was ALL SO YUMMY. We had an Acai bowl, a few eggs, salmon, mackerel, steak, cake, dude the food was absolutely fire it is completely understandable if you eat 5 pounds worth.
- We got to see Melvin today at Starbucks and he gave us a free coffee which was very very sweet of him 🙂 Also we got to catch up with him for a little bit so that was quite nice as well! I love being able to see old and familiar faces and catch up with them about how life is going.
8/9/23
- We got to sub for Mr. Matt’s class again today and it was quite interesting. I love camp and seeing the kids and everyone but it is a bit tiring. HOWEVER, we are here to have fun and enjoy ourselves so it’s nice to know that there is no pressure
- We got hugged so many times by the little kids today it’s SOOO sweet. Like the little girl who can’t speak a lick of english but remembered how I talked to her in the office or Peter who said he remembers me from last year! I love little kids but they are a little bit tiring sooo there are pros and cons to everything
- We got to have a LOT of yummy food today. We had acai bowls for the first time in a while and dude that hits SO hard. And then also we ate halal and other yummy foods so I am very very thankful to be able to eat yummy, non-Korean foods
8/8/23
- We got to sub for Mr. Matt today and have his class which was nice because we were able to get a camp teacher experience this summer 🙂 I am very very happy about that. And it was a decently easy day today because there were a bunch of rehearsals and so the entire grade was together for the most of it and we had his TA to help out. The only thing that we really had to do was lead the Bible Study which was an easy enough accomplishment in and of itself.
- At the end of the camp day we literally got paid 120 which is insane that is crazy that these teachers are making that much money LOL. I think I made a little less than 100 when I was a teacher so it’s interesting that all of the teachers got a raise. Or maybe it’s because I am a returning teacher which makes more sense. And then also we had a really really nice morning today because appa made us breakfast which was very very yummy and then Jeff gave us a coffee that had a bunch of protein in it and then we watched the second Pacific Rim movie so I really like these early mornings.
- We got to each at the APC Camp barbecue at the end of camp today which was fun I love being able to leech off of camp and then eat their food. And then their pasta and meatballs for lunch which was quite nice as well. We are getting paid to make little hearts for the skit, teach a random dance, and then eat their food and snacks 🙂
8/7/23
- We had our first day working at camp today! We got to TA for Matt Kim’s class, which was in other words just lounging around in random people’s classrooms and getting to see all of the cute kids and I am super duper happy that all of them remember me as well! We got to see Joy, Erica, Danica, Matthew, Evan, Shannon, and so many of our old kids like Ella or Everett and I LOVE SEEING THE LITTLE KIDS
- We had a lot of fun just talking with teachers after camp had ended. We are starting to see how camp really is changing when you get to know the teachers’ on a personal level rather than just having a teacher and getting to know them on a superficial level… It makes me wonder how the teachers really were when I was a camper. But anyways I am super grateful to have been able to see all of the teachers today and also we got to meet Joey’s teacher Joanne today which was nice as well! Seeing new faces and meeting new people >
- We got to have SUPER yummy food today. We had eggs and an avocado for breakfast, and then we had our Greek food that the Admins paid for during lunch and it was actually the hardest slapping food ever I really need to figure out what that restaurant was called because it was so yummy. And then we also had halal food for dinner because I wanted to have a non-spicy halal food and that was super yummy as well (especially since you ate it with extra protein and a protein shake).
8/6/23
- We were able to go to church on Sunday for the first time in quite a while and so it was very very nice 🙂 Pastor Sam gave a pretty good sermon about a doubly exalted God and then we got to talk with a lot of people that we have not been able to see in quite a while. We had a quick talk with Kendall today too which was fun
- We got to have lunch with Josh/Brendon/Jaemin (well sorta. we went to Fireside and then got a to go box and then ate it at Church and got to see all of the summer camp teachers today). We stayed there and had stupid, brain lowering IQ debates with Josh which are always fun to have but also tiring. And then we went to grab halal food with Josh after church which was very very spicy I do not think that we are capable of red sauce anymore.
- We got to have a very productive morning today ! We woke up and watched like half of the Young Sheldon series while also doing workouts, eating or just doing stuff on our phone. I love multitasking things that we genuinely enjoy doing it is very very fun to do.
8/5/23
- We had a relaxing day today as with the rest of them 🙂 But also we get super duper tired pretty early on. We went to Dumbo with Umma and Appa and then got to see Josh’s new apartment which was pretty nice and also pretty fun! I enjoyed being able to see the new house and then working out in the gym there
- We got to have a pretty fancy dinner today in a restaurant right next to Dumbo. Unfortunately the food was not too great but it was the fancy atmosphere that was pretty nice and also the conversations that we have with umma and appa is always always fun
- The weather today when we went to Dumbo was absolutely amazing I loved it. We could actually walk outside and it wasn’t too hot and the wind was very very nice and we were not dying of heat or sweating and the sky was so clear and everything was so pretty. Just that we were super tired and had an amazing night of sleep!
8/4/23
- We had a pretty good day today so I am happy about that. We got to see a lot of our home friends and also do a lot of the things that we really enjoy doing ! So we woke up, uploaded all of our PiK photos to a google drive, then cleaned out our camera roll, went to shoprite and bought all of the materials needed to make protein mac and cheese and then made the most fire meal ever, and then we went to the gym with Josh and had chipotle with him afterwards and then also went to go check out how camp is doing and got to see a lot of familiar faces
- We had so much yummy food today so I am really really happy about that; we got to have mac and cheese and chipotle which are pretty much two of my favorite foods in all of existence and even though we are a bit gasy afterwards it was completely and totally worth it.
- We were able to see Josh, Jae, Brendon, Julia, Jasmin, Millie, Andrew, Jeff, Steven, Jadon, Nick, Daniel, Jimmy, Charlie, Matthew, Erin, and so many other familiar faces so I was very very happy at church 🙂
8/3/23
- We had a very very good day today and did a lot of the things that we love doing 🙂 We woke up, worked on a puzzle with appa, then went to drop off Joey, bought some contact solution, cleaned up our room for a little bit and organized our clothing, went for a bike ride and saw Baylis, went to the library and created a Linkedin profile, visited Josh at 7-11, picked up Joey, went to Dave and Buster and played with Umma and Patrick, ate a family dinner at Tenjin sushi, ate lunch at Panera, and drove and walked around Syosset High school
- We got to see Faith randomly at Dave and Buster today playing with her siblings so that was quite the nice surprise! She looks like she is doing well and is leaving for Rice tomorrow actually which is so crazy that school is starting again what the heck it feels like I just got back
- We got to see a lot of familiar faces today so it was really nice to be back. We saw Brendon/Josh today and then we also went to pick up Joey from camp and then saw so so many camp teachers/TA’s that we used to know so that was fun! I love seeing faces that I remember LOL
8/2/23
- We are HOME! That is the most amazing thing ever I love being home and we are home for this entire month so we have an entire month to do whatever we friggen want to do and I am so so happy about that and super duper grateful that everything worked out in the end and we are HOME.
- We managed to survive both plane rides and the layover in Amsterdam today so that is great. It’s so interesting how in the past 24 hours, we have literally been to halfway through the entire WORLD. Like we were in Korea, then we went to Europe, and now we are in our house in the U.S. I’m so amazed at how far humanity has come to the point where I can just travel halfway across the world in a single day what in the world.
- We are starting to really realize how grateful we should be about everything that we have here at home in the U.S. How grateful we should be for having a U.S. passport, for being a U.S. citizen, for living here in Syosset, for having Umma and Appa able to just pay 3.5k on the spot for us to get a plane back to the U.S. like it’s actually so amazing and I am super duper grateful for these opportunities and doors that have been opened up to me.
8/1/23
- HAPPY AUGUST! We are super duper grateful that we were able to have pretty much everything work in order for this flight back to JFK. I am so so happy that we will not be…. stranded here in Korea. But yea, checking in was fairly easy, finding our terminal was good, the only thing was finding a way to kill 27 hours BUTT we managed to do so many of the things that we genuinely enjoy doing so I am pretty content with the day. The only thing is that we weren’t too healthy and our skin broke out a little because of the lack of sleep/showers. HOWEVER, we are heading home so the worst of it is slowly endinggg.
- We passed the 24 hours through watching youtube videos, eating, watching “while you were sleeping”, making a few belli reviews, making a finsta post, editting a video, writing a blog, texting/talking with friends and family, walking around aimlessly, and much much tik tok/instagram reels. But I am happy that we are finally over with this never ending wait and we can finally start boarding this flight in the next 30 minutes
- We got to say bye to Shreya today so that was quite nice seeing that we are both able to get our flights back home (even if it is not together, as long as everyone is safe and home, then I am happy). We also pulled our first “genuine” all nighter I guess? So look at that for an experience.
7/31/23
- Quite the interesting day to find something that there is to be grateful for…. HOWEVER we will still always always find things to be grateful for. We got to eat lunch and dinner at our favorite restaurants which was quite nice. We had very very yummy food at the pig resturant thingy and then cooked like 3 eggs
- People were pretty nice to use since we were leaving 🙂 Jing gave us a bread paste thingy..? That was very very interesting but it was so so sweet as well. And then we bought lots and lots of skin care thingies for Boya, Xuanying and Kevin!
- We got to call all of Kevin’s plan B friends so that was very very fun 🙂 We were in the middle of a workout when we called them so our workout got cut a little bit short but it is completely okay since I am happy that we actually have friends that we can talk to like that
7/30/23
- We had quite a relaxing last Sunday today! Umma and Appa came over and so we got to go to church and see them there, but we went to church with Stephanie and ate lunch and walked around her with for a little bit too so that was quite nice 🙂 And then we also we went to do some shopping around in Hongdae, and then after that we went to go eat at this Michelin star resturant and met Ivy and then we went to tour around Namsam tower with her which was quite fun actually! I enjoy being able to tour around with strangers that I’ve never ever met before
- We got to hang out with Santos and Marvin and Shreya at the end of the day and then watch them drink Soju? We didn’t drink any though
- We were able to do lots and lots of fun thingies today and also had so so much yummy food that I am quite grateful for being able to eat the last of my food here.
7/29/23
- We had a very very fun and stress free day today so I am very happy that I am able to do these fun days with family for a well-deserved break. We got to walk and talk a lot with umma today so it was very very nice and we shopped and got to see lots and lots of Korea. Also umma is taking a large portion of our stuff back home so our flight back to New York should be relatively light.
- We got to eat at another Michelin star restaurant and it was very very yummy. Appa didn’t like it but I enjoyed the nangmyeon very much so. It was so fire and also the mandoo and gogi was so so yummy. I am very very grateful for those types of foodss
- We got to have shake shack for dinner today and it was super duper yummy I enjoyed also having red mango today as well. We got to eat so so much yummy food with umma and appa so that is such a grateful thing to have in my life 🙂
7/28/23
- WE TOOK OUR FINAL IN THE MORNING AND NOW WE ARE OFFICIALLY FINISHED WITH THIS PROGRAM AND WE ARE LEAVING ON MONDAY SO THAT IS SO EXCITINGGG. I am super duper grateful for the opportunity to learn Korean here but that was quite something in terms of pushing ourselves to the very very maximum ability that we could learn thingies…
- We got to have lunch with Marvin today and then also say hi to Josh, Jing and Noah so that was quite nice. And then we had the “closing ceremony” where we said goodbye to all of the teachers and also received a few presents like the tiger mask and a pen? But anyways I am a little sad since we will never ever see Cho teacher again after this point but I am super duper glad to have had her as a teacher for 105 and 107, she is such an amazing teacher and I wish her the best in the upcoming years to come!
- We got to go see a Nanta show with Umma, appa, Joey and Halmony’s sister (Immo) so that was very very fun 🙂 The show was super duper funny and I actually enjoyed it a lot because of the comedy and also the audience participation. Additionally, we got to see Halmony’s sister and that was super duper nice I’m really really happy that we got to see her again and she looks like she has not aged even a single bit! We ate dinner with everyone at this sushi place which was THE BEST FOOD EVEr and then we had mandoo too which was also super yum and then we also got to try the Korean cheese corndog and kimbap at Myeongdong and I am super duper grateful that I can enjoy Korea now without the stress of classes or and getting to see new faces 🙂
7/27/23
- We had the most stressful day ever today so I am super duper grateful that we are able to have these stressful days to see how far we can test our limits (I’m really grasping at straws here to find things to be grateful for..) We woke up and had our review session, then studied for our oral exam, took our oral exam, ate lunch, came back to the room and reviewed vocab, then went to the review session where we finished our journal portfolio, our video final project, and our study guide, then we ate dinner and then we worked on memorizing the stupid study guide until we dropped
- We were able to grab lunch today with Marvin, Santos, Julia and Tara today so that was quite nice to have a quick group meal before we all leave
- We got to see Choi teacher today and it’s always super duper nice being able to see him and laugh together cause he is one super duper funny individual. But honestly today was SOOOO stressful I am not surprised if my skin breaks out before the final
7/26/23
- We had our very very last full Korean class today and tmrw is the start of finalsss. I am absolutely in shock that we technically finished our last full day of classes what in the world… HOWEVER we are super duper grateful that we were able to finish our Korean classes here at Yonsei 🙂 And now there’s only 5 days left in Korea. Also we are super grateful to have been able to meet Cho teacher and also learn a lot about relationships with other people/differences.
- We had like a 4 hour nap today and that was so so needed Idk why but I was absolutely exhausted today and even though it is only like 9:30 right now and we took our super duper long nap we are still decently tired. But anyways we had a pretty yummy dinner and got subway and then also we finished our journal and tomorrow’s homework so now we can focus fire on studying and working on the VR project for the majority of the rest of this night
- We had our last language table today so that was quite nice 🙂 We had bulgogi and were able to share a few laughs with the rest of the people on PiK and then also the last meal we will have with the teahcers. Oh yeah and also during class today Cho teacher let us teach for a little bit so that was fun, and then we took a lot of pictures on her phone and then we also got to sit on the floor for the last period
7/25/23
- There is officially only 6 friggen days left in Korea what in the world… ANYWAYS we are going strong and enjoying our last few days here 🙂 And also there is a bunch of studying and resting to be done before we say our final goodbyes so we need to make sure that we make the most of our time left here. THERE ISN’T EVEN 1 WEEK LEFT THAT’S CRAZY. So grateful for the experience of being here but there is no time to sulk, we gotta get some work done.
- We got to see Lee Professor for probably the final time in our entire lives… that sounds so scary what the heck. BUT I am super duper grateful that we got to see her here in Korea 🙂 She is super duper nice and friendly and I’m happy I got to meet her in a non-teaching setting where I can see what her personality is like and how she is actually. ANYWAYS I hope she does well here in KLI and continue to do her best teaching new students the Korean language 🙂
- ALSO we got a haircut today. We got our first down perm ever which I am quite curious about BUTT I think that we will get used to it as time goes along. Also the hair dressers here are super duper nice and they talked to us about our lives and were very hospitable so I am happy about that. However, not too sure how I feel about the new hair I guess we will find out by people’s reactions to it. Moreover, we got to eat at a michelin star restaurant today with Marvin and the food was very very yummy
7/24/23
- We had a pretty normal day today and it was a good normal so I am happy that we get to experience good normal days 🙂 We woke up and then went to class and took our quiz, and then we went to get lunch and called umma/appa during lunch time, and then afterwards we took a nap and then met Choi teacher and had our individual session with him, and then we hit the gym and did leg day, ate lots of dinner, and then went to the library to practice some piano, and then came back to study some vocab and then finish up with the skit practice for the rest of the day.
- We had so so much dinner today it was absolutely amazing. We had chicken cutlet spaghetti, and then blood sausage soup and galbi for dinner and it was super duper yummy and there was so much food that we were not able to finish all of it but it’s okay since we ate as much as we could. And then we also had some protein chips and a protein shake and also bought this peach mint so we had lots and lots of protein today.
- We got to do squats and deadlifts at the gym today and honestly it was pretty productive but I am a little bit worried that we may have been doing the form wrong but honestly I have no clue. i think we did it somewhat decently so I am grateful for being able to have a gym and the time to workout like that. AND ALSO THE FACT THAT THE FRIGGEN SQUAT RACK WAS OPEN LIKE THERES NO WAY THAT IT WAS JUST OPEN LIKE THAT. Normally it’s like never ever open EVER
7/23/23
- We had a lot of fun today being able to go to a lot of different churches and also talking with people who aren’t the Princeton people. I enjoy that we are actually able to make new friends and hang out with new people LOL… it’s a little bit sad that we were quite isolated from hanging out with other groups for such a long time but it’s changing now so I am excited for this upcoming week !
- We got to go to two separate church services today and see what both Sinchon International Church and also Jubilli service was like. And then after Jubilli we went to hang out with the rest of the college students in a small group, and then we got dinner with some new people that we met today and then bascially we hung out with them for the rest of the day 🙂 It was quite nice to be able to talk with Josh, Jing, Zoe and Joy today and then also see Hannah and Emily and then a bunch of new people that we have not met before 🙂
- We had hot pot for like the 3rd time in the span of a single weekend but it was very very yummy. And then we also got to have church food for lunch and then ate protein granola for a late-night dinner so that was also very very yum as well !
7/22/23
- We had a decently good Saturday today; we woke up and then went to make the stamp with everyone and then we went to grab shabu shabu with the rest of the PiK group as well as meeting the Princeton alumni Stanford, and then afterwards we walked with Marvin and Shrey around for a little bit and then we came back to workout and then we went out again with Marvin to grab dinner and go to an archery cafe and then came back and ended the night with some Pokemon showdown
- We had so much yummy food today is was absolutely amazing. We had hot pot or shabu shabu twice today and both of them were pretty much all you can eat so it was very very nice to be able to eat until our heart’s content 🙂
- We got to do a chest day today and finish some of our workout at the Yonsei gym but unfortunately it closed a bit early today so we finished the rest of our workout back at SK 🙂 And also archery today was super duper fun we got to absolutely destroy Marvin so we made fun of him a little bit about that (but then he absolutely rekted us in Pokemon showdown when we got back to the dorm sooooo the world is fair i guess)
7/21/23
- We had a very very good Friday today so I am pretty happy about that. We did a lot of the things that we genuinely enjoy doing today so that’s great 🙂 We went to class in the morning, then had our individual session with Cho teacher and had a lot of fun talking about a batman cave house and also telling her that she can live in our trailer at home, and then we got lunch with Marvin and Santos at the pig restaurant and that was also really really nice since they had free eggs and chajangbap so it was very very yummy, and then we did our homework after taking a fire nap, and then we did our laundry, hit the gym, ate at the cheese thuk galbi place which was super duper yummy and a lot of food, and then we went to the PC bang and played csgo for like 2.5 hours and then met up with Marvin and Tammy and then finished off the night with watching the Barbie movie
- We got to call umma for a little bit today and talk to her over text so that was nice. And then we also spammed Hsu hsu train on snap for a little bit today since we finally have data that can connect to places that do not have wifi. I am starting to really enjoy my time here in Korea now that it is coming towards an end so I am going to make sure that I enjoy the most out of every little second that I have left here
- Bro the food we ate today in general was absolutely gas. We had like 25 dollars spent on food today for a pretty much all you can eat meal for everything so that was very very yummy. And then we walked around Sinchon today and got to listen to a few street performances so that was fun too! And then also of course playing 2.5 hours of CS-Go really felt only like 30 minutes 🙂 We got like silver elite master on our rank after the first time we played so I would say that we are not too shabby 🙂
7/20/23
- We had a decently fun Thursday today; we had this day all to ourselves so we did a lot of our own interests and passions so it was pretty nice! We went to class, did our quiz, ate lunch, met up with Kim teacher to go over the midterm, did our homework, went to the gym, ate some food, went to practice piano, did some spotify/pinterest editting, and then walked around for a large portion of the night to explore Korea a little bit 🙂
- We had like 4 different foods for dinner today it’s kinda insane that you are eating so much food and not getting overwhelmingly fat. Like we had the omelet rice and then siracha chicken rice and then tuna kimbap and then bulgogi so that is quite a lot of food and it was all super duper yummy so I am happy about that
- We got to reply to another one of Hsu hsu train’s snaps today; I love that those are the highlights of your day LOL but yeah it’s super duper nice to be able to talk to some familiar faces and not become completely irrelevant to the people back at home.
7/19/23
- We got to grab dinner with umma and appa today so that was pretty fun; we had this interesting course dinner with bulgogi, sashimi and squid and then since I was still hungry afterward they got chicken while I got this knockoff chipotle from a restaurant nearby. Grateful for family and food 🙂
- We visited the publishing house and got to have a meeting with Lynn and some of the Editor in Chiefs in the publishing house. They had water. I like water. Also a bathroom. So that is fun.
- We had our Korean language table today and also did our skit during Korean class. All of that is very very fun and then also being able to talk to the teachers as if they are actually people and not just unreachable professors is very very refreshing I am going to miss this class LOL
7/18/23
- We had a decently fun day today 🙂 We met up with umma and appa and Joey and then we went to Gwangjang shijang and then also ate a lot of yummy food with them 🙂 And then we got to rest in their hotel for a bit so that was quite nice as well. It is super great that umma and appa are here and we are able to just see them whenever now
- We had a decently easy quiz today so that was fun. There were only 31 new vocab words so it was pretty okay to memorize. And then also we had a pretty yummy lunch and there was this super duper nice old lady who gave us a free pen and then introduced herself and told us her name so that’s great
- Tammy finally gave back our Prox LOL so now we actually have our ID on us 🙂 Grateful for her and her sense of humor to hide it from me for a week and then just never ever give it back.
7/17/23
- We had a very very fun day today 🙂 Especially since umma, appa and joey have finally landed in Korea and we were able to see them today! I am super duper happy that I finally see FAMILY LOL And then we got to eat dinner with all of them and then also walk around and see a few statues and then talk with them as we toured the Yonsei library and WAS FUN
- We got to finish our script with Julia today and that was funny making the script about forgetting our baby on a plane and then getting into an argument as a married couple. We also did our individual session with Cho teacher and then had a productive class today and then also studied for our Korean quiz tomorrow so I am glad that we were able to be decently productive today as well. Good for you Jonathan
- We got to go to the gym and do a chest day today so that was quite nice. I am thankful for the opportunities to go and work out 🙂 And then also we posted on our finsta so we are solidifying a lot of our memoriesss.
7/16/23
- We got to ride with Josh on the bus to go to church today and then met up with Hannah and a new girl named Angelica, and then after church we ate lunch together and then I bought underwear and then we also ate the quesadilla lunch and saw Marvin and then after that we went to Myeongdong together and then we walked around before our dinner with a few of the native Korean college students which was a little bit awkward but I am grateful for the experience of being able to talk with people from such different backgrounds. And then after the dinner, we got to go to the express bus terminal with Marvin and bought a bracelet there 🙂 And then we got back to the dorm, did our laundry, did a quick leg day and then ate dinner at the emart before calling it a night
- I am happy that we finally got to do a bereal in church with church people so now I have a picture with some memories of people from this church 🙂 I needed an excuse to take pictures with them without just making it super duper random LOL so yay for that 🙂
- We did lots and lots of exploring today with Marvin so I am super thankful that he is our roomate because we would not be doing half of the exploring that we currently are if Marvin was not here to take us places and know how to use public transportation so efficiently. We really need to learn how to step up LOL
7/15/23
- We came back from our Busan trip today! We rode on a tour bus and then we got to go to a beach (and also we found the most fire song on spotify that we played on repeat at least like 50 times), and then we had a pretty yummy lunch and then our train ride back was peaceful and the dinner that we ate with Marvin (the chicken soup thingy that Marvin said people eat after they get hangovers) was quite yummy as well. And then we had a very very good night’s sleep (other than the late night constipation…)
- We got to talk with Josh and Jin while seeing them in the lounge at like midnight which was quite nice 🙂 I am happy that I am able to make a few friends outside of Princeton and talk with people from various parts of the country or the world. And then we also met a few of their friends whose names I do not remember.
- The lunch that we had today was absolutely fire. It was the all you can eat sashimi as well as a soup thingy and also the live octopus. It was also really funny seeing Shreya’s reaction to seeing the live octopus “oh my god the food is moving” LOL
7/14/23
- We had a decently interesting day today… We went on a train to busan this morning which was quite fun and then got to sit next to Prof Kim on the ride there so that was fun as well! And then we ate a pretty yummy lunch with Marvin, Shreya and Santos and then we went to see a buddhist temple and then we went up to see a cave with Buddhist statues in it and then we went to a supermarket to buy dinner and we got some yummy blueberries and then we made dinner back at our AirBNB and then we went out to see a palace and this interesting astrology lookout thingy and then we finished the night with losing to Marvin in card games
- We had very very yummy food today. The blueberries were absolutely fire and we managed to eat the entire thing in a single day so that was quite nice. And then we also got to eat samgyupsal and steak for dinner and there was so so much meat that it was able to fill me pretty much full 🙂 And also for lunch today we had bulgogi and then we had a clam bibimbap! So all of this food was quite yum and good experiences so I am happy that we were able to experience them.
- We got to see hsu hsu train’s snaps for the first time in a while LOL So I am happy that we were able to finally respond to snaps for the first time in quite a while and catch up with her. Those snaps for some reason make me very very happy and I am quite thankful to have friends who are still willing to talk to me from high school. So THANKS HSU HSU TRAIN
7/13/23
- We had a pretty fun day today, especially since we had a 50 dollar dinner that was completely paid for so I am really happy about that. We woke up, did some studying for our midterm and then took the midterm, ate lunch, and then went on the trip to the LGU+ place where we were able to get a tour around the building, and then we had dinner, and then we came back to the dorm all safe and sound and then watched the rise of Darkrai and played pokemon showdown with Marvin until sleep time.
- We got to meet Alex and James today at the intern for the LGU+ place and it was very very nice to be able to meet other Princeton students our age and be able to talk to other guys (I know that sounds a bit weird but it’s been so long since I’ve been able to talk to another guy my age other than Marvin)
- We got to watch Yinne’s vid that was uploaded for the first time after a very very long time so it was nice to see that she is still doing well and good with making videos 🙂 Also we came to the realization today that there is quite literally 2 weeks left in Korea which is absolutely crazy. And also we are going on a trip to Busan tomorrow so that should be exciting I am happy about that.
7/12/23
- We had a really productive day today and we also did a lot of things that are new experiences so I am really grateful for that 🙂 We had our class today and did our skit and then ate lunch with a bunch of the teachers at Yonsei, and then we did some studying for the midterm tomorrow and wrote our study guide and then went to the Maker space high school to talk to a few of the Korean high school students and also see what Daniel has been up to for the past 5 weeks. We got to get dinner paid for as well and had myokguk which was quite yummy as well as some yummy galbi, and then we came back to the dorm where the finished the night with much much more studying for the midterm
- It was super duper fun being able to talk with the Korean high school students today I am so grateful for these random opportunities LOL also their english is SOO good and it seems like they live a very very stressful life so I will be wishing them the best of luck in their future. Also we got to drive this car that Daniel made and it was so cool to control it on an Ipad and then shoot people
- Both lunch and dinner were paid for today by other people so that was quite fortunate! I am glad that we are able to enjoy a few of the meals for free here so that we do not waste all of umma and appa’s money. 🙂 Also the food today was quite delicious; we had salmon and rice for lunch and then meokguk and galbi for dinner and all of it was yummy
7/11/23
- Happy national 7/11 day! We did not get a free slurpy; however it is happy that today is a Tuesday. We went to class in the morning, got lunch, had our individual session with Kim teacher after calling umma and appa, and then we relaxed in our room for a bit before heading to the library to practice piano for a little bit. Then we went to the gym, ate food, and came back to the room to bum out again for a little bit. Then we got dinner from the emart and then finished the night with doing lots and lots of Korean work
- We were decently productive today so I am pretty happy about that; we finished our journal and our Korean homework for the rest of this week so that is nice. And then also we got to study Lesson 5 of the vocab so tomorrow should just be full sending for the midterm on Thursday. We got this. Don’t sweat it Jonathan.
- We did not nap today and so I am proud of us for that. It was pretty hard and we did have to down 2 different coffees but at the end of the day we are still awake and hopefully will have a pretty good night’s sleep so I am happy about that 🙂
7/10/23
- We had the most fire nap today ever (and the fact that we had two of them makes me a bit worried about how we are going to end up sleeping tonight…) but anyways, we napped for like a solid 5 hours today which is a bit interesting since we have class tomorrow morning so we shall see how that goes I guess
- We got to do a lot of the things that we love today like going to the gym, eating yummy food, taking good naps, walking around campus, and talking with friends 🙂 I am glad that I can enjoy my time here and not have to worry too much about missing out and such; however, there is a quiz tomorrow and a midterm on Thursday so relaxing time is just about done Jonathan and you need to start getting your head in the game
- We got to have a very very chill class time today with no quizzes or tests or anything so I like being able to just learn without the worry of not doing enough or that there is going to be a stress inducing activity that we will have to do.
7/9/23
- We had lots and lots of sleep today so that was super nice 🙂 And then we went to church and then saw Hannah again so fun! And then we also met a few new people whose names I do not exactly remember… But they do live in SK with us so we shall most likely see them around within the next 3 weeks
- We got to hang out a lot with Marvin today as he planned dinner and then we walked around for a little bit and went to this super aesthetic black and white cafe and got to take a bunch of photos there which was quite cute! And then also the green tea milk drink that we had was so amazing and yummy. And also we had Chinese food for lunch that had a lot of mushrooms in it so it is good that you are experiencing new things. And also the jajangmyun at the restaurant was absolutely fire.
- We had pretty yummy lunch today which was the chicken/cheese duk bap! And also we met up with Tammy and Marvin and worked on our group skit that is due tomorrow so that is nice that we got that out of the way earlier rather than later. And then also it was really fun cause Tammy jokingly hates us so it’s funny
7/8/23
- What a day… We went to Incheon so that was quite exciting! It was nice being able to see the city where appa grew up in. But at the same time we were dying a bit today after drinking a liter of protein milk and not being able to use the bathroom for the entire ride back… HOWEVER everyone was really nice to us and Marvin carried our bag and offered us water and everyone helped me sit down so I’m glad that everyone is super duper nice
- We got to see Daniel and Anna today so it was nice being able to see a few familiar faces 🙂 Also also we went to china town and ate chinese food and white jajangmyun which was quite interesting.
- We took lots and lots of memorable pictures today so I am happy about that. And also the fact that the weather was decently bearable today was pretty good news. And also we woke up at literally 1:30 so we got so so much sleep
7/7/23
- We had like a super duper fun day today: after we went to Korean class and had our individual session with Cho teacher and then we got lunch (Octopus thingy) and then we went to Hongdae and then bought Brendon’s present and my mom’s present and then we got bingsu for the first time today and then a photo thingy and so it was all quite fun! And then we also went to a dog cafe with Cevina and it was super duper cute seeing all of the dogs and also seeing Cevina as well! (This is so bad but the racist dog was literally the funniest thing in the entire world.)
- We did decently well on our quiz today and I think that we were able to answer all of the questions for the most part. Also we ate dinner which was quite yummy 🙂 And then also the bingsu was absolutely fire so that was quite the nice experience.
- We got to meet a celebrity (question mark) today! And then recorded Cevina’s interview with her so that was quite the event that happened. Cute stuff.
7/6/23
- We had a really fund time being able to go to Gwangjang market with Marvin and Shreya today and trying out traditional Korean food at a traditional Korean market: granted, the food was honestly not too great but it was a good experience. We had chicken feet, pig’s feet, and the most oily japchae ever which were all quite nasty… However, we did have some good mandoo and subway and kimbap so I think that made up for it a little bit. We also bought the Mango candy for Joey.
- We had a decently productive day today after going to class and then doing our homework for tomorrow and then doing our journal and then studying for the quiz and then doing homework so it was all not being a lazy butthole.
- We have finally made it to the end of the week and now we are going to have a relaxing weekend 🙂 Also we posted on our instagram story for like the first time ever today about our Korea trip and a very very pretty sky soooo yay for that!
7/5/23
- We had a decently productive day today that was very relaxing: we went to class this morning, took our quiz, went to Korean language table where we got to talk with Kim teacher for a little bit, went back to our dorm and then did our homework, hit the gym, ate again, went to the library to work on a blog post, went to eat Mexican food while also eye-shopping for a little bit, and then came back to the dorm to bum out for the rest of the night
- We got to have the most killer tacos today it was honestly so fire: and then we had mandoo kalguksu for lunch at the Korean language table and then we also ate cheese donkatsu (FIRE) and kimchi bokumbap for dinner so the food that we ate today was quite yummy if I do say so myself 🙂
- We got to think a lot today… I am so grateful that we are in Korea and being able to live independently here. But also I’m gaining more and more gratitude for my life at home. I kinda like really miss being at home right now with my family and my home friends and being in my own bed where I can sleep for a full night’s sleep without waking up like 3 times.. I’m grateful that I have somewhere like that to miss and that I have a loving family who misses me too
7/4/23
- Happy Fourth of July…? It didn’t really feel like the fourth of July since we are in Korea right now and we didn’t even get a snapchat notification about it yet sooo yeah. We had a pretty relaxing day today so that was quite nice: we went to class, took our quiz, had our first lesson with Kim teacher, had a yum lunch, took a fire nap, got dinner, gymmed, ate again, studied for a very little bit before bumming out for the rest of the day
- We got a leg day done and over with today so we are happy about that ! Now it will be time to restart the cycle and not have to worry about doing legs again. And also Kim teacher was really nice and laughs a lot during class so that was quite refreshing and happy to see that she will be a good teacher. And also the fact that we got a 5/5 on the homework for a change (WOW).
- We got to have pretty yummy food today: we had beef and rice for lunch, and then there was white soup for dinner and the kimbap and more galbi for dinner dinner! Also we posted on our finsta today and got to lounge around a lot to recharge 🙂
7/3/23
- We finally got our gym membership today! And even though the gym is a bit crowded, it was still good to invest in your health and commit yourself to working out in a proper gym with actual proper machines. But to make the money worth it, we now have to go super duper often so that will be something to look forward to 🙂
- We got to call umma, appa and Joey today so that was quite nice. And also we finished our Korean homework and then bought some sunscreen and lip balm so we are improving in some of our aspects of life and always making progress !
- We figured out that we want to go to the dog cafe on Friday and it took SOOOO long to figure out how this Korean address system thingy works (and also, there’s no way that we are not using data/wifi any longer; especially if we are making plans to hang out with Cevina. SOOO we will be full sending it now..)
7/2/23
- We had a decently good day today since we studied for our final, ate lunch, took our Korean final and so we are now done with KOR 105, then went out to grab dinner and buy some clothes, and then we came back and did a workout at the gym, and then finished the night with some bible reading and more food
- We got a present from Marvin today so that was very very sweet of him. It was a Piplup/Oswatt water type pokemon statue thingy so I am very very happy about it! Super duper cute we will be cherishing this
- We got to try the kimbap place that we have been meaning to go to for quite a while and it was very very yum. And also we went to subway and had Korean subway for the first time today and that was pretty good as well! And also we texted Cevina today and we will be meeting up with her in the foreseeable future (prob Friday) and so that is pretty exciting 🙂
7/1/23
- We came back from our trip today and it was very very fun I am happy about it. We were able to take over 20,000 steps walking around today and went to so many museums and then saw many mountains and super nice views and got lunch and dinner paid for so that was really really nice! And also we were able to take a train back to the dorm and we are currently in bed and tomorrow we have our final but we will study for that tomorrow and for now we will be relaxing a little bit.
- We had pretty good food for lunch and dinner today 🙂 We had pig feet and bulgogi and fish and kimchi and a bunch of banchan and rice for lunch today so that was very very yummy and then for dinner we had mandoo and this chicken thingy that we shared with Tammy so yum for that too! And then we also ate eggs and kimchi boccumbap for after-dinner food
- We got to talk a lot with the rest of the PiK members throughout the day so it is nice being able to get that quick talking time with everybody. And also we went to this garden today which was quite possibly the prettiest garden that we have ever been to in our entire life. And then also we played a piano at the garden !
6/30/23
- We had the first day of our trip today so that was quite exciting. We took the KTX for the first time today and it looked like the train from Busan type of train. And then we went to a Buddhist temple and this super cool museum so that was fun, and then we ate lunch soondoobu with the group, and then we went to explore a market which was honestly quite dead but it was okay, and now we are at this super big and fancy hotel and I am really happy here 🙂
- We got to have our meeting with our EADs team for the final time so yay for that! It was quite nice being able to see faces that we have not seen in quite a while and then hear how everyone else is doing over the summer and what they are up to in terms of their walk with God. And then we got to pray for Sophia so that was also nice too !
- We had a very very yummy lunch of soondooobu and the Korean pancake thingy so that was good. And it was also paid for! And then we had a hamburger for breakfast, and then kimbap/tteukbokki for dinner as well as 6 slices of pizza. So you are eating a lot a lot of food Jonathan. But it is alright, you should be able to enjoy lots and lots of yummy food here without the worry of becoming fat.
6/29/23
- Even though we were dead tired today, we were able to still have a fun and somewhat productive day: we woke up and went to class, took our quiz and did our speaking final exam, and we also grabbed lunch with the rest of the PiK students and then worked on our journals. And then we went to the gym, did laundry, grabbed dinner, and then worked on some personal things for the rest of the night.
- We had pretty cheap and yummy lunches and dinners today! Ever since you found that cafeteria you are able to say a few bucks on buying cheap and yummy Korean food so that is very very nice 🙂 we do not have to waste food anymore.
- The speaking final went decently well and we did not completely screw up so that is exciting. And also we are going on our trip tomorrow tooo…. I actually have no clue where we are going but whatever 🙂 So we are excited for that.
6/28/23
- We had a quite fun day today and did lots and lots of exploring: we woke up and went to Korean class, and then we did our Korean language table lunch and then went to Makerspace High School and saw Danile, and then explored with Marvin around Gangnam, and then we went to get dinner and then came back to the dorm where we studied for our quiz tomorrow.
- We got to see and talk to Daniel today at his Asan Makerspace High School internship so that was quite fun ! It was nice being able to talk to and see a new face that is someone not in the PiK group. And also we texted Seonju today and we will probably meet up with her in Korea sometime in the future as well so that is quite exciting 🙂
- We got to grab dinner with Marvin and have chicken which was quite yum and then we also got a sandwich for lunch (bacon avocado and philly cheese). And then also we figured out that the buses have wifi connection so we realized that if we ever ride a bus we won’t just get completely lost on the bus so that is nice 🙂
6/27/23
- We had a pretty decent day today: we woke up and studied for our quiz today and then went to class early after getting coffee and blueberries and then studied before class. Then we did our Korean presentation, took the quiz and did our lesson in class. Then we got lunch with everybody and then went to do our Korean journals, and then went to our individual session, and then went to the gym, and then we went to eat dinner and then do some more work and then go get another dinner and then came back to the room to end the day
- We had pretty good food today: we had this galbi thingy for lunch and then we had spicy galbi for dinner as well as the ginseng soup that you weren’t able to eat the other day with Marvin because it had peanuts in it. All the food was really yummy so that was quite nice.
- Also we got to call umma and appa today for umma’s birthday party because they called us in the morning to celebrate her birthday so that was nice 🙂
6/26/23
- Today is Umma’s Birthdayyy! So we got to call umma during lunch today and talk to her while with appa for a little bit. Also we sent her a birthday text message and we did not write her a card/get her a present but I hope that uploading the youtube video for her to see on her birthday meant something..?
- We had mackerel for dinner today so I am happy about that. Also we tried to get a second dinner but the food was very very mid and pretty spicy so we did not really like dinner part 2. But it is okay; also I think we figured out how to navigate somewhat decently without connection? But seriously I do not think that we can do another month like this we have to get our phone fixed somehow.
- We took a fire nap today so that was quite nice. Also we saw Stephanie today so that was fun as well! She finally moved into her dorm at Yonsei and we got to talk with her for a bit at the E-mart as well as a few of the friends that she met here already. And then Stephanie and I went to go say hi to Prof Choi which was also fun. And then we also had the chance to go the gym and do a chest day 🙂 We are no longer the smallest person in the gym anymore: we are forging for ourselves a new identity.
6/25/23
- We finally finished editing our first youtube video here so that was quite the accomplishment Jonathan good for you 🙂 We are uploading the video tomorrow morning so that will be something to look forward to. I am proud of us for being able to do some of the things that we love here despite being super duper busy.
- We went to church in the morning and got to have lunch with a few of the elders which was quite nice of them. And then also we went to bible study with some others and got to talk to Son and learn about “Absolute God” which is quite the interesting theme. But also we were able to expose ourself to people with pretty radical views and see that they are a little bit closed minded to opposing viewpoints so it was interesting to hear their side of the arguments concerning the existence of God and my question I posed regarding prophecies.
- We were able to go try Korean spaghetti for the first time today and MY GOD IT ABSOLUTELY SUCKED like I can’t even explain to you how bad it was because it was just THAT bad. Like how do Korean people suck at making literally any other food that is not Korean food… but anyways we are grateful for the experience because now we know not to try any foreign food here and to only stick to Korean food… 🙂 Also I think we figured out how to work the public transportation system here in terms of buses..? I’m pretty sure
6/24/23
- Honestly even though today wasn’t exactly great we still are able to be grateful for all of the experiences that we get to have here in Korea. So we woke up decently early with pretty bad sleep so we were a bit tired in the morning when we left for Gwanghwamun, and then we rented a hanbok that cost 30,000 won (without us knowing) and then explored around for 2 and a half hours while sweating in the hanbok, and then ate lunch but then got a pretty bad headache right after and then went to sleep for 7 hours after we got back from the museum… So I am grateful for the 7 hour nap though 🙂
- We also had a fire lunch today of ramen and tuna kimbap which was perhaps the best kimbap that I have ever tried in my entire life. Wow I am super duper happy to have such yummy food here in Korea. And also we were able to explore around Gwanghwamun and get some good videos/360 camera shots/pictures there so that was quite nice! Also the views were immaculate not going to lie and you reached your step count for the day 100%
- We got to finish the Korean drama Comrades tonight because you stayed up until 3am in the Emart just binging the entire series and honestly that was soooo worth it: that was a very very addicting k-drama to watch so it is good that you got it out of the way before our final on Friday.
6/23/23
- We had a relaxing Friday today: we went to class, then did our individual session, went back to our dorm after lunch and took a fire nap, and then woke up and did homework, started working on the video for a little bit before dinner, and then went out for dinner and then did some more editting at 2 cafes before heading back to the dorm and going to the gym and then calling it a day
- We ate a pretty fire dinner today so I am pretty grateful for that: we had this chicken cheese dub bap which was surprisingly super duper yummy and we also ate some of Marvin’s chicken kalguksoo which was pretty yummy as well. And also we were able to try Korean taco bell today so that was quite the experience: we have come to the definitive conclusion that U.S. fast food is superior to Korean fast food in all aspects besides price and health. So yeah I do not think that we will be getting Korean fast food anymore during our stay here.
- We texted Cevina today and we will probably meet up with her in the foreseeable future here in Korea so that is quite exciting 🙂 I am happy about that! Will be able to see new faces and catch upppp
6/22/23
- We had a decently productive day today: we woke up and went to class and did our presentations and took our quiz, and then went to lunch with Tammy and Marvin and Santos, and then did our journals and had a chest day today, and then we went to the all you can eat kbbq place and then we came back to our dorm and started watching Comrades and YOU COULDN’T STOP EVEN THOUGH IT WAS A SCHOOL NIGHT GET BECAUSE IT WAS SOO GOOD
- We are really really happy because we finally ate all you can eat and so you were actually full by the end of dinner today 🙂 Also twas quite the yummy snacks being able to munch on Korean slim chips and protein granola afterwards
- The quiz went well so we are happy about that and also we looked in the mirror after our workout today and there were very clearly abs there so good for you Jonathan 🙂 Summer body season??
6/21/23
- We had a pretty relaxing day today: but at the same time was decently fun as well. We went to class, and then got lunch with everyone for Korean language table, then did our homework and took a 3 hour nap, and then worked on our presentation slides, and then went to grab dinner and got mandoo and galbi bap, and then we went to a cafe to do some studying, and then went to the library to play piano and work on our youtube videos, and then we came back to the dorm and finished the night with light studying 🙂
- We were able to take the most fire nap today (but Marvin told you that you make noises when you are napping so you have to figure out what that is about)
- We studied to the point where we were actually able to memorize all 80 korean vocab words for the quiz tomorrow (which is an actual insane amount of vocabulary what in the world).
6/20/23
- We had a really really good day today and you deserved it Jonathan. We woke up and studied a bit for our Korean quiz, got our coffee and went to class and took the quiz (we did pretty decently on it as well), and then we went to get lunch (white soup) while calling umma, and then we started a load of laundry and did a few errands while waiting (reading our devo, clipping nails, filling water/taking vitamins), and then we started the dryer while writing our Korean journal for homework due today, and then we folded our clothes and then went to work out and did leg day, and then we went to get food and had tuna kimbap and galbi, and then we went to a twosome place for dessert and then got ice cream while working on our youtube video, then we went to the library to work on the youtube video and also play piano, and then we went to the white soup place for 6000 won and ate there for a second dinner, then went to Uniqlo and got some clothes and then we came back to the dorm and bought mouthwash and a razor and now we are making a quizlet for lesson 7 vocab.
- We got to call umma today so that was really really nice because it has been a while since you have been able to call home and see a familiar face other than our PiK group. Don’t worry about sticking with the group or missing out on anything Jonathan. You are so much more capable of having fun on your own than with other people.
- We literally got to work on so many of our hobbies and the things we love doing while also learning a lot: I think that this is what being in Korea should be about. Yes, socialization is important, but there is no chance that I am going to ruin my entire experience here in Korea by sticking with the group and doing what everyone else wants instead of what I want.
6/19/23
- We took our stupid Korean midterm today so that is completely over with 🙂 HOWEVER there was a 2 hour class along with that and then you did an hours work of homework and there is a vocab quiz tomorrow and you see no end to your suffering in sight…
- We had two burgers for dinner and Cho teacher bought us kimbap for lunch today 🙂 Also we had oxtail soup for lunch today which was quite yummy
- We got to meet Tammy’s friend Isaac today. He was quite interesting and such a cool dude I really really like him (only having met him for a single meal though)
6/18/23
- We did a lot of studying today for tomorrow’s midterm so that was quite fun (sarcasm). But we honestly learned a lot of studying techniques that were quite helpful (such as studying vocab words when we are walking or during the rest times in between our sets).
- We had a really really good morning today that didn’t make you feel like you are wasting your time. So we woke up and then went to church (by walking) while reviewing the vocab, then went to a cafe and then got a coffee while reviewing the grammar, and then we went to church and met this guy named June from Brown and then we sat next to Hannah, and then we got lunch with elder park and Hannah and her roommate.
- We got to have a pretty good chest day today and got dinner with Marvin while studying with Julia for a little bit at the e-mart. Also today was just a really really good day in general and we are not stressing out too much about tomorrow’s midterm which is pretty good 🙂
6/17/23
- We were able to go to the DMZ today and see North Korea so that was quite interesting! It’s really nice to be able to see more of our home country and learn about my culture’s history.
- We got dinner with Shreya and Marvin today and we were able to get a pretty decently priced samgyupsal.
- We started to let the realization of money sink in…. it’s good to be aware. Don’t let it subtract from your enjoyment of Korea. But omg omg omg.
6/16/23
- We had a relaxing friday today and we are happy since we finally started the weekend 🙂 We woke up and went to Korean class, then had our individual session with Prof Cho, then we ate lunch with Marvin and walked him to his appointment with Santos, then explored a bit around starfield library, and then came back shopping and got dinner, then went to the gym and then finished the day lazy.
- We got to try out some of the new restaurants here like Lord Sandwich and this udon place. The food was absolutely fire 🙂 Also we got to buy 3 bags of this protein granola that taste so so good I am really happy about these purchases 🙂
- We got to relax a lot today and have a good Friday before we had to full send studying on Sunday
6/15/23
- We woke up and went to Korean class after getting our coffee, then in Korean class we did our Jeju presentation as well as the vocab quiz, and then we had lunch at the little restaurant next to the e-mart, we went to our room and did our laundry while downloading all of the videos for a youtube video, and then we went to the gym and did a chest day, and then got dinner with everyone (except Marvin because of his surgery), and then when we came back to the room we were able to buy some more food and then we finished the day with homework 🙂
- We got to have lunch with Marvin, Julia and Tara today and then we got dinner with Santos and Julia so it is nice to be able to grab meals with people on a daily basis. But also honestly it would be nice to start seeing new faces
- We thought that the Korean quiz today was decently easy so it was good that you studied so much for it: but now the midterm is on Monday so there is quite a bit of studying to go for that to go well… honestly though I don’t know if I’m going to be able to do that well on it 🙂
6/14/23
- We had a decently productive day today: we woke up and went to class, then the Korean language table, then we walked around campus and asked about the gym, then did our Korean slideshow presentation, then worked out, then attempted to study for a bit, then got dinner with Marvin and tried out Korean burger king, and then finished the day with some more studying for tomorrow’s quiz.
- We had a leg day for the first time in quite a while today: we also tried out deadlifts here and started sweating like a pig. I think we should do leg days more often to get that good sweat in.
- We are now somewhat starting to follow our calendar schedule and getting our life on an organized track so that is some improvement there 🙂
6/13/23
- Even though not as productive, we still had a somewhat full day today: we went to class, then had an individual session and lunch with Prof Choi, and then took a nap, did our Korean quiz, ate dinner, went to the library to work on our Korean homework and start with google calendar, and then came back to the room and got ready for bed.
- We had a really really great nap today which was quite nice because we were a little bit sleep deprived from not being able to sleep well the past few nights. But it is getting a little bit sad how you aren’t able to sleep well 😦
- You are trying a lot of new types of food in Korea (well foods you ate before, but you never ate them in Korea before so they do taste different). We had chajangmyun for lunch for the first time in Korea (honestly was pretty mid compared to U.S. chajangmyun) and then we had octopus mixed with vegetables and rice for dinner (completely forget what it was called but it was honestly quite yummy).
6/12/23
- Honestly now we are getting towards more of the productive days: we went to class, then ate lunch, called umma, went to practice piano, hit the gym, toured the library, got dinner, and then did our Korean homework. It doesn’t sound like much when I write it down like that, but at least we are not lying in bed doing absolutely nothing the entire day
- We were able to play piano for a solid hour today for the first time in quite a while which was pretty nice: I enjoy being able to practice musiccc. Tomorrow we should do guitar. Also we had a pretty good back and bi workout today: it’s just you overdid it on the bi LOL.
- We got to have a really great look at the Yonsei library today with Marvin: twas quite fun being able to explore around the entire library and see how big it was. Honestly, it’s like twice Firestone. But to be fair there are basically 20 libraries inside of the Yonsei library soooo. But yeah, there was a friggen garden inside of the library (like idk how the plants don’t die), a roof top with a view and a cafe, a literal piano that you can attach headphones too?? A makerspace, about 100000000 study cubicles and study spots, and much much more.
6/11/23
- We had a very very relaxing day today which was pretty nice: we went to church, got lunch with Hannah, did some spotify/pinterest editting at a cafe, went to the gym, got dinner, and then finished the day with laundry and Korean homework!
- We got to grab a pretty yummy dinner today with Shreya and Marvin: we got curry with hamburgers/beef, then we had mandoo and then had a tuna kimbap which was pretty yummyyy.
- We got to have lunch with Hannah today and talk with her for a bit! And then we got to walk with her for a little bit until we went to a cafe so that was quite nice: also just being able to go to church and see a familiar face who is somebody your age is a really happy thing to have in my time here LOL.
6/10/23
- We always have such full days here in Korea I think we need some rest and relaxation for a day but since the days are always so full and we are getting so much experience with the culture and food and language. We woke up and then went to this super pretty and studio ghibli like area and took a bunch of photos and saw this super cute swing. And then we went to go see Monica and learn about her striker for a little bit, met some of the traditional Jeju natives and their painters/students, and then we went to have the best lunch that we ever had in Korea so far, and then the memorial for the Jeju massacre, and then we went to the airport and got back to Seoul.
- We had a really really amazing time learning about how the traditional Jeju natives live their lives: they demonstrated how they pooped and they saved the poop for 2 years for fertilizer, and how they literally save all of their urine, and then how hard they work and it was so amazing to see how they live their lives. Also, the lunch that they provided for us was the best food that I’ve ever tasted before in my entire life. Like the samgyupsal and the meokguk was insanely good…. And then they make their own strawberry Jam and bread and omgomgomg I can’t even explain how great they make their food.
- We talked with Marvin on the plane ride back from Jeju Island and we actually had a really nice conversation about our past experiences in high school, things about our personality and being ourselves, and friendships with people and such. Also we got to see Monica today which was a treat since we have not seen her in quite a while. She seems like she is doing great in her “lazy mama” internship and hopefully she is enjoying her time/stay with the people there.
6/9/23
- We had an entirely full day today at Jeju Island :). We woke up at 9, then went to a walkway along the beach, took some polaroid pictures there, then got kal gooksu which was absolutely gas, went to this water droplet museum, and then go-kart racing as well as laser tag which was super duper amazing, and then we had dinner at this sashimi place and then ate kimbap afterwards.
- We got first place in laser tag today with a total of 32 kills and a KDA of 4. We are such a good assassin. ALSO THAT MADE US FEEL LIKE A KID AGAIN. I was super duper happy to do laser tag, but we also did get second place two times in a row in go-kart racing with Santos coming in first. That is completely unacceptable I refuse to be second. But I was so….
- We had sashimi for dinner and that fish was quite possibly the most disgusting food you have ever put inside your mouth. HOWEVER, it was a good experience and we fully immersed ourselves in the Jeju seafood world. We can no longer say that we did not have seafood at Jeju Island because we certainly did and we tried new things… But I will literally throw up if I ever eat anything like that ever again.
6/8/23
- We came all the way to Jeju today so that is super duper exciting! Jeju is so pretty and nice and amazing and awesome and you had to ruin so much of it by having a stupid friggen headache today… But anyways I’m grateful that we made it here safe and sound without too many complications. Of course there were a few complications like the plane getting delayed, you not having the correct name on your boarding pass, and that stupid headache that lasted 4 hours that made you want to throw up.. but at least that didn’t take up the majority of the day.
- We. got to experience a super pretty cafe today that was next to a beach and a mountain and that was absolutely amazing: we got a matcha latte there and twas quite delicious. Also we had a fire kbbq for dinner today and that was so so yum I am super duper happy to be here. And then also we saw the prettiest sunset ever.
- We went to this green tea museum at Jeju and also this flower garden which was perhaps the prettiest place that you have ever been to in your entire life. We took lots and lots of pictures and videos and we also posted on our finsta today so that was quite fun as well 🙂
6/7/23
- We had a pretty lazy day today: we woke up and went to class, then got lunch, then took a nap, did our Korean homework, went to the gym, went to grab dinner, and then bummed out for the rest of the day. You should be more productive here in Korea Jonathan! But honestly you’ve been out and about for a decently long time so far so I guess it’s good to take a rest.
- We got to meet Cho teacher and learn from her teaching style for the first time today. Honestly it was pretty good and she is really good at making us feel comfortable despite being the first time. Also we grabbed lunch with everyone today and went to the Korean speaking table which was a first: we got to practice speaking Korean there and interview Choi teacher about his dating life so that was quite fun.
- We had the bestest nap ever day with drool coming out and everything. Also we finished our Korean homework which was quite nice. And lastly, we tried Korean big mac for the first time today; honestly American big macs are a lot better but it was a good experience. Also we went to this mackerel place for dinner with Marvin and I LOVED IT was quite yum food.
6/6/23
- We went to the National Museum of Korea today so that was quite exciting; honestly it was super thrilling being able to see so much of my home culture and where my origins are from LOL. Also it was honestly pretty emotional seeing what Korean people did thousands of years ago and then realizing that there actually were people living life, having families, smiling, struggling, and overall going throughout the human experience thousands of years before we were even born.
- We got to have an omelet sandwich and kimbap for lunch and then a cuban sandwich for dinner. We are eating quite interesting food here, but it is all super duper tasty and so it is 100% worth it.
- We got to experience what one of those Korean exercise parks is like today, where there are like pull up bars, and then a communal bench press with a set amount of weight on it, and then a bunch of weird cardio machines that a lot of the old people use. I guess that is how people in Korea stay so fit even though they are so old, it’s because they can just go out randomly on any day and then start exercising in a park like that.
6/5/23
- We had a super fun day today because we were celebrating Julia’s birthday so we got to go out a bunch! We went to get kbbq, went to a cat cafe, and then saw the Han River! AND DUDE THE KBBQ WAS ONLY 16000 WON (14.5ish US dollars) for ALL YOU CAN EAT THAT WAS ABSOLUTELY INSANE. Also the cats that we saw today were absolutely adorable I love them. But we did realize that we are allergic to cats today
- We had our first Korean class this morning and even though it was 3 hours long, it was doable and honestly pretty fun. We learnt a lot and got through some material during class today. But I am a little bit concerned with how I am going to survive another 8 weeks of classes like that.
- Tonight was really really helpful in terms of bonding with the rest of the PiK members. I honestly had a really really nice time talking with everyone late at night by the Han River it was such a enjoyable spot to be in and made me feel as though I am reallyyyy living life. I am super duper grateful to be here 🙂
6/4/23
- What a completely random day today I am super duper confused… We woke up, went to church, met Hannah and Mickey and got lunch with them, went to Bible study with Hannah, then went to the gym, relaxed for a bit, went for a walk and found Amy, went with her to a night market where we met Jack, ate at the night market, walked around, and got pizza with them, and then came back to the dorm.
- I am really happy I was able to introduce myself to Hannah/Mickey at church today and just find out randomly that we have mutuals like that Yale LOL. We wouldn’t have had nearly the amount of fun experiences if I didn’t step out of my comfort zones from time to time. Also we learnt a lot at Bible Study today when it comes to Absolute God and credibility to the Bible and there was a really great sermon at church today about changing little by little every day as a Christian.
- We ran into Amy so randomly today and that was really quite exciting! I got to explore around with her and have so much fun just enjoying being in Korea, looking at all the pretty scenery, eating such yummy and interesting food (there were almonds on the pizza…?) and meeting her friend Jack! It’s nice to be able to expand my social circle and get to know more and more people.
6/3/23
- We had a really really fun/filled day today. We woke up, went to get some breakfast and buy some toiletries, then went to Yonsei to get some merch and bought this superrr Korean jacket, then got donkatsu for lunch with everyone else, then bought some Korean clothes, then met up with Julia/Anna and shopped with them for a while and went to a super cute cafe with them, then met up with everyone and went out for the first time tonight! We had chicken and beer, karaoke, and walked around a really really bright city. We had pretty good conversations with everyone too.
- We almost had peanuts today at the chicken and beer place but we caught it just in time luckily and so we didn’t die today 🙂
- We had so much fun at karaoke today. We tried breaking the touch barrier and it worked and was somewhat natural….?
6/2/23
- We had our first full day here in Korea and DUDE if this is how every single day for the next 60 days is going to be like, then I never wanna leave. Today was so so fun and exciting: we woke up, did a morning routine, got breakfast with Julia/Marvin/Shreya, then went to orientation, then took a tour of campus, ate lunch, did our TB test, hung out with everyone, went shopping/ate dinner, then worked out and now we are back in our dorm. That was quite the day today!
- We got to meet everyone else in the PiK program so that is nice: I think we get along well with everybody so this is going to be an enjoyable 60 days: especially since we are all going to be spending so much time together so it’s important that we don’t go for each other’s throats.
- I got to eat so so much yummy food today: we had rice balls, this galbi soup, soondoobuu gijae, and a paris baguette sandwich today so all of that was pretty yummy. Honestly though I feel like I should be eating more because that is not enough food for meeee. ALSO THE FOOD IS CHEAP SO THAT’S NICE.
6/1/23
- We landed in Koreaaaa! I’m so happy to be back in the motherland LOL. We landed safely with Shreya, and then passed through immigration without any issues, found our bag with no problems, got on the right bus after buying the right bus ticket, and made our way to SK Global housing without getting lost completely and dying so I think that these are MAJOR accomplishments. Look at us adulting nowww: but honestly it was Shreya who saved us from not knowing how to do anything.
- We got to grab dinner with Shreya and Julia today and DUDE THE FOOD WAS AMAZING AND SO CHEAP. We had Kimchi bogumbap and tteukmandoo guk and combined they were 10 won, which is like 9 US dollars and they tasted SO SO GOOD. Seriously this is my diet from the next semester on?? I’m going to get so fat.
- We got to walk with Marvin today after he came at like 7:45 and then we bought some skincare, hand soap, toilet paper, and other toiletries that would be needed for the next two months here. Also it was really really nice to just walk around Korea late at night and see what this country looks like: the only thing is that I was super duper tired from the jetlag BUTT because of that we had the best sleep EVER. Like as soon as my head hit the pillow, I was KNOCKED out.
5/31/23
- We got on our flight from Amsterdam to Seoul and all went pretty smoothly: the only thing is that we lost 6 hours and there was an 11-hour flight and so the day was reallyyy short LOL.
- We had a really nice conversation with Shreya about religion and we came to the conclusion that pretty much all religions are the same… Like even though “personal experiences” that people have to be convinced of their own religion are universal “experiences.” Christianity heavily emphasizes how once someone goes through pain and suffering and then turns to Jesus, then they are set free and have this spiritual encounter with God. Buddhism actually has the same thing where people go through pain and suffering, and then find spiritual revelation on how to reach Enlightenment. I’m sure Islam has a similar route for people who profess to have personal experiences as well. So in the end, it must come down to faith and evidence: faith is very subjective, but evidence points to which religion? That is for you to decide I guess.
- We had a croissant from Europe today and it was so so much better than any Costco croissant that we’ve every had before. Also we ate an omelette and also a bunch of airplane food which was surprisingly not too bad.
5/30/23
- We are ADULTING now Jonathan: we packed for our Korea trip and also got on the phone with the IRS to confirm our identity to get our tax returns. That was such an adult thing to do wowow you are no longer a little kid anymore dude. Talking with the IRS and NOT getting convicted of a felony is quite the accomplishment.
- We got on our first flight to Amsterdam and met up with Shreya! Luckily everything has gone smoothly so far (Not entirely sure how the baggage check-in will turn out but I hope that it goes smoothly.) Thankful to God for giving me this opportunity to fly to Korea and also not do it completely alone!
- We got to see Michael and Saheer today! It’s so interesting that just in random places that you go to, you meet people that you knew. But really thankful to see familiar faces 🙂
5/29/23
- We had a pretty good upper body workout today with Josh at the gym. Also we got to see Brendon and his huge friend working out as well so that was quite nice. (Also side tangent: we saw Sophie at Broadway mall driving but we couldn’t say hi cause they drove past us)
- We got to have dinner with Ellie today and then get Boba at Gongcha with her afterward so that was quite nice! I’m happy that I get to see some of my old friends and catch up with them and have good conversations with them as well. We also got to see Julia at Gongcha and quickly catch up with her as well.
- We had Halmony and Halabogi and Soogomo and uncle come over for Appa’s birthday today and ate an enjoyable meal with them! We had crab, mackerel, tofu and other yum Korean foods.
5/28/23
- We went to church in the morning and had a really nice time in worship and service. Also got to see a bunch of familiar faces like Irene, Claire, Josh, Hajin, Julia, Millie, Jasmin, Kendall, etc.
- We got lunch with Jaemin and Josh today and ate a yum meal at Fireside. Also we took a fire nap at church and after church too: So much sleep I love it
- We went to sleep for 11 hours today and had a safe flight back to NY so always thanks be to God for keeping us safe, healthy and happy.
5/27/23
- We said bye to EADs today: Was quite nice giving a hug to everyone on the team like Heather, James, etc. I really enjoyed this trip but I am also very very thankful that it is over. We took some photos with everyone and had a really great time fellowshipping afterwards before bouncing.
- We got to talk/eat with Sophia and Katie at the airport before our flight which was really nice. We had like a 3 hour conversation and it went by quite quickly because of them so I am really happy about not having to worry about waiting there forever. Also we had Panda express which was quite yum. But now that missions is over Jonathan you have to start getting back into shape.
- We saw Sam, Robin, Ellie, and… (forgot her name but the Cornell EADs leader) at the airport today and we got to take the same plane as them back home! That was a real treat because you didn’t have to do that flight completely alone and they helped you have some nice company on your flight home.
5/26/23
- We first got to have 6 hours of sleep (WOW) never thought I’d be so grateful for something as small as that. We were really blessed at every single one of the services today and got to hear James/Heather’s testimonies today and it has been soooo powerful. The faith of my team members and their knowledge that they gained throughout this trip has been sooo encouraging to hear. I am so grateful for them, their faith, and their overwhelming love for the Lord.
- We got saved today. At the Crusade. The speaker was talking about how if he stole tacos from that taco stand, he would get sent to prison. Then that transitioned him into the point that for the crimes that he wasn’t caught for, then we will be punished in our afterlife. Immediately that brought me to the argument that laws punish criminals, and religion ensures that those who think they got away stay in line. (This is an argument from the Oxford debate that argued that God did not exist). And so finally, I think that this was my last straw and I came to the realization that I’m never getting my answers. There’s two sides to everything, convincing evidence presented on both sides, I can’t be in the middle, throw my hands in the air and say I’m an agnostic. So I looked up to the sky and the ceilings of a few buildings that were short enough to be right under me, realized that I may very well be wrong about whichever side I choose, but said it’s worth it to choose Jesus. Not because of Pascal’s Wager because I think the atheist counter to that argument is quite convincing, but because I will have faith if he truly died for me, if he truly loves me, no matter what, he’s worth it. I’ll believe.
- We got to have some insane conversations with James, Ben, Nathan and Robin today. They are all such passionate, devoted followers of Christ. We got to hear about their experiences at FOG and their thoughts on Arumdaun AFAM. With James, we heard about his personal testimony throughout EADs and his calling for potentially becoming a pastor. We heard about his conviction with vows concerning his brother’s salvation, his struggles involving running from his calling, his parent’s potential disapproval, and we got to see a side of James that gave you even greater respect for him as a person and as an older brother in Christ. I am so so grateful that I get to meet people like that at Princeton he’s such an inspiration.
5/25/23
- We got so blessed during evening worship and just throughout today in general. We are overcoming, with God, each of the strongholds that have their place in my life. Also we gained so much insights into myself and got to know who I am as a person so much better.
- We had amazingly delicious tacos for dinner today, and since Joy and Katie didn’t want their tacos, we had 5 tacos total and while it was a bit difficult to shove it all down our throats, we still did it and Gloria a Dios. I’m actually eating so well on this mission trip(and also we pooped today for the first time so that’s good to know that my digestive system is actually working).
- We got to sit next to Heather on the bus ride to Tijuana and that was honestly such a blessing. She is such a spiritual and God-loving sister, her habit of just falling asleep, waking up, and immediately taking out her Bible to read was so encouraging. I need people like her in my life to point me to Christ and guide me to the feet of Jesus. Also we got to try a multitude of New Mexican snacks which was pretty yum. Also got running sink water at a gas station and slept on the bus!
5/24/23
- We lost our phone in the morning and so had a mini panic attack and then Bryan found it for us so that was such an amazing feeling of relief. Also Bryan was nice enough to give us a mini talk while I was stressing out over my phone and we gained such insight about our concerns with 4CM and power behind prayer. Apparently Ryan and Mirae agree with me concerning 4CM, but we both serve the same God.
- We had our last day at the church today. We did VBS for the kids, skits worship, testimony, and had lots of fun worshipping. Also Heather asked us to walk with her and one of the kids to her work place which was really needed for you personally LOL. Also we got the gift of tongues at service today so that was interesting… Also we gained lots of insights on our personal thoughts and experienced what missions with 4CM would be like, so it was quite the enlightening experience.
- JOSHUA GOT INTO MEDICAL SCHOOL??? WHAT WHATTT! CONGRATULATIONS TO HIM I AM SO PROUD OF MY OLDER BROTHER WOWOWOWOWOW. Future Dr. Lee is in the house and is going to make enough money for all of us now. I’m so happy for him. God you are so so good. MEDICAL SCHOOL PRAYERS WORKED.
5/23/23
- God was working so mightily during ministry time and VBS today when we went to our churches. God was able to move during our worship and also throughout the skits and prayer time. So many small, super adorable children we got to see, meet and laugh with. We were able to see some of the kids in the school during recess as well. Also we had the honor of taking videos and photos during ministry time. That was absolutely amazing.
- Bro the food we ate today is so so good. We had frosted flakes, yogurt, grapes, and tacos fro breakfast. Then we had sandwiches for lunch, and then the best tacos and bibimbap for dinner. The food is so amazing her what in the world. I am in awe of the food.
- So much worship, prayer, and praise today (as expected). Even though you are absolutely drained and soooo tired right now, you still are here listening and waiting on God. You also got a lot of insight into your own life, feelings and emotions concerning Christianity and 4CM.
5/22/23
- We had a really great worship session this morning and enjoyed seeing the rest of our EADs team. Also we got to see so many familiar old faces: Sam, Matthew, Pastor Paul, Nathan, AJ, Robin. Also we met lots of new people today so that was quite nice as well.
- Dude we had the most gas tacos today that was quite possibly the best Mexican food I’ve ever eaten in my entire life. Then we also ate like radishes raw and had quite a nice Mexican drink. Also we had subway for lunch and then we had breakfast at the holiday inn this morning.
- Wo we had a smooth transition into Mexico today. We crossed the border without any complications and also the bus ride went quite smoothly as well. It is such a blessing to be able to see the different ways that people here live compared back at home. It was a bit of a eye-opening experience and we are gaining more and more insight into the rest of the world that God created. Lots of worship, lots of praise today. I pray that God will continue to mold me into the son that he can be well pleased with throughout this mission trip.
- I just spoke in tongues. Unquestionably. What the heck wow the spiritual world is so real what in the world.
5/21/23
- We got to go to church this morning after getting a solid 9 hours of sleep. At church we saw so many familiar faces and said hi to a lot of people before we booked it outta there to start packing for EADs. Also Pastor Sam’s sermon today was absolutely fire. The story of Rachel and Leah and how Rachel was “nice,” which mean that you go along with what other people want because you think that you’re “better” than them so it’s okay. Moral of the story: don’t be “nice.” Only when Rachel had that superiority stripped from her did she kneel at God’s feet and was blessed with a child.
- We had such an amazing lunch today since there is a party with Halmony and Halabogi from Appa’s side. We got sushi, japchae, gable, pasta, and did I mention sushi?? Also we ate shake shack!Twas a pretty nice double cheese burger.
- We went on the airplane to San Diego all by ourself. This is so much adulting wow. Umma was nice enough to drop us off and get me started with checking in our bag, and then we did the rest on our own. You are living a bit of an old-mean/dad/loner life style now. Thankful all of it went smoothly and there were no major hiccups.
5/20/23
- We had a pretty fun and I guess productive day today? (In terms of enjoying oneself). We woke up and had breakfast, then said goodbye to Ronnie Immo and Evan as they dropped us off at Umma’s office. We got our teeth attachments for invisalign and recorded the video for umma, and then we went to get a haircut and got some yummy food. After, we took a nap and then spent the rest of the day catching up with Josh, Jae and Brendon.
- We had a lot of fun talking with Josh/Jae/Brendon today! It was super duper nice catching up with them. Also we got to see Erica so that was quite nice as well as Sam was driving her 🙂
- We always have quite enjoyable talks with Jaemin/Josh. It does get a little bit weird cause they always talk about tea/girls and such but it does help keep you exposed and balanced to differing people in the world LOL
5/19/23
- We had a pretty fun day today and so so many naps haha: we woke up at like 6:30 to go to Josh’s graduation. It was fun seeing literally our entire family today! We saw Halabogi and Halmony on both sides of the family at the graduation, then took a fat nap, then woke up and found that Ronnie immo and Evan were here, and then said hi to them and then took another fat nap, and then when we woke up, Mimi immo, Ethan and Chloe were here again!
- We had a lot of fun talking with and catching up with everybody: also we realized Mr. Man is a bit of an interesting character… He is such a conservative person in terms of parenting (sucks to suck for his son LOL) hopefully he doesn’t influence my own father. But it was interesting hearing diverse perspectives on certain issues. Also we ate lots and lots of yummy Italian food today: I think we gained at least like 5 pounds that was a TON of food
- We unpacked most of our things by now so that is quite nice 🙂 And then we are heading to Mexico in 2 days soooo lots and lots of work that is going on right now.
5/18/23
- WELCOME HOME JONATHAN! We finally got home and now we are enjoying life for a little bit before our trip to Mexico/Korea
- We got to have a pretty fun morning today with the last of our friends/saying bye to everyone. We went to junbi with Michael, Boya, Xuanying, Jocelyn and Kevin. Also we walked with them for quite a bit and then went to help Michael pack. Also we took a little walk of our own to the theological seminary and the graduate college and did some of our audiobook on the God Delusion. (We got 35,000 steps today Jonathan)
- Halmony, Appa, Umma, and Halabogi came to pick us up today and we packed relatively quickly and got to show them around campus! It was quite nice
5/17/23
- Welp… we finished our freshman year of college. That stupid Chem final is all done with and we are free 🙂 So I am very very grateful for basically everything this year: the amount of maturity and growth was absolutely amazing (honestly I completely bombed that final I might as well not have studied that was a massacre)
- We got to grab insomnia cookies with Lindsay and Michelle after the chem final today and that was super duper nice: Lindsay has a car here (WHATTT) and so she drove us to get cookies and we had a nice midnight walk around Trenton with our cookies and had good talks/laughs about life
- We had our prayer meeting with the Yale/Emory Eads team and it was cool getting to see new faces and seeing the people that we will be working with for the next week
5/16/23
- What’s the difference between being past my breaking point vs. absolute insanity? I have no clue I think I have reached that point where I do not think my brain can handle anything more I shove into it like a little otter that I want to kill because I shove a knife down its throat. Imagine killing little otters like that, but like death is completely fine since like there is nothing actually wrong with it so why don’t we all just start killing otters: but I guess we should only kill baby otters and not the bigger ones cause they can fight back.
- I am grateful that I am still sane and have not descended into madness yet.
- I have chemistry exam tmrw which means 24 hours until this nightmare is over 🙂
5/15/23
- I don’t know how much longer I can survive for dude. But GRATEFUL THAT WE ARE STILL BREATHING. But seriously I am reaching my breaking point.
- We woke up, took our Korean final and got that out of the way, went to lunch, got a coffee and went to the Korean VR meeting, but then took a nap anyways since the final was at 9am, then woke up, went to study in the library, ate dinner, back to library to study, went to gym, frist for late meal, and then back to the library to study. Soooo I am grateful for FINISHING THE STUPID KOREAN FINAL and… studying a lot for chem
- We got to have lunch with Marvin, Tim and Katherine today! Also Tim is super sweet he wrote us a card and that was quite cute: also what in the world him and Payge are dating why is everyone dating.
5/14/23
- We had a somewhat decent day today: we woke up, went to church, ate lunch, went to the library, ate dinner, then took a nap and then back to the library to study (so much studying…)
- We got to have lunch with Soraya, Cynthia and Boya today so that was nice! Also we studied in the library with Chris and Stephanie today so it was also fun seeing them and being able to share in our misery
- We got to have a very very brief conversation with Grace today so that was quite cute! AND NOW WE HAVE OUR KOREAN FINAL IN 9 HOURS SO BEST OF LUCK JONATHAN WE GOT THISSS
5/13/23
- We finished our fasting for EADs: I AM SO HUNGRY RIGHT NOW: It is currently 11:32, I have a hoagie from hoagie haven awaiting me as soon as it hits midnight. Also I am going to eat the banana and yogurt and I am very very excited but also am feeling quite weak right now. Also we did our devo for EADs today too so that was good 🙂
- We got a bit of studying done today: not nearly as productive as other days but we still are accomplishing and progressing with each passing day. We went through flash cards for Korean and we also did our chem cheat sheet that we get on test day
- We went to the gym today and had a back/bi day. Since we didn’t eat cause we’re fasting, obviously the workout was not too great and we are a little bit tired and honestly I am getting tired from just typing this right now but we got it over with
5/12/23
- FINISHED THE STUPID BIO FINAL: that was an absolute massacre what the actual hell but it is over now. Why the heck was that so specific if I took that test literally any other day of this year I would have completely failed it; but now I only partially failed it because I actually studied for a bit. I am actually so curious as to how I did in that class because I BSed so much of that test that is insane BUT it is over now, we don’t have to worry about MOL anymore, and we can focus fire studying on the rest of our finals. Also Cevina gave us a behind the back hug after the final today and for some reason that memory is sticking in your brain; it was cute!
- We got to talk with Monica, Stephanie and Inwoo because we saw them after we left the library so that was a fun conversation: it also helped time fly by a little bit faster because I refused to study ANY more biology for that stupid final omggg.
- We had a very very yum Hoagie today so that was nice 🙂
5/11/23
- We had a decent day today: we woke up and went to the town library to study: we went over all of the lecture quizzes and did the practice bio test before heading to late meal to eat. Then after we went to do some more studying at the friend center, then we went to hit the gym, ate dinner, went to prayer meeting, and tutored Anthony. Then we went to meet up with Boya and Kevin and stayed with them until like 2am.
- We realized how smart Boya is and she tutored us in bio for a bit before our test tomorrow so that should be exciting. Also you realized that you just suck at studying
- We had a good chest day today 🙂
5/10/23
- We got a lot of bio studying done today so that was decently productive. Finished going over all of the bio psets so that was nice
- We got to visit the Princeton library today so that was pretty excitinggg. Honestly it was on par with Firestone 🙂
- Really really nice weather today it was so so pretty and nice enjoying the weather. But also it is absolutely unforgivable that there are finals during these nice weather times.
5/9/23
- We had a mostly productive day today: we woke up, went to the library to study, then ate lunch, then back to the library, then gym, then dinner, then coffee house, then late meal, then dorm to rest and then back to library to study
- We got to have dinner at the graduate college today and that was such a treat! Kevin drove us on his scooter and dude the campus is literally the most aesthetic place I have ever seen in my entire life like what in the world. Also their grilled chicken is absolutely gas I am going to eat their chicken every single day from now on (jk since it’s too far without a scooter D:)
- We got a lot of bio studying done today: we figured out a lot of what we don’t know and have to review so that was mostly productive 🙂 Also coffee house was fun and then we also picked up some cards to write for mother’s day that is coming up pretty soon.
5/8/23
- We had a pretty slow day today: we woke up from the EADs lock in at like 7 in the morning. But we shared testimonies, prayed for each other, and had a total of like 1 hour of sleep for the night. Then we went back to our dorm and slept until 1:30 to go eat with Cynthia, then went back to our dorm and then slept until 7. I had so much sleep it was relaxing
- We submitted our last chem lab report so now I believe all dean’s date thingies are over and we just have to worry about actually studying for finals
- We went to the gym today and had a pretty productive chest, shoulder, and tri workout. We got to do lateral raises with dumbbells for the first time today and it was a learning experience.
5/7/23
- We had a regular day today but still grateful that our regular days are great days 🙂 We went to church this morning, then went to buy a new water bottle/gum, then went to the library and edited our testimony, finished writing our religion paper, and submitted the rest of our chemistry lab reports, then we studied a bit for bio and went to the EADs training
- We got to learn Bryan’s skit during EADs today so that was quite the retreat 🙂 I really really really love this skit it is amazing
- We had a lock in with the rest of the EADs team so that was pretty fun! Also we fasted for the first time today in quite a while and the food we ate at the end of the day was absolutely amazing.
5/6/23
- Days are passing by so fast this is so so crazy. Today we woke up from the sleepover, went to watch Brad bench 260, then went to thrift some old princeton merch at this weird clothes event, then got free matcha at coffee club at met a PhD student named Ren, then took a nap in our dorm, then went to grab dinner with umma and appa, then went to Senior Banquet for Manna and took a few pictures before all the seniors go bye bye, then we went to coffee club again and got 2 slices of free pizza, and then finished the night with doing my religion paper while playing poker with some of Kevin’s friends.
- We got chajangmyun with umma and appa today and that was super duper nice and really yummy! Also they brought us a suit so we got some fancy pictures at the senior banquet. And at senior banquet there was some wise words of wisdom from the seniors: Irene –> Don’t turn to gossiping, turn to the other person and do the Christian thing. Ashely –> Our views may be different from one another as Christians, but we all serve the same God and make sure that we are getting our faith from the Word and not the World. Brad –> Life will be very very busy at time, especially at Princeton.
- We got to play poker and for the first half we did really really well that was fun! I have not played poker for a pretty long time 🙂 Also the free merch that we got today was somewhat fire.
5/5/23
- We had another unproductive day today but we still are enjoying life: Jonathan it’s okay to take breaks! We woke up and then went to Bible study, then ate lunch, then did our laundry, organized some work, met up with Kiran and got coffee with her, talked with Bernice for a little bit and got late meal, then took a nap, wrote 1/3 of our Religion final, got dinner, did breaking bread and got a dance lesson, then learned some of King jesus from katherine, and ended the day with the manna sleepover
- We had a lot of fun learning dances today: it would be really really nice if we were able to learn dance without having to stress out about finals all the time but it’s okay! We worked a lot on some of our dance skills.
- We had a lot of fun talking with Kiran today! We went to small world and walked/talked with her for a little bit. And then we got to talk with Bernice for a little bit today too so that was also really nice 🙂
5/4/23
- We had a really fun day today: we helped Yedoh move a few boxes to Manna’s Relax day, then went to our Korean party and had food, then had fun at the Manna event, then went to the gym, then went to get food at SC house, then went to prayer meeting at Katherine’s, then tutored, and now you are in bed.
- We got to talk with Brandon for the first actual time today and it was pretty nice; he is such a chill and cool dude. Also we had a really nice time at the Manna Relax/Rejuvenate event todayyy. We made tote bags and played spike ball.
- We had a really fun time at the Korean party today: also we went to SC house with all of the Manna men today and got a free meal and ate like authentic Chinese food for the first time in quite a while and so it was quite the experience. The food was a little oily but nonetheless it was a tasty meal.
5/3/23
- There was a full day today even though it was not very productive: we studied for our Korean speaking exam, then took our Korean speaking exam, then went to Manna Corner and talked with James/Lu/Yedoh/Michael, then went to lunch at Roma, then went to farmer’s market, then did a devo at frist, then got late meal, then went to Soph Com, then went with Michael and Xuanying to their Orf review session and just did spotify/pinterest editing, then wrote a blog post, then got dinner, then did bench with brad, then finished night with chinese food and a movie
- We got to have dinner with Michael today so that was pretty nice! We had a nice conversation with him and got to walk around with him for a little bit today. Also went to the gym with him. Bench with Brad was very very fun as well and we got to learn a lot about proper form and such.
- We saw Kevin buying flowers at the farmer’s market today so that was vv funny 🙂
5/2/23
- We had a fun day today: not very productive but was still a lot of fun. We went to Korean class, then met the old Manna Intern Josh, then went to lunch, then went to Monica’s birthday thingy and then hit the gym, then went to FSG party and then ate dinner, then went to Frist to edit the Final Korean project video and then went to play basketball with manna ballers
- We got to have lunch with Andy today so that was nice! And also we got to have dinner with Katherine and have a pretty nice conversation with her too
- We had a lot of fun at the FSG party today: we played mario kart, and then played a card game, then watched the frosh vid with John!
5/1/23
- We had a pretty fun day today: we went to Korean class, then chem review session, then did some recording for the final project, then had our photoshoot with Ashley, then took a nap, then did our chem pset and went to the gym, and then finished the night with watching ant man!
- We got to grab both lunch and dinner with Jessica today! She is super cute and it’s always fun to be able to grab a meal with her and get to develop relationships with other people here
- We got to get both late meals today and that was pretty yummy. Also we went to Richard’s b-day celebration today which was really really nice! HAPPY BIRTHDAY RICHARDDD
4/30/23
- Sunday was the usual but it was full of people today: we went to church in the morning and then went to lawn parties and took many many pictures, then we did our laundry and wrote our testimony before grabbing dinner and then going to EADs training.
- We had lots and lots of fun at lawn parties today by taking pictures with people 🙂 We took pics with Manna/Six14, then Michael, Kevin, Xuanying, Jocelyn, Tracie, Richard, Brad, Breanna, Michelle, Skywalker, and Chris!
- We had a very nice time of praise and worship at EADs practice today. Also we got to have dominos for dinner because Zach bought us pizza. And then we also had taco bell and nomad pizza from lawn parties today so that was also pretty yum. (And then brunch w michael)
4/29/23
- Fun Saturday today: we went to Manna servant team meeting, then did some recording for the Korean final project, then Richard’s Orange Key tour, then got junbi with Kevin/Jocelyn/Michael/Xuanying and then helped set up for praise team and then did large group and then ended the day with watching Spirited Away with Xuanying and Boya
- We got to have chipotle for lunch today with the Manna ST and it was SO YUM. Also we got to grab dinner with Ashley, Michael, Jocelyn and Stephanie at Roma today so that was also really nice
- We got to hear Yedoh’s testimony at intern sharing night and it was really really impactful and interesting and we are so thankful that we got to have Yedoh as our intern for this year 🙂
4/28/23
- We had a really relaxing Friday today: we went to Korean class, then chem lecture, then bible study, then we got lunch, did our Korean homework, went to 2 ice cream socials today with Michael and Xuanying, then took a nap, then woke up and did our chem class participation and finished the night with eating/relaxing.
- We had a very interesting talk with Pastor Steven today about a lot of different issues!
- We had lunch with Pastor Steven and Michael today and had a really nice bible study with them too; also we took the best nap ever today it was so so relaxinggg.
4/27/23
- We had a fun day today: went to Korean class, then bio lecture, then lunch, then chem lab, then late meal, then gym, then butler carnival, then dinner, then worked on editing a youtube vid, then late meal and open room, then sleep 🙂
- We got to grab lunch with Tim and Payge today; and we also talked with Stephanie, Kevin and Alice for a little bit of lunch today
- We got to have dinner with James, Bryan, Michael, Zach and Brendan. Also we went to Manna open room and had a really nice time there even though all the sushi was gone… But did try buldak ramen and was v spicy as expected
4/26/23
- Dude the days are always so busy here what in the worlddd: we went to Korean class, then chem lecture, then we finished our Korean homework, then got lunch/farmer’s market, then went to Religion class and then bio lab, then went to the gym, got dinner, learned a bit about makerspace, and spent the night at frist editting a youtube video and getting late meal and then finished the day with studying for Korean
- We got to have lunch with Quinn and Kate today and talk to them for a bit, so it was nice quickly catching up with them. Also we got to have dinner with Jessica today and talk to her which was fun as well. We talked to Michelle (not just waving) for the first time today so it was nice walking her to her room and quickly getting to know her better. Caught up with Jam at the gym today and had a nice chest, shoulder tri workout. Also also also we talked w Cevina as per usual and had a bittersweet last bio lab; we won’t be her lab partner anymoreeeee 😦 But we shall see her around and force her to be friends with us still
- We finally got to breath a little bit: not a lot but it is less stressful that the other days in this week. We finished our bio lab report and submitted our bio laboratory notebook today. But then there’s studying for the Korean quiz that is tomorrow and then the entire Korean project so there’s always work to be done
4/25/23
- We ended up finishing our chem lab exam… It didn’t go too well but nonetheless grateful that we finished that and no longer have to think about work :)… except for the fact that you have your bio lab notebook, your lab report, and the chem pset all due tmrw.
- We had a eventful day today! We went to study for chem lab test for a bit, then heard the most fire lecture about cancer in bio today (sounds a lil weird but it was v interesting), then went to Korean class, then had lunch and late meal, then studied for chem until we eventually took the test, and now we are at Six14 elections!
- We got to grab junbi at FSG today so that was a nice drink 🙂 Was really sweet and was a yum late meal today with the hamburger and fries!
4/24/23
- We got to have a fun day today (but productive at the same time): we went to Korean class, then chem lecture, then bio precept, then religion lecture, then did our Korean homework, then got late meal coffee/yogurt, then religion precept, then finished audio recording for Korean, then went to Korean individual session for summer study abroad, then worked on bio lab notebook, then went to dinner, then took and nap and finished the day with laundry and studying for chem
- We got to go to Charter with Michelle today! It was extremely extremely fun and it was really nice to be able to eat at a new eating club and also the food there was so yum I enjoyed it very much 🙂 It’s really nice to be able to catch up with the seniors and see them before they leave Princeton and start their journey elsewhere
- We got to talk with Daniel for a little bit today! We were studying in the common room for chem and he came since his roommate has a girl over and it was nice catching up with him as well! Daniel is always v fun it’s nice to be able to talk with him
4/23/23
- We had a relaxing Sunday today! We went to church, then got lunch, took a nap, finished our bio pset, got dinner, and then went to EADs training. And then we finished the night with some chem
- We got to have lunch with Boya, Bryan, Michael, and Andrew today. We talked with them about the 2023 seniors demographics! Was vv fun conversation
- We got to have dinner with Colton today: he asked us a bunch of would you rather questions and we asked him about why he wanted to become an FSG leader. Also we got to go to EADs training today and had a v fun time of worship, prayer and fellowship as per usual
4/22/23
- What a Saturdayyy: we woke up and ate breakfast, then read our Religion paper, then we wrote our Religion paper while enjoying the weather, then we did praise team for Manna large group today, and shared our testimony and watched the frosh video together 🙂
- We got to share our testimony today in front of Manna Large Group so that was something!
- We got to do praise for large group for the first time and our fingers are hurting because you have not played guitar that much for a really really long time. But I enjoyed doing praise (even though you aren’t the bestest singer)
4/21/23
- Although not that productive, we did have an enjoyable day today: we did our Korean homework, went to chem lecture, then lunch, then we took a nap, then finished editing the frosh video, then dinner, then finished our chem lab report!
- We had lunch with Michael, Kevin, and Xuanying today! FRIENDSSSSS
- We had dinner with Ellie and talked with her a bit about life in generall: it was a really nice conversation 🙂 Also we went to campus club and got sushi and an empanada today so that was yummy 🙂
4/20/23
- We had a productive day today! We went to Korean class, then bio lecture, the did our chem practical exam, then went to our last day of the psychology study, then had our meeting with John and ended the day with some editing for the frosh video!
- We had lunch with Tim and Payge and Vivian again! Also we got to meet Joel and we are so so happy that he said that if we were to beat up Tim that he wouldn’t protect him. I LOVE JOEL FOR THAT. But he did say he gets 70% of any earnings while I only get 30% if we were to beat up Tim.
- We got to have a really productive conversation with John today and learn a lot about biblical slavery, God’s overall plan compared to the smaller instances throughout the Bible that we had issues with, and learned about biblical genocide. It is a really hard thing to rectify but through conversations with him, we came to understand that God’s glory is greater than the worth of human value, is it not? As Christians, we have to come to that conclusion that God is above all of us: humanism sounds good but valuing human life over God’s glory is where it gets a little iffy.
4/19/23
- We had a good day today: went to Korean class, then chem lecture, then took a nap, then bio lab, then worked on the frosh video, then did the psychology study, then korean homework, and then ended the day with some more editting of the frosh video
- We got to have lunch with Melissa today! I love Melissa she is so fun to talk to and has such a personality to her
- We got to grab dinner with Kevin today and talk to him a little bit about his relationship life and about Christianity for a little bit!
4/18/23
- We had a pretty fun day today! We went to Korean class, then did our chem pset, then chem precept, then psychology study, then bible study, then meeting with pastor Sam, and then we got to edit the frosh video for a little bit
- We had a really really nice conversation with Pastor Sam today and learnt a lot about Biblical slavery and the possibilities behind the story Jephthah in the book of Judges (burnt offering may mean she was just sent to become a nun..?)
- We got to learn about about Revelations in Bible Study today with John! I love going to Princeton and learning so much more about Religion than I ever knew when I was back at home. This is absolutely amazing (Anti-trinity vs. Holy Trinity)
4/17/23
- We had a decently fun day today: we went to Korean, then chem, them bio precept, then religion lecture, then did korean hw, then religion precept, then bio lab, then chem assignment, then gym, then ustore to buy shampoo/gum, then dinner, and then we did our laundry
- We got to have lunch with Jessica today and talk with her for a little bit so that was fun! It’s always nice being able to catch up with her weekly
- We got to grab dinner with Skywalker today and then play spikeball with him after! We also talked with some pre-frosh today and got to play spikeball with them too so that was pretty fun! Also our workout in the gym today was productive and enjoyable 🙂
4/16/23
- We finished our Religion paper about the film analysis so we are on our way to finishing the course completely
- We went to church in the morning and got to walk with Michael for a little bit after it ended (and we heard some of the tea that was surrounding Kevin LOL). Also we took the best 3 hour nap of our lives today 🙂
- We went to EADs training and had a really nice time of prayer and worship there! Made you think a little bit and reflect on the joy that God put in your heart.
4/15/23
- We got to finish the stupid bio quiz today and I think we did decently on it so yay for that!
- Umma and appa came over and we got to eat lunch at the Amish buffet place and the food was absolutely amazing omg omg omg omgomg
- SENIOR AUCTION WAS SO FUNNNN. We are now going to get a personal trainer lesson from Brad, a dance workshop from Yaxin, a tour from Richard, a sleepover with the seniors, and a photoshoot from Ashley.
4/14/23
- We got to have a decent day today 🙂 We went to Korean class, then chemistry class, then we worked outside for a little bit and then went to do our bio lab day 3 with Cevina, then MRI psychology study, then gym, then Korean k-pop karaoke and then worked on a few assignments
- We got to have dinner with Marvin today and talk with him for a little bit! Marvin is cracked he is absolutely insane at academics I am in awe
- We got to enjoy the weather outside again :)) Unfortunately tomorrow is thunderstorms but the weather was absolutely amazing up to this point
4/13/23
- We had a filled day today! We went to our VR Korean individual session, then bio lecture, then our academic advisor meeting, then our chem lab, then our bio lab day 2, then the psychology study, and then worked on videos for a little bit 🙂
- We got to have dinner with our dship group and talk about masculinity and how Christian men are supposed to display their emotions. Was a really nice conversation topic and we learnt a lot so it was interesting
- We got to enjoy the beautiful weather outside today by lying down on the grass with Michael when it wasn’t too hot and just talk for a bit! I really like it when the weather is warm enough to wear shorts but not too hot for me to start sweating. Evenings are the perfect temperature.
4/12/23
- We had a decently productive day until 9pm LOL. We went to Korean, chem, pre-dental funding meeting, did our Korean homework, went to religion lecture, had bio lab, signed birthday card, went to our psychology study, went to our pre-dental meeting, filmed for the gym scene in the newbie video
- We got to grab late meal with Cevina after bio lab and we had a really really nice conversation with her and got to know her a little bit more! She is a vv fun person I’m grateful to have met her
- We went to the farmer’s market today and bought guacamole with the voucher that they gave us! Also the weather was absolutely amazing today what in the world.
4/11/23
- Busy day! We went to Korean class, then bio lecture, then chem precept, then manna ice cream social stand, then psychology study, then bible study, then pre-dental meeting, finished bio lab report about worms and chemistry pset, and went to the gym and did a workout 🙂
- We had lunch with Tim and Payge and Vivian and it was really really fun conversation as per usual with Tim and Payge they are so so fun people you vibe really really well with them : )
- You got to have dinner with the other Jonathan Lee today and hear his testimony and go to Colonial and have dinner at an eating club! We also met Oleg againnnn 🙂 Was really really nice being able to talk with Jonathan and see how dedicated he is to… well everything! Your goal is to be as jacked and as cool as he is.
4/10/23
- We had a pretty busy day as per usual so I am grateful that Princeton allows us to be busy: we went to Korean class, chem lecture, bio precept, religion lecture, religion precept, did our Korean homework, made $60 from the psychology study, got late meal, went to the gym, did the pre-lab quiz for bio, and did our laundry.
- We got to grab lunch with Jessica so that was nice being able to talk with her for a little bit 🙂
- We called umma today and got to talk with umma and appa for a little bit: they are coming to visit on Saturday and take us to a yum restaurant so that is exciting.
4/9/23
- HAPPY EASTER! We got to go to King’s Covenant Church today to watch Heather get baptized and have our easter service there. It was really really fun going to a different church, eating KOREAN FOOD, and just overall having a really nice Sunday full of worship and praise
- We got to grab lunch with Sophia and Jessica! That was really nice being able to talk with them and quickly get to know each of them better. Sophia is such a sweet person! And also we got to talk a lot with Allen on the car ride to and from church today so that was nice 🙂
- We got to go to EADs training again today and have a pretty fun time with the rest of the team and have prayer and worship as per usualll. Also we finished up our bio pset tonight so that’s something: I really really am out of my league academically here what in the world.
4/8/23
- We had a really fun time at our last Six14 company today! We learnt a bit of new choreo and they got us tacoria to have for dinnerrr 🙂
- We went to see the mario movie in theaters! That was super duper fun I really enjoyed the nostalgia of that movie was p beautiful
- We had a really really really nice conversation with Kevin and Xuanying. We talked until like 2am and just bonded with them over our failed relationships and how we are all going to die alone (except for Kevin because he has rizz).
4/7/23
- ITS FRIDAYY; had a less busy but still fun day. Went to Korean class, went to Chemistry, did our Korean quiz and submitted our Korean homework, went to the gym, did Bible Study with Pastor Steven, had our psychology experiment thingy, good Friday service, and now back in the dorm!
- Was a lot of fun at Bible Study today with Pastor Steven, Kevin, and Michael. He is a very knowledgeable person I’m excited since it looks like you can learn a lot from him. Honest opinion however: he does seem a little bit stubborn so we shall see 🙂
- Good Friday service was really nice. Cynthia popped off and blessed us with her amazing singing voice I am absolutely in awe of her what in the world.
4/6/23
- We had a busy day as per usual with Princeton! Went to Korean class, went to bio, had lunch with Tim/Payge, went to chem lab, went to the gym, had dinner with our dship group, had a predental association meeting, and then did tutoring for Anthony
- We got to interrogate Brad and Brian about how they got girlfriends during dinner today… Was super duper fun talking to them about that (Lesson: Requirement for a girlfriend is loving Jesus)
- We got to finish up our student chem lab report that took literally FOREVER
4/5/23
- We had a really productive day today: went to Korean class, finished up the Korean hw and went to our funding meeting for pre-dental association, went to Religion class for the first time in 3 weeks, went to bio lab, did the psychology study thingy and made some money, and then did some work until the end of the day!
- We got to have lunch with Quin and Kate and got late meal and talked with Geoff for a little bit and then we had dinner with Michael at late meal and then got to study with Heather, Michael, Lynn, and Rebekah until the end of the day!
- I am very very grateful for her and thankful for memories 🙂
4/4/23
- We had a decently productive day today! We went to Korean, then bio, then chem precept, then gym, then bible study, and then we went to do work with Michael, Xuanying and Kevin!
- We got to have lunch with Tim, Payge, Skywalker and Andrew! And we also got to grab dinner with Michael and Xuanying and it was super duper nice talking with them
- We got to go to the gym today and had a really really good workout for back and bi!
4/3/23
- We had a super duper busy but productive day today: we went to Korean class, then did our Korean homework, then went to bio precept to submit our pset, then went to the Princeton in Korea info thing, then worked on our study guide, then had our individual session with Korean teacher, then went to religion precept, then got late meal and went to firestone to study, and then finished up the chem midterm (even though it didn’t go too well…)
- We got to have late meal with Evelyn and her friend Nead! Was a super fun conversation and we got to learn about people with diverse backgrounds from myself
- We got to have dinner with a few of the PCF people today! Was super nice talking with Noelle and Colin and Abigail and all of the other PCF freshmen 🙂
4/2/23
- We went to church today and heard the most fire sermon on Daniel 9 about why not to take some of the bible literally: Seventy sevens (7 times 10) the fullness of time. NOT 77 weeks
- We got to grab lunch with Michael and Kevin and talk to them a little bit about masculinity and Christianity and Pastor Steven’s Bible Study and all of that is super duper interesting I love being able to talk about this type of stuff with other believers in Christ it’s so amazing
- We got to go to EADs training today and had a super duper fun time and I love prayer and worship and I love practicing skit and playing music 🙂 We are being Jesus in Blood!
4/1/23
- We had our LAST SIX14 SHOW TODAY AND IT WAS SUPER FUN AND HYPE we got to see umma and appa and Joey and we also had a super nice time in prayer and worship before hand 🙂
- We talked with Tiff for the first time after the show… was a little bit awkward..?
- Finished the bio quiz! Also had the best gym workout today ever I love push day it is the absolute best day. But there was so many other memories that you made today and so much smiling and so much worship and I really love being so close to God’s presence I don’t want to ever give that up…
3/31/23
- We got to grab TACORIA with some of the Six14 people after the show! Had a really really nice conversation with Michael, Bryan, Heather, Cynthia, and Jocelyn about theology.
- POSSIBLY JOINING PASTOR STEVEN’S BIBLE STUDY??? He is the smartest person ever I really hope that I can join them
- Had the most fun SIX14 SHOW EVER! Was super exciting being able to dance today, and then watch the videos and then the sympoh mid-act show! Also I really had a fun time after the show and we got to talk to Grace for a little bit so that was also nice too! She is still superrrr sweet. Also we got to walk with Abby and Lindsay after pretty late at night so that was a pleasant surprise and we saw Grace during the walk too! And then we played ping pong with Michael and walked a bit with Xuanying and talked about crushes and relationships so that was also very very fun too! I love these little fun experiences college is so beautiful.
3/30/23
- We got to have a late night sesh with William, Kevin, and Stephanie! That was really fun
- We went to happy hour with all of the Frosh and that was super duper fun! Also Stephanie is so so funny
- FINISHED FIRST SIX14 SHOW! THAT WAS SUPER HYPE AND SUPER FUN I REALLY ENJOYED BEING ABLE TO WORSHIP AND PRAISE GOD WITH DANCE!
3/29/23
- We had our LAST DAY OF HEAVEN WEEK TODAYYY Let’s kill this Six14 Show. Do it for JESUS
- We had such a busy week this past week and had a really really fun day today. Although we missed 3 of our classes… We still got 10 hours of sleep and went to lab!
- We got to grab dinner with Stephanie, Xuanying, Michael and Tracie! Was a pretty interesting group to grab dinner with 🙂
3/28/23
- We got to get CHIPOTLE FOR DINNER after picking up hsu hsu train’s birthday gift! That was super duper sweet of her so we bought chipotle for Xuanying, Stephanie and Jocelyn.
- We had Six14 rehearsal until 2am today… omg you are behind on all of your work and are dying but that was really fun and it’s for Jesus!
- We got to have a really fun time watching those videos today! The newbie vid and the senior vid 🙂
3/27/23
- We had a super big day today that was mostly productive so I am proud of ourselves for that. Although we slept in throughout Korean and Chemistry today, we did end up finishing our bio pset, making up the Korean class (during Religion), doing our Korean homework, getting late meal, doing our laundry, putting up six 14 posters, and going to the first heaven week practice
- It’s always fun being able to talk with Stephanie and Michael and Xuanying and we got to do all of that during practice today 🙂
- We got messaged from Isabelle today! She is such a sweet person and a really fun person to text too haha
3/26/23
- Reminded of first love again….
- HAPPY BIRTHDAY JONATHAN! You are officially 19 years old now: you got a lot of people to wish you happy birthday! Also the Manna group “surprised” you with a chicken and a birthday card and a song! Was super cute and nice. Got to have lunch with Michael, Brad, Kevin, Xuanying, Bryan and Michelle
- We are officially the treasurer of the Princeton Pre-dental association now!
- We got a little piggy as a birthday present! Was a really nice and thoughtful gift Michael is such a good friend
- We got to hear Appa’s words of advice on so many different topics he is vv knowledgable. Some of his takes are….
- Donald Trump > Biden because although he is obviously way more rude/impolite/racist, he makes good business decisions.
- Doctors > any other professional degree because we are Asian Americans. Lawyers/accountants will pretty much only get clients who are asian too. However, doctors, regardless of the race, will get clients from all over because of INSURANCE!
- Umma suffered for four years throughout college and got into Harvard, and because of her sacrifice the rest of our family can live pretty comfortably from her 7 figure salary.. Likewise, you have to suffer to.. get through it.
- Early bird gets the worm. Apply earlier and don’t wait for the last minute. You can do 99% of everything correct, it’s that last 1%, the final stretch, that you have to last until. Everyone will judge you based on that 1% rather than everything else you’ve done correct.
- Be honest: why does the U.S. care about the war in Ukraine? One missile cost 2 million dollars, and we literally just went into the city yesterday and saw countless homeless people trying to shelter themselves from the rain. And the only result from this war is more and more young people dying pointlessly. They think that it is patriotic and that they are dying for a noble cause, but your life and family is more valuable than patriotism. Think about your mother/father, would they rather have you or a folded flag
- According to doctors 19 years ago, I had a high probability that I would be born with Down Syndrome and the doctors told my parents to consider the possibility of abortion. Think about how hard life is for people with disabilities: life is hard enough as it is without being disabled. If it was guaranteed that I would have been born with Down Syndrome…. then…
3/25/23
- We got to see HAMILTON with the rest of the family! Was a super duper fun play I enjoyed it a lot 🙂
- We ate HALAL food and it was super duper yum I love halal. Also we ate other food too like mackerol, mac and cheese, the bread thingy, kbbq, tteokbokki, white soup, and so many yummy foods when we were at home
- We went to get our haircut done today!
3/24/23
- We got to have lunch with Timothy, Payge, and Kat today! Also met their friend Anthony
- We played a Santa.. cookie… elf.. candy… snowman game! Was a pretty interesting game I enjoyed it a lot
- Also we ARE HOME TODAYYY I love being home. We got to eat some good Korean food and say hi to Soo-gomo and Uncle Sukil
3/23/23
- We got to go to Halal with the rest of the Manna Praise Team! IT WAS SO YUM I LOVE HALAL FOOD
- We had a productive gym sesh today (who’s gonna carry the boats… and the logs…). I love chest day and screw legs
- We got to grab lunch with Timothy and Payge and it is soooooo fun to bully Tim. If you had to beat someone up and take their lunch money, it would 100% be Tim right?
3/22/23
- We got our room draw all taken care of and got a single in Bloomberg! I love singles 🙂
- We got to grab dinner with Grace! It was a little bit awkward after…. but still I am proud of myself for building the courage to ask!
- Bought our ticket to MEXICOOO! We are going to on our mission tripp
3/21/23
- Finished that stupid chem PSET that took literally FOREVER there was no purpose in that being so long and hard whattt
- We got dinner with the rest of the Manna Frosh today and it was nice to talk about things that you find really interesting regarding the Bible
- We found Kevin’s Youtube Channel and it was the funniest thing EVER oh my god
3/20/23
- We grabbed lunch with Khoa and ate dinner with Andy and his friends Josh and Allie! Was nice catching up with themmm
- Also you went to Thomas Sweets and tried ice cream (didn’t actually order anything, just free sample) with Colin, Matthew, Noelle, Abigail, and Iris!
- Went to all 5 of your classes today and had a really productive gym workout. ITS SO HARD TO BE ON TOP OF EVERYTHING BUT YOU GOT THIS GO YOU JONATHAN
3/19/23
- Heard the most fire sermon at Hope today about Daniel 8: talking about allusions to Alexander the Great and the Persians and all of that super cool stuff
- FINISHED THE GYM BRO SCENE TODAY FINALLY
- Grabbed dinner with the rest of the Manna Frosh to talk about Freshman takeover and such. Also went to EADs training and honestly that is super duper fun I am very happy to be a part of that team.
3/18/23
- FINISHED WITH SIX14 BOOTCAMP! Was super tiring and very very long but we managed to finish 🙂
- We grabbed dinner with Soraya today and talked with her for a little bit so was pretty nice
- MOCHINUTS ARE SO YUMMY BUT SO UNHEALTHY WHAT DO I DOOOO
3/17/23
- Lenaya came in clutch this morning and cancelled our 9am practice and so we got to sleep until like 1 🙂
- We got to grab dinner with Michael! Also went to the gym today and had a protein shake afterwards: I love that combo it’s so amazing
- We picked up a few more hobbies to take some time (pinterest and spotify). Also had a productive day at Six14 bootcamp as per usualll
3/16/23
- Six14 bootcamp was very very fun today but also extremely long! You are getting the dances down and learning more but it’s a big time commitmenttt
- You got to take a 3.5 hour long nap today and it was the best nap EVER
- Played ping pong, chess, and had fun with Michael and Xuanying today 🙂
3/15/23
- We finished our Religion Midtermmm (was a pretty fun midterm we actually learnt a little bit about the bible while writing it haha)
- Came back to Princeton and hsu hsu train kept us company on the entire train ride from Penn station back to Princeton! She is such a funny texter I am vv grateful for her
- Our new shoes arrived today and they are very very swag I enjoy new clothes!
3/14/23
- Met up with hsu hsu train today and talked with her for like 3 hours! Really nice catching up with her (even though you already talk with her every day) and also nice seeing her in person. You have to figure out how to venmo back
- You are grateful for the last day being back at homeee. School we go back tomorrow. School = home now.
- Grateful for umma and appa and how much they care about me
3/13/23
- We got to hang out with Josh today and watch Creed and got some new shoes 🙂
- We bought our plane tickets to Korea with Shreya today woohooo
- Moved on with yinne and life. Deleted all those memories. No more looking into the past. Live in the moment. You got this. You’ll be good
3/12/23
- Got to see Michael and his friend Kyle at church yesterday and quickly catch up with themm!
- Ate dinner with the entire family today and it was pretty nice 🙂 Also we got to see grandpa and grandma and got a soap from her…?
- Had a very very relaxing night and got to see all Rocky Movies on Netflix! We stayed up until like 3 watching it was a very good night : )
3/11/23
- Finished so many errands! We got our soap refilled, found our recording stand thingy, got a box of tissues, bought contact lense solution, bought our supplements, and got some new clothes
- SO MUCH SLEEP we got like 9 hours of sleep at night and then took another 3 hour nap after waking up and eating breakfast LOL
- We texted Hsu hsu train a lot today and it was really fun talking with her and watching her overthink her love life
3/10/23
- WE ARE GOING HOMEEE (had a smooth train ride back) I love being home omg
- Had a nice dinner at Pastaria with the familyyy 🙂 I got lobster ravioli and it tasted pretty good
- Finished our Korean speaking exam and got to talk a little bit with Sophie today and figured out that she is the Korean 102 tutor
3/9/23
- FINISHED BIO AND KOREAN MIDTERMS WOOOHOOOO very very relieved; you studied your butt off you should be proud
- Had a really productive gym chest day today: it has been a while I really missed the gym LOL
- Got to eat dinner with Jessica and talk with her for a bit! She is very very sweet 🙂
3/8/23
- Went to all of our classes today and managed to finish our 3.5 hour bio lab (it was super long but it is always nice to get to talk with Cevinaa)
- We studied a bit for bio tomorrow so GOODLUCK WE GOT IT
- Had the bestest dinner ever like Whitman dinner today was absolutely fire I enjoyed it so much wowowow (We had 2 sandwiches, mac and cheese, a salad, tuna, tofu, chicken, pasta, and other fancy foods it was yum)
3/7/23
- We went to all of our classes today 🙂 It was only 3 classes, but we still went to all of them so we have our little mini-victories! Korean quiz was short today as well
- We got to have lunch with Timothy and Payge and got dinner with Michael, Bryan, Jonathan, Tiffany and Michelle! GOT TO GO TO COLO TODAY SO WAS EXCITING TO TRY OUT AN EATING CLUB FOR THE FIRST TIME
- Had a really fun time in FSG today asking about embarrassing first date stories and had the best 2 hour nap of your life as per usual and now we are studyinggg 🙂
3/6/23
- We had a pretty productive day today: went to all 6 of our classes (;-;), ate 2 meals, went to the gym, and got to go to sesh for sympoh! You know sesh is actually really fun I enjoy it a lot
- We had dinner with PCF people and got to catch up with Colin, Ryan, and Meagan. Was nice talking to people (and also we ate with Charles and Por for a little bit)
- We got to talk with Grace for a little bit today! Gaslight ourselves into being happy = lesson of the day 🙂
3/5/23
- We got to have lunch with Xuanying, Brad, Alaister, Michael, and Kevin! Got to talk to them about Squash and see Alaister’s huge forearm.
- Got to have dinner with UMMA and try the sushi platterr. Was very very yum (except for those 2 disgusting pieces of sushi)
- Went to EADS practice today and had a really nice time there! I really enjoyed worshipping and doing the skit practice that was really fun.
3/4/23
- Got to have lunch with Michael and talk with him about his favorite foods and potential dating. It’s really nice to grab one on one meals with people and be able to build our relationships even better
- We went to the Koko pops performance today and it was reallyyy good. You need to learn how to dance and become cool like that. You should definitely learn how to do that when you get to Korea
- Had a really nice gym session today for chest day, and you got to see Grace at Murray dodge and get free cookies there! She is soooo cute and I loved the matcha strawberry cookie that was delicious.
3/3/23
- We got lunch with Kiran today and got to have dinner with Skywalker, Jy, and Michael! Had a super interesting conversation with them about Christianity and God’s existence and all of that stuff
- Got to grab a junbi drink with Katherine today! Was a really nice time and talked with her about EADS. I am decently sure that we want to go but we just have to get our passport arrived in time
- Welp we are a part of the Manna Servant Team for Praise Team now! That should be exciting I am happy to serve a part of this community and give back after receiving so much LOL
3/2/23
- Got a quick 5 minute lunch with Kadin today and talked with Yi-ying for a bit as well. Also you got to say hi to Grace at lunch today and wish her luck on her cos midterm
- You had a productive gym sesh today and got a nice back/bi workout! Also FAIR LIFE IS SO GOOD I LOVE IT
- You got to finish your chem lab today and did your laundry! Also you ate dinner with a few of the pre-dental group members so that was fun :O
3/1/23
- Got lunch with Brad today and talked with him about how he’s going to Oklahoma for Medical School and his dating life LOL
- FINISHED THE STUPID CHEM MIDTERM NOW YOU CAN ACTUALLY GO TO SLEEP AND ENJOY LIFE FOR A LITTLE BIT
- You went to the gym today for the first time in 4 days and did a really good chest day today 🙂 Also you saw Sky and Por and you are grabbing a meal with both of them sometime in the next week!
2/28/23
- You got to grab dinner with Jessica today and talk with her for a bit!
- You played guitar at Manna FSG today 🙂 I am happy I had the opportunity to lead worship during one of our small groups this semester
- You took 2 naps today for 2 hours each LOL what the heck you kinda definitely messed up your sleep schedule but honestly, it was worth it that was the best sleep of my life.
2/27/23
- Got lunch with Jessica and Kadin! Was fun catching up with him and talking about OA with him again (and then versing him in an arm wrestle). So he told us that he wasn’t being serious during OA which makes so much sense LOL
- Got dinner with Matthew and Chimwemwe! You needed to show face at the PCF dinner thing today so that they don’t forget you and you stay a part of the community. But was nice quickly talking with them about their day and seeing what they are up to
- You had a really productive day today so I am grateful that you didn’t crash 🙂 Today we went to all 5 classes, got 2 late meals, finished our bio lap report, submitted our bio pset, went to a chem review session, finished our Korean homework, and submitted the Manna Servant Team application with questions!
2/26/23
- Got to volunteer at the Taekwondo tournament today and we got a super cool/free taekwondo t-shirt. Also we saw our old teacher from YH Park Taekwondo and saw Edward’s sister…?
- Grabbed dinner with Brandon! He’s a really busy and pretty popular guy! Interesting that you were able to eat with him LOL
- Went to dance practice and finally finished up Abigail’s piece. Also was fun talking with Cynthia and Zoey as well
2/25/23
- Got lunch with Cynthia, Jessica, Michael and Xuanying! And dinner with Heather, James, Ellie, and Andrew.
- Got my short religion paper out of the way (there’s still so much more work to do but you got ittt)
- Had a fun time at Six14 rehearsal today, Praise Team, and Large Group. Also you enjoyed going to the gym and having a pretty good back/bi day 🙂
2/24/23
- Got to grab lunch with Michael, Kevin, and Pastor Steven! That man is super jacked it’s absolutely insane
- Got to bake cookies with Tina today 🙂 Even though you won’t be spending any more time with her, it was really nice getting to know her, taking her on a few dates, and enjoying her company. I hope she has a super amazing rest of her life and finds someone who is just right for her as well. Honestly I am a little bit disappointed that we didn’t work out, but I am grateful for the experience, grateful for her honesty, and grateful to just have met her.
- I’m a part of Sympoh now! That was fun; hopefully I become a super amazing break dancer in the future.
2/23/23
- Got to grab lunch with Quin and had a super nice time catching up with her! She is a super sweet and nice person
- Got dinner with Bryan, Zach, and Matthew! Had a nice conversation with them 🙂
- Committed to PiK so we have our summer plans set! Also we got a 2026 scarf today!
2/22/23
- Got to grab dinner with Enzo and quickly catch up with him! And while I was there I got an m and m cookie with coffee ice cream and chocolate milk! Was so so yum
- Went to the Sympoh workshop today and got to practice break dancing with Xuanying! (But you did see __ so was a little bit awkward..)
- GOT INTO PiK! I am going to Korea over the summer yayayay; hopefully that goes well!
2/21/23
- Got to grab dinner with Grace and walk her to the library! She is such a sweet/amazing person I am super glad to have caught up with her today 🙂 You should probably let her know that you are interested before someone else does
- Finished my Chem PSET, submitted Bio PSET, finished pre-lab quiz, and finished a youtube video! Grateful for a productive day
- Had a super amazing nap today for 2 hours and 30 minutes! Also grabbed lunch with Brandon and talked with him for a bit
2/20/23
- Got to see Pastor DK, DC, and Aaron at EADS info night tonight! You probably will go to the EADS trip that looks like a place where you should serve
- Got to grab junbi and eat at Roma with Sophia, Nathan, Abellia, and Eunice! It is nice seeing the underclassmen hopefully they are all doing well
- You got to talk to Jessica a little bit today on the walk to Whitman and a little bit during lunch! She is a super sweet person I’m happy to have met her 🙂
2/19/23
- Got to sit next to Justin on the way to church today and catch up a bit with him; and you talked with Michael a bit on the bus ride back as well
- You got lunch with Bryan, Cynthia and Andrew! And you talked to hsu hsu train so much today why do you talk to her so much. But she’s always fun to talk to and make fun of
- You got dinner with Tina today! Had a pretty nice conversation over dinner and got to know her a bit better. You’re baking with her Friday as well!
2/18/23
- Six14 today was super duper fun you got to learn a bit of a new hip hop choerography and it was pretty cool! Also Lina is such a fun/outgoing person I’m glad she came to visit today
- You bought yourself a new chain todayy; you deserve it! It’s a really nice chain
- Got to help out with worship at Manna today again! And you got lunch with six14 people and dinner with Chris so it was a nice day today 🙂
2/17/23
- Relaxing Friday today: Went to Korean class, got homework done, did your laundry, met up with Andrew, finished the PiK interview, went to the gym, and finished up an application for Jeju Island!
- You met Justin during lunch today! He is not the most talkative person but he was fun to get to know
- You got to message Grace on insta about her cookies! She is a bakerrr (ok u have to see if ur interested now; baking is literally one of the most attractive hobbies ever).
2/16/23
- Got a haircut and dinner with Umma! Spent about 3 hours getting food
- You are going to grab a meal with Grace sometime!
- Finished the Korean quiz and so you are basically set with difficult things for the week!
2/15/23
- You went on your first date today; Christina was a super nice person and it’s nice to talk to someone who is actually interested in getting to know you
- Finished bio lab about an hour early so you got to rest in your room a little bit today
- Finished the Korean homework and the stupid bio lab report and submitted your bio pset today. And now you are doing a little bit of studying for Korean quiz tomorrowww.
2/14/23
- Managed to apply for a new passport very smoothly and was only like 10 minutes. Took 2 Ubers all by yourself and you are acting so mature now what whatttt
- Got dinner with Xuanying, Tracie, and Kevin. Tracie imparted her senior wisdom onto us!
- Data match! (Happy Valentine’s Dayyy) But yeah we are grabbing ice cream at Junbi with Cristine tomorrow so we shall see how that goes.
2/13/23
- Tried out Princeton Taekwondo for the first time today! Was really fun and you got to see Jessica there so that was exciting! Also, Elise is literally adorable. But you realized that you need to stretch a LOT more
- Got dinner with Enzooo. He’s such a cool dude and you had like an hour-long conversation with him.
- I am thankful for being able to go to all of my 5 classes today 🙂 and also for being able to have a really nice gym workout sesh
2/12/23
- Got to grab lunch with Irene, Jocelyn, Kevin and Boya! (Hope Church people). It’s always really nice getting to talk with people and building relationships/friendships
- Grabbed dinner at Yeh with Kevin! Had a really nice conversation with him 🙂
- Caught up with Daniel on the bench! He APPLIED TO 50 COMPANIES WHAT (Also you got to talk with Jadi for a little bit on the walk to Forbes!)
2/11/23
- Got to go to my first praise team practice today! Was super fun and I realized that I am capable of playing along to the songs decently well 🙂
- I grabbed lunch with the Six14 group and got dinner with Chris! We went to a hidden Mexican place and honestly the burritos there were pretty good.
- SO MUCH SLEEP! Slept until 11am, and then took another 2 hour nap and it was heavenly.
2/10/23
- Watched the Sympho concert with Michael. Was a super duper cool show I was really impressed. And then got food at campus club with Michael as well!
- Got lunch with Kirannn; was super duper happy to see her and catch up with her today
- Got over with a leg day. ALSO HAD A COOKIE WITH HOT CHOCOLATE AND IT WAS THE MOST DELICIOUS THING EVER
2/9/23
- Got to grab dinner with the praise team and have a nice conversation with Chris and James : )
- Went to the gym for a back/bi day
- Had a really nice and relaxing nappp
2/8/23
- Got to see Hero again at dinner! What a nice coincidence.
- Went to go see the Native American show at McCarter with Lu! Was an extremely… interesting/funny/creative play. Definitely would get canceled if played anywhere else in society but was really fun nonetheless!
- Got to do a really nice chest day at the gym today. Also got 4 bananas, napkins, and 3 protein bars for future eats. GET IN THAT PHYSICAL SHAPE
2/7/23
- Got lunch with a super cool grad student named Hero from Japan! He didn’t speak much english but it was an interesting conversation nonetheless
- Got dinner with James! Caught up with him about life and asked him about joining praise team and now you might be playing guitar for Manna Praise Team!
- Got to go to Yedoh’s place to study and it was a really nice time with Katie, Joy, Ellie, and Andrew
2/6/23
- Got to practice ballroom dancing! Was so much fun you are going to do that every Monday night from now on. It’s really nice getting to dance with a girl and learn ballroom dances together with friends
- Was a really productive day today: finished your chem PSET, bio PSET, Chem Pre-lab, Bio Lab Entry, and Korean Homework. Also went to 4 classes, got lunch/dinner/2 late meals, and went to the gym and did leg day
- Ate lunch with Jessica! She is hopefully going to be one of your new friends. And got dinner with PCF people.
2/5/23
- Got to go to the gym with Chris and catch up with how his life is goinggg
- Went to Hope Church today and talked with Jocelyn on the bus ride. Also! You got to wave to Grace today (she is so cute what the heck)
- Had a somewhat productive dance rehearsal today (But more importantly you got to nap!)
2/4/23
- Got to get lunch with Abigail, Zoey, and Katherine! And got to talk with Irene a bit during dinner! 🙂 Am super happy to have met them
- Such a good workout today. Chest day = best day
- Got to quickly catch up with Grace a bit after Manna today! She is absolutely adorable and the sweetest person ever what in the world.
2/3/23
- Got lunch with Jessica and had a pretty nice conversation with her 🙂
- Went to my first FNF with PCF! Was a really interesting time; made fun of Will for sleeping during the message and got to catch up with Eric and Paul.
- Finished my first week of Princeton classes!
2/2/23
- Mother came to grab dinner with meee. Now we know which restaurant sucks
- Submitted my Princeton in Korea application and hoping for the best
- Got lunch with Skywalker! Had a really fun time telling him my story of how I ditched him to sit by himself in the lunch room 🙂
2/1/23
- Got dinner with Bryan and had a really nice conversation with him 🙂
- Partnered up with Cevina in Bio! (attempting to make friends. Hopefully I do not screw this up)
- Pretty much finished the PiK application (I REALLY WANT TO GOOO)
1/31/23
- 2nd day of classes and you are not completely dead yet
- Got lunch with Nile and Daniel
- How about the fact that you are literally studying at Princeton University What in the World.
1/30/23
- 1st day of classes! Met a lot of new people
- Had a super nice dinner with people from prayer meeting (Heather, Joy, Andrew, Bryan, Lu)
- REST DAY FROM GYM
1/19/23
- HAD LUNCH WITH VIV! She is actually adorable
- Got to see Mr. Mal and listen to Joey’s concert (It sucked)
- Had such an amazing and awesome winter break I am so grateful for all of my friends
11/7/22
- Day lights saying so I got an extra hour
- FINISHED WITH THE STUPID R2 SO AM EXTREMELY RELIEVED
- Skipped Chem precept for a nap
(I’ve been slacking but I’ll get back on keeping this gratitude journal updated)
11/6/22
- Had a really good gym session today
- Acne is slowly going away
- ALMOST FINISHED WIT THIS SUPER PAPER
10/18/22
- YINNE TEXTED AGAIN 🙂
- IM BACK HOME AND REALLY HAPPY
- Went to the library today
10/15/22
- HAD SO MUCH FUN TODAY
- Played volleyball, wearwolf, spike ball, and basketball
- Made a bunch of new friends
10/14/22
- FRIDAY so we finished writing Sem for the week
- GOING ON THE RETREAT WITH MANNA
- SUPER EXCITED
10/13/22
- Finished the Korean Midterm
- Umma came to visit
- NAP NAP NAP
10/11/22
- Korean quiz today was relatively easy
- Got lunch with Lindsay and Zuha
- Super chill day todayy
10/10/22
- FINISHED CHEM MIDTERM
- Got cookies with Koki
- Loved midterm care package that was great
10/9/22
- HAD 10 HOURS OF SLEEP
- Finished a productive 3 hours of studying as well as the alcohol edu thing
- Got dinner with Xuan and Por
10/8/22
- Got lunch with the Six14 group
- Met Matthew Oh at Manna (Such a cool dude)
- Had some Pad Thai for dinner
10/7/22
- Got lunch with Kiran
- Got a free cookie and see Kiran’s dorm
- Finished the stupid math EP
10/6/22
- Yinne texted and wants to hang! 🙂
- Got lunch with Lindsay and Kate
- 4 HOUR NAP
10/5/22
- Got to finish my Chem Lab early and left 3 hours before everyone else
- Ate lunch with Athena, Oyu, Azhar and Christine
- Had a really fun time with VR in Korean today
10/4/22
- My new watch has arrivedd
- Got lunch with Sunil, Andrew, and Tiffany Deane. Got dinner with Bryan and Andrew
- Had a really nice time at the Manna Study Group tonight
10/3/22
- Yinne followed back my finsta 🙂
- Almost finished with my R1
- Got dinner with Zach, Isaiah, and Jaisnav

